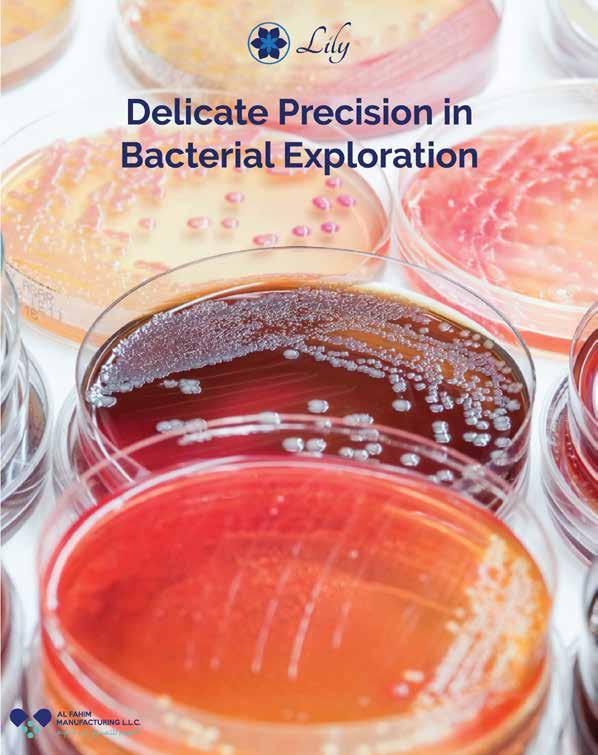

Issue 212 l May 2024
ﺔﻴﺤﺼﻟا ﺔﻳﺎﻋﺮﻟا ﻟﻢﺎﻋ ﰲ ﺔﻤﻬﻠﳌا ةدﺎﻴﻘﻟا جذﻮﻧﻤ ﻲﺒﻳﺮﻐﻟا لﻤﺎﻛ
www.thearabhospital.com
Publisher
Arab Health Media Communication
President Simon Chammas schammas@tahmag.com
Executive Vice President Mirna Khairallah mirna@tahmag.com
Editor in Chief Simon Semaan
Senior Editor Elham Najem
Editors
May Atallah, Adel Abdel Karim Najib Zein, Dany Khairallah
Content Marketing Manager Jessie Chlela jessie@tahmag.com
Creative Director Rania Khalil rania@tahmag.com
Business Development Manager Wadih Chammas wadih@tahmag.com
IT Manager Elie Yammine elie@tahmag.com
Photographer Hanna Nehme
Advertising advertising@thearabhospital.com
OFFICES
IHMC, Cyprus +357 96 158661
Dubai
Expert Media Communication Services-FZCO
Dubai Silicone Oasis +971 50 2971007
Printing
Distribution
KSA - UAE - OMAN - TURKEY LEBANON - JORDAN - KUWAIT BAHRAIN - QATAR - EGYPT

نياجلما انقيبطت ليمحتب مق
part
publication can
reproduced
form
ىلع رثكأ زيكرتلا يرجي هثاحبأ عسوتو بطلا مدقت عم ةحصلا ىلع ةيلقعلاو ةيسفنلا ةحصلا ريثأت ةيمهأ روطتلا تايادب يف ىتح .امومع ناسنلإل ةيدسجلا تابارطضلإا ثحب يف برعلا ءابطلأا عسوت يبطلا اهضارعأ فصو يف اوعربو ،لقعلا ىلع أرطت يتلا لا ،انيس نبإ بطلا وبأ مهنمو ،اهتاجلاعو اهتاملاعو .هلامعأ رهشأ »ءافشلا« باتك يف اميس تابارطضا ةيلقعلا ضارملأا اودع برعلا ءابطلأاف ءاضعأ يرتعت يتلا ضارملأا يقاب لثم اهلثم ،ةيوضع أرطت ةيوضع تاباصإ ةلاحلا هذه يف يهو ،مسجلا يف ةيارد برعلا ءابطلأا ىمادقل ناك امك .غامدلا ىلع لئاسولاب اهب نيباصملا ذاقنإو ضارملأا هذه ةجلاعم »يسفنلا ليلحتلا« اهيمسن يتلاو ،ةبسانملا .)psychoanalysis( بورحو تابوعص نم ملاعلا هب رمي ام دعبو ،مويلا ةحيرش تتاب ،اهريغو ةيحصو ةيلامو ةيداصتقإ تامزأو دقتعي وأ ،دقتعت تابارطضا يناعت سانلا نم ةعساو ةيسفن يه اميف ،ةفرص ةيدسج اهنأ ،نيجلاعملا ضعب جلاعلا نإف انه نم .ةيدسج ىلإ تلوحت ،ساسلأا يف .ةجيتنلا نم لا ببسلا نم أدبي ام وه يفاشلا نوكي نأ بجي ميلسلا جلاعلاف نييئاصخلأا بسحبو ةفورعملاو ةداتعملا ريقاقعلا ،لاوأ :نييوتسم ىلع .ةلاح لك بسحب ةمئلاملا يطاعتلا قرط دامتعاو ،ايبط تاموكحلاو تامظنملا لمع ،مهلأا نوكي امبرو ،ايناثو تائيب نيمأت ىلع ةفاك ةينعملا تاهجلاو تاسسؤملاو عسوت نم دحي ام ،ةبسانم ةيسفنو ةيعامتجإ تاخانمو يعدتسي ءاد حبصت نأ لبق ،يسفنلا بارطضلإا تلااح نبإ هنمضي مل »ءافشلا« باتكف .ةيريرسلا تاجلاعملا ةعوسوم وه لب ،ريقاقع عاونأو ةيعضوم تاجلاع انيس مولع اهنمض ،ةعيبطلا دعب امو ةعيبطلا مولعل ىربك ةيمهأ ىلإ ريشي نأ اهب دارأو ،قطنملاو تايهللإا اذهو .فرعن اذامو فرصتن فيكو ،هءارو امو انطيحم ،ريقاقعلاب طقف سيل ءافشلا نأ ،هرظن يف ،رسفي !هدعب لا ضرملا لبق أدبي جلاعلاو يرقاقعلاب طقف سيل ءافشلا !هدعب لا ضرلما لبق جلاعلاو 3 l 2024 )رايأ( ويام
All images from shutterstock© unless provided by clients. All rights reserved by the HOSPITALS magazine. No
of this
be
in any
without prior permission in writting from the publisher.

Is Your Organization on the Path Toward Delivering Highly Reliable Healthcare?
Joint Commission International (JCI) offers a comprehensive framework and practical tools to guide your healthcare organization on its journey towards high reliability. We equip your leaders and staff with the knowledge, resources, and strategies needed to:
• Foster leadership commitment to zero harm, ensuring unwavering support for safety initiatives
• Promote safety culture, open communication, and continuous improvement
Let us guide you on a transformative path toward consistent excellence in quality and safety.
• Implement robust process improvement (RPI) methods to systematically identify and eliminate potential risks Start

your journey today. Scan the QR code to learn more. *The use of Joint Commission International (JCI) advisory services is not necessary to obtain a Joint Commission International Accreditation award, nor does it influence the granting of such awards.





2024 )رايأ( ويام l 4 28 ةيحصلا ةياعرلا لماع في ةمهللما ةدايقلا جذونم ...يبيرغلا لماك زوين قارعلا يف يحصلا عاطقلا يف اهعسوت نم اددجم ززعت ةضباقلا رامثتسا 8 رطق ةلودب ىلكلا ةعارزل ةيتوبور ةحارج لوأ يرجت ةيبطلا دمح ةسسؤم 42 متتخت ةيبطلا دمح ...ماعلا اذهل مييختلا مسوم للاخ اعجارم 1260 ليجست 45 نيليس ةقطنمب مييختلا مسومل ةيبطلا ةدايعلا ةطشنأ تلاباقم Cedars-Sinai International ـل يذيفنتلا سيئرلا ،نوسح مثيه روتكدلا 68 دبكلا تايلمع ةدحوو ةماعلا ةحارجلا مسق سيئر ،رايط دولك روتكدلا 72 توريب يف يبطلا وصنميلك زكرم يف سايركنبلاو رطق - بطلل لينروك لياو -ءايزيفلا ذاتسأ ،فسوي دمحم روتكدلا 80 زكرم يف ضارملأا ملع مسق سيئر ،رصان ميلس روتكدلا 86 ةيلك يف ضارملأا ملع مسق سيئرو توريب يف يبطلا وصنميلك










2024 )رايأ( ويام l 6 ةيبط تلااقم اهدئاوفو اهعاونأ مهأ :ةنمسلا ةحارج :رطق - يلهلأا ىفشتسملا 94 :ةدعملا تانولاب ىلع فرعت :رطق - يلهلأا ىفشتسملا 102 اهعاونأ رهشأو اهدئاوف يئاذغلا ماظنلا :ميمكتلا دعب ام :رطق - يلهلأا ىفشتسملا 108 تاميلعتلا مهأو ةيبط عيضاوم يوئرلا ليهأتلا ةداعإ 74 ىلكلا ليسغ تاينقت مدقت 82 ىضرملل لضفأ ةايح وحن ةلهذم تاوطخ ؟ةيناطرس ىلإ لوحتت له ...ةديمحلا يدثلا ماروأ 88 ملاعلا لوح ةنمسلا ضرم 96 ةريبك ةيداصتقإ ةفلكتو يحص قلق ؟لبقتسملا نع اذامف ةيملاعلا ةحصلا ددهي رطخ ..ةنمسلا 98 اقحلا ضارملأاب مهددهي ءابو ...لافطلأا ىدل ةنمسلا 104 ىلعأ ةيلاعفو ربكأ ةنورمب يركسلا ضرم ةرادإ ..نيلوسنلأا نقح روطت 110 نيديفتسملا رثكأ ضيرملاو ...اهل رصح لا تاناكمإ - دعب نع بطلا 128 74 يوئرلا ليهأتلا ةداعإ 88 ةديمحلا يدثلا ماروأ 82 لىكلا ليسغ تاينقت مدقت 96 لماعلا لوح ةنمسلا ضرم




ةضباقلا رماثتسا قارعلا في يحصلا عاطقلا في اهعسوت نم اددجم ززعت م.م.ذ ةيحصلا ةياعرلل ايسناغيلإ ةكشر تعقو ةدئارلاو ةضباقلا رماثتسلا ةعباتلا تاكشرلا ىدحإ ةيجيتاترسا ةيقافتا ،ةيحصلا ةياعرلا لاجم في ليغشتو ةرادإ فدهب ةيقارعلا ةحصلا ةرازو عم )يميلعتلا( ىبتجلما نسحلا ماملإا ىفشتسم في ءلابرك ةظفاحم في اريسر 492 ةعسب .قارعلا ةيروهمج نم ةيناثلا يه ةيقافتلاا هذه نأ ركذلاب ريدجلاو ةيروهمج يف ةيحصلا ةياعرلل ايسناغيلإ ةكرشل اهعون ليغشتو ةرادلإ ةيقافتا عيقوت مت ثيح قارعلا راق يذ ةظفاحم يف يميلعتلا ةيرصانلا ىفشتسم اهترادإ متيس يتلا ةرسلأا ددع كلذب لصيل ارخؤم راق يذ يتظفاحم نيب ام اريرس 1000 براقي ام ىلإ روتكدلا نم لك ةيقافتلاا عيقوتب ماق دقو .ءلابركو ءلابرك ةظفاحم ةحص ماع ريدم يوسوملا رون حابص سيئرلا هتفصب ةداسلا ردب نب دمحم سدنهملاو .ةضباقلا رامثتسا ةعومجمل يذيفنتلا نب دمحم سدنهملا قلع ةبسانملا هذه يفو رامثتسا ةعومجمل يذيفنتلا سيئرلا ةداسلا ردب قارعلا يف ةكرشلا تاطاشن عسوت ىلع ةضباقلا مجح ريوطت راطإ يف ةوطخلا هذه يتأت“ :لائاق ةضباقلا رامثتسا اهريدت يتلا عيراشملاو لامعلأا .راق يذ ةظفاحم يف اندجاوتل ازيزعتو قارعلا يف زوين ةكارشلا هذه يف امدق يضملاب ءادعس اننا امك ريوطتل انهجوت عم ىشامتت يتلا ةيجيتارتسلاا هب ءاقترلااو قارعلا ةيروهمج يف يحصلا عاطقلا عم ةددعتملا انتاكارشو تايقافتلاا هذه للاخ نم ”.ةيقارعلا ةحصلا ةرازو ةيحصلا ةياعرلل ايسناغيلا ةكرش نأب زتعن امك تلاهؤملا ىلعأ كلتمت ةضباقلا رامثتسلا ةعباتلا زيمتلاو ةءافكلا ريياعم ىلإ ةدنتسملا تاربخلاو ةيحصلا ةياعرلا تآشنمو عيراشم ربكأ ةرادإ يف انمازتلا ةيقافتلاا هذه لثمت امك ،ايملاعو ايميلقإ ىلإ فدهت يتلا ةضباقلا رامثتسا ةيجيتارتساب ةيحصلا ةياعرلا عاطق يف ةكرشلا لامعأب عسوتلا ومنو ةيرامثتسلاا ةظفحملا ريوطتل اقيقحت كلذو ”.نيمهاسملل اهتميق سيئرلا ،ليزاه فيزوج ديسلا هبناج نم لاقو هذه فدهت”:ةيحصلا ةياعرلل ايسناغيللإ يذيفنتلا ةيحصلا ةياعرلا تامدخ ريوطت ىلإ تايقافتلاا نسحلا ماملإا ىفشتسم يف ايلاح ةمدقملا ءاقترلال يميلعتلا ةيرصانلا ىفشتسمو ىبتجملا ةيليغشتلا ةءافكلا ةدايزو تامدخلا ىوتسمب للاخ نم كلذو ةيبطلا تاصصختلاب عسوتلاو ةيليغشتلاو ةيرادلإا تايجيتارتسلاا ثدحأ قيبطت نم ةيحصلا ةياعرلل ايسناغيلإ ةكرش اهب زيمتت يتلا ةرادإ لاجم يف اهسرمتو ةخسارلا اهتربخ للاخ ”.ةيحصلا تآشنملا ليغشتو ،عيراشملا مجح ةماخضب تايقافتلاا هذه زيمتتو نسحلا ماملإا ىفشتسم عورشم مضي ثيح نم اريبك اددع يطغيو نابم ةثلاث ىبتجملا بلطتي نيذلا ىضرملل يحارجلا جلاعلاك تامدخلا يوتحيو امك ،ىفشتسملا لخاد ةماقلإا مهجلاع ةيجراخلا تادايعلا نم ريبك ددع ىلع ىفشتسملا تاراشتسلاا ميدقتل تاصصختلا فلتخم رفوت يتلا يعيبطلا جلاعلاو ىلكلا ليسغك تاجلاعلاو ةيرصانلا ىفشتسم عورشم مضي امك.اهريغو ايبط امسق 19 يميلعتلا 2024 )رايأ( ويام l 8















HO S T E D B Y 13 - 15 MAY 2024 | ADNEC AND ABU DHABI CITY, UAE Under the Patronage of His Highness Sheikh Khaled bin Mohamed bin Zayed Al Nahyan Crown Prince of Abu Dhabi and Chairman of Abu Dhabi Executive Council Accelerating the
Join the healthcare conversation at Abu Dhabi Global Healthcare Week, and make health and quality care a global priority 4 CONFERENCE PILLARS 1 EXHIBITION PLATFORM 200 SPEAKERS 5,000 ATTENDEES 1,000 DELEGATES 100 EXHIBITORS Book your stand: Secure your free visitor pass: HEALTHCARE TRANSFORMATION PARTNER INNOVATIVE PARTNER FOR TRANSFORMING HEALTHCARE LONGEVITY PARTNER SCIENTIFIC HEALTHY LONGEVITY LEADER STRATEGIC PARTNER SUSTAINABLE HEALTHCARE PARTNER SUPPORTED BY VENUE PARTNER ORGANISED BY DESTINATION AND CULTURAL PARTNER NETWORK PARTNER HOSTED BY NATIONAL HEALTHCARE AND LONGEVITY CHAMPION FOUNDATION PARTNER HEALTH SYSTEM SUSTAINABILITY AND RESILIENCE PARTNER HEALTHCARE SECTOR SPONSORS PATIENT ENGAGEMENT PARTNER RESEARCH & DEVELOPMENT LEADER HEALTHCARE ECOSYSTEM PARTNER ACCESS TO HEALTHCARE PARTNER INNOVATIVE GLOBAL HEALTHCARE PARTNER PREMIUM IMMUNISATION PARTNER
Future of Global Healthcare
REHABILITATION CLINIC
A MODERN REHABILITATION FACILITY ESTABLISHED BY THE MINISTRY OF HEALTH. ONE OF THE OLDEST REHABILITATION CLINIC FACILITIES IN THE CZECH REPUBLIC.
Janské Lázně Spa has a long-standing reputation as one of the best rehabilitation facilities in the Czech Republic. It is also an ideal starting point for sports and recreational activities in the Krkonoše Mountains.
The natural healing resources are the thermal mineral water of the hydrocarbonate-lime-sodium type, springing up in the spa area, and the local foothill climate
The medical spa focuses on physiotherapy and the treatment of the disorders of the musculoskeletal system resulting from diseases of the brain, disc, spine or accidents (hemiplegia in the lower body or on one side of the body or complete paralysis), diseases of the muscular and nervous system, including muscular dystrophy, cerebral palsy, various sclerosis and effects of strokes. In addition to this, the effects of malignant tumours on the body are also treated as are problems with joints, rheumatism, joint stiffness, muscle weakness, gait impairment and balance.
The spa also treats respiratory diseases such as asthma and allergies and cases after respiratory surgery. It also offers tailored programs for weight reduction.
The Children’s Sanatorium is one of the largest and most modern facilities of its kind in the Czech Republic. It continues a long tradition of treating cerebral palsy, especially in children. It


specializes in the treatment of children from 6 months and adolescents up to 18 years of age with nervous disorders including muscular dystrophy and cerebral palsy, as well as in the treatment of musculoskeletal disorders and conditions after injuries and orthopedic surgeries. Among other things, we also treat metabolic disorders and endocrine problems, including obesity, as well as respiratory diseases.
INDIVIDUAL PHYSIOTHERAPY
Individual physiotherapy is the key to effective treatment; the therapist accurately diagnoses the patient’s condition, then designs and adjusts the treatment plan according to the patient’s
ELECTROACUPUNCTURE
It combines traditional acupuncture, an official medical method in the Czech Republic, with the current knowledge of physical treatment. The doctor inserts acupuncture needles and then uses the device to deliver an electric current to the needles.
In Janské Lázně, patients with complete severing of the spinal cord have been able to regain movement, and a unique treatment of paralysis using electroacupuncture has been helping patients for several years. The author of the AC-TIVE ENF treatment method is Peter Olšák, a rehabilitation physician who has treated more than 700 patients, including some with complete spinal cord severance. The method was created by combining medi-
needs and abilities. This personalized approach allows the therapist to work with individual limits, provide immediate feedback and correct exercise techniques, maximizing the effectiveness of the therapy and preventing potential complications.
PHYSICAL THERAPY
SUPER INDUCTIVE SYSTEM (SIS) consists of an intense electromagnetic field that has positive therapeutic effects on human tissue. The main therapeutic effects include pain relief, promotion of fracture healing, muscle relaxation, muscle stimulation and joint mobilization.
ERGOTHERAPY
Combines physical and mental training, helping to increase muscle strength, improve coordination and develop cognitive function.
SNOEZELEN
A specially adapted room with light and sound for children with developmental, mental and physical disabilities, autism spectrum disorder, behavioural and learning disorders, and post-traumatic brain injury.

cal acupuncture and knowledge of physical medicine.
Olšák led a team of scientists from Palacký University in Olomouc who won the Transfera Technology Day 2023 competition with innovative needles for electroacupuncture applications.
13 l 2024 )رايأ( ويام
NEW!!! www.janskelazne.com











Excellence in Healthcare










Cedars-Sinai is proud to be recognized eight years in a row on the “Best Hospitals” Honor Roll and ranked among the top fi ve in the U.S. in six specialties by U.S. News & World Report . As a global leader in healthcare, we offer a full range of services to patients from around the world. Whether we’re providing clinical services in your region, via video visits or at our main campus in Los Angeles, our mission remains unchanged: to give patients access to excellence in healthcare— wherever they may be.











































• Cancer



11 specialties ranked among the best in the U.S.
• Cardiology, Heart & Vascular Surgery
• Diabetes & Endocrinology
• Ear, Nose & Throat

• Neurology & Neurosurgery

• Obstetrics & Gynecology
• Orthopedics


• Pulmonology & Lung Surgery
• Gastroenterology & GI Surgery
• Geriatrics







• Urology


Learn more: cedars-sinai.org/international | cedars-sinai.org/globalcollaborations




Scan the QR code to follow us on LinkedIn.




2024 OS.D95

High Quality Healthcare Services for Everyone’s Needs!




202 4 O S D9 5 xhibition 2024







ESSENZA 300
Become a designer of a hospital bed
Patient comfort and well-being are getting more important within hospital care. The design of the room and the entire design concept can play a significant role in recovery.
Original Design
The Essenza 300 bed enables the integration of advanced medical beds into a unique hospital room concept due to SMART LINK technology. Thanks to SMART LINK you create the original design of bed ends and side rails.
Customized Solutions
Thanks to the unique technologies in LINET production can adapt the bed to your needs. We are ready to integrate colors and graphic motifs such as logos, photos, or other graphic elements.
Advanced Technology
Essenza 300 is a top-quality, smart hospital bed available as a universal low-height bed or Essenza 300 LT with bed-framed lateral tilt.

@LINETMEA @LINETMEA
@LINET mea@linet.com
Jitka Stranska Managing Director of LINET MEA

“The fusion of hospital care and hotel services is increasingly evident. Prestigious hospitals not only pay attention to high-level medical standards but also to other aspects of hospitality, including, among others, top-quality interior design. We are delighted that our beds are once again bringing a new element: personalized room customization. Thanks to special technology, our new Essenza 300 bed offers a completely individual design to match the room concept or create pleasant healing environment.”






فلاغلا ةيلماعلا ةيحصلا ةياعرلا لاجم في ازراب انكر هبصن رهاب حاجن لىإ لاوصو سنوت في ةعضاوتم تايادب نم يبيرغلا لماك ةلحر ةفلتخم تلااجم برع يبيرغلا لماك يعاسم دسجتت ."ةيويؤرلا ةدايقلاو داجلا نيافتلا" ناونع تحت راصتخاب نونعت نأ نكيُم للاخ نمو .ةفلتخم نكامأ في ةدحولاو لماشلا ومنلا زيزعت كلذكو ،ميلعتلاو ةيحصلا ةياعرلا ريوطتب قيمعلا همازتلا سكعت رمتسي مانيبو .ثيدحلا لصاوتلا صرع في ةلاعفلاو ةلوؤسلما ةدايقلل اجذونم حبصأ ،ةينهلما هتاحاجنو ةخسارلا هميق هجمد مايلعتو ةحص لضفأ يلماع عمتجم وحن قيرطلا ادهمم ،يرخلا بحو عادبلإل اعبنم يبيرغلا لماك ىقبي ،ماهللإاو يرثأتلل اردصم لغشي :لبقتسلما في ديزلما قيقحت لىإ علطتيو ،يرثكلا ققح ،يرخ لجرو لماعأ لجرو يلماع دئاق ،يبيرغلا لماك .انواعتو وتانود ناس تايفشتسم ةعومجم ةسائر اضيأ لىوتيو ،رماثتسلال ةضباقلا "GKSD" ةعومجم سيئر بصنم يبيرغلا لماك ىفشتسمو يعماجلا لييافار ناس ىفشتسم سيئر بئان وهو ،ةيحصلا ةياعرلاو ءافشتسلااو ثوحبلل يملعلا دهعملل ةعباتلا ،هذه ةينغلا ةيتاذلا هتيرس لضفب .ةيحصلا ةياعرلاو ءافشتسلااو ثوحبلل يملعلا دهعملل ينعباتلا ويجوبرمأ تناس - يزتايلاغ .يلماع ىوتسم لىع ةيحصلا ةياعرلا لاجم في ةزيمتم ةمصب يبيرغلا لماك كرت ينعي حاجنلا نأ وه عيمجلا هيلع قفتي يذلا موهفلما نكل ،رخآ لىإ صخش نم حاجنلا ميهافم فلتخت“ ثيح ،ىبرك ةيصخش تايحضت جاتن وه رهابلا حاجنلا .حاجنلا اذه قيقحت لجأ نم ةيحضتلا لىع ءرلما ةردق ”.هفادهأ لجأ نم لتاقي نأ ءرلما لىع


2024 )رايأ( ويام l 30 فلاغلا يبيرغلا لامك طبتري ،ةيسنوتلا هلوصأب ارختفم ديدعلا بسني ثيح ،هنطوو هروذجب اقيثو اطابترا تايادب نم اقلطنم .هتقلاطنا ناكم ىلإ هتازاجنإ نم سركو ةيوقلا لمعلا تايقلاخأ ملعت ،ةعضاوتم ناك يتلا لامعلأاو ماهملل لماك لكشب هسفن ةمراصلا هلمع قلاخأ نيب عمج .اهزاجنإ ىلإ جاتحي هنطو ةرداغم ىلإ هعفد امم ،يدايرلا هحومطو هترداغم ةظحل تناك .ةديدج قافآ فاشكتسلا ملأا باوص تدكأ جئاتنلا نكلو ،ةريرم هترسأو هنطول هتدلاول هنانتما نع يبيرغلا لامك ربعي ؛هرارق حبصأ ،مويلاو .هتريسم نم ةلحرم لك يف سنوتلو ةياعرلا ةعانص يف ةرثؤملا تايصخشلا زربأ نم ادحاو ناكم لك يف ةحاتم صرفلا نأب نمؤي وهو ،ةيحصلا ،اهلجأ نم لمعلل نيدعتسم مه نمل ملاعلا يف عم لمعيو ءرملا نواعتي نا ةيمهأ ىلع اددشم .هلوح نم يوق قيرف ةيقيرفلإا هروذج يف هثبشت نم مغرلا ىلع امئاد امتهم ناك يبيرغلا لامك نأ لاإ ،ةيلامشلا قرشلا ةقطنم هجاوت يتلا تايدحتلاب ركفيو صقنب قلعتي ام يف ةصاخ ،ايقيرفإو طسولأا ةيحصلا ةياعرلا لثم ةيويح تاعاطق يف رامثتسلاا هذه ةشقانمب ردابف .ةيتحتلا ةينبلاو ميلعتلاو لاإ ،ةمهلمو ةرثؤم تايصخش عم ةحارص فواخملا رملأا ،لودلا ضعب نيب مهافتلا بايغ ظحلا هنأ فاشكتسا يف ددرتلا ىلإ نيرمثتسملا عفدي يذلا أجل ،كلذل .قطانملا هذه يف رامثتسلاا صرف ،ناسنلإا اهدمتعي يتلا لئاسولا ىوقأ ضعب ىلإ قيرطلا لازي لا .لصاوتلاو يعامجلا لمعلا يهو ديهمتل ادهاج لمعي يبيرغلا لامك نكلو ،لايوط نييسايسلا ةداقلا نم ةمداق لايجأ مامأ قيرطلا تايدحتلا ةهجاوم نم اونكمتيل ،لامعلأا لاجرو .ةعاجشب تايلوؤسملا لمحتو اهليلذتو ةلئاهلا ءوضلا طيلستب ”يبرعلا ىفشتسملا“ ةلجم ىنعت ايسيئر ارود بعلت يتلا ةزرابلا تايصخشلا ىلع سانلا فيرعت لجأ نم ،ةيحصلا ةياعرلا عاطق يف مهرثأو مهتمصب زواجتت نيذلا صاخشلأا ىلع يقيقح لاثم يبيرغلا لامك .اهنؤوبتي يتلا زكارملا تاحاجنلا قيقحتب فتكي مل وهو ،تايصخشلا هذهل .عاطقلا اذه يف ريبك لكشب اهزواجت لب ،ةداتعملا زيمتم ينهم راسم ىلع لايلد هتاماهسإ لكشت تاعورشم لك سكعت .ةيويؤر ةدايقو تباث مازتلاب دسجتت ثيح ،هتادقتعمو ةيساسلأا هميق يبيرغلا ىلعأ قيقحتو ةيلوصولاو راكتبلاا لثم ئدابم اهيف رصتقت لا .ةيحصلا ةياعرلا لاجم يف ةدوجلا ريياعم ريوطت يف رامثتسلاا ىلع طقف تاردابملا هذه تامدخلا ريوطت ىلع اضيأ زكرت لب ،ةيتحتلا ةينبلا نيسحتو ريياعملا زيزعت فدهب ،ةدوجلا تاذ ةيحصلا .لودلا فلتخم يف ىضرملل جلاعلا جئاتن تارارقلا ذاختا يف يبيرغلا لامك جهن مستي لعافتلاو ةيلومشلاب يجيتارتسلاا طيطختلاو زواجتي يذلا يصخشلا رامثتسلاا عم ،قيمعلا نم ةسمل هلمع يفضي .ينهملا همازتلا درجم حاجن طقف سيل هل نمضي امم ،ةفطاعلاو ينافتلا وه مازتللاا اذه نإ .اضيأ زيمتلا امنإو هدوهج لك ةدايقلل ارايعم اعضاو ،ةظوحلملا هحاجن ةصق ساسأ .ةيحصلا ةياعرلا لاجم يف ةيحبر للاخ نم طقف يبيرغلا حاجن سايق نكمي لا ىلع اهريثأت للاخ نم لب ،اهمجح وأ هعيراشم ام ابلاغ .ماع لكشب يحصلا دهشملاو تاعمتجملا نيب عمجي ثيح ةكرتشم ادوهج هتايجيتارتسا لمشت ةيحصلا تايدحتلا ةهجاومل ةحلصملا باحصأ فلتخم هتيؤر ىلإ ةفاضلإاب ،ينواعتلا جهنلا اذه .ةدقعملا ،ةيحصلا ةياعرلا عاطق تايناكمإو تاجايتحلا ةداحلا ميدقت لكش تريغ ةركتبم لولح داجيإ ىلإ ىدأ .ةفلتخم قطانم يف ةيحصلا ةياعرلا

2024 )رايأ( ويام l 32 لاجم في افورعم ادئاق كنوك ،لماك ديس ائماد ركذتست ،رماثتسلااو ةيحصلا ةياعرلا ثيدحلا في سينوتلا كثرإ يرثأت ىدم ىدم وه ام كيأرب .كلمع تايقلاخأ نع ةداير لاجم في كجهن لىع كلوصأ يرثأت ؟ةيلماعلا ةدايقلاو لماعلأا ىلإ دتميو يتيوه رهوج لكشي يسنوتلا يثرإ اروعش يف سرغ ،رغصلا ذنم .يلمع تايقلاخأ هذه تناك .حومطلاو لوضفلاو ةرباثملاب ايوق يتلحر هيلع تينب يذلا ساسلأا رجح يه ميقلا ،ثرلإا اذهب احلستم .لامعلأا ةداير لاجم يف ،ةيملاعلا تافاقثلاو رظنلا تاهجو مامأ احتفنمو .ةعونتملا ةيفاقثلا تلااجملا رامغ ضوخ نم تنكمت تاراهملا يف رامثتسلاا ةيمهأ ىدم امامت كردأ انأ أدبم وهو ،لضفأ لبقتسم ءانب لجأ نم ةيرشبلا .يعيراشم عيمج هيلع زكترت لىع تارلما نم ديدعلا في تدكأ .ةدايقلا في ةيلبقتسلما ةيؤرلا ةيمهأ كتيؤر يرثأت ةيفيك حيضوت كنكيم له ةدايقلا في كجهن لىع ةيصخشلا يجيتاترسلاا هاجتلاا لىع اهيرثأتو فيك ،كلذ لىإ ةفاضلإاب ؟كعيراشلم زيزعت في مهاست ةيؤرلا هذه نأ دقتعت عمتجم لخاد داشرلإاو ةيلومشلا ةفاقث ؟هجراخو لماعلأا بعلت ةحضاولا ةيؤرلا نأب ةوقب نمؤأ انأ ،ديكأتلاب تناك املاطل .ةلاعفلا ةدايقلا يف امساح ارود موقأ ام لك يف ايوق اعفاد ةيصخشلا يتيؤر يجيتارتسلاا هاجتلاا طقف ددحت لا اهنإ ثيح ،هب زيمت يتلا ةيساسلأا ميقلا اضيأ امنإو انعيراشمل يف قمعب ةرذجتم ةيؤرلا هذه .ةيميظنتلا انتفاقث داجيإ لوح روحمتتو ،يفادهأو يلاعفأو يتادقتعم تاعمتجملل لب ،انلامعلأ طقف سيل ةمادتسم ةميق اضيأ اهمدخن يتلا ةلاعفلا ةدايقلا نأ تملعت ،ةينهملا يتريسم لاوط ةيؤر ،ةكرتشم ةيؤر داجيإ ىلع ةردقلا بلطتت ةيلبقتسملا تايناكملإاب ؤبنتلا ىلع رصتقت لا باحصأو قيرفلا ىلإ قمعب دتمت لب ،بسحف ايساسأ ناك جهنلا اذه .لكك عمتجملاو ةحلصملا قيقحتل انقرف زيفحتو ةيعامجلا دوهجلا كيرحت يف لصاوتلا لوح رودي جهن هنإ .ةكرتشملا فادهلأا اءزج نوكي نأ يف عيمجلا بغري لبقتسم نأشب ىرأ ،كلذ ىلإ ةفاضلإاب .هب اونمؤي نأ مهنكميو هنم لامعلأا دودح زواجتي يندم بجاوك لامعلأا ةداير فلاغلا هميلعتو مداقلا ليجلا هيجوت لمشي ثيح ،ةيراجتلا تاراهملا لقن للاخ نم مدقتلاو روطتلا ةيفيك يصخشلا روطتلل ةيمهلأا غلاب رمأ وهو ،ةفرعملاو ةفاقث زيزعت ىلإ انتردابم فدهت .انعمتجم مدقتو ءامتنلااو ريدقتلاو نيكمتلاب بابشلا اهيف رعشي .ةيلبقتسملا مهصرفو مهثارت ىلإ بلغتلا فادهلأا هذه قيقحت بلطتي ،كلذ عمو ةيسايسلا تاميسقتلا كلذ يف امب ،تابقعلا ىلع ةيلومشلا ىلإ ةوعدلا يرورضلا نم .ةيعاطقلاو نمضي يعامج جهن نع عافدلاو ،يملسلا شياعتلاو مجرتت نأ بجي .هريدقتو درف لك توصل عامتسلاا ،ةيداصتقلاا انتايجيتارتسا ىلإ اضيأ ةيلومشلا هذه ،عيمجلا ىلع ةدئافلاب دوعي مدقتلا نأ نامضل يتيؤر زكرت ،ةطاسبب .ةراتخم ةلق ىلع طقف سيلو نيبو ،لبقتسملاو رضاحلا نيب روسج ءانب ىلع .ةعونتم تاعومجم نيبو ،تاعمتجملاو لامعلأا ةيؤرلا هذه نوكت لاأ نامض يه دئاقك يتيلوؤسم نوكراشي نم لك عم اهتكراشم امنإو ،يدحو يل قيقحتل كرتشملا انريثأت زيزعت ،يلاتلابو ،انتلحر يف .ةرشابملا انريثأت دودح زواجتي يذلا يباجيلإا رييغتلا فوغش مازتلا نع تبرع دقل ،لماك ديس تلااجم في مايس لاو ،ةييرخلا لماعلأاب ترثأ فيك .ميلعتلاو ةيحصلا ةياعرلا ضارغلأ كلماعأ حاجن رماثتسا في كتمهم ةعومجم تايولوأو تايلمع لىع ةيناسنإ ةعومجمو ،رماثتسلال ةضباقلا ”GKSD“ سلجمو ،”GSD“ وتانود ناس تايفشتسم قشرلاو ايقيرفلأ بيورولأا تاكشرلا فيكو ؟”ECAM“ يحبرلا يرغ طسولأا تارارقلا في ةييرخلا فادهلأا هذه جمدت ؟كلماعلأ ةيمويلا ةطشنلأاو ةيجيتاترسلاا ،ةيصخش ةميق درجم سيل ةيريخلا لامعلأاب يمازتلا ”GKSD” ةعومجم يف انجهن نم يساسأ ءزج لب حاجنلا نأ تكردأ ،ةيادبلا ذنمف .رامثتسلال ةضباقلا مل ،لورتبلا عاطق يف ةصاخبو ،لامعلأا ملاع يف ءاطعلا ةداعلإ ةيلوؤسم لب ،بسحف ةصرف رفوي مهفلا اذه رثأ دقو .ةلاعفو ةيدجم قرطب عمتجملل .ةيجيتارتسلااو ةيلمعلا انتايولوأ ىلع قيمع لكشب بناج لك يف يريخلا لمعلا يعوب جمدن نحن ةيفيك يف حورلا هذه ىلجتت .انلمع بناوج نم لوصولا زيزعت وحن انتاكبشو انتاربخو اندراوم هيجوت نأب نمؤأ .ميلعتلاو ةيحصلا ةياعرلا ىلإ لماشلا بجيو رضحتم عمتجم يلأ ةزيكر يه ميقلا هذه عضولا نع رظنلا ضغب ،عيمجلل ةحاتم نوكت نأ .يفارغجلاو يسايسلاو يداصتقلااو يعامتجلاا معدلا مدقن ،فدهلا اذه قيقحت لجأ نمو قطانملا يف ةصاخ ،تاسسؤملل ةدعاسملاو ىلع .تامدخلا صقنو رقفلا نم يناعت يتلا ”GKSD” ةعومجمل اسيئر يتفصبو ،لاثملا ليبس ناس تايفشتسم ةعومجمو ،رامثتسلال ةضباقلا يبورولأا تاكرشلا سلجمو ،”GSD“ وتانود ،”ECAM“ يحبرلا ريغ طسولأا قرشلاو ايقيرفلأ لوصولا ةيناكمإ ىلع ريثأتلل زيمتم عقوم يف انأف رصتقت لا انتمهم .رشابم لكشب ةيحصلا ةياعرلا ىلإ زيزعت ىلع لمعن لب تايفشتسملا ةرادإ ىلع .دراوملاو تاراهملاو ةفرعملا لدابت لهست تائيب نييحصلا نيينهملا بيردت انعيراشم لمشت ام ابلاغ ،ةيبطلا ةيتحتلا ةينبلا يف رامثتسلااو ،نييلحملا يف ىتح ةيبطلا تاسرامملا لضفأ قيبطت نامضو .ةيئانلا قطانملا عم يريخلا انجهن جمدب انمق ،كلذ ىلإ ةفاضلإاب نم انتارامثتسا ىلإ رظنن نحن .انلامعأ جذومن يعامتجلاا ريثأتلاو ةيحبرلا نمضتي جودزم روظنم ،انلامعأ روطت نمضي جودزملا زيكرتلا اذه نلأ .ةيعامتجلاا ةيمنتلا يف ريبك لكشب اضيأ مهسيو يف هتيناكمإ يف لمأتن ،هذختن يجيتارتسا رارق لك ليومتلا للاخ نم ءاوس ،ةيريخلا فادهلأا معد .ةيعمتجملا ةكراشملا جمارب وأ تاكارشلا وأ رشابملا ةيريخلا فادهلأا هذه نيمضت للاخ نم ،راصتخاب ةلسلستم ةرود لكشن ،انلامعأ تايلمع رهوج يف ،ةيناسنلإا دوهجلا لامعلأا حاجن يذغي ثيح ةيباجيإ تاعمتجملا يرثتو ،اهرودب ،دوهجلا هذه رقتستو مهسي لا لماشلا جهنلا اذه .اهيف لمعن يتلا اضيأ نمضي هنكلو ةيراجتلا انفادهأ قيقحت يف طقف يريخلا لمعلل ةميدقلا لثملا ىوتسم ىلإ انءاقترا ةحماستمو ةينواعت تاعمتجم ءانبو ةيناسنلإا بحكرت ىلإ فدهن ،دوهجلا هذه للاخ نم .ةمرتحمو نم نكلو ةيلاملا ةيحانلا نم طقف ساقي لا ثرإ .ملاعلا ءاحنأ عيمج يف رشبلا ةايح نيسحت للاخ دتيم ةيعماتجلاا ةيلوؤسلماب كمازتلا فياقثلا ثاترلا في كتكراشم للاخ نم ةيسامولبدلا تاقلاعلا زيزعتل يخيراتلاو في مازتللاا اذه دسجت فيك .ةيراجتلاو لثم قطانم في ةصاخ ،كلماعأ تاسرمام حشر كنكيم له ؟ايقيرفأو طسولأا قشرلا جذانم لىع ئدابلما هذه يرثأت ةيفيك ؟ةيلحلما ةيمنتلا في كتمهاسمو كلمع

35 l 2024 )رايأ( ويام اطبترم لامعلأا يف يجهن ناك املاطل ،ديكأتلاب .ةيوقلا ةيعامتجلاا ةيلوؤسملاب قيثو لكشب ،تاكرشلا نأب فارتعلاا ىلإ جهنلا اذه دوعي اهيدل ،يملاع قاطن ىلع لمعت يتلا كلت ةصاخو يباجيلإا رييغتلا زيزعتب - مازتللاا لعفلابو - ةردقلا اذهو .اهمدخت يتلا لودلاو تاعمتجملا نمض ةينغلا ةيفاقثلا قطانملا يف ةصاخ ةيمهأ هل رمأ ،ايقيرفأو طسولأا قرشلا لثم ايخيرات ةمهملاو تاريثأت اهل نوكي نأ لامعلأا ةطشنلأ نكمي ثيح .ةقيمع ةيعامتجا لاجم يف يتاراهم تمدختسا ،ةيادبلا ذنم يداصتقلاا حاجنلا قيقحتل طقف سيل لامعلأا تاسسؤملا عم لاعف لكشب اضيأ ةكراشملل امنإو ارمأ ربتعي لعافتلا اذه .ةيموكحلا تائيهلاو ةيلحملا ةيفاقثلا تاقايسلل قيمع مهف ريوطتل ايساسأ يف ددحتو ةيراجتلا تاقلاعلا لكشت يتلا ةيخيراتلاو اذه ،ةيلمعلا ةيحانلا نم .انلامعأ تايجيتارتسا ةياهنلا يعوب عورشمو يراجت رارق لك عم لماعتن اننأ ينعي يف هتامهاسمو ةلمتحملا ةيفاقثلا هراثآب ديدش .عمتجملا مدقت قرشلا يف انتطشنأ يف ،لاثملا ليبس ىلع يتلا عيراشملل ةيولولأا حنمن ،ايقيرفأو طسولأا اضيأ ةرداق لب ،بسحف ايداصتقا ةرقتسم نوكت لا .يلحملا عمتجملا جيسن يف ةمهاسملا ىلع ةيحصلا ةياعرلا يف رامثتسلاا كلذ لمشي نأ نكمي ةرشابم دئاوف رفوت يتلا تاعاطقلا - ميلعتلاو عمتجملا مدقتل سسلأا عضتو يلحملا عمتجملل عم ةءانب تاراوح يف كراشن .ليوطلا ىدملا ىلع قفاوت نامضل ةحلصملا باحصأو نييلحملا ةداقلا .تاعمتجملا تاعلطتو تاجايتحا عم انعيراشم ةيعامتجلاا ةيلوؤسملاب انمازتلا ،كلذ ىلإ ةفاضلإاب نحنف .انلامعأ جذامن عضو ةقيرط يف ىلجتي ةيلحملا ةلماعلا ىوقلا ريوطتل صرفلا جمدب موقن جهنلا اذه نمضي .دمعتم لكشب تاردقلا زيزعتو ةدعاق ليكشت يف ةقطنملا يف اندوجو ماهسإ ةيساسأ يهو ،ةرهاملا ةلماعلا ىوقلا نم قلخ ةيمهأ ىلع دكؤن نحن .ةمادتسملا ةيمنتلل ايروحم ارود بابشلا بعلي ثيح ،بابشلل صرف .لبقتسملا يف عمتجملا راهدزاو رارقتسا يف ةيميلعتلا تاسسؤملا عم تاكارشلا للاخ نمو تاراسم ريفوت ىلإ ىعسن ،ةيلحملا تاكرشلاو ةمزلالا صرفلاو تاراهملا باستكلا بابشلل يف ةمهاسملا ىلع رصتقي لا دهجلا اذه .حاجنلل دارفلأا نم لايج اضيأ ززعي لب ،لهجلاو رقفلا فيفخت يف ةمهاسملا مهنكمي نيذلا ةرهملاو نيفقثملا .مهعمتجم رارقتساو ومن سيل انلامعأ جذامن ميمصتب انمق ،ساسلأا يف لمعن يتلا قطانملا نم ةميقلا صلاختسلا طقف ةيلوؤسملا جمد للاخ نم .اهئاشنلإ لب اهيف ىعسن ،ةيراجتلا انتاسرامم رهوج يف ةيعامتجلاا قيقحت يف ةمهاسملاو يداصتقلاا حاجنلا قيقحتل دقل .ومنلل صرفلا زيزعت ربع رارقتسلااو ملاسلا نامضو انلاعفأ هيجوت يف ايساسأ جهنلا اذه ناك .لضفأ ملاع ءاشنإ يف انثرلإ ةيدجملا ةمهاسملا ةماع ةرظن انل مدقت نأ كنكيم له GKSD Healthcare“ ةكشر رود لىع في ”Management & Consulting رماثتسلال ةضباقلا ”GKSD“ ةعومجم ؟وتانود ناس تايفشتسم ةعومجمو كتيرسم ززعت فيك ،كلذ لىإ ةفاضلإاب نم تاعاطق لمشت يتلا ،ةعونتلما لىع كتردق ،ةيحصلا ةياعرلا لىإ تاراقعلا ؟ةفلتخم قطانم برع ةلماكتم لولح ميدقت GKSD Healthcare Management ةكرش دعت ”GKSD” ةعومجم نم ايويح اءزج & Consulting ناس تايفشتسم ةعومجمو رامثتسلال ةضباقلا اهنكمي يجيتارتسا عقومب عتمتت ثيح ،وتانود ةعساولا ملأا انتامظنم ةربخ نم ةدافتسلاا نم ،2020 ماع يف ةكرشلا هذه تسسأت .ةزيمتملاو ةيراشتسا تامدخ ميدقت ىلع انزيكرت ناكو ،ةلامكتم ةيحص ةياعر لولحو ةزيمتم ةيجيتارتسا ةرفوتملا ةعساولا ةفرعملاو ةربخلا نم نيديفتسم ناس هيتولاس اتيف ةعماج“ لمشتو ،انتكبش نمض جامدإب قلعتي رملأا ناك ءاوس .ةزيمتملا ”لييافار ةينبلا عيراشم يف ةمدقتملا ةيسدنهلا لولحلا يف انتربخ للاغتسا وأ ةيحصلا ةياعرلل ةيتحتلا يدسجلا لوصولا ةيناكمإ زيزعتل تاراقعلا لاجم ةعساولا انتكراشم نإف ،ةيحصلا ةياعرلا قفارم ىلإ ،كلذ ىلإ ةفاضلإاب .انتامدخ يرثت تاعاطقلا يف ةقطنمو ابوروأو ايلاطيإ ربع ةيفارغجلا انتاريثأت دتمت عساو روضح عم ،ايقيرفإ لامشو طسولأا قرشلا ضايرلاو يبدو ونلايم لثم ندم يف سوملمو روضحلا اذه انل نمضي .وناغولو تسراخوبو دادغبو قمعب نيجمدنمو لب لا ،نيفورعم نوكن نأ عونتملا نم اننكمي امم ،اهمدخن يتلا ةيلحملا قاوسلأا يف ةيلاعفب ةيميلقلإا تاجايتحلاا ةيبلتل انلولح صيصخت .يملاعلا زيمتلا تايوتسم ىلع ظافحلا عم GKSD Investment Holding لثمت ،راصتخاب قطانمو تاعاطق نيب ارسج GKSD Healthcareو ةلامكتم لولح ميدقت ىلع انتردق ززعي امم ،ةعونتم ةموظنملل ةدقعملا تاجايتحلاا سكعت ةركتبمو ،يلامكتلا جهنلا اذه للاخ نم .ةثيدحلا ةيحصلا نيسحت يف ريبك لكشب ةمهاسملا ىلإ فدهن .ةيملاعلا ةيحصلا ةياعرلا ةمظنأ ريوطتو


ردقت تاداريإب ايلاطيإ يف ةصاخ تايفشتسم ةعومجم ربكأ يه )رامثتسلال ةضباقلا ” ” ةعومجم نم ءزج( GSD - وتانود ناس تايفشتسم ةعومجم ةثلاث ةعومجملا مضت ،كلذ ىلإ ةفاضلإاب .ادنلوب يف 77 رخف لكب مضتو ،1957 ماع يف تسسأت .وروي رايلم 2.3 ىلاوحب انيدلو ،ةنسلا يف ضيرم نويلم 5.6 نم رثكأ انقفارم لبقتست .بيبط 8,000 نم رثكأ كلذ يف امب ،صخش 26,000 نم رثكأ فظوتو ،ةيعماج ةيثحب تايفشتسم ةعومجملا ثاحبأ فنصت .يبطلا بيردتلاو ةيملعلا ثوحبلا يف ةزيمتم زكارم اهرابتعاب ايلود اهب فرتعم سيردتلل انتايفشتسم .ةلود 15 نم رثكأ يف عيراشم ،تفوسوركيام ةكرش عم نواعتلاب .يولخلاو ينيجلا جلاعلا لاجم يف يسيئرلا انرودب رختفن نحنو ،ةيبطلا تاداهشتسلاا ثيح نم ملاعلا يف 10 لضفأ نمض ةياعرلا ةرادإ يف انتردقو انمهف اذه يرثي ،لاحلا ةعيبطبو .يعانطصلاا ءاكذلا ىلع ةمئاقلا ةيصيخشتلا ةياعرلا لاجم يف اهريوطت متي يتلا جماربلا نم ديدعلا انيدل تامدخ اهدمتعت يتلا ةيراكتبلاا ةياعرلا تايجهنمو تاينقتلا ثدحأب اهمازتلاب ةموعدم عاطقلا اذه يف وتانود ناس تايفشتسم ةعومجم يف انتدايق .ةيحصلا اضيأ GKSD تاراشتسا ةياعرلا لثم ةعونتم تلااجم يف ةصصختم تامدخ تاصصختلا ةددعتم ةعومجمك مدقن ذإ ،قوسلا يف ديرفلا انعقوم رامثتسلال ةضباقلا ”GKSD” ةعومجم ززعت مت يتلا ةيلودلا انتكبش للاخ نم .تاءاشنلإاو ةسدنهلاو ،ةددجتملا ةقاطلا لولحو ،تاكرشلاو يجيتارتسلاا ليومتلا يف تاراشتسلااو ،تايرتشملاو ،ةيحصلا مت ،صاخ لكشب .تاراشتسلااو عيراشملا ةرادإ لاجم يف ةدئار رامثتسلال ةضباقلا ”GKSD” ةعومجم تحبصأ ،طاشنلا نم اماع نيعبرأ نم رثكأ ىدم ىلع اهؤانب GKSD Engineering & Construc- ةيعرف صصختت امنيب .ةمادتسملاو ةددجتملا ةقاطلا تامدخ ريوطت يف انتبغرل ةجيتن GKSD Green Solutions ةيعرف ءاشنإ يف انعيراشمل امعد مدقن .ندملا ريوطتو ديدجتل ةدقعملا عيراشملا ةرادإ ىلإ ةفاضلإاب ،ةيئاشنلإا لامعلأاو ةريبكلا ةيندملا ةيسدنهلا لامعلأا ءانب يف tion ربتعي .ةيتحتلا ةينبلاو ةقاطلا دادمإ ةمظنأو ةيحصلا ةياعرلا تآشنم زيزعتل نيدهاج ىعسنو ،اينامورو ةدحتملا ةيبرعلا تاراملإاو قارعلا كلذ يف امب ،نادلبلا فلتخم .انئلامعل ةلامكتم لولح ميدقتل ةعونتملا ةربخلا للاغتساب انل حمست ةيجيتارتسا ةادأ لب ةوق درجم سيل عونتلا اذه فلاغلا

2024 )رايأ( ويام l 36 ايقيرفلأ بيورولأا تاكشرلا سلجم تفصو زيزعتل ةصنمك ”ECAM“ طسولأا قشرلاو ايقيرفأو ابوروأ ينب نواعتلاو راوحلا لماشو طسولأا قشرلا ةقطنمو فيك انل حشرت نأ كنكيم له .ايقيرفأ جمدل كتيؤر عم ةردابلما هذه شىماتت ؟لماعلأا تاسرمام في ييرخلا لمعلا سلجلما مزتعي فيك ،كلذ لىإ ةفاضلإابو تارماثتسلااب ةقلعتلما تايدحتلل يدصتلا برع ميلعتلاو ةيحصلا ةياعرلا يعاطق في ؟ةعونتلما قطانلما هذه ايقيرفلأ يبورولأا تاكرشلا سلجم ءاشنإ متي مل راوحلا زيزعت فدهب ”ECAM“ طسولأا قرشلاو راهظلإ اضيأ امنإو ،بسحف ةديدجلا تاكارشلاو يف ةسلاسب يريخلا لمعلا جمد نكمي فيك .ةيباجيإ ةيملاع تاريثأت قيقحتل ةمكوحلاو لامعلأا لامعلأا نأب - ةيصخشلا يتادقتعم عم قفاوتلا اذه قيقحت ىلع ةرداق ةطبارتم ىوق يريخلا لمعلاو .سلجملا جهنل يساسأ - يرهوج رييغت ثيح ةدحوم ةصنم ءاشنإ وه يسيئرلا انفده طسولأا قرشلا ةقطنمو ايقيرفأو ابورولأ نكمي نيديفتسم ،ربكأ لكشب نواعتلا ايقيرفأ لامشو تايدحتلا رثكأ ضعب ةهجاومل ةيعامجلا انتوق نم ةصاخبو ،مويلا قطانملا هذه اههجاوت يتلا ةلجاعلا ناذه .ميلعتلاو ةيحصلا ةياعرلا يعاطق يف يرقفلا دومعلا نلاكشي امهنلأ نايرورض ناعاطقلا سيل امهيف رامثتسلاا .عمتجم يأ ةيمنتو ومنل يجيتارتسا يداصتقا رارق هنكلو يريخ لعف طقف .عيمجلا هنم ديفتسي 19 -ديفوك ةحئاج ترهظأ ،لاثملا ليبس ىلع ةمظنلأا يف طبارتلا مجحو فعضلا طاقن حوضوب ةحلملا ةجاحلا ىلع دكأ امم ،ةيملاعلا ةيحصلا يساسأ ءزجك ةيحصلا ةياعرلل ةيوق ةيتحت ةينبل تاكرشلا سلجم زكري .يداصتقلاا رارقتسلاا نم ”ECAM“ طسولأا قرشلاو ايقيرفلأ يبورولأا ةيمهأ لوح يعولا زيزعت ىلع صاخ لكشب نم طقف سيل - ةيحصلا ةياعرلا يف رامثتسلاا رارقتسلاا يف يويحلا رامثتسلاا لب ،ةفلكتلا ثيح زيزعت للاخ نم .ةملأل يعامتجلااو يداصتقلاا ةيحصلا ةياعرلا يف تارامثتسلاا ليهستو تاجايتحلاا هذه ةيبلت نامض ىلإ ىعسن ،ميلعتلاو مهميلعتو ناكسلا ةحص زيزعت يلاتلابو ،ةيساسلأا .مهتاداصتقا يف ةمهاسملا نم اونكمتيل نواعتلل ارمم نوكي نلأ اضيأ سلجملا فدهي ،ايلاطيلإ ديرفلا عقوملا للاغتسا للاخ نم ربكلأا ةقطنمو ايقيرفإ ىلإ رسجك ،ابوروأ ماع لكشبو امورل انرايتخا .ايقيرفأ لامشو طسولأا قرشلا ،يجيتارتسا رايخ وه ةيناثلا انترود دقع لجأ نم تاقلاع .هققحيو عماجلا رودلا اذه ىلإ زمري وهف اهلعجت قطانملا هذه عم ةيباجيلإاو ةيخيراتلا امور دودحلا زواجتت يتلا تاشقانملا زيزعتل ايلاثم اناكم ،تايدحتلا هذه ةهجاوم يف .ةيفاقثلا تابقعلاو قرشلاو ايقيرفلأ يبورولأا تاكرشلا سلجم مزتعي ءاشنلإ هتصنم مادختسا ”ECAM“ طسولأا لاب ،ةدحوم - ةدحتملا مملأا رود هبشت تافلاحت ،كلذ للاخ نم .عيمجلاب ةبحرمو ،ةلماش ،دودح ىلإ ملاعلا اهب رظني يتلا ةقيرطلا رييغت مزتعن عقاو نم لقتنن يكل ،ميلعتلاو ةيحصلا ةياعرلا ةيويح تارامثتسا اهنأب فارتعلاا ىلإ ائبع اهرابتعا دارفأ عيمجل ليوطلا ىدملا ىلع اهرامث يتؤت تاكرشلا سلجم دسجي ،ةياهنلا يفو .عمتجملا ”ECAM“ طسولأا قرشلاو ايقيرفلأ يبورولأا مساح رود هل لامعلأا ملاع نأب ةخسارلا يتادقتعم مدقن نأ اننكمي .ةينطولا تاسسؤملا زيزعت يف نم لضفأ ملاع ءانب فدهب ةيدجم تامهاسم مدختو معدت يتلا ةيجيتارتسلاا تارامثتسلاا للاخ تاكرشلا سلجم نإف ،ببسلا اذهلو .سانلا ةماع ”ECAM“ طسولأا قرشلاو ايقيرفلأ يبورولأا لب ،راوحلاو نواعتلا زيزعت ىلإ طقف ىعسي لا ةيلمعو ةيلعف تاراسم عضو ىلإ اضيأ ىعسي ةيرورضلا روسجلا ءانبو ،تارامثتسلاا هذه قيقحتل انواعتو اطبارت رثكأ لبقتسم ليكشتل ايقيرفلأ بيورولأا تاكشرلا سلجم كراشي في طاشنب ”ECAM“ طسولأا قشرلاو ةييرخلا عيراشلما نم ةعونتم ةعومجم ةيحصلا ةياعرلا لثم ةيويح تاعاطق في ةشقانم كنكيم له .بيردتلاو ميلعتلاو ماق يتلا ةيسيئرلا عيراشلما ضعب فيكو ؟اهتايرثأت حيضوتو سلجلما اهب فادهأ عم عيراشلما هذه شىماتت نواعتلاو ةيمنتلا زيزعت في سلجلما ؟اهيف لمعي يتلا قطانلما لخاد ايقيرفلأ يبورولأا تاكرشلا سلجم مزتلي ،ديكأتلاب قيقحتب قيمع لكشب ”ECAM“ طسولأا قرشلاو ةيحصلا ةياعرلا تلااجم يف ةسوملم تاريثأت ارود تلااجملا هذه بعلت ثيح ،بيردتلاو ميلعتلاو ربع نواعتلاو ةمادتسملا ةيمنتلا زيزعت يف ايويح تاجايتحلاا ةيبلت ىلإ عورشم لك فدهي .قطانملا ربكلأا انتمهم ةبكاوم ىلإ اضيأ ىعسيو ةيروفلا ةردق زيزعتو دملأا ةليوط تاكارش ريوطت يف .لمحتلا ىلع عمتجملا سلجملا اهب ماق يتلا ةظوحلملا تاردابملا نيب نم ،ايروس يف لزلازلا اياحضل تادعاسملا ميدقت ناك .2023 رياربف 11 يف ةردابملا هذه قلاطإ مت ثيح ميدقت يف ةغلاب ةيمهأ اذ عورشملا اذه ناك دكؤي ام ،ةررضتملا تاعمتجملل ةيروفلا ةدعاسملا ،تامزلأا تاقوأ يف ةعيرسلا ةباجتسلااب انمازتلا يف لودلا نيب معدلاو نماضتلا ةيمهأ زربيو .ةيعيبطلا ثراوكلا ةهجاوم نيتيسارد نيتحنم حنمب انمق ،ميلعتلا لاجم يف نم عساتلا يف مولب يلوم ةيميداكأ عم نواعتلاب نم اءزج ةيساردلا حنملا هذه ربتعت .2022 وينوي ريفوت للاخ نم بابشلا يف رامثتسلال انتيجيتارتسا يلاتلابو ،ةدوجلا يلاع ميلعت ىلع لوصحلا صرف اونكمتيل ةيرورضلا ةفرعملاو تاراهملاب مهديوزت .مهتاعمتجم يف ةلاعفلا ةمهاسملا نم اعربت انمدق ،2021 سطسغأ نم عبارلا يف عمتجملا تاجايتحا معد فدهب ،رئازجلل اماه ايناسنإ ةجلاعمب اندهعتل اديسجت عربتلا اذه دعي .ةعونتملا زيزعتو ،تاعمتجملا اههجاوت يتلا ةصاخلا تايدحتلا .ةيومنتلا اهتاعلطت معدو ،اهتيهافر نم نيرشعلاو عبارلا يف ،كلذ ىلإ ةفاضلإاب نيجسكولأا“ ناونعب اعورشم انأدب ،2021 ويلوي صاخ لكشب امهم اذه ناك .”سنوت تايفشتسمل ةرشابم مهاس ثيح ،-19ديفوك ةحئاج ةورذ للاخ حاورلأا ذاقنإ ىلع يحصلا ماظنلا ةردق ةدايز يف .ةيلاعف رثكأ لكشب ةيحصلا ةمزلأا ةرادإو وينوي 11 يف هقلاطإ مت ريبك ريثأت وذ رخآ عورشم .لافطلأل بلقلا ةرطسقل ةفرغ ءاشنإ وهو 2021 رودلا هل ناك صصختملا يبطلا قفرملا اذه ةجرحلا ةيحصلا ةياعرلا تامدخ ريفوت يف يسيئرلا ةدوج يف ريبك نيسحت يف مهاس امم ،لافطلأل .راغصلا ىضرملل ةحاتملا ةيبلقلا ةياعرلا اهرايتخا مت يتلا ،عيراشملا هذه سكعت يبورولأا تاكرشلا سلجم مازتلا ،ةيانعب اهذيفنتو ةجلاعمب ”ECAM“ طسولأا قرشلاو ايقيرفلأ ءاشنإ ،هسفن تقولا يفو ،ةيروفلا تاجايتحلاا ىلع زيكرتلا للاخ نم .ةمادتسملا ةيمنتلل ةدعاقلا تائيب ريفوت ىلإ ىعسن ،ميلعتلاو ةيحصلا ةياعرلا ةيلاحلا تايدحتلا ةهجاومل ازهجم عمتجملا نوكي ثيح ةردابم لك .اقارشإ رثكأ لبقتسم ليكشتل امهلمو هيف زواجتي ملاعل انتيؤر قيقحت وحن ةوطخ لثمت ىوقأ يملاع عمتجم ءانبل ،دودحلا ةيمنتلاو نواعتلا .اطبارت رثكأو فلاغلا



INSIGHTERS® VIDEO LARYNGOSCOPE
*Not all airways are created equal.* Up to 8.5% of patients can experience difficulty getting a breathing tube in place during regular laryngoscopy. In rare cases )about 1 in 2,000(, it might even fail completely. The good news? Video laryngoscopes, like Insighters® device, can help doctors see the airway better. This can lead to smoother intubation, less damage to the airway, and fewer failed attempts.
Here's what makes Insighters® so versatile: It has a high-resolution camera for a crystal-
clear and precise view of the airway, singleuse blades in various sizes to fit different patients, and a compact, portable design for use anywhere in any clinical setting.
Moreover, it seamlessly connects to various monitors, from large screens to tablets, allowing for easy sharing and recording to improve teamwork and training through realtime high resolution image and video sharing; and therefore achieve optimal intubation efficiency and success.

MedboX
Lebanon MedboX LLC UAE
SAL
LEBANON UNITED ARAB EMIRATES T +96181549182 T +97145809632 WWW.MEDBOX-ME.COM INFO@MEDBOX-ME.COM


43 l 2024 )رايأ( ويام دبع روتكدلا حضوأ ةحارجلا هذه ىلع اقيلعت ةيلمعلل ريضحتلا قرغتسا“ :لائاق يراصنلأا هللا ددعتم لماكتم قيرف للاخ نم عيباسأ ةدع ةيحارجلا ةيبطلا دمح ةسسؤمب ءاربخلا نم تاصصختلا ،ءاضعلأا ةعارز ،ةيتوبورلا ةحارجلا ءابطأ مهو ،ىلكلا ضارمأ ييصاصتخاو ريدختلا ييصاصتخا ،ضيرملا ريضحت بناج ىلإ ،ضيرمتلا قيرفو قيرط نع حاجنب ةيحارجلا ةيلمعلا ءارجإ مت ىتح اهؤارجإ قرغتسا يتلاو ”يشنفاد“ توبورلا عرز اهللاخ مت ،طقف ةعاسلا فصنو نيتعاس ىلاوح ءارجإ دعب ايغامد ىفوتم عربتم نم ةديدجلا ةيلكلا نيب ،ةجسنلأا قباطت نم دكأتلاو ةمزلالا تاصوحفلا تاقفاوملا ىلع لوصحلا دعبو عربتملاو ضيرملا يراصنلأا .د فاضأو .”عربتملا يوذ نم ةمزلالا ةلصحمك يتأي يحارجلا روطتلا اذه نإ“ :لائاق ةلود يف يحصلا عاطقلا يف ريبكلا رامثتسلال لاجم يف تازاجنلإا نم ريثكلا ققح يذلاو ،رطق ثيح نم ىضرملل ةمدقملا ةيحصلا ةياعرلا تامدخ لاجم يف تادجتسملا ثدحلأ عاطقلا اذه ةبكاوم ةيملاعلا ريياعملا ىقرأب مازتللااو ةحارجلاو بطلا .”اهيلع فراعتملا ةعرس ىلع قوزرم وبأ رمع روتكدلا دكأ هرودب ةيحارجلا ةيلمعلا ءارجإ دعب ءافشلل ضيرملا لثامت دعب يشملا عاطتسا ثيح ،توبورلا قيرط نع لصاوتو ،ةيحارجلا ةيلمعلا ءارجإ نم طقف نيموي ةيعيبطلا اهفئاظوب مايقلا ةعورزملا ىلكلا نم ضيرملا ةعباتم متي ثيح يجيردت لكشب لضفب كلذ عجريو ،ةرمتسم ةروصب ءابطلأا لبق ايازملا نم ديدعلا رفوت يتلا ةيتوبورلا ةحارجلا ليلقتو تافعاضم ثودح ةروطخ ليلقت اهمهأ ىلإ ةعيرسلا ةدوعلاو ىفشتسملاب ةماقلإا ةدم ضفخ ىلإ ةفاضلإاب ،ةيعيبطلا ةايحلا ةسرامم دعاسي ام ،ىندلأا دحلا ىلإ مدلا نادقف لدعم مسجلا فئاظو ةداعتساو يفاعتلا ةعرس ىلع .ضيرملا ةايحل ةيعونلا ةدوجلا نيسحتو ةيعيبطلا نأ يناعلا رمع روتكدلا دكأ ،هتاذ قايسلا يفو ىلكلا ةعارز تايلمع يف توبورلا مادختسا نم قوبسم ريغ اردق رفوي ثيح امهم ارمأ تاب ربكأ ةردقو ةيحارجلا ةيلمعلا ءارجإ دنع ةقدلا ةيومدلا ةيعولأل قيقدلا طبرلاو ،مكحتلا ىلع ةيؤر ريفوت للاخ نم كلذو ةساسحلا ةجسنلأاو ىلإ ةفاضلإاب ،ةقدلا ةيلاعو داعبلأا ةيثلاث ةربكم لكشب حارجلا اهب مكحتي ةيلصفم ةيتوبور عرذأ ىلع اضيأ ةيتوبورلا ةحارجلا دعاست امك ،لماك عربتملاو ضيرملا مسجب ةريغص قوقش ثادحإ صرف ليلقت ىلإ يدؤي ام ةيديلقتلا ةحارجلاب ةنراقم مللأاب ساسحلإا ليلقتو ةطيحملا ةجسنلأا ةباصإ .ةيلمعلا ءارجإ دعب قيرفلاو يراصنلأا هللا دبع روتكدلا برعأ هبناج نم دمحم نانح ةروتكدلل قيمعلا مهريدقت نع يحارجلا ةسسؤم ماع ريدمو ةماعلا ةحصلا ريزو يراوكلا ةيبطلا رداوكلل لصاوتملا اهمعدل ،ةيبطلا دمح تاينقت نم ديدج وه ام لك ميدقت ىلع اهصرحو اذه يف نيصتخملا تاربخو فراعم ريوطتو ةيبط ةيحصلا ةياعرلل ةدوج لضفأ ريفوت لجأ نم لاجملا ةياعر لضفأ ريفوتب ةسسؤملا مازتلا عم ايشامت .اهاضرم نم ضيرم لكل ةلاعفو ةيناحو ةنمآ




2024 )رايأ( ويام l 42 ذنم نمزم يولك لشف نم نياعي ناك ،رمعلا نم عباسلا دقعلاب ضيرلم رطق ةلودب لىكلا ةعارزل ةيتوبور ةحارج لوأ ةيبطلا دمح ةسسؤم في تيرجأ ةيلمعلا تيرجأ .مدلا طغض عافترا لثم ىرخأ ةيحص لكاشم لىإ ةفاضلإاب ،يموي لكشب نطبلا قيرط نع يولكلا ليسغلا ءارجإ بلطت مام تاونس ةدع ةيبطلا ةرادلإا سيئر ،يراصنلأا هللا دبع روتكدلا ةدايقب ءاضعلأا ةعارزو ةيتوبورلا ةحارجلاب صصختم قيرف يديأ لىع ماعلا دمح ىفشتسبم ةيحارجلا لوأ يراشتسا -قوزرم وبأ رمع روتكدلا نم لك ةكراشبمو ،ضيرملل ةيحارجلا ةيلمعلا ىرجأ يذلا يحارجلا قيرفلا سيئرو ةيبطلا دمح ةسسؤبم مسق سيئر بئانو ءاضعلأا ةعارز لوأ يراشتسا ليع رمع روتكدلاو ،ةيبطلا دمح ةسسؤبم ةيحارجلا ثاحبلأا مسق سيئر بئانو ةيتوبورلا ةحارجلا .ةيبطلا دمح ةسسؤبم ءاضعلأا ةعارز ةحارج لوأ يرجت ةيبطلا دمح ةسسؤم رطق ةلودب لىكلا ةعارزل ةيتوبور يراصنلأا هللا دبع روتكدلا قوزرم وبأ رمع روتكدلا نياعلا رمع روتكدلا ةيبط تاسسؤم




45 l 2024 )رايأ( ويام اهتدايع ةطشنأ ةيبطلا دمح ةسسؤم تمتتخا يتلاو ينليس ةقطنم في مييختلا مسولم ذنم مسولما اذهل مييختلا ةترف ةليط ترمتسا مسوم ءاهتنإ ىتحو ضيالما برمفون رهش ةيادب ثيح ،لياوتلا لىع ةشرع ةعبارلا ةنسلل مييختلا مهتلبقتسا نيذلا ليماجلإا ينعجارلما ددع غلب ةبارق مييختلا مسوم للاخ ةيبطلا دمح ةدايع .تايسنجلاو رماعلأا ةفاك نم اعجارم 1260 لاصتلاا سيئر ،ليهلا دمحم نسح ديسلا لاق عورشم ريدمو ةيبطلا دمح ةسسؤمب يسسؤملا ىعست ةيبطلا دمح ةسسؤم نإ ،نيليس زكرم اهمازتلا للاخ نم كلذو اهروهمج ةمدخل امئاد مييختلا مسومل ةيبطلا ةدايعلا حاتتفاب يونسلا ىلع ةيحصلا اهتامدخ ميدقتو ،نيليس ةقطنمب ةيسيئرلا ةيجلاعلا ةياعرلا ةهج اهرابتعاب هجو لمكأ .رطق ةلود يف ةيبطلا رداوكلا ليهلا دمحم نسح ديسلا ركش دقو يف ةلثمتملا مييختلا مسوم نيمأت يف ةكراشملا ؛نييرادلإاو ،فاعسلإا ةمدخو ،نيضرمملاو ءابطلأا اهمعد ىلع ةئيبلاو ةيدلبلا ةرازو دوهج نمث امك ناكم صيصخت يف اميس لا رمتسملاو مئادلا ةهجاو يف دارفلأا نم ابيرق نوكي ثيحب ةدايعلل .ةريخلأا تاونسلا يف لاحلا وه املثم ئطاشلا ،رمع دمحم باتفأ روسيفوربلا داشأ ىرخأ ةهج نم ةيبطلا دمح ةسسؤمب ئراوطلا ماسقأ سيئر مسومل ةيبطلا دمح ةدايع نع يبطلا لوؤسملاو تناك يتلا ةدايعلا تامدخب نيليس يف مييختلا ئطاشلا يداترم نم نيعجارملا ةمدخل ةصصخم تماق يتلاو نيليس ةقطنمب مييختلا يداترمو لمعلا ةطخ نمض ةمزلالا ةيحصلا تامدخلا نيمأتب ئراوطلا مسق نأ ىلا تفلو ؛ةدايعلا يف ةررقملا اناك ةيبطلا دمح ةسسؤمو ةركولا ىفشتسمب ىضرملا لابقتسلا دادعتسلاا ةبهأ ىلع اضيأ .ةريطخلاو ةلجاعلا تلااحلا يف نيباصملاو رذحلا يخوت ةيمهأ ىلع باتفأ روسيفوربلا دكأ امك هابتنلاا عم سقطلا ةلاح ىلع ةئراطلا تاريغتلا نم ماعلا اذهل مييختلا مسوم للاخ اعجارم 1260 ليجست مسولم ةيبطلا ةدايعلا ةطشنأ متتخت ةيبطلا دمح ينليس ةقطنبم مييختلا ليهلا دمحم نسح ديسلا رمع دمحم باتفأ روسيفوبرلا يرلما حراقلما حلاص ديسلا


2024 )رايأ( ويام l 44 ةيبط تاسسؤم ناطسرلا ثاحبأو جلاعل ينطولا زكرلما قلطأ ةديدج ةيجلاع ةمدخ ةيبطلا دمح ةسسؤلم عباتلا نم يدثلا ناطسرو اتاتسوبرلا ناطسر ضىرلم نقح مهئاطعلإ ينيرطقلا تاديسلاو لاجرلا مهلزانم في مهل ةررقلما ئيايميكلا جلاعلا كلذو ،زكرملل عبات بردم ضييرتم قيرف للاخ نم زكرلما لىا مودقلا ءانع ضىرلما لىع فيفختلل ةررقلما اهديعاوم في نقحلا هذه لىع لوصحلل .مهنم لكل ةيجلاعلا ةطخلا قفو يذيفنتلا سيئرلا ،نسحلا ملاس دمحم روتكدلا دكأ ثاحبأو جلاعل ينطولا زكرملل يبطلا ريدملاو دمح ةسسؤمب ناطرسلا تامدخ سيئرو ناطرسلا ةيئايميكلا تاجلاعلا دحأ ميدقت يف ءدبلا ،ةيبطلا ،ناضمر رهش ةيادب يف مهلزانم يف ىضرملا ىلإ 2023- ناطرسلل ةينطولا رطق ةطخل ادانتسا ضعبل ةيلزنملا ةياعرلا ريفوت نمضتت يتلاو 2026 روتكدلا مدقت ثيح ،ناطرسلا ىضرم تلااح ريمأ ومسلا بحاص ةرضح ىلإ ركشلاب نسحلا ةحاتلإ كلذو ةديشرلا ةموكحللو ىدفملا دلابلا نيميقملاو نينطاوملل ناطرسلا تاجلاع عيمج ريفوت ةردابم ذيفنت مت هنأ ىلإ اتفلا ،لباقم نودب لزانملا يف ىضرملل يئايميكلا جلاعلا نقح راشأو .ةماعلا ةحصلا ريزو ةداعس نم هيجوتب اذه ميدقت متي نيذلا ىضرملا نأ نسحلا روتكدلا يحيرط اونوكي نأ طرتشي مهل يلزنملا جلاعلا 65 مهرامعأ زواجتت نيذلا ىضرملا نم وأ شارفلا لوصولا نوعيطتسي لا نيذلا ىضرملا وأ ،اماع جلاعلا ريفوت متيل ،جلاعلا يقلتل ىفشتسملل فاضأو .طقف ةياعرلا ميدقت سيلو لزنملاب مهل نوكم يبط قيرف صيصخت مت هنأ نسحلا روتكدلا ،هلزنم يف ضيرملا ةرايزل نيضرممو ءابطأ نم يف نقحلاب جلاعلا ميدقت فدهب ةلاحلا مييقتو متي يلزنملا جلاعلا نأ ىلإ اريشم ،ضيرملا لزنم انأدب“ :لائاق ،عوبسلأا مايأ نم تبس لك هميدقت ءزجك ناطرسلا ىضرمل يلزنملا جلاعلا ميدقتب فدهت يتلاو ناطرسلل ةينطولا رطق ةطخ نم دقو ،رطق يف ناطرسلا ىضرم عيمج جلاع ىلإ لزانملا يف يئايميكلا جلاعلا ةمدخ نم دافتسا ناطرسو يدثلا ناطرس ىضرم نم اضيرم 40 ءلاؤه لكل جلاعلا ميدقت يف انحجنو ،اتاتسوربلا صلختن ةوطخلا هذهبو ،مهلزانم يف ىضرملا يهو ،اهيلع لمعلا يرجي يتلا تايدحتلا دحأ نم ةبغر وأ زكرملل روضحلا ىلع نسلا رابك ةردق مدع .”ايلزنم جلاعلا يقلت يف ضعبلا ةيلبقتسملا ططخلا نمض هنأ نسحلا روتكدلا دكأو جلاعلا نم عونلا اذه ميدقتل ىعسي زكرملا نإف نأو ناطرسلا ىضرم عيمجل يموي لكشب يلزنملا نم يذلا رملأا ،ناطرسلا نم ىرخأ عاونأ لمشت لوصولا ءبع ناطرسلا ىضرم نع فيفختلا هنأش نأ ىلإ اريشم ،جلاعلا يقلتل ىفشتسملا ىلإ زكرملا أدب ناطرسلا ىضرمل ىرخأ ةمدخ كانه جلاعلا ميدقت ةمدخ يهو ماع ذنم اهميدقتب مهجمارب تهتنا نيذلا نسلا رابك ىضرملل يلزنملا ثيح ةيفيطلت ةيجلاع ةلحرم يف مهو ةيجلاعلا ،تاحرقتلاو حورجلا ديمضت ةيلزنملا ةرايزلا لمشت .ةيضيرمتلا ةياعرلاو ملالآا فيفختو ةدايزل ةريثك اططخ كانه نأ نسحلا روتكدلا فاضأو نأ ىلع ادكؤم ،ناطرسلا تاجلاع ةدوجو ةيعون فدهت 2023-2026 ناطرسلل ةينطولا رطق ةطخ ايجولونكت دامتعاو ،ةيلاحلا تامدخلا ةدوج زيزعت ىلإ ةينطو جمارب لاخدإو ،ىضرملل ةقيدصو ةركتبم .رطق يف ناطرسلا نع ركبملا فشكلل ةديدج زكرملاب ةيجراخلا تادايعلا يعجارم ددع نأ ركذي 6 يلاوح غلبي ناطرسلا ثاحبأو جلاعل ينطولا ةيرودلا ةعباتملا تلااح لمشت ايرهش عجارم فلاآ .ةديدجلا ةيضرملا تلااحلاو ةيبطلا دمحل عباتلا ناطسرلا ثاحبأو جلاعل ينطولا زكرلما مهلزانم في ناطسرلا ضىرلم ةديدج ةيجلاع ةمدخ قلطي نسحلا لماس دمحم.د


47 l 2024 )رايأ( ويام مسق سيئر ،ديس ملاغ روتكدلا حضوأ هتهج نم نإ“ :لائاق ةيبطلا دمح ةسسؤمب يوونلا بطلا ىضرمل ديدج جلاع ميدقتب ارخؤم أدب مسقلا جلاعلا نأ انيبم ،رطق يف ةرم لولأ ناطرسلا يعاعشلإا عبتتلاب جلاعلا مساب ةداع فرعي ديدجلا تاديون ىلع يوتحت ةنقح ضيرملا ءاطعإ متي ذإ .ةيناطرسلا ايلاخلا ىلإ عاعشلإا ليصوتل ةعشم جلاع يف يوونلا بطلا مادختسا لوح لولأا عونلا نأ ملاغ روتكدلا حضوي ،تاناطرسلا مت نيذلا ىضرملل هؤاطعإ متي جلاعلا اذه نم ةيبصعلا ءامصلا ددغلا ماروأب مهتباصإ صيخشت اذه نم ديفتسيو ،مسجلا يف ترشتنا يتلا اماع 18 نع مهرامعأ ديزت نيذلا ىضرملا جلاعلا عونلا امأ ،ىرخلأا تاجلاعلا حاجن مدع لاح يف روكذلا ىضرملل ىطعيف جلاعلا نم يناثلا يف رشتنملا اتاتسوربلا ناطرسب نيباصملا .ينومرهلا جلاعلل اوبيجتسي مل نيذلاو مسجلا جلاعلا قرط تحبصأ“ :لائاق ملاغ روتكدلا فاضأو ،ناطرسلا ىضرمل ةمدقملا ةياعرلل ارايعم ةديدجلا لاجملا اذهب ةينعملا ةيلودلا تامظنملا يصوتو ةباجتسلاا مدع لاح يف قرطلا هذه مادختساب هذه دامتعا للاخ نمو .ةيديلقتلا جلاعلا قرطل ةسسؤم يف اناضرمل ةمدقتملا ةيجلاعلا قرطلا اءزج نلآا يوونلا بطلا مسق حبصأ ،ةيبطلا دمح ئدابملا قيبطتب ةمزتلملا ةيملاعلا ةكبشلا نم ةملاسو ،ةينفلاو ةيريرسلا ةربخلا نأشب ةيهيجوتلا .”ةعشلأا نم ةيامحلاو ىضرملا تاجلاعلا لاخدإ عم هنأ ملاغ روتكدلا حضوأ امك ىضرملا ناكمإب حبصأ ،مويشيتوللا ىلع ةدمتعملا ىلع ةرطيسلل جلاعلا ةريسم يف رارمتسلاا نلآا ءامصلا ددغلا ماروأ ىضرمل اصوصخ ناطرسلا حجنت مل نيذلاو اتاتسوربلا ناطرسو ةيبصعلا ذإ ،مهجلاع يف ةيئايميكلا وأ ةينومرهلا تاجلاعلا لكش ىلع ةديدج ةيجلاع ةصرف نلآا مهيدل حبصأ ةحفاكم أدبت ذإ ،عيباسأ 8 - 6 لصافب تاعرج 6 - 4 ظحلاي تقولا رورم عمو ىلولأا ةعرجلا عم ضرملا .مهتلااح ىلع ريبك نسحت ءابطلأا حجنت لا نيذلا ىضرملا نم ددع كانه“ :فاضأو نم وحنب مهددع ردقي ةعئاشلا جلاعلا تارايخ مهعم ةيبصعلا ءامصلا ددغلا ماروأب نيباصم ىضرم 10 - 8 اتاتسوربلا ناطرس ىضرم نم اضيرم 16 ىلاوحو ءلاؤه عضخيل ةصرفلا نلآا دجوت ثيح ،ماع لك يف ةيبطلا دمح ةسسؤم يف ديدجلا جلاعلل ىضرملا .“ جراخلل رفسلا ىلإ ةجاحلا نود ىضرم ةعبرأ ليجست مت هنأ ملاغ روتكدلا راشأو ربمتبس ذنم ةيبصعلاءامصلا ددغلا ماروأب نيباصم ىقلتو ةيجلاع تاعرج عبرأ مهدحأ ىقلت ،2023 .مهنم لكل تاعرج 3 نيرخلآا ةثلاثلا ناطرسب نيباصم نيضيرم ليجست مت امنيب ىلع امهنم لك لصحو 2024 رياربف ذنم اتاتسوربلا ىضرملا عيمج نأ ادكؤم .ديدجلا جلاعلا نم نيتعرج نونسحتي مهنإف ةيربخملا جئاتنلل اقفوو .ريخب جلاعلل ةريبك ةيبناج راثآ يأ مهيدل أرطي ملو ،ايريرس ررقملا نمو .ةعجشم اهنأب ةيلولأا جئاتنلا اربتعم ءاهتنلاا دعب ضيرم لكل لصفم ةباجتسا ليلحت ءارجإ ةملاس نم دكأتلل ديدجلا جلاعلا نم تارود عبرأ نم .مهل ةمدقملا ةيبطلا ةياعرلا ةدوجو ىضرملا



2024 )رايأ( ويام l 46 ءانثأ عفدلا ةيعابر تاجاردلا لامعتسا دنع امئاد .ةمداقلا مساوملا يف مييختلا تارتف ،يرملا حراقملا حلاص ديسلا دافأ قايسلا اذه يفو طيطختل فاعسلإا تامدخل يذيفنتلا ريدملا دعاسم نأ ،ةيبطلا دمح ةسسؤمب تايلاعفلاو ئراوطلا مسوم يف مئاد لكشب تدجاوت فاعسلإا ةمدخ نيتيدايتعا فاعسإ يترايس ريفوت ربع مييختلا حضوأو .يعابر عفد فاعسإ يترايس ىلإ ةفاضلإاب تلبقتسا ةدايعلا نأ يرملا حراقملا حلاص ديسلا ،روسكو حورجو طوقسو ثداوح نيب اباصم 816 لكاشمب ةقلعتم ةيضرم ةلاح 444 بناج ىلإ امك ،ةطيسبلا سمشلا قورحو ةيبلقو ةيسفنت ربع تايفشتسملا ىلإ ةئراط ةلاح 629 لقن مت .يوجلا فاعسلإا للاخ نم وأ فاعسلإا تارايس لمعلا ططخل اقبط فاعسلإا رداوك عيزوت مت امك نم افلس ةددحملا ةيمويلا تايلمعلاو ةموسرملا ةرادإب تايلاعفلاو ئراوطلا طيطخت مسق لبق ططخو فادهأ عم ايشامت كلذو فاعسلإا تامدخ ةمدخ تصصخو .نيليس ةقطنمل ةيبطلا ةيطغتلا برقلاب اهرداوكو اهتارايسل اتباث اعقوم فاعسلإا ةكرحتملا تادحولل ةفاضلإاب تاهيلاشلا راود نم حلاص ديسلا برعأ اماتخ .يسيئرلا قيرطلا ىلع ةسسؤمب فاعسلإا ةمدخ رخف نع يرملا حراقملا اهميدقت مت يتلا ةيبطلا تامدخلاب ةيبطلا دمح مييختلا مسوم للاخ نيليس ةقطنم يداترمل تاهجلا لكل ركشلاب هجوت امك ،رهشأ 6 رادم ىلع .مييختلا مسوم للاخ ةدناسملاو ةكراشملا ةيبط تاسسؤم ضىرلم )177 - مويشيتوللا( ةينقتب جلاعلا برع يوونلا بطلا مادختسا ةيبطلا دمح ةسسؤم تأدب يوونلا بطلا مسق في حاجنب جلاعلا ضيرم لوأ ىقلتو .رطق ةلودب ةرم لولأ اتاتسوبرلا ناطسر ضىرلما نم يرثكلا لىع رفويس مام ،ةيبطلا دمح ةسسؤبم ناطسرلا ثاحبأو جلاعل ينطولا زكرلماب .جراخلاب جلاعلا اذه يقلتل رفسلا ءانع ةعشأ ءابطأ ريبك ،يراوكلا ميرم ةروتكدلا تلاقو تاجلاعلا“ :ةيبطلا دمح ةسسؤمب يوونلا بطلا حنمت )177 - مويشيتوللا( ةينقت ىلع ةدمتعملا تارايخ لك اوبرج نيذلا ىضرملا كئلولأ لمأ ةصرف ىلع رييغت يأ أرطي ملو ،ةيديلقتلا تاجلاعلا نيسحت اننكمي تاجلاعلا نم عونلا اذه عم ،مهتلااح ةيبصعلا ءامصلا ددغلا ماروأ ىضرم ةايح ةدوج ةروتكدلا تدكأو .”اتاتسوربلا ناطرس ىضرمو اهللاخ نم نكمي ةديدجلا صيخشتلا ةينقت نأ ميرم ءاطعإ قيرط نع ،يدثلا ناطرس ماروأ صيخشت زاهج ىلع هضرع مث )FES( ةعشم ةدام ضيرملا ىلإ ةريشم ،ةقدب مارولأا عضاوم ديدحتل ريوصتلا ديزملا ميدقت ىلإ ىعست ةيبطلا دمح ةسسؤم نأ مهاسيس امم ةمدقتملا صيخشتلا تاءارجإ نم .جراخلل رفسلا ىلإ ىضرملا ةجاح عجارت يف زاجنلإاب صيخشتلا اذه ميرم ةروتكدلا تفصوو ءابطلأ ةليوط تاونس دوهج مجرتي يذلا يبطلا مارولأا ييراشتساو يوونلا بطلا ييصاصتخاو ةسسؤمب يوونلا بطلا مسقب ةعشلأا يينفو عيمجل ةيبطلا ةياعرلا ريفوت فدهب ةيبطلا دمح .ةسسؤملا يف ناطرسلا ىضرم ناطسر جلاع في يوونلا بطلا مادختسا أدبت ةيبطلا دمح لىولأا ةرملل اتاتسوبرلا ديس ملاغ روتكدلا يراوكلا ميرم ةروتكدلا


65 36 100
@alemadihospital1761 www.alemadihospital.com.qa ﻲﺻﺎﺼﺘﺧا يرﺎﺸﺘﺳاو صﺎﺼﺘﺧا ةدﺎﻴﻋ
alemadi.hospital



2024 )رايأ( ويام l 48 زوين ضايرلا في سورديتو ستيغ ليب ةيلماعلا ةيحصلا ةوجفلا صيلقت ثحبو مهافت ةركذم لجلاجلا دهف يدوعسلا ةحصلا ريزو كراش تايلاعف نمض ةعيفر ةيراوح ةسلج في هتفاضتسا يذلا يلماعلا يداصتقلاا ىدتنلما رابك نم ةبخن ةسلجلا تمض دقو .ضايرلا ةنيدم سسؤم ،ستيغ ليب :مهنم ،ةيلماعلا تايصخشلا نياتسكابلا ءارزولا سيئرو ،تفوسوركيام ةكشر ،سوسيبريغ سورديتو ،فيشر زابهش دمحم .ةيلماعلا ةحصلا ةمظنلم ماعلا ريدلما تاءارجإ ذاختا ةرورض ىلع دكأ يدوعسلا ةحصلا ريزو اياضقلل ةيلبقتسملا تايدحتلا ةهجاومل ةيقابتسا زيزعت ةيمهأ ىلع اددشم ،خانملاب ةقلعتملا ةيحصلا تلااحو ةئبولأا ريثأت نم فيفختلل يلودلا نواعتلا ةنجللا قلاطإ نع لجلاجلا فشك امك .ئراوطلا فدهت يتلاو ،ةفاك تاسايسلا يف ةحصلل ةيرازولا ريياعملا ةاعارم للاخ نم ناكسلا ةحص زيزعت ىلإ .رارقلا عنص تايلمع عيمج يف ةيحصلا يف ةيدوعسلل يروحملا رودلا ىلإ كلذك راشأو نم ايلاخ ملاعلا نلاعإ لجأ نم ايملاعو ايميلقإ لمعلا تاداضم ةمواقم راطخأ نم ارذحم .لافطلأا للش يذلا ”تماصلا ءابولا“ ـب اهفصوو ،تابوركيملا .هتحفاكمل ايلود ادهج بلطتي ةحصلا نيب مهافت ةركذم عيقوت نع لجلاجلا نلعأو فدهت ستيغ ادنيلمو ليب ةسسؤمو ةيدوعسلا ضارملأا ةبقارم لثم تلااجم يف نواعتلا زيزعت ىلإ معدو ،ةنمآ ةيحص لولح ريفوتو ،صيخشتلا تاودأو .تاحاقللا ةعانص امعد تمدق ةيدوعسلا ةيبرعلا ةكلمملا نأ ركذي ”يفاج“ نيصحتلاو تاحاقلل يملاعلا فلاحتلل ايوق فلاحتلا تاردابم نم اهريغو سكافوك قفرمو ةشاشه رثكلأا ةيحصلا ةمظنلأا نيكمتل ،ىرخلأا .اهناكس نيصحت نم ملاعلا يف يف ةلود 26 نم رثكلأ رشابملا معدلا تمدق امك يف ترمثتساو ،يحصلا اهماظن نيسحت ليبس .يكريمأ رلاود نويلم 900 نم رثكأ كلذ



ضايرلا في ”ةيحصلا ةحايسلا لبقتسم“ ىقتلم ةيحصلا ةياعرلاو ةحايسلا تاعاطق في ةيرماثتسلإا صرفلا ضرع لبقتسم“ ىقتلم لماعأ ضايرلا ةنيدم تدهش ةحايسلا يدان نم ميظنتب ”ةيحصلا ةحايسلا ةكاشرلاب ةيحصلا ةحايسلا ةيعمجو ،ةيحصلا فدهب ،ةيحصلا ةحايسلل يلماعلا سلجلما عم تاعاطق في ةيرماثتسلإا صرفلا فاشتكا ،ةديدجلا تاهجولاو ةيحصلا ةياعرلاو ةحايسلا .تايدحتلا ةهجاومو ةيحصلا تاهجوتلا زيزعت ىلع ىقتلملا صرح عاطقلا اذه يف اهتلاسرو اهتيؤر لاصيإو ةكلمملل ةيسيئر ةهجو ةكلمملا لعج ىلإ لوصولا وحن ،ماهلا يميلقلإا نيديعصلا ىلع ةيحصلا ةحايسلا يف ،ةحومط ةيؤر قيقحت ىلإ ةفاضلإاب ،يملاعلاو يف ةدئارلا ةهجولا ةكلمملا لعج يف لثمتت ،ملاعلاو طسولأا قرشلا يف ةيحصلا ةحايسلا ريوطتلاو راكتبلإل ةزفحم ةئيب ءاشنإ ىلع زيكرتلاو .ةيحصلا تامدخلا ريوطت يف مهست ةكارشلاو نواعتلا زيزعت ىلع لمعلاب ىقتلملا زكرو ةكلمملا لعجو ،صاخلاو يموكحلا نيعاطقلا نيب نم صاخلاو يموكحلا نيعاطقلل لااعف ادصقم ةدافتسلإا نم ىضرملا نيكمتو ،ملاعلا ءاحنأ عيمج .ةيلاعلا ةدوجلا تاذو ةروطتملا ةيبطلا تامدخلا نم ىلإ ”ةيحصلا ةحايسلا لبقتسم“ ىقتلم فده ةحايسلا تاعاطق يف ةيرامثتسلإا صرفلا ضرع ءانب نع لاضف ،ةديدجلا تاهجولاو ةيحصلا ةياعرلاو ،ضايرلا ةنيدم اهرقم ةديدج ةيملاع ةيونس ةصنم ةيحصلا ةحايسلا لاجم يف نيصصختملا بذجو .ملاعلا لوح نم اهب ةطبترملا تاعاطقلاو شروو ،ةيميدقت اضورع ىقتلملا تايلاعف تلمش ،شاقن تاسلجو ،بابشلا نيثحابلل ىدتنمو ،لمع ةيسيئر عيضاوم ةشقانمو ،ةيئانث لمع تاعامتجاو تايدحتلاو ةحاتملا صرفلا فاشكتسا لوح روحمتت لدابت ىلإ ةفاضلإاب ،ةيحصلا ةحايسلاو ةياعرلا يف هيلإ تلصوت ام رخآ ضرعو ،تاربخلاو ةفرعملا .ةثيدحلا ةينهملا ةيحصلا تاسرامملاو تاينقتلا لبقتسم“ ىقتلم نم تاسلج تاعوضوم تعونت زوين جهنملا“ تاعوضوملا تلمشو ،”ةيحصلا ةحايسلا يف ةدايرلا”و ”ةيليمجتلا ةراشتسلإا يف ركتبملا ةيفاعلا يف رامثتسلإا ”و ،“ ةقيمعلا ةحصلا لاجم ةملاعلا انينب فيك ”و ”لاثمك ةماجحلا ..ةحصلاو يف يبطلا ليمجتلا لاجم يف ةدئارلا ةيراجتلا يف ةروثلا”و ،”طقف تاونس 3 للاخ ارسيوس ىلإ ةفاضإ ،”ةيحارجلا لولحلا ريغ ..يلاودلا جلاع ثيدحلا بطلا يف يعانطصلاا ءاكذلا مادختسا “ ىقتلملا تاسلج تلوانت امك .“ صيخشتلاو تايفشتسملا يف ةيلودلا تايلمعلا سسأ“ ةداهش“و “تاسرامملا لضفأو نييلودلا ىضرملل ،”ةيبطلا ةحايسلا لاجم يف تامدخلا ةدوج ..لماكتملا ليهأتلا ةداعإو يعيبطلا جلاعلا”و .”ليغشتلاو ءانبلاو جلاعلا ةيفيك ةحايسلا لبقتسم“ ىقتلم دهش ىرخأ ةهج نم تايقافتلإا نم ددع عيقوت لامعأ نمض ”ةيحصلا نيب نواعتلا زيزعت فدهب مهافتلا تاركذمو فادهأ قيقحتل لاوصو ،ةكراشملا تاعاطقلا ةيحصلا ةحايسلا ةيعمج لبق نم مظنملا ىقتلملا .ةيحصلا ةحايسلل يملاعلا سلجملا عم ةكارشلاب لمعي ”ةيحصلا ةحايسلا لبقتسم“ ىقتلم نأ ركذي لامعلأا عاطق معدل ةزيمتم ةيتحت ةينب ريفوت ىلع ماهسلإاو ،لاجملا اذه يف ثاحبلأاو تاساردلاو ،2030 ةكلمملا ةيؤر فادهأ قيقحت يف لعافلا ةيحصلا ةحايسلا يف ةدئار ةهجوك اهرود زيزعتو .يملاعلاو يلحملا نيديعصلا ىلع 2024 )رايأ( ويام l 50

NEW IMAGING HORIZONS.
Featuring a large gantry aperture, the NewTom 7G is the most advanced CBCT device on the market. From in-depth detail to the big picture.

ULTRA-DETAILED MULTI-DIAGNOSTICS
Localised analysis over the entire body. Ray2D and 3D imaging up to 90 µm, also with radiocontrast agent. Artifact reduction and movement analysis using CineX and Cine-Scout. The eXtra Functions protocol extends the field of view longitudinally to analyse anatomical structures such as the spine and limbs.
TECHNOLOGICAL EXCELLENCE
High power generator (120 kV – 20kW). High-sensitivity 3D panel and innovative algorithms for volumetric reconstruction. 77 cm gantry aperture.
ERGONOMICS AND PRACTICALITY
Fully motor-powered table and 10” touch-screens, front and rear. Optimised examination flow thanks to certified NNT software with processing, sharing and RIS/PACS connectivity functions.
MAXIMISING PATIENT CARE
The patient lies comfortably on the table and X-ray doses are always proportioned to the patient’s build and the examination type thanks to SafeBeamtm technology.
WIDE .VISION NEWTOM 7G www.newtom.it

2024 )رايأ( ويام l 52 بيد في يبطلا وصنميلك زكرم ىفشتسم ةيلودلا ةيبطلا زنكبوه زنوج ىفشتسم نم نيزراب ءابطأ فيضتسي يبطلا وصنميلك زكرم ىفشتسم فاضتسإ زنكبوه زنوج ىفشتسم نم نيزراب ينبيبط بيد لوب .دو بريخم ليمإ .د ماهو ةيلودلا ةيبطلا نيرئازلا ءابطلأا جمانرب ةيقافتا نمض نوسندنلا ةيبطلا زنكبوه زنوج ىفشتسم عم نواعتلاب .ةيلودلا يبطلا وصنميلك زكرم ىفشتسم مازتلا راطإ يف ةيملاع ةيحص ةياعر تامدخ ميدقتب رمتسملا يبد ةيبطلا تاسسؤملا عم نواعتلا زيزعتو ىوتسملا ايرثأ نيذللا نيبيبطلاب بيحرتلا مت ،ةقومرملا اهابستكا يتلا ىؤرلاو تاربخلاب ىفشتسملا ةيبطلا زنكبوه زنوج ىفشتسم يف امهلمع نم ةياعرلا لاجم يف ايملاع ةدئار ةهج يهو ،ةيلودلا .يبطلا ميلعتلاو ةيحصلا ةيئانثتسلاا هتامهاسمب افورعم ربيخم ليمإ .د ام يف اميس لاو ،باصعلأا بط لاجم يف ةيروثلاو .نوسنكراب ضرمو ةكرحلا تابارطضا ةجلاعمب قلعتي يبطلا عمتجملا يف ةعساو ةرهش ىلع زاح دقو ىلع هدامتعاو ،ىضرملا ةياعر يف هينافت لضفب .ةركتبم ةيجلاعو ةيصيخشت تاينقت ريبك ريدقتب نوسندنلا لوب .د ىظحي ،لثملاب ،ءامصلا ددغلا بط لاجم يف زيمتملا هلمعل ىلجتي ثيح ،ةيقردلا ةدغلا ضارمأ يف اديدحتو زوين نيسحتو ةيبطلا ةفرعملا ريوطتب خسارلا همازتلا هتامهاسم للاخ نم حضاو لكشب ىضرملا جئاتن .بطلا لاجم يف ةظوحلملا هتازاجنإو يبطلا وصنميلك زكرم ىفشتسمل امهترايز للاخ نوسندنلا لوب .دو ربيخم ليمإ .د كراش ،يبد تاسلج يف اكراش امك ىضرملا جلاع يف قيرفلا عم ةينواعتلا تاشقانملاو ةفرعملا لدابتل مازتلا ززع امهروضحف .ىفشتسملا يف يبطلا راكتبلااو رمتسملا مدقتلاو روطتلاب ىفشتسملا .ةيحصلا ةياعرلا ميدقت يف زيمتلاو ةرادإ سلجم سيئر حرص ،ةبسانملا هذه يفو ديسلا ،يبد يبطلا وصنميلك زكرم ىفشتسم نأ انفرشي“ :لائاق ،بحاصناخ زيزعلا دبع نمحرلادبع ىفشتسم نم نوسندنلا .دو ربيخم .د فيضتسن يه ةرايزلا هذهف .ةيلودلا ةيبطلا زنكبوه زنوج ةفرعملا ريوطتب كرتشملا انمازتللا ساكعنا راكتبلاا ةلجع عفدو ىضرملا ةياعر زيزعتو ةيبطلا ةوطخلا هذه ديعت ثيح ،ةيحصلا ةياعرلا لاجم يف ىفشتسمب انعمجت يتلا ةيوقلا ةكارشلا ديكأت امهتكراشم مهاستو ،ةيلودلا ةيبطلا زنكبوه زنوج يف يبد يبطلا وصنميلك زكرم ىفشتسم يف ىلإ يبد ليوحت يف لثمتملا انحومط قيقحت قرشلا يف ةيحصلا ةياعرلا لاجم يف ةدئار ةهجو .”طسولأا ،يعورزملا فيس ءايلع .د تلاق ،اهتهج نم وصنميلك زكرم ىفشتسمل ةيذيفنتلا ةسيئرلا .دو ربيخم .د ةدوع اندعست“ :يبد يبطلا يبطلا وصنميلك زكرم ىفشتسم ىلإ نوسندنلا ىفشتسملا مازتلا ةوطخلا هذه دسجت ذإ ،يبد اهلاكشا ةفاكب ىضرملا تاجايتحا ةيبلتب مئادلا نع لاضف ،يبد يف ةيبطلا تايدحتلا ةهجاومو ةياعرلا لاجم يف ةدوجلا تايوتسم ىلعأ ريفوت ىؤر يبطلا انقيرف بستكيس نيح يفو .ةيحصلا نيديفتسملا نأ لاإ ،ةعساولا امهتربخ نم ةميق ةبرجت ىلع نولصحيس نيذلا ىضرملا مه نييلعفلا ”.ةديرف ةيبط وه يبد يبطلا وصنميلك زكرم ىفشتسم سلجم لود يف ديحولا صاخلا ىفشتسملا رئازلا بيبطلا جمانرب مدقي يذلا يجيلخلا نواعتلا ةيبطلا زنكبوه زنوج ىفشتسم عم نواعتلاب 2022 ويام 9 يف ةيقافتلاا عيقوت ذنمو .ةيلودلا يبطلا وصنميلك زكرم ىفشتسم فاضتسا :يهو ،ةفلتخم تاصصخت 6 يف ءابطلأا رابك يبد ،)ةيميمرتلا ةحارجلاو مارولأا ةحارج( يدثلا ةحارج ،)ةقيردلاو ةيقردلا ةدغلا( ءامصلا ددغلا بطو ةحارجو ،)ةكرحلا تابارطضا( باصعلأا بطو بطو ،)ةبكرلاو كرولاو فتكلا( لصافملاو ماظعلا ضارمأو يسنجلا فعضلا( ةيلوبلا كلاسملا .يرقفلا دومعلا ةحارجو )ىلكلا تاوصح

55 l 2024 )رايأ( ويام


2024 )رايأ( ويام l 54 زوين تاعاترخلال ليودلا فينج ضرعم في زئاوجلا نودصحي ةمركلما ةكم ءابطأ ةيحصلا تاراكتبلاا لماع في مهتداير نوتبثي نويدوعسلا يحصلا ةمركلما ةكم عمجت ءابطأ قيرف ققح تاعاترخلال ليودلا فينج ضرعم في ايخيرات ازاجنإ ةيزنوربو ةيضفو ةيبهذ زئاوج دصح ثيح ،2024 .اهب كراش يتلا ةسمخلا تاعاترخلاا عيمج في ةبترم عم ةيبهذلا ةيلاديملا تازاجنلإا تلمش فتكلا لصفمل رركتملا علخلا جلاع عارتخلا فرشلا عارتخلا ةيبهذلا ةيلاديملا ؛جارس قيفوت روتكدلل ىلإ يئايميكلا جلاعلا لقنل ونانلا ةينقت مادختسا ؛يناتسكرت ميرم ةروتكدلل ةيناطرسلا ايلاخلا مدلا كونبل ةيكذلا ةجلاثلا عارتخلا ةيضفلا ةيلاديملا عارتخلا ةيضفلا ةيلاديملا ؛يريرك ماستبإ ةذاتسلأل ؛فيرشلا دمحأ روتكدلل يكذلا يسفنتلا زاهجلا ظفحل نرملا ءاطغلا ةرتس عارتخلا ةيزنوربلا ةيلاديملا اذه دعي .ينايبذلا دمحأ روتكدلل ضيرملا ةيصوصخ ةبوؤدلا ةيدوعسلا ةحصلا دوهج ىلع ةداهش زاجنلإا امك .يملعلا ثحبلاو راكتبلاا معدو عاطقلا ريوطتل اهتردقو ةيدوعسلا ةيبطلا رداوكلا ةءافك ىلع دكؤي ةايحلا ةدوج نيسحت يف مهاست تاعارتخا زاجنإ ىلع .ملاعلا ءاحنأ عيمج يف ىضرملل ةيدوعسلا كوبت ةيلماعلا ةحصلا ةمظنم نم ”ةيحص ةنيدم“ فيصوت ققحت نم »ةيحص ةنيدم« ةداهش كوبت ةنيدم تدصح اهئافيتسا دعب كلذو ،ةيلماعلا ةحصلا ةمظنم حبصيل ،ةيلودلا ةمظنلما يرياعم نم ارايعم 80 ـل ةيدوعسلا لجس لىإ فاضي اديدج ازاجنإ كلذب .ةماعلا ةحصلا لاجم في لفاحلا دوهج ةرمث ةداهشلا هذه ىلع كوبت لوصح دعي ريزو دكأ ثيح ،ةددعتم ةيمسر تاهج نم ةرفاضتم كوبت لوصح نأ لجلاجلا دهف يدوعسلا ةحصلا ةدايقلا مامتها سكعي »ةيحص ةنيدم« ةداهش ىلع عيمج يف ةماعلا ةحصلا زيزعتو ةايحلا ةدوج نيسحتب ندملا جمانرب نأ ىلإ لجلاجلا راشأو .دلابلا ءاحنأ نيسحت يف ادئار اجذومن دعي ةحصلا ةرازوب ةيحصلا اركاش ،ةنمزملا ضارملأا نم دحلاو ةحصلا تارشؤم .زاجنلإا اذه قيقحت يف تمهاس يتلا تاهجلا عيمج ندملا جمارب لاجم يف ةدئار ةيدوعسلا دعتو ةيحصلا ندملا نم ددع ربكأ مضت ثيح ،ةيحصلا يف ةيحص ةنيدم 15 عقاوب ،ميلقلإا يف ةدمتعملا .قطانملا فلتخم
Temples

Under-eye
Nose
Nasolabial folds
Lips
Neck lines
Cheekbones
Jawline
Chin
FINE:
Treats fine lines on face and neck
DEEP: Treats deep wrinkles and gives volume
SUB-Q:
Contours and shapes the face
CE Marked Monophasic (highly viscous homogeneous cohesive gel with low risk of migration)
0.3% Lidocaine on top of the 1.1 ml
Highly purified HA concentration

Stable and consistent extrusion force





Cancer treatment plans built around you.
Our experts get to know you, then tailor treatments to help fit your needs—which could include radiation, surgery, chemotherapy, immunotherapy, cellular therapy, genetic counseling, or a customized lifestyle management plan. In collaboration with Baylor College of Medicine, we’re equipped to pave the way for even more revolutionary discoveries and groundbreaking approaches to cancer prevention, diagnosis, and treatment.
Learn more about the NCI-designated Dan L Duncan Comprehensive Cancer Center at Baylor College of Medicine at stlukeshealth.org/bslmcinternational


59 l 2024 )رايأ( ويام

Beauty and Wellbeing Forum 2024

2024 )رايأ( ويام l 60
ىدتنم حاتتفا يديلقتلا جلاعلاو قيضلا صيخشتلا نع اديعب ينينانبللا لكل لضفا ةايحل ةصرفو عادبإو لماج ةحاسم لىإ ةفاضلإاب مض فيثك لابقإ طسوو ،يربك مخزب نيرثؤلما نم ايربك اددع ،ملاعلإاو ةفاحصلا لهأ ةحصلا تلااجم في ءابرخلاو لصاوتلا عقاوم لىع ةيحصلا تاعجتنلماو ةكرحلاو ةيسفنلاو ةيدسجلا ىدتنلما حاتتفا مت ،ةضايرلا لاجم في ءابرخو Beauty and Wellbeing ناونعب هعون نم لولأا قلعتت ةددعتم تلااجم في صصختلما Forum .ناسنلإا ةايح بناوج لكب توريب يد موروفلا يف هميظنت مت يذلا رمتؤملا يترازو نم ةياعربو 2024 ناسين 21 ىلإ 18 نم تارضاحملا نم اريبك اددع نمضت ،داصتقلإاو ملاعلإا بناوجب ةقلعتملا ةريدتسملا تلاواطلاو تاودنلاو ميدقت ةيحانل اميسلا دارفلأا ةايح نم ةديدع يئاقولا بطلاو شيعلا طمن رييغت لوح ةحيصنلا نع اديعب ناسنلإا ةحصل ةلماشلاو ةديدجلا ةرظنلاو .ةيديلقتلا جلاعلا ةقيرطو ضرملل قيضلا صيخشتلا عم تاءاقلو لاصفم اجمانرب حاتتفلاا لفح نمضت نم لكل حاتتفا تاملك دهشو ،ىدتنملا ءارفس .نييمسرلاو نيمظنملاو ةاعرلا تلهتسا ،رغاد يدانه ةديسلا ،ىدتنملا ةسسؤم اهيف تحرش ةراح بيحرت ةملكب حاتتفلاا لفح ىلع كلذ رثأ فيكو ىدتنملا ءاشنإ ءارو ببسلا يعس ةجيتن ىتأ ،مويلا هدهشن ام لك نأو اهتايح ملح قيقحتل لماك ماع ةليط لصاوتمو بوؤد .همعن داج روتكدلا سيسأتلا يف اهكيرشو اهدوار يف برحلا مغرو ،انلوح لصحي ام لك مغر“ : تلاقو ىلع نانبل عضن نأو رايتلا سكع ريسن نأ انررق ،نانبل ام ينانبللا“ نأب لوقنل ةيلودلا ضراعملا ةطراخ ”! ولح ىقبي حر ولحلا نانبلو .رسكنيب ام .توميب ةينانبللا ةأرملل ةربعم ةلاسر يف رغاد تمتخو لا .كملاحأ نع يلختت لاو ،يملست لا “ :لوقت ،ملحلاب ةدارلإا يقتلت امدنع ليحتسم ءيش دجوي .”ىدتنملا ةياكح يه هذهو همعن داج .د سسؤملا كيرشلا ثدحت ،هرودب ةيدسجلا ةحصلاو Wellbeing ـلا ةكرح ةيمهأ نع ىتأ ىدتنملا اذه “ :لاقو ةكرحلاو ةيسفنلاو وه قيليو ةايحلا هيف قيلت دلب وه نانبل نأب انركذيل وه ناسنلاا نأب يناميإو ينطول يبح نم .انب لمعلا انررق لضفأ ةايحو قفلأ انتجاحلو ،هيف ةيولوا ناح .اننطو يف ناسنلإا ةحص نيسحت لجأ نم نانبل يف ناسنلإل ةديدج ةدلاو ىلع دهشنل تقولا ناسنلإا ةداعسو ةيسفنلاو ةيدسجلا ةحارلا :اهناونع هذه قلاطلإ بسانملا ناكملا وه ىدتنملا اذهو ينانبللا يضارلأا لك ىلإ لصتس يتلا ةكرحلا ءاطعلإ ملاعلاو يبرعلا ملاعلا وحن دودحلا ربعتسو .”نانبل نع ةروص لمجأ لامعلأا فيرصت ةموكح يف ينانبللا ملاعلإا ريزو يتلا بابسلأا نع ثدحت ،يراكم دايز سدنهملا ىنمتن ”:لائاق ةياعرلا هيطعيو ىدتنملا معدي هتلعج نا لما ىلع حاجنلا لك هيمظنملو ىدتنملا اذهل بوعش لك ىلا لما ةلاسرو ةايحلا دلب نانبل ىقبي ةيهافرلاو لامجلا ةمصاع توريب ىقبت ناو ملاعلا نيرذجتم اهؤانبا ىقبي يكل باعصلا نم مغرلا ىلع ىلع ظفاحن يكلو ليمجلا دلبلا اذهب نيكسمتمو مهئاطعا للاخ نم ةرجهلا حبش مهنع دعبنو انبابش ”.مهدلبب اثبشتو لاما مهديزت ةلثامم اصرف ،رديح وبأ دمحم روتكدلا داصتقلاا ةرازو ماع ريدم امأ ةئيضم ةملاع وه تايدتنملا هذه دوجو نأ دكأف ىلع نيميقلا ركشن نحن “ :لاقو نانبل ءامس يف بعشلل ةديدج ةركف ميدقت هنأش نم ذإ ىدتنملا .”ةيمويلا ةايحلا تاطوغض نم يناعي يذلا ينانبللا بذج يف ةيمهأ لمحت ضراعملا هذه“ :لوقي عباتو اميس ةقثلا ةداعإو دلبلا ىلإ ةيجراخ تارامثتسا ريفوت ىلع دعاسي امم نانبل يف صاخلا عاطقلاب .”ومنلا زيفحتو ةلماع دي صرف قلخو فسوي روتكدلا نانبل ءابطأ بيقن ثدحت ،هرودب Beauty and Well- ىدتنملا ةركف ةيمهأ نع شاخب رشن ةيمهأ ىلع ددشو ، being Forum 2024 يف ،ىدتنملا اذه ةيمهأ يتأت“ :لائاق هلوح يعولا ةيبط ميهافم لوح ةيعوتلا رشن ىلا ىعسن تقو ةيعوت ادج يرورضلا نمو .ناسنلاا ةحص مدخت ةديدع مهبنجي يذلا يئاقولا بطلا ةيمهأ ىلع سانلا ىدتنملا اذه يف اندجو دقو ،ضارملأا نم ديدعلا حئارش طسو هميمعتو ماعلا عفنلا رشنل ةدارلإا كلت ،مهتحصل لضفلأا قيقحت نم مهنكمي ام سانلا ماع لكشب ةيحايسلا ةلجعلا يف مهاسيس كلذك .”صاخ لكشب ةيبطلا ةحايسلاو ماع لكشب ،ىدتنملا سيئر بئان ،نوع جروج روتكدلا امأ ةياغب رمأ ةيسفنلا ةحصلا ىلع زيكرتلا“ :نأ ربتعاف يذلا قيقدلا فرظلا اذه يف اميسلا ةيمهلأا ةدايزل ةبسانم اضيأ وهو .ينانبللا بعشلا هشيعي ةثيدحلا تاجلاعلاو ةيودلأاو ثاحبلأا رخآ لوح يعولا ةفاضلإاب ةثيدحلا ةيبطلا تادعملاو ايجولونكتلاو حورلاو دسجلاو لقعلا يذغي ةايح طمن فاشكتسلا تائفلا لك نمو هترايزل نيينانبللا لك اعدو نآ يف .”ةيرمعلا تايدايقلا تاديسلا ةيعمج ةسيئر تربتعا ،اهرودبو ةبسانم وه موروفلا “ :نأ نلاسر ةحيدم ةديسلا عونت ىلع ،تلائاعلل ،عمتجملا حئارش لكل ةوعدو فرعتتل يتأت نأ يعامتجلاا اهاوتسمو اهلوخدم ةيدسجلا ةحصلا ىلع ظافحلل ةددعتملا قرطلا ىلع سانلا لكل Wellbeing ـلا موهفمف .ةيسفنلاو رثكا فرعيو فشتكيو ملعتي نأب قحلا هل ناسنا لكو .”هتحص ديفي امع زوين
Liquid biopsy in breast cancer – Less invasion more precision
Plasma-SeqSensei™
Liquid biopsy in breast cancer – Less invasion more precision
Plasma-SeqSensei™

The Plasma-SeqSensei Breast Cancer IVD Kit is an NGSbased liquid biopsy assay that focuses on highly sensitive detection of clinically relevant mutations in TP53, ESR1, PIK3CA, AKT1 and ERBB2 from blood plasma.


Learn more about the unique advantages of Plasma-SeqSensei technology
The Plasma-SeqSensei Breast Cancer IVD Kit is an NGSbased liquid biopsy assay that focuses on highly sensitive detection of clinically relevant mutations in TP53, ESR1, PIK3CA, AKT1 and ERBB2 from blood plasma.
High sensitivity at low MAFs
Learn more about the unique advantages of Plasma-SeqSensei technology
Down to 0.06% - 0.07% Mutant Allele Fractions.
High sensitivity at low MAFs
Down to 0.06% - 0.07% Mutant Allele Fractions.
Absolute quantification
Short and standardised workflow
From cfDNA samples to results in two days.
Short and standardised workflow
From cfDNA samples to results in two days.
Data analysis and reporting made easy
Generate report designed for clinicians with just a few clicks.
Absolute quantification
Meaningful comparison of ctDNA levels per millilitre of plasma.
Expert voices
Meaningful comparison of ctDNA levels per millilitre of plasma.
Data analysis and reporting made easy
Generate report designed for clinicians with just a few clicks.

Expert voices

‘We know that tissue samples cannot be taken regularly, but liquid biopsy is easy to take, it is simply a sample of blood. And it gives you real-time information.’


‘Even low levels of ctDNA could have given an indication of the coming progression in the follow-up.’

‘There is much more diagnostic power in the absolute quantification.’

Dr Bhuwnesh Agrawal Member of The Supervisory Board Sysmex Inostics and MD, Germany
‘We know that tissue samples cannot be taken regularly, but liquid biopsy is easy to take, it is simply a sample of blood. And it gives you real-time information.’
Dr Bhuwnesh Agrawal Member of The Supervisory Board
Sysmex Inostics and MD, Germany
‘Even low levels of ctDNA could have given an indication of the coming progression in the follow-up.’
‘There is much more diagnostic power in the absolute quantification.’
Prof. Christopher Gebhardt UKE Hamburg, Germany
Prof. Christopher Gebhardt UKE Hamburg, Germany
Prof. Geert A. Martens AZ Delta General Hospital, Belgium
Prof. Geert A. Martens AZ Delta General Hospital, Belgium
For more information, visit www.sysmex-mea.com/liquidbiopsy

للاط نب نسحلا يرملأا ومس نم هيجوتب بورحلا يرضرتلم ”MentaHealth “ ةيسفنلا ةحصلا ةصنم قلاطإ سلجلما سيئر ،للاط نب نسحلا يرملأا ومس ىعر قلاطإ تايلاعف ،ايجولونكتلاو مولعلل لىعلأا تايبرعلا تابيبطلا ةطبارل ”MentaHealth “ ةصنم سيفنلا معدلاو ةيانعلا ميدقتب ةصتخلماو ةيبرعلا نادلبلا في ثراوكلاو بورحلا يرضرتلم .تاعازنو بورحو تاعاصر نم نياعت يتلا هترضح يذلا لفحلا للاخ ،نسحلا ريملأا ومس دكأ ريمدت نم ةزغب يرجي ام نأ ،دعرم انيد ةريملأا ومس ةحصلا قحل ءاغلإ طقف سيل وه يبطلا عاطقلل .ةمداقلا لايجلأا صرفل ءاغلإ امنإو ةيسفنلا ةحصلاو تاسايسلل سسأ عضو ةيمهأ ىلإ هومس راشأو ءانب تايلولأا ريرقتو ةئيبلاو ةيبرتلاو ةحصلاب ةقلعتملا .اهل ساسأك ناسنلإا ةحص ىلع صخش رايلم نم برقي ام نأ ىلإ هومس هون امك يلقعلا بارطضلاا لاكشأ ىدحإب رثأتم ملاعلا لوح نأ ىلإ اتفلا ،اراشتنا رثكلأا بائتكلإاو قلقلا دعيو نوناعي ملاعلا ناكسلا نم ةئملاب 30 نم براقي ام ةدع ةيبرع لود يف ولعت ةبسنلاو بائتكلإا نم ىلإ هومس راشأو .بورحلاو تامزلأا نم تناع ميلعتلاو ةحصلاب ةقلعتم تامولعم ريفوت ةيمهأ نامرحلل عماج سرهف ىلع ءانب ةشيعملا تايوتسمو نامرحلاو رقفلا هجوأ ةسارد لجأ نم كلذو ددعتملا ةمدخل تاءاصحلإاو ماقرلأا ةنسنأ ىلع زيكرتلا عم .ناسنلإا تايبرعلا تابيبطلا ةطبار ةسيئر تلاق ،اهبناج نم ةيسفنلا ةحصلا ةصنم نإ ،شوركع مسيم ةروتكدلا ثراوكلاب بوكنملا يبرعلا عمتجملا ةمدخل تءاج ،نسحلا ريملأا ومس نم هيجوتب ،بورحلاو ةيعيبطلا يسفنلا بطلا مقاوط عيمج وحن دوهجلا تقلطناو نينانفو سفنلا ملعو ةرسلأا بطو ينطابلاو نم لكل ةيبطلا ةمدخلا ميدقتل نيعوطتمو نيعدبم .يبرعلا نطولا دادتما ىلع اهجاتحي ةمهاسملا تاهجلل ةيحتلاو ركشلا شوركع تهجوو نيكراشم نم ةصنملا قلاطإ حاجنإ يف ةفاك .نيمعادو دعس روتكدلا قبسلأا ةحصلا ريزو ضرعتساو ناونعب ريرقتل تايصوتلاو جئاتنلا زربأ ،ةشبارخلا يذلاو ”ندرلأا يف ةيسفنلا ةحصلا تامدخ عقاو“ نم ةينطو ةطخ راكتبا فدهب 2010 ماع هدادعإ مت ءاقترلاا اهنمو ندرلأا يف ةحصلا عاطق ريوطت اهنأش .ةيسفنلا ةحصلا تامدخب هجاوت يتلا تايدحتلا ضعب ىلإ ةشبارخلا راشأو فعض اهنمض نمو ،ندرلأاب ةيسفنلا ةحصلا عاطق مدختست يتلا ةيتسجوللا دراوملا فعضو مامتهلاا ةيبط رداوكو ةرسأو ةيودا نم يسفنلا جلاعلا يف .ةيجراخلا تادايعلا وا تايفشتسملا يف ىلإ تراشأ ةساردلا تايصوت نأ ةشبارخلا دكأو ةيسفنلا ةحصلا يف ةصصختم تادحو ءاشنإ ةرورض ىلا ةمدخلا لوصو نامضل ىفشتسم لك يف ةيحصلا زكارملا ءابطأ بيردت يف عسوتلاو ،نطاوملا .ةيرشبلا رداوكلا ةدايزو ،ةيلولأا طيطختلا ريدم نم ةلجسم ةلاسر ضرع متو روتكدلا ةزغ يف ةحصلا ةرازو يف يلودلا نواعتلاو ةطبار وضع اقسلا ةراس ةروتكدلاو ،تاتش دمحأ ةيسفنلا راثلآا اهيف انيب ،ةزغ نم تايبرعلا تابيبطلا ةمئاقلا برحلا ةجيتن اهنم نوناعي يتلا ةيحصلاو تايفشتسم نم ةئملاب 90 نم رثكأ فادهتساو ،راجنلا ءافيه ةفاقثلا ةريزو لفحلا رضح .عاطقلا نم تايندرلأا تابيبطلا ةطبار ءاضعأ نم ددعو نيلوؤسمو ءابطأ ىلإ ةفاضإ ،يبرعلا نطولا ماعلا نيعاطقلا نم يحصلا نأشلاب نيمتهمو .بط بلاطو صاخلاو زوين 2024 )رايأ( ويام l 62




With a vast and diverse portfolio, Pharmatrade offers over 5000 high-quality products. These encompass a wide array of medical and pharmaceutical supplies, catering to various healthcare needs. Pharmatrade's product range is carefully curated to meet the requirements of both the Government and Private sectors in the UAE.
46 Years of Exellence
30+ Multinational Companies
5,000+ Products in Portfolio


Quality is at the heart of our mission. Quality | Reliability | Patient Care
What We Do





2024 )رايأ( ويام l 64 عبارلا ليودلا نيدرلأا ةنمسلا ةحارج رتمؤم مايأ 3 ىدم لىع ةصصختم ةيملع ةضراحم 60 نم ثركأ ةيرادلإا نوؤشلل ةحصلا ةرازو ماع ينمأ تحتتفا ةحصلا ريزو نع ةبودنم ،تاسيرخ ماهلإ ةروتكدلا ةحارج رتمؤم تايلاعف ،يراوهلا سارف روتكدلا هتدقع يذلا عبارلا ليودلا نيدرلأا ةنمسلا .نماع في ةيندرلأا ةنمسلا ةحارج ةيعمج تاونسلا للاخ تدهش ةكلمملا نإ تاسيرخ تلاق تاصاصتخلإا نم ديدعلا يف اظوحلم اروطت ةيضاملا ،اهعورفو ةماعلا ةحارجلا صاصتخا اهنمض نم ،ةيبطلا يف ةيملعلا تادجتسملا صاصتخلإا اذه بكاو ثيح تفاضأو .عمجأ ملاعلا ىوتسم ىلع لاجملا اذه ةيلمعو ةيملع تازاجنإو ةيعون ةزفق ققح ندرلأا نأ ،اهتجلاعمو ةنمسلا ضارمأ صيخشت يف ةسوملم راطتخلإا لماوع زربأ نم ،عمجأ ملاعلا امك ،اهربتعاو ليلقت ةيمهأ تزرب انهو ،ناطرسلا ضرمب ةباصلإل طمن وحن ةيئاذغلا طامنلأا رييغتو لماوعلا هذه نم فيفختلل ةمزلالا تايمحلا عابتاو ،يحصلا ةايحلا اذه لوح ةديجلا ةيعوتلا ريفوتو ،ةدئازلا ةنمسلا ةحص ىلع يبلسلا هريثأتو هتروطخو عوضوملا ةيملعلا تاساردلا ىلإ تاسيرخ تراشأو .ناسنلإا ،ناسنلإا ةحص ىلع رشابملا ةميلسلا ةيذغتلا رثأو ثادحإ ىلإ ىدأ يذلا ةايحلا طمن يف تاريغتلاو تحبصأ ثيح ،ةيئاذغلا مظنلا يف ةحضاو تارييغت ةمعطلأا نم ىلعأ بسن ىلع يوتحت مظنلا هذه ام ،ةيرورضلا تايذغملا ىلإ رقتفتو ،ةقاطلاب ةينغلا ضارملأاو ةنمسلا تايوتسم يف ةدايز ىلإ ىدأ ضرم لثم ،يئاذغلا ماظنلاب ةطبترملا ةيراسلا ريغ مدلا طغض عافتراو يناثلا عونلا نم يركسلا عاطقلا نأ تنيبو .ةيومدلا ةيعولأاو بلقلا ضارمأو ةنمسلا ضرمب همامتها عبات ةكلمملا يف يحصلا ةيحارجلا تاينقتلا نم ةعومجمل هلاخدإ للاخ نم ،ةيحارجلا قرطلا ثدحأبو ،ضرملا اذه جلاع يف يحارجلا راظنملاب ةيحارج تايلمع ىرجأ املثم اهمهأ نم ،ةديج جئاتن تققح يتلاو ،ةنمسلل ءارجلإا نم رطاخملاو تافعاضملا بسن ليلقت دادعأ يف ةريبك ةدايز ىلإ ىدأ يذلاو ،يحارجلا .نزولا فيفختل تايلمع مهل تيرجأ نيذلا ىضرملا ،ملاس يماس روتكدلا ةيعمجلا سيئر لاق هبناج نم قلعتي ام لك مايأ 3 رادم ىلع شقان رمتؤملا نإ ةيبلسلا امهتافعاضمو ةنمسلاو ةنادبلا ضارمأب ام ضرع مت ثيح ،ةثيدحلا جلاعلا قرطو امهراثآو نم جلاعلا ةلأسم يف بطلاو ملاعلا هيلإ لصوت اهمدقي ةصصختم ةيملع ةرضاحم 60 نم رثكأ للاخ لكو ةكلمملا لخاد نم ةحارجلا ملاع يف ءاربخ ءابطأ ،سنوت ،ايلاطيإ ،اسمنلا ،اسنرف ،ايناطيرب ،اكريمأ نم ،قارعلا ،رصم ،ايكرت ،تيوكلا ،تاراملاا ،ةيدوعسلا اذه يف ةيندرلأا تاربخلا نأ ،ملاس دكأو .نيطسلف ريثك يف دوجوم وه ام اهتاردق يف قوفت لاجملا تاحارجلا نم عونلا اذهل ىضرم اندصقيو ،لودلا نم تايفشتسم انيدل نأو ةصاخ ،ةيبنجأو ةيبرع لود نم .لاجملا اذه يف لاع ىوتسم ىلع روتكدلا رمتؤملل ةيملعلا ةنجللا سيئر لاق هرودب ةرملل دقعي يلودلا رمتؤملا اذه نإ ،ةرهازم بلغت يدانل 75ـلا ةيلودلا ةودنلا عم نمازتلاب ىلولأا ةنمسلا يدانل 11 ـلا ةودنلاو )IBC( يلودلا ةنمسلا ىلع ةعبارلا ةرمللو ،ايقيرفأو طسولأا قرشلا يف ةنمسلا ةحارجل يلودلا داحتلإا نم دييأتب يلاوتلا .ةيضيلأا تابارطضلااو شرولا نم ددع دقع رمتؤملا شماه ىلع مت امك ،نيضرمملاو ءابطلأل ةيعونو ةصصختم ةيملع ةيذغتلا ييئاصخلأ لمع تاشرو ىلإ ةفاضلإاب ةفرعملاو ةربخلا كلتمي صصختم رداك اهمدقي رمتؤملا نأ ىلا اريشم ،لاجملا اذه يف صصختلاو 6 عقاوب يندرلأا يبطلا سلجملا نم دمتعم تاياغل نيرضاحملل تاعاس 8و روضحلل تاعاس .ينهملا ريوطتلا ديشر روتكدلا ءابطلأا بيقن بودنم لاق هتهج نم ةيبطلا ندرلأا ةداير ىلع دكؤي رمتؤملا نإ ،حادبا عاطقلل ةبيطلا ةعمسلاو ،ملاعلاو ةقطنملا يف .صاخ لكشب ةنمسلا ةحارجو ماع لكشب يبطلا روتكدلا ةنمسلا ةحارجل يملاعلا داحتلإا وضع لاقو نيذلا ىضرملا تايسنج ددع نإ ،سيرخ دمحم جلاعو ةنمسلا تايلمع ءارجلإ ةكلمملا نودصقي عفترا ةكلمملا جراخ تيرجأ ةقباس تايلمع تافعاضم ةنمسلا ةحارج صاصتخا نأ فاضأو .ةيسنج 72 ىلإ ةيجلاعلا ةحايسلا ديعص ىلع لولأا زكرملا لتحي تاب بناجلأاو برعلا ىضرملل ىرجت يتلا تايلمعلا ددعو تاونسلا يف ظحول هنأ ىلإ اتفلا ،ةكلمملا يف نم جلاعلل ىضرملا نم دادعأ مودق ةريخلأا لود يف تيرجأ يتلا ةنمسلا تايلمع تافعاضم ايملاع ازكرم ربتعت ةكلمملا نأ دكأو .ةيبنجأو ةيبرع ،ةليقثلا نازولأاو ةدقعملا ةنمسلا تايلمع ءارجلإ يبطلا عاطقلا تاحاجن ةلسلس ىلإ فاضي كلذ نأو ةللاج ندل نم ةياعرب ىظحي يذلاو ةكلمملا يف .يناثلا هللا دبع كلملا زوين


)JCI( تايفشتسلما دماتعلا ةيلودلا ةكترشلما ةئيهلا نع دامتعلإا ميدقت للاخ نم يلودلا عمتجملا يف ىضرملا ةملاسو ةيحصلا ةياعرلا ةدوج نيسحت ىلع )JCI( تايفشتسملا دامتعلا ةيلودلا ةكرتشملا ةئيهلا لمعت ةيلمعلا لولحلا داجيإو ةدوجلا ريياعم قيبطت ةيغب ةيبطلا تاسسؤملا ىلإ ةيميلعتلاو ةيراشتسلاا اهتامدخ ميدقت للاخ نم كلذكو ةيلودلا تاداهشلا حنمو يهو ،)JCR( ةيلودلا ةكرتشملا ةئيهلا دراوم ةسسؤم نم ءزجك 1997 ماع يف )JCI( تايفشتسملا دامتعلا ةيلودلا ةكرتشملا ةئيهلا تسسأت .ةمادتسملاو ةئيهلا عسوت ،ميلعتلا جماربو تارشنلاو تاراشتسلااو يلودلا دامتعلاا للاخ نم .ةكرتشملا ةئيهلل ةعبات يهو لماكلاب اهريدت حبرلل ةفداه ريغ ةعبات ةكرش ةيلودلا ةيحصلا تامظنملل ةدعاسملا ميدقت يف دعاست امك .ةيحصلا ةياعرلا ةدوج نيسحت يف ةدعاسملا للاخ نم ملاعلا ىوتسم ىلع اهتمهم ةيلودلا ةكرتشملا .ةلود 100 نم رثكأ يف اهريغو ةحصلا تارازوو ةماعلا ةحصلا تلااكوو يبطلا وصنميلك زكرم نع ةذبن ىلع زاح دقل .نانبل ،توريب بلق يف زيمتم يبط زكرم وهو ،”لانوشانرتنإ نسيديم زنكبوه زنوج“ عم نواعتلاب لمعيو ،2006 ماع يبطلا وصنميلك زكرم سسأت ،تقولا ةيحانل ةيحصلا ةياعرلا لاجم يف ةدوجلا ةيلاع تامدخ ميدقت ىلع رداق وهو )JCI( تايفشتسملا دامتعلا ةيلودلا ةكرتشملا ةئيهلا لبق نم دامتعلاا ةداهش وصنميلك زكرم أشنأ ،”زيمتلاو ةملاسلاو ةياعرلا“ ىلع ةمئاقلا ةيسيئرلا هتمهم راطإ نمضو .طسولأا قرشلاو نانبل يف ىضرملل ةمئلاملا ةئيبلاو ةفلكتلاو ،دبكلاو يمضهلا زاهجلا ضارمأو ،مارولأاو ،ردصلاو بلقلا ةحارجو ،بلقلا ضارمأو ،ربتخملاو ةعشلأا مسق كلذ يف امب ،ةدع تاصصخت يف زيمتلا زكارم يبطلا تاينقتلا تدحأب لماك لكشب اهزيهجت مت تاصاصتخلاا ةفاك يطغت اعورف زكرملا مضي .نولوقلا تاحارجو توبورلاو راظنملا ةحارجو ،يرقفلا دومعلاو غامدلا ةحارجو .ةمدقتملا ةيبطلا

2024 )رايأ( ويام l 66 ةكترشلما ةئيهلا دماتعا لىع ،ةسداسلا ةرملل لصحي يبطلا وصنميلك زكرم زيمتلاب رمتسيو تايفشتسلما دماتعلا ةيلودلا )JCI( تايفشتسلما دماتعلا ةيلودلا ةكترشلما ةئيهلا لبق نم هدماتعا لىع لانويشانترنا ينسيديم زنكبوه زنوج عم نواعتلاب يبطلا وصنميلك زكرم رختفي .زايتمابو لياوتلا لىع ةسداسلا ةرملل ةيلودلا ةكرتشملا ةئيهلا تكردأ .ةيملاعلا ةيحصلا ةياعرلا ريياعم زيزعتب ةروهشملاو ،ملاعلا يف دامتعلااو ةيحصلا ةياعرلا ةدوج نيسحت يف ةدئار ةئيه يه JCI زكرملا مازتلا ديدجلا زاجنلإا سكعيو ،2021 ماع يف قباسلا هدامتعا ىلع زكرملا لصح .ةملاسو ةدوجب ةياعرلا يف يبطلا وصنميلك زكرم هرهظي يذلا ينافتلا .هل دامتعا لوأ ذنم ىضرملل ةيلودلا ةملاسلا فادهلأ لاثتملاا ىلع زكرملا ظفاح ،كلذ ىلإ ةفاضلإاب .ةيئانثتسإ ةيحص تامدخ ميدقتب رمتسملا نحن ،انيدل دامتعلاا تايوتسم لضفأ دحأ ىلع نولصحت متنأ“ :اربعم ،ةكرتشملا ةئيهلا قيرف دئاقو يبطلا شتفملا ،يبنلا برلا دبع فرشأ روتكدلا داشأ دقو .دامتعلاا ةداعإ نم ددعلا اذه ىلع زرحت تايفشتسملا نم ليلق ددع نأ يبنلا برلا دبعروتكدلا دكأ ”.ميظع زاجنإ هنإ ،مكسفنأب اورخفت نأ بجيو ،مكب نوروخف يل زايتماو فرش هنإ“ :لائاق يرادلإاو يضيرمتلاو يبطلا وصنميلك زكرم قيرفل هنانتما نع ،CMC يف ةيرادلإا تايلمعلا ريدم ،ةلازغ وبأ قراط ديسلا هرودب ربع امك ”.مكداصح وه حاجنلاو زاجنلإا اذهف .مكئلاوو مكينافت ردقأ .مكلثم نيفرتحم عم لمعلا للاخ نم توريب يف يبطلا وصنميلك زكرمل يذيفنتلا سيئرلاو ةرادلإا سلجم سيئر ةلازغ وبأ رهام ديسلا هلاوت يذلا مهملا رودلا زربي زاجنلإا اذه نأ ركذلاب ردجي .”رمتسملا نيسحتلل انل ةيميلعت ةصرف تناك “ :ةلازغ وبأ ديسلا فاضأ .ددصلا اذه يف ةرمتسملا دوهجلا لذبو ةديدج تايجيتارتسا عضو .دعبأو ةقطنملا يف ةيحصلا ةياعرلا ىوتسم عفر يف يبطلا وصنميلك زكرم لصاوي ،يبطلا زيمتلاو ةروطتملا ايجولونكتلا للاخ نم ةيبط تاسسؤم
Cedars-Sinai

69 l 2024 )رايأ( ويام قرشلا ىلإ ايسآ ىلإ كيسكملا نم .ةيملاعلا تنرتنلإا ربع تاودنلا يف انؤاربخ كراشي ،طسولأا فراعملا لدابتل ةيراجتلا ضراعملاو تارمتؤملاو .لبقتسملا ىلإ ةكرتشملا انتاعلطتو راكفلأاو انبتاكمل ديازتملا دوجولا نإف ،كلذ ىلإ ةفاضلإاب ،يتيس وكيسكم يف ايلاح( نادلبلا نم ديدعلا يف ىضرملل رفوي ،)نادلبلا نم ديزملاو ةروفاغنس يف نع ديزملا ةفرعمل ةصرفلا ،نيعباتملا ءابطلأاو نم هيلع نحن ام ىلإ لوصولاو ،Cedars-Sinai يف ةياعرلا يقلتو ،ىرخأ ءارآ للاخ نم ةفرعم .ةجاحلا بسح سولجنأ سول ءاشنإ ىلإ لعفلاب يجيتارتسلاا اننواعت ىدأ دقو ىفشتسم لثم ،زارط ثدحأ ىلع ةديدج قفارم راديس ةكرش نيب ةكارش وهو ،رطق يف ويف يهو ،ةيحصلا ةياعرلل ايسناجيلإ ةكرشو ءانيس ترشب دقلو .ةضباقلا رامثتسا ةكرشل ةعبات ةكرش نواعتلا نم ديدج رصعب ةيئانثتسلاا ةأشنملا هذه دعي يبظ وبأ يف نيميقملا ىدل .يملاعلا تامدخلا يمدقم دحأ اضيأ
ماظن لهسي ثيح ،ةدحتملا تايلاولا يف نيلضفملا ةيبرعلا تاراملإا نم ىضرملل حمسي يذلا ةلاحلإا معديو Cedars-Sinai ةياعر نم ةدافتسلااب ةدحتملا .ةدوجلا نيسحت عيراشم نم ةعساو ةعومجم ةيقافتا انيدل ،يميداكلأا نواعتلاب قلعتي ام يفو نيتنسلا يف بطلا بلاط ديوزتل ةفيلخ ةعماج عم تارودلا ىلإ لوصولا ةيناكمإب ةعبارلاو ةثلاثلا نم حوارتت ةدمل ،ىدملا ةريصق ةيلمعلا ةيريرسلا نم ةعونتم ةعومجم يف عيباسأ ةينامث ىلإ ةعبرأ ةثلاث انفضتسا ،2023 ةنسلا يفو .تاصصختلا ةفيلخ ةعماج نم ةعبارلا ةنسلا يف بط بلاط ةدمل يريرس بوانتو ةبقارم ةبرجت ىلع لوصحلل .سولجنأ سول يف يسيئرلا انمرح يف نيرهش :اتباث دحاو ءيش ىقبي ،يعاسملا هذه لك عمو تاعقوت زواجتت ةحاتم ةياعر لضفأ ريفوتب انمازتلا .اوناك امنيأ اناضرم ةبرجت لىع ءوضلا طيلست نكيم له مكتيرسم في لوحت ةطقن وأ ةيسيئر نودوقت فيك تلكش يتلا ةينهلما ؟ىفشتسملل ليودلا ومنلا نوروصتتو نم نينسلا رم ىلع تروطتو تبستكا دقل حارجك يب ةصاخلا ةحارلا ةقطنم نم جورخلا للاخ ،لمعلا ةسراممو ناديملا يف طارخنلإاو ،يميداكأ ةيادب يف .يرادلإا وأ يريرسلا بناجلا ىلع ءاوس تاراملإا يف اماع تيضمأ ،ةينهملا يتريسم يف ةحارجلا مسقل سيئرك ةدحتملا ةيبرعلا قيرف ىلإ تممضنا كلذ دعبو ،ماوت ىفشتسم كانه لمعلا ثدحأ دقلو .يلودلا زنكبوه زنوج .يلودلا مسقلا يف يسفن جمد دعب اريبك اقرف ىلإ ريثكب كلذ نم رثكأو ةربخلا هذه لك تبلجف ،Cedars-Sinai International يف يدايقلا يرود نم ملاعلا يف ريثأتلل اقح نيدهاج ىعسن ثيح .هب موقن يذلا لمعلا للاخ لاو ،يلودلا نواعتلا تايكيمانيد بستكن نحن تايلاولا ىلع طقف تزكر اذإ كلذب مايقلا كنكمي اتقو قرغتسي رملأاف .اهيف حجني امو ةدحتملا .مهقرفو كئارظن عم دجاوتلل افغشو ءاوس ،Cedars-Sinai International ـل اماه اءزج ةدحتلما ةيبرعلا تاراملإا بَرتعت“ يلماع عاطقلا اذه نودوقي نيذلا ةيحصلا ةياعرلا يمدقم وأ ضىرلما روظنم نم في Abu Dhabi Global Healthcare Week ةبسانبمو .يبظ وبأ في ىوتسلما ةطشنلا تاثداحلما هذه في ةكراشملل Cedars-Sinai قيرف علطتي ،ةيحاتتفلاا هترود ةروطتلما تاينقتلا قيبطتو ،ةيحصلا ةياعرلا لاجم في تاراكتبلإا ثدحأ لوح ةماهلاو علطتن .اوناك مانيأ ضىرلما ةحلصم نمؤي ابم تاينقتلا هذهل لوؤسلما ذيفنتلاو ”C28 حانجلا ،5 ةعاقلا في مكئاقلل
Cedars-Sinai

2024 )رايأ( ويام l 68 ةلباقم يانيس–زراديس“ ـل يذيفنتلا سيئرلا ،نوسح مثيه روتكدلا عم يصرحلا راوحلا اذه في ”بيرعلا ىفشتسلما“ ةلجم فشكتست )Cedars-Sinai International( ”لانوشانترنإ روتكدلا كراشي .لماعلا في ةيبطلا تاسسؤلما زربأ دحأ هجوت يتلا ةيساسلأا ئدابلما ،ضيرلما ةبرجتو ،ةدوجلا ةيلاع ةيجلاع جئاتنب Cedars-Sinai مازتلا لوح هتيؤرب نوسح تانواعتلا لىإ طسولأا قشرلا في ىفشتسملل يلماعلا لصاوتلا نم .رمتسلما ريوطتلاو يتلا ةيويؤرلا ةدايقلا لىإ ةمهم ةرظن راوحلا نمضتي .زيمتلا وحن اهيعسو ةيجيتاترسلاا .يلماع ىوتسم لىع ةيحصلا ةياعرلا دوقت ـل ةيساسلأا ةلاسرلا يه ام ةيؤرو لانوشانترنإ يانيس-زراديس هذه هجوت فيكو ،ىفشتسلما هطيطختو ةيمويلا هتايلمع ئدابلما ؟ليبقتسلما جئاتن ميدقت ىلع لماك لكشب Cedars-Sinai زكري مدقن نحنف .ضيرملل ةبرجت لضفأو ةدوجلا ةيلاع ةسسؤم ةنورم عم يميداكأ يبط زكرم زيمت يف اندوجول نوظوظحم اننأ ربتعنو .ةلقتسم تاذو اعونت ملاعلا ندم رثكأ ىدحإ ،سولجنأ سول ،اماع 120 ىدم ىلع .يفاعتلاو ةحصلل ةليمج ةئيب انتاقلاع نإف اذل ،انعمتجم نم أزجتي لا اءزج انك اننوك ىلإ ةفاضإ .ةقراخ انتبهومو ،ةريبك اندراومو رارمتساب زواجتت تايفشتسم ةثلاث نم ادحاو نم ديدعلل جئاتنلا ةدوج يف ينطولا طسوتملا ،2023-2024 ةرتفلا يفو .ةيسيئرلا ةيبطلا تلااحلا فرشلا ةمئاق يف نيجردم اننوكب نوروخف نحن U.S.ةلجم نع ةرداصلا ،”تايفشتسملا لضفلأ“ ىلع نماثلا ماعلل News & World Report نمض انتاصصخت نم ةتس فينصت مت امك ،يلاوتلا .ةدحتملا تايلاولا يف تاصصخت ةسمخ لضفأ تاردابلما وأ تاءارجلإا يه ام رمتسلما ينسحتلا نماضل ةدمتعلما جئاتنو ةيحصلا ةياعرلا ةدوج في ؟ضىرلما تانايبلا ىلع امئاق اجهنم Cedars-Sinai عبتي ةبرجتو ةملاسلاو ةياعرلا ةدوج نيسحتل ةلدلأاو يف طشن وضع نحن .رمتسم لكشب ضيرملا ةيحصلا ةمظنلأاو ةيميلعتلا تايفشتسملا سلجم بطلا تايلكل ةيكريملأا ةيعمجلل عباتلا )COTH( يميلعت ىفشتسم 400 لثمي يذلاو ،)AAMC( ريدجلاو .ةدحتملا تايلاولا يف ةدئار ةيحص ةمظنأو يف اهب فرتعم COTH يف ةيوضعلا نأ ركذلاب ىضرملا ةياعر يف زيمتلل رايعمك ملاعلا ءاحنأ عيمج ةيبطلا ةياعرلا زكارمف .نييبطلا ميلعتلاو ثحبلاو ،ةيكريملأا ةموكحلل ةعباتلا )CMS( ةيبطلا تامدخلاو 30 ةدمل تايفولا تلادعم نع تانايب عمجب موقت ةياعرلا نوقلتي نيذلا ةيبطلا ةياعرلا ىضرمل اموي ،بلقلا لشفو ،ةيبلقلا ةمزلأا :ةيحص تلااح سمخل نمزملا يوئرلا دادسنلاا ضرمو ،يوئرلا باهتللااو CMS أدب نأ ذنم .ةيغامدلا ةتكسلاو )COPD( تايفولا تلادعم تلظ ،تانايبلا هذه عبتت يف تلادعملا ىندأ نيب نم Cedars-Sinai ىضرمل ساكعنا يه جئاتنلا هذهو .ةدحتملا تايلاولا يف .ةيئافشتسلإا انتامدخ زيمتل رشابم ىعسي تاياغ وأ فادهأ ةيأ قيرط نع اهقيقحتل مكافشتسم ؟طسولأا قشرلا في عسوتلا ىلإ انيدل ةيملاعلا ةيعوتلا دوهج عيمج ىعست ميدقت للاخ نم ءاوس ،ضيرملا نم ةياعرلا بيرقت ،دعب نع ةيحصلا ةراشتسلاا وأ ،ةرشابملا ةياعرلا وأ .كلذ ىلإ امو ،دامتعلاا معد وأ ،ءابطلأا ةرايز وأ يمدقم عم انتكارش للاخ نم رشابم ريغ لكشب صاخلاو ماعلا نيعاطقلا نم ةيحصلا ةياعرلا نحنو .ثيدحلا بطلا قفارم لضفأ سيسأتل قرشلا يف ءاوس فادهلأا كلت قيقحت يف نوتباث .ملاعلا ءاحنأ عيمج يف وأ طسولأا يتلا صرفلا وأ تايدحتلا يه ام ةياعرلا تامدخ ميدقت في اهنورت ةنراقم طسولأا قشرلا في ةيحصلا ؟ةيلحلما مكتايلمعب ضيرملا ةلحر ربع صرفلاو تايدحتلا ىرن نحن ثيح ةينمزلا ةقطنملا فلاتخا كلذ يف امب ،اهلمكأب يف تافلاتخلاا كلذكو ،راهنلاو ليللا لاوط نواعتن ،كلذ نم مهلأاو .ةيميظنتلا تائيبلاو عفدلا ةمظنأ ديلاقتلاو تافاقثلا نيب تافلاتخلاا مارتحاو ملعتلا نوكت ثيح ادحوم ةمدخ ماظن دمتعن نحن .اهريدقتو اهسفن يه يبد يف ضيرملا اهاقلتي يتلا ةياعرلا .سولجنأ سول يف ضيرملا اهاقلتي يتلا اهنورجت يتلا تاكاشرلا جئاتن نع اذام تاردابلما معدل طسولأا قشرلا في ؟Cedars-Sinai International ـل ةيلودلا ةكرشل عباتلا ةيملاعلا تامدخلا قيرف فشكتسي صرفلا رارمتساب Cedars-Sinai International نم ربكأ ددعل ىلولأا ةجردلا ةياعر ريفوتل ةحاتملا تايفشتسملا عم نواعتلا للاخ نم صاخشلأا تايجيتارتسلاا للاخ نمو .ةدحتملا تايلاولا جراخ تامدخلا نم ةلماكتم ةقاب مدقن ،ةدمتعملا ةديدعلا ىلع نيلمتحملا ءاكرشلا دعاست يتلا ةيراشتسلاا ةيحصلا ةياعرلا ةئيب روطت عم ،مهفادهأ قيقحت نوسح مثيه روتكدلا
International ـل يذيفنتلا سيئرلا ةدوجلا ةيلاع جئاتن ميدقت لىع لماك لكشب زكرن“ ”ضيرملل ةبرجت لضفأو


https://uchicagomedicine.org/global
71 l 2024 )رايأ( ويام
عقوملا ةرايز ىجري ،تامولعملا نم ديزملا ةفرعمل ةحارجلا ذاتسأ ،ةحارجلا في روتكد ،يخلب ماسح لغوتلا ةفيفط ةحارجلاو ةيتوبورلا بلقلا ةحارج ريدم يحارجلا لخدتلا تاذ بلقلا ةحارج لاجم يف دئار ،يخلب ماسح روتكدلا ،يجاتلا نايرشلا ضرم جلاع يف صصختم وهو .ةيتوبورلا ةحارجلاو طيسبلا ،ىرخلأا بلقلا ضارمأو ،ينيذلأا نافجرلاو ،بلقلا تامامص تابارطضاو .يفاعتلا تقوو مللأا ليلقت لجأ نم لاخدت لقأ ةيتوبور تاينقت مادختساب توبورلا ةطساوب بلقلل ةيحارج ةيلمع يرجي يخلب روتكدلا ةدوعلا نم اضيأ يريسوم نكمت ،ةحارجلا دعبو رفسلا هنم بلطتي يذلا رملأا ،لمعلا ىلإ ةعرسب .ملاعلا لوح لاو ،ةمدخلا ىلع امئاد زكرأ ،يلمع يف“ :لاقو يتلا ةمدخلا ةدوج نع يفكي امب ربعأ نأ عيطتسأ .وغاكيش ةعماج ىفشتسم يف اهتيقلت تاضرمملاو ءابطلأا – نييئانثتسا عيمجلا ناك ”.بلقلا ضبنب كانه ىلإ دوعأس .نيدعاسملاو

2024 )رايأ( ويام l 70 ضيرلما دعاست ..ةيتوبورلا يجاتلا مماصلا ةحارج طشنلا ةايحلا طنم لىإ ةعسرب ةدوعلا لىع ةيبط تاسسؤم وغاكيش ةعماج ىفشتسم نم نم نياعي هنأ تاونسل ملعي ييرسوم ناد ناك بلقلا مماص ضرم وهو - يجاتلا مماصلا طوبه في فلخلا لىإ مدلا بسرت في ببستي يذلا امدنع نكل .بلقلا نم ىسريلا ةيولعلا ةفرغلا عضو ،داح يغامد مروب هتجوز ةباصإ صيخشت مت تاونس سمخ ةدلم ابناج ةصاخلا هتحص اياضق .اهب ةيانعلل غرفتيل يريسوم داع ،2022 ماع رخاوأ يف اهتافو دعبو طوبه ةلاح نأب هغلبأ يذلا بلقلا بيبط ىلإ نم ديزملا ناك .تروطت دق هيدل يجاتلا مامصلا .هتلاح راثآب رعشي أدبو ،فلخلا ىلإ برستي مدلا ،اماع 69 رمعلا نم غلابلا ،يريسوم ظفاح املاطل يشملاو تاجاردلا بوكر للاخ نم هتقايل ىلع نلآا جردلا دوعص درجم نكلو ،ةليوط تافاسمل ناح دق تقولا نأ تكردأ“ :لوقيو .ثهلي هلعج .”ام ءيشب مايقلل ةيحارج ةيلمع ءارجإ بلقلا بيبط حرتقا امدنعو ثحبلا ملعت يذلا - يريسوم دجو ،مامصلا حلاصلإ همامأ نأ - هتجوزل هتياعر ءانثأ ةيبطلا تايبدلأا يف يتلا ردصلا ةحوتفم ةيديلقتلا ةحارجلا امإ :نيرايخ وأ ،ةقطنملا يف تايفشتسملا مظعم اهمدقت اهمدقت يتلا لغوتلا ةفيفط ةيتوبورلا ةحارجلا .وغاكيش ةعماج ىفشتسم سسؤملا ،يريسوم لاق ،”ةيسدنه ةيفلخ يدل“ تقمعت املك“ :ينملأا لماكتلا ةكرشل كراشملا دجوي لا هنأ تكردأ املك ،ةيتوبورلا ةحارجلا يف رثكأ ”.ةعئار ةبرجتلا تناكو .اهب مايقلا مدعل ببس يدؤتو لاخدت لقأ ةيتوبورلا ةحارجلا عسرأ لكشب ضىرلما فياعت لىإ ةعماج ىفشتسم مدق ،تاونس 10 نم رثكلأ ،ةيتوبورلا بلقلا ةحارج تارايخ هاضرمل وغاكيش بلق ةيلمع 1600 نم رثكأ نوحارجلا ىرجأ دقو ماسح روتكدلاو .حاجنلاب اهعيمج تللكت ةيتوبور ةحارجل اريدم هتفصب .لاجملا اذه يف دئار ،يخلب ةعماج ىفشتسم يف ةيتوبورلاو ةطيسبلا بلقلا يحارجلا يشنفاد ماظن مدختسا دقف ،وغاكيش .2006 ماع ذنم يللآا صق بلقلل ةيديلقتلا ةحارجلا يضتقت نيح يف ،بلقلا ىلإ لوصولل يردصلا صفقلا حتفو علاضلأا تاودأ لاخدإ ىلع يوطنت ةيتوبورلا ةحارجلا نإف مجحب قوقش ةسمخ وأ ةعبرأ للاخ نم ةيتوبور اريماكو ةيلآ اعرذأ تاودلأا هذه لمشت .دوقن ةعطق .حلاصلإا ءارجلإ ةمزلالا زرغلاو ربلإا ليصوتل اذفنمو عرذلأا ليغشتل مكحت ةدحو حارجلا مدختسي مث .ةيلمعلا ءارجلإ ةيللآا ةيؤر ىلع لوصحلا حارجلل حيتت اهنإ“ :يخلب لاقو هحنمتو ،ردصلا لخاد ءاضعلأل حوضولا ةيلاعو ةربكم نييرشب نيعارذ سيل مادختسا ىلع ةردقلا ديلا تاردق زواجتت نأ نكمي ةيلآ عرذأ ةثلاث لب .”ةيرشبلا ةحارجلا نمضتت ،يجاتلا مامصلا طوبهل ةبسنلاب ةيعانطصإ داتوأ لاخدإ وأ ةفلاتلا طاقنلا ميمرت امإ .هتفيظوو مامصلا لكش ةيوقت يف ةدعاسملل يجاتلا مامصلا ضرم ةلاح يف“ :يخلب لاقو حلاصإ وه هلعف نكمي ام لضفأ نإف ،يسكنتلا .”هلادبتسا نم لادب مامصلا عتمتيو ،طقف تاعاس عضب ءارجلإا قرغتسي ىندلأا دحلا عم عرسأ يفاعت تقوب ىضرملا قوقشلا نلأ ارظن .مللأا ةرادإ ىلإ ةجاحلا نم ةباصلإل لقأ ارطخ اضيأ ىضرملا هجاوي ،ادج ةريغص اوعضخ نيذلا ىضرملا نأ نيح يفو .ىودعلاب يف نوقبي ام ةداع ،ةيديلقتلا ردصلا حتف ةحارجل نإف ،ةيلمعلا دعب مايأ ةسمخ ةدمل ىفشتسملا دعب مهلزانم ىلإ نودوعي ام ابلاغ يخلب ىضرم .نيموي وأ موي لغوتلا ةفيفط ةيتوبورلا ةحارجلا“ :يخلب لاقو ىلإ ةدوعلاب سانلل حمستو ريبك لكشب لاخدت لقأ .”ةريبك ةعرسب ةيداعلا مهتايح ءاحنأ عيمج يف تايفشتسملا ددع نأ ردقي ةحارج نم عونلا اذه مدقت يتلا ةدحتملا تايلاولا 15% ىلاوح كانهو .ءطبب دادزي ةيتوبورلا بلقلا ةدعاسمب متت يجاتلا مامصلا تاحارج نم طقف قيرفو يخلب موقي ،هتربخ لضفب نكل .تاتوبورلا وغاكيش ةعماج ىفشتسم يف ةيتوبورلا ةحارجلا نم رثكأف .دلابلا ءاحنأ عيمج نم ىضرملا بذجب .يونيلإ جراخ نم نوتأي هاضرم فصن طشنلا ةايحلا طنم لىإ ةدوعلا ،يشنفاد ماظن ىلع هثحب يريسوم ىرجأ نأ دعب يف ةحارجلا ءارجلإ ادعوم ددحو يخلب ىقتلا ططخم وه امك ةيلمعلا تراسو .2023 سطسغأ دحاو موي دعب ىفشتسملا يريسوم رداغو ،اهل ةليلق بوبح ىلإ جاتحي هنأ دجو ،لزنملا يف .طقف .هيفاعت ءانثأ مللأاب مكحتلل لونيلياتلا نم ةسمخ دعب“ .”ديدج صخش لثم تنك دقل“ :لاقو ىلع لايم 20 ةفاسم عطقأ تنك ،ةحارجلا نم مايأ يف هزنتلاب تمق ،عيباسأ ةثلاث دعبو .يتجارد رادقم ناك دقل .ئداهلا طيحملا برغ لامش لابجلا ،قدصي لا ارمأ ةحارجلا اهايإ ينتحنم يتلا ةقاطلا ”.ريبك نسحتب ترعش مكو يلأ ةيتوبورلا ةحارجلا ءارجإب يريسوم يصوي يف يقطنم رمأ هنإ“ :لاقو .اهجاتحي صخش وه ام مهفو ثحبلا ىلإ سانلا جاتحي ثيح ،ملاعلا اذإ .مهسفنأ نع نيعفادم اوحبصي نأو مهل حاتم ءارجإ مدعل ببس دجوي لا هنأ ىرت ،رملأا يف تثحب .”ةيتوبورلا ةحارجلا ييرسوم ناد

73 l 2024 )رايأ( ويام ةحارج دعب ةيرودلا ةعباتملا .لهؤم يبط مقاطو نامضل ةيرورض تاونس سمخل لصت ةدملو لبيو هارن ام وهو ،هتدوع عنمو ناطرسلا نم ماتلا ءافشلا سمخلا اوطخت نيذلا ىضرملا نم ريثكلا ىدل مويلا .تاونس لبيو ةحارج رارق ذاختا نأ ىلإ ةراشلإا دوأ ،انهو رطاخملا مييقت ىلع دمتعي ىضرملا ضعبل ةبسنلاب ةحارج ءارجإ رارق نوكي ،تلااحلا ضعب يفف ؛دئاوفلاو يناعي لاو اباش ضيرملا ناك لاح يفف ،احضاو لبيو ةحارج نوكت دق ىرخأ ةيحص لكاشم وأ ضارمأ نم .لضفلأا يجلاعلا رايخلا يه لبيو ،ةبوعص رثكأ رارقلا نوكي ،ىرخأ تلااح يف نكلو يناعي وأ نسلا يف اريبك ضيرملا ناك لاح يفف لبيو ةحارج نوكت دقف ،ةنمزم ةيحص لكاشم نم .لضفلأا رايخلا نوكت لا دقو ةياغلل ةريطخ ةيلمع مييقت بيبطلا ىلع بجي ،تلااحلا هذه يف زكرم يف انل ةبسنلاب .ةيانعب دئاوفلاو رطاخملا ،ةصصختملا ةدحولا للاخ نمو يبطلا وصنميلك هذه ىلإ نوجاتحي نيذلا ىضرملا ةلاحلإ زكرم نحنف ىتحو لاجملا اذه يف تاربخ مكارت انيدلو ةحارجلا تايفولا ةبسنو ةريطخ تافعاضم فداصن مل نلآا تلادعم يف ضافخنا عم رفصلا ىلإ برتقت انيدل ةدم ةدايز بلطتت دق اهنكلو ةريطخلا تافعاضملا .تلااحلا ضعبل ىفشتسملا يف ةماقلإا ةدحولا اهرفوت يتلا صئاصخلا يه ام دبكلا ضارمأ ةحارج في ةصصختلما زكرم في مكيدل سايركنبلاو ةرارلماو ؟يبطلا وصنميلك دبكلا ضارمأ ةحارج يف ةصصختملا ةدحولا مضت يبطلا وصنميلك زكرم يف سايركنبلاو ةرارملاو ةعساولا ةربخلا يوذ ةرهملا نيحارجلا نم اقيرف ةيحارجلا تايلمعلا نم اهريغو لبيو ةحارج ءارجإ يف ةحارج يف ةصصختملا ةدحولا عتمتت .ةدقعملا وصنميلك زكرم يف سايركنبلاو دبكلا ضارمأ ةزاتمم جئاتن قيقحت يف ةبيط ةعمسب يبطلا نيذلا ىضرملا ةلاحلإ ازكرم اهنأ ثيح ىضرملل هيحارج ةربخ لضفب كلذو ،لبيو ةحارج ىلإ نوجاتحي .ةثيدحلا هتازيهجتو يبطلا همقاط ةءافكو اماع 23 نع ديزت لاجملا اذه يف ةعساو ةربخ يدل ةءافكو حاجنب تايلمعلا هذه نم ريثكلا تيرجأ دقو ةمزلالا ةيبطلا تازيهجتلا ثدحأ انيدل رفاوتيو .ةيلاع عم ،جئاتنلا لضفأبو ةيلاع ةقدب لبيو ةحارج ءارجلإ .اهدعبو ةحارجلا لبق ةلماكتم ةياعر ميدقت ةزاتمم جئاتن يبطلا وصنميلك زكرم ققح دقل عتمتي ثيح ،لبيو ةحارجل نوعضخي نيذلا ىضرملل ةايحلا ديق ىلع ءاقبلا نم ةيلاع ةبسنب ىضرملا .ةحارجلا دعب ةايحلا ةيعون نيسحتو 73 2024

2024 )رايأ( ويام l 72 ةحارج ءارجلإ ةقطنلما في ةيبطلا زكارلما لضفأ دحأ تويرب في يبطلا وصنميلك زكرم دعي ةدحو كلتيم ثيح ،ةثيدحلا هتازيهجتو يبطلا همقاط ةءافكو هيحارج ةبرخ لضفب لبيو دولك روسيفوبرلا ثدحتي ،راوحلا اذه في .سايركنبلاو دبكلا ضارمأ ةحارج في ةصصختم وصنميلك زكرم في سايركنبلاو دبكلا تايلمع ةدحوو ةماعلا ةحارجلا مسق سيئر ،رايط ،اهتيهام احضوم ،)Whipple( لبيو ةحارج لوح ”بيرعلا ىفشتسلما“ ةلجم لىإ ،يبطلا ةحارج ةدحو صئاصخو ،ضىرلما ءافشو حاجنلا بسنو ،اهئارجإ يعدتست يتلا تلااحلاو .يبطلا وصنميلك زكرم في سايركنبلاو دبكلا ضارمأ ةلباقم رايط دولك روتكدلا زكرم في سايركنبلاو دبكلا تايلمع ةدحوو ةماعلا ةحارجلا مسق سيئر تويرب في يبطلا وصنميلك ”لبيو ةحارج ءارجلإ ةدئار ةهجو يبطلا وصنميلك زكرم“ ام .لبيو ةحارج لىع ةيادب ةءاضلإا دون ؟اهتقد ىدم امو ؟ةحارجلا هذه يه زاهجلا تايلمع ربكأ نم ةدحاو لبيو ةحارج دعت لاصئتسا اهللاخ متي ثيح ،اديقعت يمضهلا ةقطنم يف ةيويحلا ةجسنلأاو ءاضعلأا نم ديدعلا ءزجو ةقيقدلا ءاعملأاو رشع ينثلإا يهو نطبلا ةرارملاو سايركنبلا سأرو ةيوارفصلا ةانقلا نم ةيلمعلا ةقطنم يف ةدوجوملا ةيوافميللا ددغلاو ةطيحملا نوهدلا ىلإ ةفاضلإاب ةدعملا نم ءزجو ،ةروكذملا ءاضعلأا لاصئتسا دعب .ةقطنملا هذهب ،قيقدلا نارصملاب سايركنبلا ليصوت ةداعإ متي ةيوارفصلا ةانقلاو ،قيقدلا نارصملاب ةدعملاو ةداع لبيو ةحارج قرغتست .ةقيقدلا ءاعملأاب ءاقبلا ىلإ ضيرملا جاتحيو ،تاعاس 6 ىلاوح دعب مايأ 10 ىلإ عوبسأ ةدمل ىفشتسملا يف يف مايأ ةثلاث ىلإ نيموي كلذ يف امب ،ةحارجلا .ةزكرملا ةيانعلا يعدتست يتلا ةيضرلما تلااحلا يه ام ؟ةحارجلا هذه ءارجإ جلاعل سياسأ لكشب لبيو ةحارج ىرجت :ةيناطسرلا مارولأا نم ةيسيئر عاونأ ةعبرأ Pancreatic Adeno- سايركنبلا ةدغ ناطرس ( اعويش تاناطرسلا عاونأ رثكأ وه )carcinoma نم أشني ثيح ،سايركنبلا سأر ةقطنم يف .سايركنبلا يف ددغلا ايلاخ Cholangiocarci- ةيوارفصلا ةانقلا ناطرس ( ،ةيوارفصلا ةانقلا ةناطب ايلاخ نم أشني )noma نم ةيوارفصلا ةراصعلا لقنت يتلا ةانقلا يهو .ةقيقدلا ءاعملأا ىلإ مث ةرارملا ىلإ دبكلا أشني )Ampullary Tumor( يوارفصلا مرولا ةقطنملا يهو ،يوارفصلا مرولا ايلاخ نم ىرجمب ةيوارفصلا ةانقلا اهيف يقتلت يتلا .سايركنبلا :)Duodenal Cancer( رشع ينثلإا ناطرس ءزجلا وهو ،رشع ينثلاا ةناطب ايلاخ نم أشني .ةقيقدلا ءاعملأا نم لولأا ةحارج ءارجإ وه راطلإا اذه يف هيلع ديكأتلا دوأ ام نأ يعدتسي ةيناطرسلا مارولأا هذه جلاعل لبيو يف اروصحم لازي لا هنأ يأ ايعضوم مرولا نوكي ينثلااو ةيوارفصلا ةانقلاو سايركنبلا سأر ةقطنم ةئرلا وأ دبكلا لثم ىرخأ ءاضعأ ىلإ رشتني ملو رشع .اهريغو ءوجللا متي دق ،كلذ لىإ ةفاضلإاب تلااحلا ضعب في اضيأ ةحارجلا هذه لىإ :لثم ،ةديمحلا Pancreatic( سايركنبلا يف ةيطاخملا مارولأا ةعومجم يهو )Mucinous Neoplasms ةناطب ىلع ومنت يتلا ةديمحلا مارولأا نم ،تلااحلا ضعب يف .طاخملا جتنتو سايركنبلا عم ةيناطرس ىلإ مارولأا هذه لوحتت دق دق ام )Precancerous Lesions( تقولا رورم اهروطت عنمو اهتلازلإ لبيو ةحارج يعدتسي .ناطرس ىلإ Pan- سايركنبلا يراجم يف يطاخم ددمت ( creatic Intraductal Papillary Mucinous مارولأا نم عون وهو )Neoplasm - IPMN ةيوارفصلا تاونقلا لخاد ومنت يتلا ةديمحلا ةديمح مارولأا هذه نوكت دق .سايركنبلا يف بلطتت دق ،تلااحلا ضعب يفو ،ةيناطرس وأ .ناطرس ىلإ اهروطت عنمو اهتلازلإ لبيو ةحارج ضىرلما ءافشو حاجنلا بسن يه ام ؟ةحارجلا دعب دمتعت ىضرملا ءافشو حاجنلا بسن نإ ،عقاولا يف تلااحلا ضعب كانه ىلولأا ةجردلاب .نيرمأ ىلع ةيلمعلا لبق ةدناسم تاجلاع ىلإ جاتحت يتلا وأ يعاعشلا وأ يئايميكلا جلاعلا نمضتت اهدعبو نم عون لكل صاخلا لوكوتوربلا بسحب يعانملا نيسحت يف اماه ارود بعلي ام وهو ناطرسلا عاونأ .لبيو ةحارج دعب ناطرسلا نم ءافشلا تلادعم ،مرولا ةيناودع ىلع اضيأ ءافشلا تلادعم دمتعت تلادعم فلتخت امك .هراشتنا ةعرس ىدم يأ .همدقت ةلحرمو ناطرسلا عون ىلع ادامتعا ءافشلا رثكأ ىقتلملاو دبكلا ىرجمو سايركنبلا ناطرسف .رشع ينثلإا ناطرس نم جلاعلا يف ةبوعص ديدحت يف اهرودب مهست ةحارجلا ةينقت نإف ،كلذكو مرولل لماك لاصئتساب موقن ثيح ،ءافشلا تلادعم ةفاضلإاب )R0 Resection( هفارطأ نع داعتبلإا عم .ةيوافيمللا ددغلا لاصئتسا ىلإ اعبط نأ يغبني يذلا حارجلا ةربخ وهف يناثلا رملأا امأ تاربخ مكارت هيدلو لبيو ةحارج يف اصصختم نوكي حارجلا ةربخ دعت ثيح تايلمعلا نم عونلا اذه يف حاجنلا تلادعم ديدحت يف اماه لاماع هتاراهمو اهئارجإ ةرورض عم .تافعاضملا رطاخم ليلقتو ةيلاع تايناكمإب عتمتي صصختم يبط زكرم يف

يوئرلا ليهأتلا ةداعإ لضفأ لكشب سفنتلاو ةايحلا ةيعون ينسحت يبط تاجلاع ةدعاسلم لماش جهن يه ةئرلا ليهأت جمارب سيفنتلا زاهجلا ضارمأ نم نوناعي نيذلا دارفلأا سفنتلا لىع مهتردق ينسحت لىع ةنمزلما برع لضفأ لكشب ةيمويلا ةطشنلأاب مايقلاو جهن هنإ ؛ضارعلأا ليلقتو ةئرلا فئاظو ينسحت لىع بيردتلا ينب عمجي تاصصختلا ددعتم .ةيكولسلا تلاخدتلاو ميلعتلاو نيرماتلا وه يوئرلا ليهأتلا ةداعلإ يساسلأا فدهلا يسفنتلا زاهجلا ةحصو ةيفيظولا ةردقلا نيسحت ضرم لثم ةنمزملا ةئرلا ضارمأ نم يناعي نمل فيلتلاو وبرلا COPD نمزملا يوئرلا دادسنلإا ضارعأ نم يناعي نمل هب ىصوي امك ،يسيكلا نم مغرلا ىلع ةيفيظو دويق وأ ةرمتسم ةيسفنت قيبطت متي ام ةداع .يسايقلا يبطلا جلاعلا يقلت نم يبط فارشإ تحت يوئرلا ليهأتلا ةداعإ جمانرب وأ ىفشتسملا يف تاصصختلا ددعتم قيرف لبق فلتختو ،صصختملا ليهأتلا ةداعإ زكرم وأ ةدايعلا يف امب ،ةفلتخم لماوع ىلع ادامتعا جمانربلا ةدم ؛ةلاحلا ةدشو ضيرم لكل ةددحملا تاجايتحلإا كلذ ليهأتلا ةداعإ جمانرب رمتسي ام ابلاغ ،كلذ عمو .رهشأ ةعضب ىلإ عيباسأ ةدع نم يجذومنلا يوئرلا 2024 )رايأ( ويام l 74
75 l 2024 )رايأ( ويام :ليي ام ةداع جمابرلا هذه نمضتت ةيضايرلا نيرماتلا لىع بيردت ام ،ةيندبلا ةقايللاو لمحتلا ةوق نيسحت فدهب يف ةكراشملاو لهسأ لكشب سفنتلا ىلع دعاسي .ةيمويلا ةيندبلا ةطشنلأا قيهشلا تلاضع بيردت ةردق نيسحتو سفنتلا تلاضع ةيوقتل نم نسحي ام ،قيمع سفن ذخأ ىلع ضيرملا .سفنتلا ةيلمع ةءافك ىضرملا ديوزت ربتعي :ةيعوتلاو فيقثتلا هعم لماعتلا بيلاسأو مهضرم لوح تامولعملاب ةيفيك ىضرملا ملعتيس ثيح ،ةمهملا روملأا نم ةيدؤملا لماوعلا بنجتو لضفأ لكشب مهتلاح ةرادإ .ضارعلأا مقافتل هذه لمشت دق :ةيكولسلاو ةيسفنلا تلاخدتلا وأ يسفن يئاصخأ عم ةراشتسا تاسلج جماربلا لماعتلا ىلع ىضرملا ةدعاسمل يعامتجا يئاصخأ زاهجلا ضارمأ بحاصي دق يذلا قلقلاو رتوتلا عم .ةنمزملا يسفنتلا ةمئلام ةصرف ةئرلا ليهأت جمارب لكشت ،عقاولا يف نيباصملا صاخشلأا ةايح يف يباجيإ رييغت ثادحلإ يف ةكراشملا للاخ نمف ،ةنمزملا ةئرلا ضارمأب ةرطيسلا ضيرملل نكمي جماربلا نم عونلا اذه لثم ةديدج تاراهم ملعت للاخ نم ةيحصلا هتلاح ىلع ضارعلأا عم لماعتلاو لضفأ لكشب ضرملا ةرادلإ سفنتلا ةيفيك ملعت ىلإ ةفاضلإاب ،ةيمويلا مايقلا ىلع ةردقلا ضيرملا بستكيف ربكأ ةلوهسب يف ةكراشملاو لهسأ لكشب ةيمويلا ةطشنلأاب .ةيلعاف رثكأ لكشب ةايحلا سفنتلا ينسحت جمارب نم يساسأ ءزج ةيضايرلا نيرامتلا ربتعت فلتخت نكلو ،سفنتلا نيسحت فدهب ةئرلا ليهأت نيرمت جمانرب ميمصت متي ثيحب ةلاحلا فلاتخاب نكمي .هتاردقو هتاجايتحا ىلع ءانب ضيرم لكل يدرف :يلي ام نيرامتلا عاونأ لمشت نأ قيهشلا تلاضع ةيوقت سفنتلا تلاضع ةيوقت ىلإ فدهت نيرامت يهو نم ربكأ ةيمك لاخدلإ قيهشلا ةيلمع نع ةلوؤسملا .نيتئرلا ىلإ ءاوهلا لمحتلا نيراتم ضيرملا ةردق ةدايز نم نيرامتلا هذه مهست عمو ،لوطأ ةدمل ةيندبلا ةطشنلأاب مايقلا ىلع مايقلا لهسيو بعتلاب روعشلا ضفخني تقولا .ةيمويلا تابجاولاب ةوقلا نيراتم اهيف امب تلاضعلا ةيوقت ىلع نيرامتلا هذه دعاست سفنتلا ةيلمع نسحتتف ،يسفنتلا زاهجلا تلاضع .لمحتلا ىلع ةردقلا ديزتو ليضعلا يبصعلا ئيابرهكلا زيفحتلا مادختسا ىلإ بيبطلا أجلي دق ،تلااحلا ضعب يف نيسحت ىلع ةدعاسملل يئابرهكلا زيفحتلا ةينقت .تلاضعلا رومض جلاعو ةيلضعلا ةوقلا ةفيظو ئياوهلا بيردتلا يشملا لثم تاضايرلا عاونأ ضعب انه دوصقملاو ةرتفل لصاوتم لكشب ةيئاوهلا ةجاردلا بوكر وأ نيسحت ىلع ةدعاسملل ةلدتعم ةريتوب ةليوط نودب ةيمويلا ةطشنلأاب مايقلاو ةئرلاو بلقلا ةوق .سفنلا قيضب روعش ةحيحصلا ةيعضولا ذاختا ةحيحص تايعضو ذاختا ةيفيك ىضرملا ملعتي يتلا ةيمويلا ةطشنلأاو سفنتلا ءانثأ مسجلل لثملأا عيزوتلاو ردصلا ةنورم نيسحت يف مهست .نيتئرلا يف ءاوهلل طغضلا ةرادإ لىع بيردتلا ةرادإو ءاخرتسلإا تاينقت ىلع ىضرملا بيردت متي ليلقتو يسفنتلا قيضلا يف مكحتلل رتوتلا هذه .سفنتلاب طبترملا يسفنلا رتوتلاو قلقلا نيرامتو ،لمأتلاو ،قيمعلا سفنتلا لمشت تاينقتلا .يلضعلا ءاخرتسلإا ضىرلما فيقثت ةداعإ جمانرب نمض جردنت ىضرملا فيقثت تاسلج يف زراب رود نم اهل امل يساسأ لكشب ليهأتلا .ةيحصلا مهتلاح ةرادإ زيزعتو مهتايح ةيعون نيسحت تامولعم ميدقت متي ،ةيفيقثتلا تاسلجلا للاخ ةعيبطلا كلذ يف امب ةيحصلا مهتلاح لوح ةلماش ةيفيكو يسفنتلا زاهجلل ةيفيظولاو ةيحيرشتلا حيضوت متي امك .سفنتلاو نيتئرلا ىلع ضرملا ريثأت هروطت ىلع رثؤت يتلا لماوعلاو ضرملا ليصافت ىضرملا ميلعتل نويئاصخأ كانهو .همقافتو مهدعاست يتلا ةلاعفلاو ةحيحصلا سفنتلا تاينقت قيقحتو ةئرلا فئاظو مادختسا نيسحت ىلع كلذ نمضتي دق .نيتئرلا يف ءاوهلل لضفأ عيزوت يفيوجتلا سفنتلاو قيمعلا سفنتلا ىلع بيردتلا ةياقولاو ضارعلأا ةرادإ .ردصلا عيسوت نيرامتو ليهأتلا ةداعإ جمانرب تايساسأ نم مقافتلا نم عم لماعتلا ةيفيك ىضرملا ملعتي ثيح يوئرلا سفنتلا قيض لثم مهتلاحب ةطبترملا ضارعلأا فيفختلل تايجيتارتسا ريفوت ربع مغلبلاو لاعسلاو تاينقت كلذ يف امب ،اهمقافت بنجتو ضارعلأا نم .ةيودلأل حيحصلا مادختسلااو ةحارتسلااو سفنتلا فطاوعلا عم لماعتلا ىلع ىضرملا بيردت متي امك يسفنلا معدلا بناج ىلإ ةيسفنلا طوغضلاو ةيحصلا مهتلاح نع ةمجانلا فطاوعلا عم لماعتلل تاسلج ريفوت نكمي .ةيلقعلا ةحصلا نيسحتو معدلا تاعومجم يف ةكراشم وأ ةيسفن ةجلاعم نوناعي نيذلا نيرخلآا عم نواعتلاو تاربخلا لدابتل .اهسفن ةلاحلا نم ةايحلا طنم ضيرملا ميلعت يوئرلا ليهأتلا ةداعإ جمانرب لمشي يف هتيمهلأ ارظن يحص ةايح طمن ينبت ةيفيك يف اماه ارود بعليو ،سفنتلا قيض تابون بنجت ةحص نيسحتو يوئرلا ليهأتلا ةداعإ جمانرب حاجن ىضرملل ةروشملاو معدلا جمانربلا مدقي .ىضرملا يف مهاست ةيحص تاداع عابتا ىلع مهتدعاسمل .ضرملا ضارعأ نم دحلاو نيتئرلا فئاظو نيسحت ماعط لوانت ةيمهأ لوح تامولعم ريفوت متي زاهج ةيوقتو ةماعلا ةحصلا زيزعتل نزاوتمو يحص زاهجلا باهتلا لماوعب ةيعوت كلذ لمشي .ةعانملا ماظنلا ببسب مقافتت نأ نكمي يتلا يسفنتلا ىلع دارفلأا عيجشت متي امك .يحصلا ريغ يئاذغلا طاشنلاو ةبسانملا ةيضايرلا نيرامتلا ةسرامم يندبلا طاشنلا دعاسي .ماظتناب لدتعملا يندبلا ةردقو ةيسفنتلا تلاضعلا ةوق نيسحت ىلع .لضفأ لكشب نيجسكولأا مادختسا ىلع مسجلا جمانرب يف يعيبطلا جلاعلا يصصختمل نكمي بسانم نيرمت جمانرب ميمصت يوئرلا ليهأتلا ةداعإ .هتاردقو ضيرم لك تاجايتحلا ةرئاد نمض يوئرلا ليهأتلا ةداعإ جمانرب مدقي رتوتلا ليلقتل تاينقت ىضرملا ميلعت فيقثتلا امم ،لمأتلاو قيمعلا سفنتلا تاينقت لثم قلقلاو ةدايزو ضيرملل ةيسفنلا ةلاحلا نيسحت ىلع دعاسي .ضرملا ضارعأ عم لماعتلا ىلع هتردق

لماكلا مدلل رشابملا طلخلل ةيفاضإ ةخضم .بصلا ءانثأ جزاطلا ىلع لوصحلل يلصفملا فورضغلا ديلوت .واستم حطس ةءافك هذه ةيللآا ةئبعتلا تلاآ رفوت ،ماع لكشب ةئبعتلا قرطب ةنراقم ريثكب لضفأ اقاستاو ةقدو قاطنلا عساو جاتنلإل لثملأا رايخلا اهنأ امك .ةيوديلا تازيملا لضفب كلذو ،ةعرزملا طسو قابطلأ جاتنإ تلادعمو ةيلاع ةدوج نمضت يتلا ةمدقتملا ةفرغلا يوتحت ،يلاحلا دادعلإا ىلإ ةفاضإ .ةعفترم ةحاسم ىلع عينصتلل ميهفلا ةكرش يف ةفيظنلا ىلع ةرداق ،ةيفاضإ ةئبعت تلاآ باعيتسلا ةيفاضإ تلالآا هذه زيمتت .ةعاسلا يف قبط 4000 ةجلاعم فيلغتلا ماظن عم ةسلاسب اهجمد ةيناكمإب ةديدجلا ةدوجوملا تاقصلملا ةعابط ةطحمو يلاحلا نم ةصصخم ةقطنم ىلع يوتحت امك .اقبسم ةعابطلاو تاجاجزلاو بيبانلأا ةئبعتل 10,000 ةئفلا فرغ كانه ،كلذ ىلإ ةفاضلإاب .ربحلل ةثفانلا ةئف نم ةفنصم طئاسو ريضحتو ةيصخش لوخد .طغضلا ةلداعم قطانمك لمعت ،100,000 نم ةعومجم ىلع عينصتلل ميهفلا ةكرش دمتعت ،اهتاجتنم فلتخم فيلغتو بيلعتل ةثيدحلا تاينقتلا .جاتنلإا يف ةءافكو ةيلاع ةدوج نامضل كلذو ،تنرتنلإا ربع قابطلأل ربحلل ةثفانلا ةعابطلا لصحت .ايئاقلت يئاهنلا جتنملا ةعابط متت ثيح ربحلل ةثفان ةعباط كانه ،كلذ ىلإ ةفاضلإاب ةلآ دجوت .تاجاجزلاو بيبانلأل ايرصح ةصصخم ةلآ ةنايص ءانثأ مادختسلال ةزهاج شامكنلااب فيلغت نكمي ،كلذ ىلإ ةفاضلإاب .ةيكيتاموتولأا فيلغتلا ةليلق تايمكب ”راجأ“ طئاسو فيلغتل اهمادختسا ديربت فرغب عينصتلل ميهفلا ةكرش زيمتت .ادج حوارتتل ةقدب اهترارح تاجردب مكحتلا متي ةريبك نيزختل ةيوئم تاجرد 8 ىلإ نيتيوئم نيتجرد نم داوملل ةصصخم ةحاسم بناج ىلإ ،ةيئاهنلا تاجتنملا ىلإ ةفاضلإاب .ىرخلأا ةيكلاهتسلاا داوملاو ماخلا ىلإ 2 نم اهترارح ةجرد طبض متي ةجلاث دجوت ،كلذ نيزختل ةيطايتحا ةيراطبب ةزهجمو ،ةيوئم تاجرد 8 .ةيويحلا تاداضملاو ومنلا تلامكم حضانتلا ماظنب هايملا ةجلاعم ةطحم زيمتتو للاخ رتل 5000 جاتنإ ىلع رداقلا )RO( يسكعلا يضارتفا رمعب RO ءاشغ عتمتي امك .ةعاس 24 ةجلاعملاب هلامكتسا متيو تاونس 2-3 نيب حوارتي حيشرتلاو ،طخلا ربع ةيجسفنبلا قوف ةعشلأاب .ةيفاضإ سيفنت تاحشرمو ،)0.2um( طخلا ربع 77 l 2024 )رايأ( ويام

2024 )رايأ( ويام l 76 عينصتلل ميهفلا ايجولويبوركيلما ةعارز قابطأ جاتنإ في ةدئار ،بيد ةرامإ نم ”عينصتلل ميهفلا“ ةكشر ذختت يهو .اهل ارقم ،ةدحتلما ةيبرعلا تاراملإا ISO 13485 يرياعم عبتتو ،بيد ةيدلب نم ةدمتعم جاتنإ في ةروطتلما انتأشنم صتخت .GMPو .مادختسلال ةزهاجلا ايجولويبوركيلما قابطأ ةفرغ نمض لماكلاب ةيلآ جاتنإ طوطخ مدختسن عضخت ثيح ،ISO 7/Class 10,000 ةدمتعم ليسغ لىع ءانب ةمراص ةدوج تارابتخلا تاجتنلما عيمج .ISO 11133و CLSI M22 A3 يرياعم تاكرشلا نم ةدحاو عينصتلل ميهفلا ةكرش دعت ةيبرعلا تاراملإا ةلود يف ةرهش رثكلأا ةعنصملا قابطأ نم ةلماش ةعومجم مدقت ثيح ،ةدحتملا يبلت .مادختسلال ةزهاجلا ايجولويبوركيملا ةعارز يف امب ،تاعانصلا فلتخم تاجايتحا انتاجتنم نابللأا تاجتنمو ةيذغلأاو ةيبطلا تاربتخملا كلذ ةلود يف كلذو ،ةيرطيبلاو ةينلاديصلا تاربتخملاو سلجم لود ةقطنمو ةدحتملا ةيبرعلا تاراملإا .يجيلخلا نواعتلا عيمج يف ةدوجلا ريياعم ىلعأب ةكرشلا مزتلت تلاوكوتورب قيبطت متي ثيح عينصتلا لحارم عينصتلا ةيلمع ىلع ةلماكلا ةباقرلا نمضت ةمراص ةقيقدلا ةبقارملا ىلع ظفاحن نحن .اهبناوج فلتخمب ةمراص ريياعم ةاعارم عم جاتنلإا تايلمع ءانثأ ىلإ ةفاضلإاب .ةرياعملاو ،ققحتلاو ،ةدوجلا نامضل ةدوجلا ةبقارمل لماكلاب ازهجم اربتخم ريدن ،كلذ ،عقوملا يف هايملا ةدوج رابتخاو ةيجولويبوركيملا .ةيلاحلا ةيلودلا تاداشرلإاب مازتللاا نامضل ةفيظن ةفرغب عينصتلل ميهفلا ةكرش زيمتت يبلت ،يرتب قابطأ ةئبعتل ةصصخم )Cleanroom( 10,000 ةئفلا نم يهو ةيملاعلا ريياعملا ىلعأ .راتمأ 9 ـب ارتم 15 ةحاسمب ىلع ةرداق ةروطتم ةئبعت ةلآ ىلع انتأشنم يوتحت تادعم اهلمكت ،ةعاسلا يف قبط 2000 ةجلاعم ةفرغلا”ـب دوصقملاو .لماكلاب ةيلآ فينصتو فيلغت ةممصمو ةلوزعم ةقطنم )Cleanroom( ”ةفيظنلا عتمتت .عينصتلا ةأشنم وأ ربتخملا نمض اصيصخ ةدعملاو مراصلا مكحتلل ةعضاخ ةئيبب ةفرغلا هذه ةيانعب ايجولويبوركيملا ةعارز قابطأ ةئبعتو ريضحتل ةحاسم ىلع دتمتو ؛ةمقعم فورظ قفو ةمات ،ةءافكلا ةيلاع ةئبعت ةلآ باعيتسا اهنكمي ةصاخ يف قبط 4,000 ىلإ لصي ام ةجلاعم ىلع ةرداق عم لماكتم لكشب ةللآا هذه لمعتو .ةعاسلا ةدوجوملا لماكلاب ةيللآا مسولاو فيلغتلا ةمظنأ زيمتت ةلماكتم جاتنإ ةلسلس رفوي امم ،اقبسم ،عينصتلل ميهفلا ةكرش يف .ةيلاعلا ةءافكلاب متخلل لاباق افلاغ لمشت ةروطتم ةينقت مدختسن ةبلاص نم ززعي ام ،نافوليسلا يبناج ىلع ةرارحلاب ةيذافن يف مكحتلا عم ،ديربتلا فورظ يف قابطلأا يبوركيملا ثولت عنمل مهم رمأ وهو ةبوطرلا .يذغملا طسولا ةدوج ىلع ظافحلاو ططخ عم ،قبط 20,000 ةيجاتنلإا انتردق غلبت ،ايلاح تادعم لاخدإ دعب ايموي قبط 60,000 ىلإ اهتدايزل .ةيفاضإ ةئبعت تلاآو طئاسو دادعإ ميهفلا ةكرش يف يرتب قابطأ ةئبعت تلاآ زيمتت ةفلتخم ماجحأ عم لماعتلا يف اهصصختب عينصتلل 140و ،ملم 90و ،ملم 55 يهو ،قابطلأا نم يف قبط 2000 ىلإ لصت تاعرس ققحتو ،ملم يف قبط 800و ،ملم 55و ملم 90 عاونلأ ةعاسلا ءانب جاتنلإا تلادعم ددحت .ملم 140 قابطلأ ةعاسلا .قئاقد ثلاث فيفجت تقو ىلع ثلاث غلبت فيفجت ةدم ىلع جاتنلإا تلادعم دمتعت فيفجتل مزلالا تقولا باسح متي ثيح ،قئاقد ،ةئبعتلا ةيلمع دعب لماك لكشب ةعارزلا طسو .قابطلأا ءاقنو ةدوج نامضل كلذو ةكشر في يترب قابطأ ةئبعت تلاآ زيمتت تادحوب ةزهجم اهنأب عينصتلل ميهفلا ةيلاعو ةقيقد ةئبعت نمضت ةروطتم ةيسايق ثيح ،ايجولويبوركيلما قابطلأ ةدوجلا :لمشت ءاوه ةرتلفب ةقلغم فيفجت ةئيب ةياهن دنع ةيفاضإ HEPA ةرتلفو ،HEPA .يقلتلا فرطلا صلختلل حوتفم ءاطغب فيفجت ماظن ءانثأ فثكتلا ليلقتو ةدئازلا ةبوطرلا نم .نيزختلاو لقنلا فيفجت ةدم يف مكحتلل لباق فيفجت تقو .قابطلأا لخاد يذغملا طسولا .نمازتملا بصلل ةجودزم فيواجت ةيبط تاسسؤم

ةدحتلما ةيبرعلا تاراملإا ،بيد .جيلخلا زرأ عنصم لباقم .2 رماثتسلال بيد عمجم LLC, 597-4217 م.م.ذ عينصتلل ميهفلا :عنصلما ناونع با ستاو فتاه info@alfahimhealth.com :نيوتركللإا ديبرلا www.alfahimhealth.com :نيوتركللإا عقولما رابتخلا ناويح لك مد عضخي ،تاعفدلا جاتنلإ مدلا جرختسم ناويح لك ىلع ةملاع عضو متي .لماش مازتللإا متيو .عبتتلاو فيرعتلا ضارغلأ ،هنم ةمراصلا ةيجولويبوركيملا ةدوجلا ةبقارم تاءارجإب مانغلأا مد نم ةعفد لك ىلع ةقفاوملا لبق ةصصختم ةللاس ظفاحت .جاتنلإا يف اهمادختسلا ايرصح ظاظتكلإا ةيلاعلا ايلاخلا مجح تاذ مانغلأا نم مانغلأا مدل يضارتفلاا رمعلا غلبيو .ضرغلا اذهل لك تابلطلا ريودت متيو ،اموي 56 طلجتلا لازملا قابطأ طئاسو جاتنلإ فاك نوزخم نامضل اموي 20 .عينصتلل ميهفلا ةكرش يف ”راجأ”ـلا طئاسولل ةمدختسملا داوملا ىلع لوصحلا متي تاداضملا تلامكمو ،ومنلا تلامكمو ،ةففجملا ،ةدحتملا ةكلمملا ،Oxoid, Ltd ةكرش نم ةيويحلا ىلع ظافحلل .ماخلا داوملل زراب دروم يهو نوزخملا ريودت متي ،نوزخملا نم ةيفاك تايوتسم عضخت .يبد يف انتاعدوتسم يف رهشأ 4 لك ،اهقلاطإ لبق ةمراص تارابتخلا ديوسكوأ تاجتنم ISO/ تلاوكوتوربب عينصتلل ميهفلا ةكرش مزتلتو ماخلا داوملا رابتخا للاخ نم اهب لومعملا GMP .ينيتور لكشب ةدراولا لماكلاب ازهجم اربتخم عينصتلل ميهفلا ةكرش ريدت ءارجلإ ةدوجلا ريياعم ىلعأ قيبطتب اهنم امازتلا .جاتنلإا نم ةعفد لك ىلع ةلماشو ةقيقد تارابتخا لثم ةيساسأ تاودأ ريفوتب ربتخملا اذه زيمتي ،ATCC تلالاس نيزختو ظفحل ةقيمعلا تادمجملا ،نوبركلا ديسكوأ يناثو ةيجولويرتكبلا تانضاحلاو داوملاو ،ةضومحلا ةجردو ،ةيويحلا ةملاسلا ةنازخو تاجلاثو ،ةيلصوملا سايق ةزهجأو ،ةبئاذلا ةبلصلا ريفوت متي .كلذ ريغو ،رهاجملاو ،تاربتخملا اهميلست متي ةعفد لك عم ةدوجلا ةبقارم تاداهش .جتنملا ةملاس نامضل جتنملا ليصوتب عينصتلل ميهفلا ةكرش موقت متي ةدربم تانحاش يف ءلامعلا ىلإ يئاهنلا 2 نيب حوارتت ةرارح تاجرد دنع اهيلع ظافحلا تايلمع دتمت .ةيوئم تاجرد 8 ىلإ ةيوئم ةجرد تاراملإا ةلود يف ءلامعلا ىلإ انيدل ميلستلا يجيلخلا نواعتلا سلجم لودو ةدحتملا ةيبرعلا نحشلا ربع ةددحم ةيلود تاهجو ىلإو ةرواجملا زكرم ةباثمب يلودلا يبد راطم دعي .يوجلا امم ،طسولأا قرشلا يف انتايلمعل يسيئر .لاعفلا لقنلا لهسي دعبأ وه ام ىلإ دتمي راكتبلااب انمازتلا نإ ةيساسلأا تاودلأا دوجو عمف ،جاتنلإا نم لقأ مدقن لا اننإف ،ةمراصلا رابتخلاا تلاوكوتوربو جاتنإ ةعيلط يف اننوكب نوروخف نحن .زيمتلا نم ةيبرعلا تاراملإا ةلود يف ايجولويبوركيملا قابطأ .اهجراخو ةدحتملا 79 l 2024 )رايأ( ويام




2024 )رايأ( ويام l 78 ةيبط تاسسؤم يسايق جنيتارب تانويلأا ةلازإ ةناوطسأ زيهجت مت ديدجتلا ىلإ ةجاحلا يغلي امم ،طلتخم )يوق( لادبتسا متي .ضامحلأا وأ تايولقلا مادختساب .ةنسلا يف ةدحاو ةرم طلتخملا جنيتار ةدوزم ةثيدح ةمظنأ قابطلأا ريضحت تادعم لثمت نيتعسب ةرفوتمو لماكلاب ةيلآ مكحت تاحولب لماعتلا ةيناكمإ حيتي امم ،رتل 50و رتل 30 نيتفلتخم تارتل 5و رتل 30 ىلإ رتل 2.5 نم حوارتت ماجحأ عم .يلاوتلا ىلع رتل 50 ىلإ ةءارب ىلع لصاح ةءافكلا يلاع كيرحت ماظنب زيمتت لاوط لماك لكشب طئاسولا طلخ نمضي ،عارتخا كرحملا ةعرس طبض متي .اهلمكأب ليغشتلا ةرود متي امك ،اهدادعإ متي يتلا طئاسولا عونل اقفو .تاعاقفلل نيوكت يأ ىلع ءاضقلل كرحملا ميمصت ىصقأ دح يف جتني نأ رتل 30 جذومنلل نكمي 50 جذومنل نكمي امنيب ،ةرود لكل قبط 1500 ةرود يف قبط 2500 ىلإ لصي ام جتني نأ رتل تارم ثلاث وأ نيترم ةرودلا راركت رايخ عم .ةدحاو نم ةفدهتسملا ةيمكلا قيقحت نإف ،مويلا يف قلغي ءاطغ ناملأا تازيم لمشت .نكمم جاتنلإا ةجرد 80 ىلإ ةرارحلا ةجرد لصت امدنع ايئاقلت ىلإ ،ةفلتخملا لفقلا تايلآ مادختساب .ةيوئم ةدوجوملاو ،ةعومسملاو ةيئرملا تاراذنلإا بناج رطاخملا ليلقت متي ،تامدصلل ةداضم ةبلع لخاد ةيكيناكيملا ريضحتلا قرطب ةنراقم ريبك لكشب ريدصتو لماكلا عبتتلا لهسي .طئاسولل ةيديلقتلا لهسي امم ،USB ةهجاو ربع ةلوهسب تانايبلا فيظنتلا .لمعلا قفدت نسحيو ليغشتلا تايلمع .ءاعولا لفسأ عقت فيرصت ةيلآ ةطساوب ،لهس يقيقحلا تقولا يف تانايبلا ةبقارم نيكمت متي زاهجب تنرتنلإاو Wi-Fi ـلا ربع لاصتلإا للاخ نم متي .يحوللا زاهجلا وأ يكذلا فتاهلا وأ رتويبمكلا رايخ عم ،ايلحم اهنيزختو ةقدب ةرود لك ليجست ةطساوب )CSV وأ PDF ةغيصب( تانايبلا ريدصت ”راجأ”ـلا قابطأ نم 45% ابيرقت كانه .USB مد بلطتت عينصتلل ميهفلا ةكرش اهجتنت يتلا نواعتن ،رملأا اذه ةيبلتل .طلجتلا لازملا مانغلأا يف ةيانعب يرطيب فارشإ تحت مانغأ ةعرزم عم اصيصخ ةممصم عمج سايكأ مدختست .ادنلتكسا عيمجت لبق.مانغلأا مد جارختسلا ةصصخم تاودأو

81 l 2024 )رايأ( ويام ةملاسلا معدل ةمراص ريياعمو ةيهيجوت ئدابم ززعي ام ،ةيحصلا ةياعرلا نكامأ يف ةيعاعشلإا نيلماعلاو ضيرملا ةملاس نامضل ةذختملا ريبادتلا .ةيحصلا ةياعرلا لاجم يف ءايزيفلل لبقتسلما هلمحي يذلا ام ضارملأا جلاع ديعص لىع ةيعاعشلإا ؟ةيصعتسلما وأ اهجلاع بعصي يتلا ىلع ،يعاعشلإا جلاعلا ةيمهأب رارقلإا دادزي ضارملأا ةرادإ يف ةيويح ةادأك ،ديدحتلا هجو عاونأ اهنمو ،اهجلاع بعصي يتلا وأ ةيصعتسملا .ةيبصعلا تابارطضلااو ناطرسلا نم ةنيعم رفوت ةيوق ةيجلاع ةقيرط لثمي نوتوربلاب جلاعلاو مارولأل عاعشلإا نم ةقدب ةفدهتسم تاعرج ةطيحملا ةميلسلا ةجسنلأل ضرعتلا لعج عم ،كلذ ىلع ةولاعو .نكمم قاطن قيضأ نمض ريوصتلا لثم ،ةمدقتملا ريوصتلا قرط جمد نإف فورعملا( ينورتيزوبلا ثاعبنلااب يعطقملا هجوملا يعاعشلإا جلاعلاو )PET مساب اراصتخا طيطختلا ززعي نأ هنأش نم ،يسيطانغملا نينرلاب نيسحت يف مهسي ام ،ةيفادهتسلاا هتقدو جلاعلل .ةبعص ضارمأب نيباصملل ةيجلاعلا ةليصحلا ملع يف ةيراجلا ثاحبلأا يقلت ،كلذ ىلإ ةفاضلإابو ىلع ءوضلا مارولأا ايجولويبو يعاعشلإا ءايحلأا يئيزجلا يعاعشلإا جلاعلا لثم ،ةيراكتبا ةيجلاع جهن قافآ اهل يتلا ،يعانملا عاعشلإاو فدهتسملا ةيجلاعلا ةليصحلاو جلاعلا ةيلاعف نيسحت يف ةدعاو .اهجلاع بعصي يتلا ضارملأا يف تايجولونكتلاو ةيعاعشلإا ءايزيفلا نيب رزآتلاو ايجولونكتلاو يعانطصلاا ءاكذلا لثم ،ةئشانلا نم جلاعلا جذامن يف ةيروث ةلقن ثدحي تاب ،ةيونانلا ةيفيكتلا يعاعشلإا جلاعلا بيلاسأ نيكمت للاخ .صخش لك ةلاح ىلع ةمئاقلاو قيبطت في ةثيدح تاروطت ةثم له ؟ةددحم وأ ةنيعم ضارمأ جلاعل ءايزيفلا رمياهزلأ لثم ضارمأ ةجلاعم تمت ،ايديلقت تاجلاعلاو ةيئاودلا تلاخدتلا للاخ نم نوسنكرابو تايجولونكتلا مويلا مدقت نيح يف ،ةيكولسلا ةيراكتبا تاراسم ءايزيفلا ملع يف ةرذجتملا ةئشانلا روطت ةمثو .ةقوبسم ريغ تاجلاع فاشكتسلا زيفحتلا قيبطت يف لثمتي ددصلا اذه يف مهم .نوسنكراب ضرم جلاع يف )DBS( غامدلل قيمعلا ريغ تاينقت ترهظ ،رمياهزلأ ضرم يف ،لثملابو يسيطانغملا زيفحتلا لثم ،غامدلا زيفحتل ةعضاب ربع رشابملا رايتلا زيفحتو )TMS( ةمجمجلا ربع ناتيجلاعلا ناتقيرطلا ناتاهو ،)tDCS( ةمجمجلا تاودأ جمد نإف ،كلذ ىلإ ةفاضلإابو .ناتدعاو ملع ىلع ةمئاقلا ةيبوساحلا ةاكاحملاو ةجذمنلا تايمانيدلا نع ةميق ةقمعتم ةيؤر انيطعي ءايزيفلا نمو .ةيبصعلا ةيسكنتلا ضارملأل ةدقعملا نيثحابلل نكمي ،ةيبصعلا تاكبشلا ةاكاحم للاخ ةيجلاعلا ةليصحلاب ؤبنتلاو ضارملأا تايلآ فاشكتسا امب اصيصخ ةممصملا ةيجلاعلا تلاخدتلا نيسحتو .ةيدرف ةيضرم ةلاح لك عم قفاوتي ءايزيفلا جامدإ مهلما نم هنأ نورت له ؟ةيبطلا جهانلما في عطاقتت يهو ةيساسلأا مولعلا دحأ يه ءايزيفلا ناك نإو ،ابيرقت ةفاك ةيبطلا تاصصختلا عم امتح سوملم روضح ءايزيفللو .رشابم ريغ لكشب كلذ ،حيرشتلاو باصعلأا ملعو ءاضعلأا فئاظو ملع يف مهف بعصي يئيزجلا ىوتسملا ىلع ىتحو نود ناسنلإا مسج لخاد ةدقعملا تلاعافتلا نوضغ يفو .ءايزيفلا ملع ئدابمل مكحم مهف ،ةمداقلا ةنس ةرشع سمخلا ىلإ رشعلا تاونسلا ءاربخ ىلإ ءابطلأا لوحت دهشن نأ حجرملا نم وأ ثوحبلا لثم ىرخأ تاصصختو بطلا نيب نوعمجي ليلحت وأ ةسدنهلا وأ ءايزيفلا وأ يعانطصلاا ءاكذلا لك نم عقوتن لا ،لاحلا ةعيبطبو .ةمخضلا تانايبلا نكل ،نييئايزيف اونوكي نأ لبقتسملا يف ءابطلأا ملع تايساسأب نيملم اونوكي نأ مهيلع نيعتي مهتيسفانت ززعي نأ كلذ نأش نم نلأ ءايزيفلا تاريغت دهشت يتلا ةيبطلا ةسرامملا لاجم يف ىرخلأا مولعلاو ءايزيفلا ملع جامدإو .ةعراستم ليهأتو دادعلإ ةيرورض ةلأسم بطلا ميلعت يف نومستي نيذلا ةيحصلا ةياعرلا لاجم يف رداوكلا فيكتلا ىلع نيرداقو ،ةلماكتم تاءافكو تاردقب ةيحصلا ةياعرلا عاطق تايدحت عم ةيلاعفب لماعتلاو .لبقتسملا يف ءايزيفلا لبقتسم نوروصتت فيك ؟بطلا في ةيعاعشلإا بطلا يف ةيعاعشلإا ءايزيفلا لبقتسم دعي يف ةقرافلا تلاوحتلا ديعص ىلع ةلئاه تاناكمإب امنيبو .ىضرملا ةياعرو اهجلاعو ضارملأا صيخشت ايجولونكتلا يف تاقارتخاو تازاجنإ قيقحت لصاون ،ةقوبسم ريغ قافآ وحن امهب قلاطنلااو راكتبلااو ةلأسم نييئايزيفلاو ءابطلأا نيب نواعتلا نوكيس مدقي ثيح ،ةيؤرلا هذه قيقحت يف ةيمهلأا ةغلاب رظن تاهجوو ةقمعتم ةيكينيلكإ ىؤر ءابطلأا نويئايزيفلا مهسي امنيب ،ضيرملا لوح روحمتت ةعاطتسابو .ةيليلحتلا تاراهملاو ةينقتلا ةفرعملاب ،مهدوهج ترفاضت ام اذإ ،نييئايزيفلاو ءابطلأا ةليصحلا نيسحتو ،ةقوبسم ريغ ةيجلاع قرط راكتبا ةياعر ريياعمب ضوهنلا فاطملا ةياهن يفو ،ةيجلاعلا .ملاعلا ءاحنأ عيمج يف ىضرملا

2024 )رايأ( ويام l 80 ةلباقم نأ هل قبس دقو ،رطق – بطلل لينروك لياو في ءايزيفلا ذاتسأ وه فسوي دمحم روتكدلا وهو .ليفسدراودإ - يونيلإ بونج ةعماج في ءايزيفلا ملع في كراشم ذاتسأ بصنم لغش مولعلا تاصصختل اصيصخ ةدعلما ءايزيفلا جهانم سرد ثيح ،ينسرمتلما ينييمداكلأا نم لمشتو .يويحلا بطلا ءايزيفو ةيديهمتلا ةينهلما جمابرلا سيردت لىإ ةفاضلإاب ،ةيبطلا لىع نهارلا تقولا في فكعيو ،ةيلكيهلاو ةيئيزجلا ةيويحلا ءايزيفلا ةيثحبلا هتامماتها روتكدلا .بطلاو ةيئيبلا ةيويحلا ءايزيفلاو )اتاد غيب( ةمخضلا تانايبلاب قلعتت ةيثحب تاراسم ،اديرولف ةيلاو ةعماج نم ةيئيزجلا ةيويحلا ءايزيفلا في هاروتكدلا ةجرد لىع لصاح فسوي ةلجم .يونيلإ بونج ةعماج نم ةيحصلا ةياعرلا ةيتامولعم في مولعلا يرتسجام ةجردو ءايزيفلا ميهافم نع اهيف ثدحت فسوي دمحم روتكدلا عم ةلباقم ترجأ بيرعلا ىفشتسلما .ابيرقت ةفاك ةيبطلا مولعلاب اهئاقتلا هجوأو ةيبطلا مولعلل ةبسنلاب ةيساسلأا اهتيمهأو ؟بطلاب ءايزيفلا ةقلاع ام لثمت يتلا ةيساسلأا مولعلا دحأ يه ءايزيفلا نم ءادتبا ،ثيدحلا بطلا بناوج نم ريثكلل ةماعد ءاهتناو ،يصيخشتلا ريوصتلا نكمي يذلا عاعشلإا ةدوجوم ءايزيفلاو .ةيبطلا تاجلاعلل قيقدلا ذيفنتلاب ئدابملا مهفو .ناكم لك يف انب طيحتو انلوح ةيبطلا نهملا باحصلأ حيتي ءايزيفلل ةيساسلأا تايجيتارتسلإا قيقحتو ةقئاف تايجولونكت ريوطت .ضيرملا ةملاس نامضو ةيلاثملا ةيجلاعلا اهتيمهأو ةيعاعشلإا ءايزيفلا انل فرع .بطلا لاجم في ةصصختملا عورفلا دحأ يه ةيعاعشلإا ءايزيفلا تايكولسو تامس فشكتستو ،ءايزيفلا ملع يف ،بطلا يفو .ةفلتخملا عاعشلإا عاونأ تاريثأتو تاعاعشلإا ةسارد ةيعاعشلإا ءايزيفلا لمشت ،اماغ ةعشأو ةينيسلا ةعشلأا لثم ،ةنيؤملا يف ةمدختسملا ةنيؤملا ريغ تاعاعشلإاو لاجملا اذهلو .ةيجلاعلاو ةيصيخشتلا تاقيبطتلا ،ةيبطلا تاصصختلا نم ديدعلا يف ةيروحم ةيمهأ يوونلا بطلاو يعاعشلإا جلاعلا كلذ يف امب عمو ،كلذ ىلع ةولاعو .ةيصيخشتلا ةعشلأاو ءايزيفلا دهشت ،يعانطصلاا ءاكذلا ةبقح انلوخد ريسفت يف ةقوبسم ريغ تاروطت ةيعاعشلإا ةيجلاعلا ةيجهنملا طيطختو يبطلا ريوصتلا .يصخشلا بطلاو ءايزيفلاب ايمانتم ايميلقإ امامتها انسمل دقو نيرضاحلل ةيسايقلا دادعلأا يف دسجت ةيعاعشلإا ارخؤم اهانفضتسا لمع ةقلح يف نيكراشملاو يذلا رمتسملا يبطلا ميلعتلا ةطشنأ راطإ يف تقلا دقف .رطق - بطلل لينروك لياو اهدقعت يف ةيعاعشلإا ءايزيفلا لبقتسم“ لمعلا ةقلح باحصأ نم ةعساو ةعومجم ىدل ىدص ”بطلا ةقلح مهل تحاتأ نيذلا نيصصختملا ةيحصلا نهملا ءاملعلا زربأ نم ةبخن ىلإ ءاغصلإا ةصرف لمعلا تاراسملاو تاروطتلا ثدحأ نأشب نييلودلا اصصخت اهتفصب ةيعاعشلإا ءايزيفلل ةلمتحملا ءايزيفلل تاصصختلا ددعتم نواعتلا نأشبو ،ايمانيد ةلصلا ةقيثولا تلااجملا نم ديدعلا عم اهعطاقتو .يعانطصلاا ءاكذلاو ةيويحلا اكيناكيملا لثم ،بطلاب تاينقتلا في عاعشلإا نامأ ىدم ام ؟ةيبطلا ةيبطلا تاينقتلا يف عاعشلإاب ةطيحم فواخم ةمث زييمتلا مهملا نم نكلو ،ةموهفم ةلأسم هذهو ةنيؤملا ريغ تاعاعشلإاو ةنيؤملا تاعاعشلإا نيب .لاعف لكشب ةملاسلاب ةقلعتملا فواخملا ديدبتل ةينيسلا ةعشلأا لثم ،ةنيؤملا تاعاعشلإاف تانورتكللإا ةلازلإ ةيفاك ةقاطب مستت ،اماغ ةعشأو ابلاغو .اهنيأت مث نمو ،تارذلا نم ةدشب ةقصتلملا يف ةقاطلا قئافلا عاعشلإا اذه مدختسي ام ريوصتلا لثم يصيخشتلا ريوصتلا تاينقت ،ةيعطقملا ةعشلأاو ،ةينيسلا ةعشلأاب يعاعشلا يفو .يوونلا بطلا تاءارجإو ،يعاعشلإا جلاعلاو اهنأ لاإ ،ةياغلل ةلاعف ةنيؤملا تاعاعشلإا نأ نيح فلاتإ ىلع اهتردق ببسب ةلمتحم رطاخم لمحت نكل .يولخلا ىوتسم ىلع ةيجولويبلا ةجسنلأا كلذ يف امب ،ةمراص ةملاس تلاوكوتورب قبطت تائيبلا يف ،ةيلاثملا ةعرجلا ميدقتو عيردتلا زجاوح ىضرملا لاطت دق يتلا رطاخملا ليلقتل ةيبطلا .نييحصلا نيلماعلاو تاعاعشلإا مدختست ام ابلاغ ،لباقملا يفو تاجوملاو ،ةيويدارلا تاجوملا لثم ،ةنيؤملا ريغ ءوضلاو ،ةيتوصلا تاجوملاو ،ةيوركملا وأ ةيرغصلا ريوصتلا لثم ةيبطلا تاقيبطتلا يف ،يئرملا تاجوملاب ريوصتلاو )MRI( يسيطانغملا نينرلاب ةنمآ لئادب تاينقتلا هذه لثم دعتو .ةيتوصلا قوف .ةنيؤملا تاعاعشلإا ىلع ةمئاقلا ريوصتلا قئارطل نيتينقتلا نيتاه نأ ىلإ انه ريشن نأ دب لاو رملأا ،نيتعضاب ريغ وأ نيتيقارتخا ريغ نيتيعاعشلإا .امهتملاس ززعي يذلا ةملاسلل ةلماش جمارب ةيبطلا قفارملا يف قبطتو تاعاعشلإل نملآا مادختسلاا لفكي امب ةيعاعشلإا .ةيجلاعلاو ةيصيخشتلا تاءارجلإا يف ةنيؤملا ةيميظنتلا تائيهلا قبطت ،كلذ لك ىلإ ةفاضلإابو فسوي دمحم روتكدلا رطق - بطلل لينروك لياو -ءايزيفلا ذاتسأ ةماعد لثتم يتلا ةيساسلأا مولعلا دحأ يه ءايزيفلا“ ”ثيدحلا بطلا بناوج نم يرثكلل

لىكلا ليسغ تاينقت مدقت ضىرملل لضفأ ةايح وحن ةلهذم تاوطخ ةزهجأ ءاوس ،لىكلا ليسغ تاينقت تدهش ةلئاه تاروطت ،نيوتيبرلا وأ يومدلا ليسغلا ةلوهسو اهلمع ةءافكو ةقد ينسحت لىإ تدأ ظوحلم لكشب اهتافعاضم ليلقت عم ،اهمادختسا مدقتلا دعيو .ماع لكشب ضىرلما ةحص ينسحتو لئاه زاجنإ ةباثبم لىكلا ليسغ تاينقت في ضىرم ةايح ينسحت في يربك لكشب مهاسي اذه في تاروطتلا رارمتسا عمو .يولكلا لشفلا ضىرلم اقاشرإ ثركأ لبقتسم لىإ علطتن ،لاجلما .ةحص ثركأو لوطأ ةايحب اوظحيل لىكلا يف اقيقد امكحت ةثيدحلا ىلكلا ليسغ ةزهجأ رفوت ،لئاسلا ةرارح ةجردو مدلا طغض لثم ،ليسغلا ريياعم امك .ضيرم لكل صصخم جلاع ريفوت حيتي امم مومسلاو تلاضفلا ةلازإ ىلع ةزهجلأا هذه دعاست ةزهجأ تحبصأ امك .ةيلاعف رثكأ لكشب مسجلا نم ،مادختسلإا يف ةلوهس رثكأ ةثيدحلا ىلكلا ليسغ لزنملا يف ىلكلا ليسغ ءارجإب ىضرملل حمسي ام لكشب ىفشتسملا يف دجاوتلا ىلإ ةجاحلا نود نم اهل ناك ىلكلا ليسغ تاينقت يف تاروطتلا .مئاد لثم تافعاضم ثودح رطاخم ليلقت يف مهم رود نيسحت يلاتلابو ،ىودعلاو مدلا طغض ضافخنا ىلع مهتردق ةدايزو ،ماع لكشب ىضرملا ةايح ةيعون تاروطتلا هذه ريثأت رهظي .ةيعيبطلا مهتايح ةسرامم نوشيعي نيذلا ىضرملا صصق للاخ نم حوضوب ليسغل مهعوضخ نم مغرلا ىلع ايبسن ةيعيبط ةايح .ةليوط تارتفل ىلكلا لىكلا ليسغ يرغ فيك ؟ضىرلما ةايح يف نمكي ةاجنلل ديحولا لملأا ناك ،يضاملا يف ىلع لوصحلا صرف نكل ،ىلك ةعارز ؛ةياغلل ةليلق تناك بسانم وضع ليسغ ةزهجأ روهظ عم تريغت ،ةثيدحلا ىلكلا ةزهجلأا هذه تحبصأو يرذج لكشب ةروصلا هذه ةلازإ نم مهنكمت ثيح ،ىضرملل ةاجن قوط ةباثمب ىلع ظافحلاو ،مسجلا نم مومسلاو تلاضفلا مهتايح ةيعون نيسحتو ،نداعملاو لئاوسلا نزاوت ىضرملا ةايح ىلكلا ليسغ لهس .ريبك لكشب نع جتانلا توملا عنمي لااعف اجلاع حبصأ ثيحب شيعلا نم ىضرملا نكمي امك ،يولكلا لشفلا مهتايح ةسراممب مهل حمسيف ،ايبسن ةيعيبط ةايح ةلازإ ىلع كلذك ىلكلا ليسغ دعاسي .ةيمويلا لوانتب ىضرملل حمسي ام ،مسجلا نم مومسلا ةحصو مهنزو ىلع ظافحلاو يعيبط لكشب ماعطلا مسجلا فئاظو ىلع ظافحلا ىلإ ةفاضإ ؛مهماسجأ يف ركسلا تايوتسمو مدلا طغض لثم ،ةيويحلا اريبك امازتلا ىلكلا ليسغ بلطتي ،كلذ عم .مدلا ليسغ تاسلجل عوضخلا يغبني اذإ ،ضيرملا نم ،يحص يئاذغ ماظن عابتاو ،مظتنم لكشب ىلكلا ةعباتم هيلع بجي امك .ةفوصوملا ةيودلأا لوانتو .بيبطلا عم يرود لكشب ةيحصلا هتلاح يومدلا لىكلا ليسغ يومدلا ىلكلا ليسغ ةزهجأ تاينقت روطتت اهمادختسا ليهستو اهئادأ نيسحتل رارمتساب قدأو ةءافك رثكأ ةزهجأ ريوطت متي .ىضرملا ةحارو تلااصتلاا ايجولونكتو ،مادختسلاا يف لهسأو نيب تانايبلا لدابتو دعب نع ةزهجلأا ةبقارمب حمست ىلكلا ليسغ ةزهجأ .ةيحصلا ةياعرلا قرفو ةزهجلأا مومسلا ةلازإ يف ةيلاع ةيلاعف تتبثأ يومدلا قيقدلا مكحتلا نع لاضف ،مسجلا نم تلاضفلاو وه يومدلا ىلكلا ليسغ .ليسغلا ةيلمع يف نم نوناعي نيذلا ىضرملل ةايحلا نايرشب هبشأ مدختست ةيويح ةيبط ةزهجأ اهنإ ؛يولكلا لشفلا لشفلا نم نوناعي نيذلا ىضرملا ةايح ذاقنلإ نم مدلا ةيفصت ىلع ةزهجلأا هذه دعاست .يولكلا لا يتلاو ،ةدئازلا لئاوسلاو تلاضفلاو مومسلا .يعيبط لكشب اهنم صلختلا ةلشافلا ىلكلل نكمي يف يومدلا ىلكلا ليسغ ةزهجأ ةيمهأ نمكت لشفلا نم نوناعي نيذلا ىضرملا ةايح ىلع ظافحلا مومسلا مكارتت ،ىلكلا ليسغ نودبف ؛يولكلا تافعاضم ىلإ يدؤي دق ام مسجلا يف تلاضفلاو ليسغ ةزهجأ دعاست امك .ضيرملا ةافوو ةريطخ ىضرملل ةايحلا ةيعون نيسحت ىلع يومدلا ىلكلا ةلازإ للاخ نمف ؛يولكلا لشفلا نم نوناعي نيذلا ىلع ةزهجلأا هذه دعاست ،تلاضفلاو مومسلا لثم ،يولكلا لشفلل ةبحاصملا ضارعلأا ليلقت يلاتلابو .نايثغلاو ةيهشلا نادقفو قاهرلإاو بعتلا نيذلا ىضرملل يومدلا ىلكلا ليسغ ةزهجأ حيتت ةيعيبط ةايح شيعلا يولكلا لشفلا نم نوناعي نكمي ،مظتنملا ىلكلا ليسغ عمف ؛ريبك دح ىلإ ةطشنلأا ةسراممو ةساردلاو لمعلا ىضرملل .ةريبك دويق نود نم ةيمويلا ضيرملا روضح ىلكلا ليسغ نم عونلا اذه بلطتي ةسلجلا رمتستو ،يرود لكشب ىفشتسملا ىلإ ةداع ضيرملا جاتحي .تاعاس 4 ةدمل ةداع ةدحاولا دق نكلو ،عوبسلأا يف ليسغ تاسلج 3 ىلإ للاخ .ضيرملا ةلاحو ةحص بسح ددعلا اذه فلتخي يف رممب ليسغلا زاهج ليصوت متي ،ليسغلا ةسلج مدلا بحس متي .)ضيرملا دي يف ابلاغ( ضيرملا مد يتلا رتلافلا نم ماظن ربع هريرمتو ضيرملا نم دعب .تلاضفلاو مومسلا نم مدلا ةيقنتب موقت .ضيرملا مسج ىلإ يقنلا مدلا ةداعإ متي ،كلذ نم ةداع ةزهجلأا هذه نوكتت :ةيلاتلا صرانعلا مدلا ةيقنت زاهج حشرمو )Blood Pump( مدلا رضحم نم نوكتي Blood( مدلا لصف ءاشغو )Dialyzer( مدلا ىلإ مسجلا نم مدلا بحس متي ؛ )Membrane هتيقنت متي مث ،مدلا ةخضم ةطساوب ةيقنتلا زاهج تلاضفلا ةلازإ متت .مدلا ءاشغ ربع هرورم قيرط نع داوملا تازيكرت ليدعتو مدلا نم ةدئازلا لئاوسلاو .هيف ةيئايميكلا ةيئايميكلا داولماو لئاوسلا ميظنت ماظن داوملاو لئاوسلا تازيكرت سايق ةزهجأ نمضتي تاجايتحلا اقفو اهميظنتو مدلا يف ةيئايميكلا لئاوسلا ةيمك يف ماظنلا اذه مكحتي .ضيرملا يتلا لئاوسلا ةيمكو مسجلا نم اهتلازإ متي يتلا .اهتفاضإ بجي ةبقارلماو مكحتلا ماظن ةبقارملل ةثيدحلا زليدلا ةزهجأ مادختسا متي ةبقارمو سايق متي .زليدلا ةيلمع يف مكحتلاو ةبقارم متتو ،لئاوسلاو مدلا قفدتو مدلا طغض .جلاعلا ءانثأ ضيرملل ىرخلأا ةيويحلا تارشؤملا 83 l 2024 )رايأ( ويام

ةيبط تاروطت













2024 )رايأ( ويام l 84 ةيتاذلا ةيقنتلا ةمظنأ ىلع يوتحت يومدلا ىلكلا ليسغ ةزهجأ ضعب يف ةمدختسملا تانوكملل ةيلآ فيظنت ةمظنأ يوديلا لخدتلا ىلإ ةجاحلا نم للقي ام ،جلاعلا .زاهجلا ةءافك نسحيو مدختسلما ةهجاو تاهجاو ىلع ةثيدحلا زليدلا ةزهجأ يوتحت نيضرمملل حمست مادختسلإا ةلهس مدختسم ضيرملل ةيويحلا تاملعملا طبضب ءابطلأاو .جلاعلا ريس ةبقارمو يف ةياغلل ةلاعف يومدلا ىلكلا ليسغ ةزهجأ دعت هذه نكمت .تلاضفلاو مومسلا نم مدلا ةيفصت ةيويحلا ءايميكلا نزاوت ىلع ظافحلا نم ةيلاعفلا .ةريطخلا تافعاضملا ثودح عنمو مسجلل نيوتيبرلا لىكلا ليسغ لشفلا جلاعل مدختست ةثيدح ةيبط ةينقت وه ،يومدلا ىلكلا ليسغل لااعف لايدب دعتو ،يولكلا ارايخ اهلعجت يتلا تازيمملا نم ديدعلاب زيمتتو ىلكلا ليسغ دعي.ىضرملا نم ديدعلل لاضفم نيذلا ىضرملا ةايح ىلع ظافحلل ايرورض ينوتيربلا ةيفصت للاخ نمف ؛يولكلا لشفلا نم نوناعي جلاعلا اذه دعاسي ،مدلا نم تلاضفلاو مومسلا ىلإ يدؤي دق امم ،مسجلا يف اهمكارت عنم ىلع ليسغ دعي .ضيرملا ةافوو ةريطخ تافعاضم ىلكلا ليسغ نم ةحار رثكأ ينوتيربلا ىلكلا ىلكلا ليسغ ءارجإ ىضرملل نكمي ثيح ،يومدلا باهذلا ىلإ ةجاحلا نود نم ،لزنملا يف مهسفنأب ةنورم حيتي امك .مظتنم لكشب ىفشتسملا ىلإ ةلودج ىضرملل نكمي ذإ ،ةايحلا طمن يف ربكأ نود نم مهبساني يذلا تقولا يف ىلكلا ليسغ ،يلاتلابو .ةددحم ديعاومب ديقتلا ىلإ ةجاحلا ةعرج ليدعتو هجلاع يف مكحتلا ضيرملا ناكمإب بيبطلا فارشإ تحت هتاجايتحا بسح جلاعلا ةضرع لقأ ينوتيربلا ىلكلا ليسغ دعي .صتخملا نمف ،يومدلا ىلكلا ليسغ نم ةيبناجلا ضارعلأل ىودعلا وأ مدلا طغض يف ضافخنا ثودح ردانلا .لصولا ناكم يف نيوتيبرلا لىكلا ليسغ ةيلمع متت :لياتلا وحنلا لىع ماع لكشب ةرطسقلا عرز ،نطبلا يف ةنيلو ةقيقر ةرطسق عرز متي لئاس تاسيك وأ سيكب نطبلا لصول مدختستو .ريدختلا تحت ايحارج ةيلمعلا هذه ءارجإ متي .ليسغلا نطبلا في لئاسلا عضو للاخ نم نطبلا يف ليسغلا لئاس عضو متي لولحم ىلع ليسغلا لئاس يوتحي .ةرطسقلا تلاضفلا صاصتما يف دعاسي صاخ يحلم .موينوتيربلا ربع مدلا نم ةدئازلا لئاوسلاو )رارقتسلإا( ليسغلا ةترف تقولا ضعبل كرتي ،نطبلا يف لئاسلا عضو دعب عم لعافتلاب لئاسلل حامسلل )رارقتسلإا ةرتف( ةدئازلا لئاوسلاو تلاضفلا صاصتماو موينوتيربلا .مدلا نم فيصرتلا لئاس فيرصت متي ،رارقتسلإا ةرتف ءاهتنا دعب اذه يوتحي .ةرطسقلا للاخ نم نطبلا نم ليسغلا مت يتلا ةدئازلا لئاوسلاو تلاضفلا ىلع لئاسلا .مدلا نم اهصاصتما تارودلا رارقتسلإاو فيرصتلا( ةيلمعلا هذه راركت متي ،ددحم لودجل اقفو مويلا يف ةدع تارم )ةئبعتلاو .ضيرملا ةلاحو موينوتيربلا عون ىلع دمتعتو لزنملا يف ينوتيربلا ىلكلا ليسغ متي نأ نكمي صخش ةدعاسمب وأ هسفن ضيرملا ةطساوب ىفشتسملا يف متي نأ اضيأ نكميو ،بردم .صصختم يبط قيرف ةطساوب ضيرلما عضخي نأ بجي ىتم ؟لىكلا ليسغل مييقت ىلع ءانب ىلكلا ليسغ ءارجإ رارق ذاختا مت ام ةداع .ةيلاحلا ىلكلا فئاظوو ضيرملا ةلاحل لماش نم نوناعي نيذلا ىضرملل يولكلا ليسغلاب حصني :ةيلاتلا تلااحلا ىدحإ يف مهو نمزم يولك لشف ضفخنلما )GFR( داحلا يولكلا حيشترلا لدعم ىلع ىلكلا ةردق ىدم ديدحتل GFR سايق متي اضفخنم GFR ناك اذإ .تلاضفلا ةلازإو مدلا ةيفصت 1.73/ةقيقد/ليم 15 نم لقأ ةداع( ريبك لكشب .ايرورض حبصي ىلكلا ليسغ نإف ،)عبرم رتم لىكلا لشف ضراوع ةريطخ ضارعأ نم يناعي ضيرملا ناك اذإ مدلا طغض عافترا لثم ىلكلا لشف نع ةجتان رمتسملا ءيقلاو نايثغلاو ماعلا فعضلاو ديدشلا حصني دقف ،اياحسلا باهتلاو ديدشلا بعتلاو .يولكلا ليسغلاب ةدئازلا لئاوسلا مكارت مسجلا يف لئاوسلل ريبك مكارت كانه ناك اذإ نكميف ،اهنم صلختلا ىلع ىلكلا ةردق مدعل ةجيتن هذه ةلازلإ ىلكلا ليسغ ىلإ ءوجللا متي نأ .ةدئازلا لئاوسلا ةراضلا ةيئايميكلا داولما تايوتسم عافترا ةريبك ةدايز كانه تناك اذإ يولكلا ليسغلاب حصني مدلا يف ةراضلا ةيئايميكلا داوملا تايوتسم يف .كيلوبلا ضمحو روفسوفلاو مويساتوبلا لثم رخلآا يبطلا جلاعلل ةباجتسا مدع فاك لكشب مكحتلا متي لا دق ،تلااحلا ضعب يف يبطلا جلاعلا مادختساب ىلكلا لكاشم يف .مزلالا ليدبلا يولكلا ليسغلا نوكيو ،يديلقتلا ةيبط تاروطت


87 l 2024 )رايأ( ويام هذه جمانربلا طبري ثيح تاجلاعلاب ةينيجلا تاريغتلا امب ،ناطرسلل ةهجوملا تاجلاعلاب ةينيجلا تاريغتلا ،زاجيإب .ةيراجلا ةيريرسلا براجتلا ثدحأ كلذ يف يف ينيجلا لسلستـلل يلاتلا ليجلا ةصنم رفوت ليلحتل ةيوق ةادأ توريب يف يبطلا وصنميلك زكرم مهاسي ام ،اهب ؤبنتلاو ناطرسلاب ةطبترملا تانيجلا .ضيرم لكل جلاعلا تارايخ لضفأ ديدحت يف قيبطت نم ةوجرلما دئاوفلا يه ام صيخشت ينسحت ةهجل ةينقتلا هذه ؟اهنم فدهلا امو ؟ضارملأا جلاعو صيخشت لاجم يف ةروث NGS ةينقت لكشت ليلحتل ةيوق تاودأ ريفوت للاخ نم ناطرسلا دئاوفلا نم ديدعلا رفوتو ،يناطرسلا مونيجلا ريغ صيخشتلاو ،قيقدلا صيخشتلا كلذ يف امب ةباجتسا ةبقارمو ،يصخشلا جلاعلاو ،يحارجلا ريفوتو ،ةيريرسلا براجتلا ةقباطمو ،جلاعلا ىلع NGS ةينقت دعاست امك .ةيؤبنت تامولعم ناطرسلاب نيباصملا ىضرملل ءافشلا صرف نيسحت .ةديدج ةيجلاع تارايخ مامأ بابلا حتفتو ةينقت قيبطت نم ةعقوتلما دئاوفلا لمشت :ناطسرلا لاجم في NGS قيقد ديدحتب NGS حمست :قيقدلا صيخشتلا ناطرسلا عاونأب ةطبترملا ةينيجلا تارفطلل .ةقدب مارولأا فينصت ىلإ يدؤي ام ،ةفلتخملا نكمت :تلااحلا ضعب يف يحارجلا ريغ فشكلا تارفطلا نع يحارجلا ريغ فشكلا نم NGS or ةلئاسلا ةعزخلا للاخ نم ناطرسلاب ةصاخلا ةرادإ لهسي ام ،مد ةنيع يأ liquid biopsy .ةيضرملا تلااحلا ضعب رايتخا ىلع NGS دعاست :يصخشلا جلاعلا ةينيجلا تارفطلا ىلع ءانب ةهجوملا تاجلاعلا جلاعلا ةيلاعف نم ديزي ام ،مرولل ةددحملا .ةيبناجلا راثلآا نم للقيو تايلآ ديدحتو جلاعلل ةباجتسلاا ىدم ةبقارم مونيجلا يف تاريغتلا NGS بقارت :ةمواقملا بيبطلا حنمي ام ،تقولا رورمب يناطرسلا ةباجتسلا يلعفلا تقولا يف امييقت جلاعملا وأ تايجيتارتسا ريوطت نم نكمتيف جلاعلا يئايميكلا جلاعلا نيب رايتخلااك تلاوكوتورب .Targeted Therapy هجوملا جلاعلاو NGS ددحت :ةيريرسلا براجتلا ةقباطم تاجلاعلا نم نوديفتسي دق نيذلا ىضرملا تارايخ عسوي ام ،ةيريرسلا براجتلا وأ ةهجوملا امدق ثحبلا عفديو جلاعلا ةيئيزجلا تامصبلا رفوت :تامولعملاب ؤبنتلا لوح ةيؤبنت تامولعم NGS نم ةقتشملا .ةيصخشلا ةبقارملا تايجيتارتساو جئاتنلا انزكرم يف ةينقتلا هذه قلاطإ نم فدهلا امأ عقوتو ضارملأا صيخشت نيسحت وهف ،يبطلا جلاعلا ةيعون ديدحتو ،لضفأ لكشب ةيثارولا رطاخملا دعاست ثيح ةيناطرسلا ضارملأا اهمهأو ضارملأل لكل ةبسانملا جلاعلا ةطخ مسر يف ةينقتلا هذه انتردق نم ززعي ام هعضول اقفو اهديدحتو ضيرم .ىضرملل ةلاعف ةيصخش ةياعر ميدقت ىلع رطاخلما عقوت في اهرود نع اذام ؟ةيلبقتسلما ةيثارولا ؤبنتلا يف امساح ارود NGS ةينقت بعلت تاقيبطت للاخ نم ةيلبقتسملا ةينيجلا رطاخملاب :لمشت ةفلتخم ةينيجلا تانيابتلل لماشلا ينيجلا صحفلا .ةيثارولا لويملا وأ ةثوروملا ضارملأاب ةطبترملا رفوي ةينيجلا ضارملأل تانيجلا لماح صحف ةينيجلا تابارطضلاا لقن رطخ لوح تامولعم صاخ لكشب دعاسي ام يلاتلا ليجلا ىلإ .ةيباجنلإا تارارقلا ذاختاو يلئاعلا طيطختلل ىلإ دنتست يتلا ةيمونيجلا ةراشتسلإا تاسلج نوصصختملا موقي ثيح ،NGS ةينقت جئاتن ةشقانمو ،ةينيجلا تامولعملا ريسفتب نوبردملا لوح هيجوتلا ميدقتو ،ةلمتحملا ةيحصلا راثلآا تارايخو ،صحفلا تايصوتو ،ةايحلا طمن تلايدعت فيرعت فلم ىلإ ادانتسا يلئاعلا طيطختلا .درفلل ةينيجلا رطاخملا كانه نأ مأ ؟عيمجلل ةحاتم يه له ؟ةنيعم تائف تحت هؤارجإ بجي يبط رابتخا يه NGS ةينقت بجي .كلذل لهؤم بيبط لبق نم يبط فارشإ مييقت هنكمي علطم بيبط لبق نم جئاتنلا ريسفت تلاخدتلا وأ تاهيجوتلا ميدقتو ةقدب اهتيمهأ .اهيلع ءانب ةبسانملا

2024 )رايأ( ويام l 86 وصنميلك زكرم في NGS - Next Generation Sequencing لياتلا ليجلا لسلست ةينقت رفوت ةينيجلا داولما لسلست ديدحتل مدختست ثيح ،تانيجلا ليلحتل ةيوق ةادأ تويرب في يبطلا يوونلا ضمحلا ليلحت للاخ نم ينيجلا صيخشتلاو مونيجلا لاجم في ةيعون ةلقن برتعتو ةينقتلا هذه لثم بلج في داورلا نم ناك تويرب في يبطلا وصنميلك زكرم .ةعسرو ةقدب ةينقتلا هذه لىع ةءاضلإل .مونيجلا ثوحبو بطلا لاجم في ةروث تثدحأ يتلا ةروطتلما صران ميلس روتكدلا ”بيرعلا ىفشتسلما“ ةلجم تقتلا ،ةعساو تاقيبطت نم اهل امو ةثيدحلا :لياتلا راوحلا ناكف ،تويرب في يبطلا وصنميلك زكرم في ضارملأا ملع مسق سيئر ةلباقم صران ميلس روتكدلا تويرب في يبطلا وصنميلك زكرم في ضارملأا ملع مسق سيئر ةيكيرملأا ةينانبللا ةعماجلا ىدل بطلا ةيلك في ضارملأا ملع مسق سيئرو لاجم في ةيعون ةلقن ...لياتلا ليجلا لسلست ةينقت“ ”ينيجلا صيخشتلاو مونيجلا يه امو ؟ةينقتلا هذه يه ام ؟مونيجلا لاجم في اهتامادختسا ثدحأ نم NGS يلاتلا ليجلا لسلست ةينقت ربتعت تائيزج نم ريبك ددع ةجلاعم اهنكمي يتلا قرطلا .نمازتم لكشب يوونلا ضمحلا ليلحت ىلع ةردقلا وه لاجملا اذه يف روطتلا نإ ةللاد اهل يتلا ةينيجلا تارفطلا نم دكأتلاو جئاتنلا .صيخشتلا ىلع نم ةعساو ةعومجم NGS ةينقت نمضتتو :اهنم تاقيبطتلا مهف ىلإ لوصولل لماكلا مونيجلا لسلست دعاسيف ،يرشبلا ينيجلا بيكرتلل لماش تارفطلاو ةينيجلا تاريغتلا ديدحت ىلع كلذ .ضارملأل ةببسملا يف مهسي يبوركيملا مونيجلا لسلست ثودح ةيفيك لوح عيرس مهف ىلإ لوصولا تايلآو ةيويحلا تاداضملا ةمواقمو ىودعلا يف قيقحتلا ىلإ ةفاضلإاب ،ةيدعملا ضارملأا يرشبلا مويبوركيملا رودو ضارملأا يشفت .ضرملاو ةحصلا يف نوكت ىلإ يدؤت يتلا ةينيجلا تاريغتلا مهف ديدحت يلاتلابو ،اهفيصوتو ةيناطرسلا ايلاخلا فادهلأاو ةيجولويبلا ناطرسلا تاملاع .ةيجلاعلا ةينيجلا تانيابتلا ةساردو ينيجلا ةلديصلا ملع لهسي ام ،ةيودلأا تاباجتسا ىلع رثؤت يتلا ةيلاعفلا زيزعتل ةيصخشلا ةيئاودلا تاجلاعلا .ةيبلسلا تلاعافتلا ليلقتو ؟ينيجلا صيخشتلاب دوصقلما ام في ةروطتلما ةينقتلا هذه ةيمهأ امو ؟لاجلما اذه وأ تافلاتخلإا ديدحت ةيلمع وه ينيجلا صيخشتلا نم ضارملأاب ةطبترملا تارفطلا وأ ةينيجلا تاريغتلا هذه ةيمهأ نإ ؛)DNA( يوونلا ضمحلا ليلحت للاخ :يف نمكت ةينقتلا دعاسي ثيح ضارملأا نع ركبملا فشكلا ضارملأا فاشتكا ىلع ينيجلا صيخشتلا حمسي ام ،ةركبملا اهلحارم يف ةلمتحملا صرف نيسحتو يروفلا يبطلا لخدتلاب .حجانلا جلاعلا )Personalized Therapy( يصخشلا جلاعلا ديدحت متيف ضيرملل ةينيجلا ةمصبلا ىلع ءانب تارايخ رفوي ام ،هل ةيلعاف رثكلأا تاجلاعلا .درف لكل ةصصخم ةيجلاع خيرات مهيدل نيذلا جاوزلأل باجنلإل طيطختلا نيجوزلا نكمتيف ،ةيثارو ضارمأب ةباصلإل يلئاع .ةرسأ نيوكت نأشب ةرينتسم تارارق ذاختا نم صيخشتلا مهسي ثيح قيقدلا مارولأا بط ةيلعاف رثكلأا تاجلاعلا ديدحت يف ينيجلا ام ،مرولل ةينيجلا صئاصخلا ىلع ءانب ناطرسلل .ةيبناجلا راثلآا نم للقيو جلاعلا ةيلاعف نم ديزي اهصيخشت بعصي يتلا ةردانلا ضارملأا مهف .ةيديلقتلا قرطلاب لاجم يف ةروث ينيجلا صيخشتلا لثمي ،ماع لكشب تامولعملا نم ةدافتسلإا للاخ نم ةيحصلا ةياعرلا ةقد رثكأ ةيبط تارارقو اصصخت رثكأ تاجلاعل ةينيجلا يلاتلابو ،ةلاعف قرطب ضارملأا ةرادإ ةيناكمإ عم .جلاعلا جئاتن نيسحت نإ صئاصخلاو تازيملما زربأ يه ام ةهجل وأ ةمدختسلما تادعلما ةهجل ؟صحفلا ةعيبط ينيجلا لسلستـلل يلاتلا ليجلا تاصنم عاونأ ددعتت زكرم يف ةمدختسملا ةصنملا نأ لاإ ،)NGS( ةثادح رثكلأا ربتعت توريب يف يبطلا وصنميلك عيمج يطغتو لماكلاب ةيلآ اهنأب زيمتت ثيح ،اروطتو لسلستلاو NGS ةبتكم دادعإ نم اءدب لحارملا غلابلإا ىلإ بلاوقلا دادعإو ةيلولأا تانايبلا ليلحتو ـلاو يوونلا ضمحلا نم لكل ةينيجلا تاريغتلا نع تاريغتلا لوح ريراقتلا دادعإ ىلإ لاوصو RNA ضمحلاو )DNA( يوونلا ضمحلا نم لكل ةينيجلا درفلل نمضي يذلا رملأا )RNA( يزوبيرلا يوونلا :ىلع لوصحلا نم اموي 14ـلا زواجتت لا ةرتف للاخ تانيعلا جئاتن ام بلطتي يذلا جراخلا ىلإ اهلاسرإ ءانع نود اموي 20 نع ديزي نكمي ةصنملا ةقد لضفب ،ةقدلا ةيلاع جئاتن .جئاتنلا ةيقوثوم ىلإ نانئمطلإا تقو يف ريراقتلا ىلع لوصحلا يف ةعرس تارارقلا ذاختا يف مهاسي ام ،يسايق .ربكأ ةعرسب ةيجلاعلا جمانرب اهمعدي ،ةصنملا هذه تاردق زيزعتلو نمضتت ةلصفمو ةلماش ريراقت ءاشنلإ روطتم طبر ىلإ ةفاضإ ،ةفشتكملا ةينيجلا تاريغتلا مهأ
89 l 2024 )رايأ( ويام اهنأ لىع يدثلا في ةديمحلا مارولأا فرعت اهنأ مغرو ،يدثلا ةجسنأ في نياطسر يرغ ونم عمو .ايرطخ اديدهت ةداع لكشت لا اهنكل ةعئاش ةيارد لىع ةأرلما نوكت نأ مهلما نم ،كلذ يأ تظحلا اذإ بيبطلا عجارت نأو ضرلما اذهب يجيسنلا مييقتلا لازي لا .اهييدث في تايريغت يدثلا ماروأ صيخشتل يبهذلا رايعلما وه هذه لىع قيقدلا فرعتلا نمضي ام ،ةديمحلا صىوي ثيح ،ثيبخلا ومنلا نع اهزييتمو لتكلا عاونلأ ةلضفم صيخشت ةليسوك ةعزخلا ءارجإب نأ نم مغرلا لىع .ةديمحلا مارولأا نم ةفلتخم ،ةيرطخ نوكت لا ةداع يدثلا في ةديمحلا مارولأا درجبم بيبطلا ةراشتسا مهلما نم هنأ لاإ ىدحإ في فولألما نع جراخ رمأ يأب روعشلا نأ نكيم يتلا تايرغتلا وأ ضارعلأا نمو .ينيدثلا :ةأرلما اهب رعشت يدثلا في ةلتك روهظ ةلتكلا فلتخت دقو ،اعويش رثكلأا ضرعلا وه اذه .سململاو لكشلاو مجحلا يف يدثلا في لمأ دقو ،يدثلا سمل دنع ثدحي وأ اماع مللأا نوكي دق .ةيرهشلا ةرودلا لبق اءوس دادزي ةملحلا نم تازارفإ وأ ،ينب وأ ،رفصم وأ ،يفاص زارفإ ثدحي نأ نكم .ةملحلا نم يومد ىتح يدثلا مجح وأ لكش في تايرغت دحأ لكش وأ مجح يف اريغت ةديسلا ظحلات دق .امهيلك وأ نييدثلا يدثلا دلج نول في يرغت وأ شرقت انول وأ ارشقت ةديسلا ظحلات تلااحلا ضعب يف .يدثلا دلج يف ارارمحا وأ انكاد يدثلا دلج في زازغنإ إ رئاغ وأ شمكنم هنأكو يدثلا دلج ودبي دق .لخادلا ىل صيخشت ءارجإ لىإ بيبطلا جاتحي .ىرخأ تلاماتحا يأ داعبتسلا قيقد صيخشت في ةعبتلما تاوطخلا نمو :ةديمحلا مارولأا يدثلل يريسرلا صحفلا فشكلل سمللاب نييدثلا صحفب بيبطلا موقي ةقطنم اضيأ صحفتي .ىرخأ تاريغت وأ لتك يأ نع ددغلا يف مخضت يأ دوجو مدع نم دكأتلل طبلإا .ةيوافميللا ةيريوصتلا تاصوحفلا :)Ultrasound( ةيتوصلا قوف تاجوملا ةروص ءاشنلإ ةيتوصلا تاجوملا مدختست قوف تاجوملا دعاست نأ نكمي .يدثلل ةبلص ةلتكلا تناك اذإ ام ديدحت يف ةيتوصلا مرو( لئاوسلاب ةئيلم وأ )ةيناطرس نوكت دق( .)حجرلأا ىلع ديمح :)Mammography( يدثلل يعاعشلا ريوصتلا نع فشكلل يدثلل ةينيسلا ةعشلأاب روص ريوصت ىلإ بيبطلا جاتحي دق .تاهوشت يأ نكي مل اذإ يصيخشتلا يدثلل يعاعش .احضاو ينيتورلا صحفلل يعاعشلا ريوصتلا :)MRI( يسيطانغملا نينرلاب يدثلا ريوصت ريوصتب بيبطلا يصوي دق ،تلااحلا ضعب يف نكي مل اذإ يسيطانغملا نينرلاب يدثلا قوف تاجوملا مادختساب احضاو صيخشتلا .يدثلل يعاعشلا ريوصتلا وأ ةيتوصلا يدثلا ةعزخ ذخأ ىلإ بيبطلا جاتحي دق ،نايحلأا ضعب يف ديكأتل يرهجم صحف ءارجلإ يدثلا ةجسنأ نم ةنيع ثيح ،تاعزخلا نم ةفلتخم عاونأ كانه .صيخشتلا .ةلاحلا ىلع ءانب بسنلأا عونلا رايتخاب بيبطلا موقي يدثلا في ةديمحلا مارولأا عاونأ )Fibroadenoma( يدغلا يفيللا يدثلا مرو بيصي ام ابلاغو ،اعويش ةديمحلا مارولأا عاونأ رثكأ ةبلص ةلتك هنوكب زيمتي .باجنلإا نس يف ءاسنلا ءاسنلا ىدل ثدحي ام ةداعو ،ةيطاطمو ةمعانو دق .اماع 35 و 20 نيب نهرامعأ حوارتت يتلالا ةرودلا للاخ رغصأ وأ ربكأ ةلتكلا نأب نرعشي .ةملؤم ريغ نوكت ام ةداعو ةيرهشلا Fibrocystic breast ةيفيللا ةيسيكلا تاريغتلا ،يدثلا ةجسنأ يف تاريغت ببست changes ثدحت .ثمطلا عاطقنا لبق اعويش رثكأ نوكتو روهظ نم لادبو يدثلا ةجسنأ يف تاريغتلا هذه همروتو يدثلا ةيساسح ببست اهنإف ،ةزيمتم لتك ربتعت .ةيرهشلا ةرودلا ةرتف لبق ةصاخ ،هلتكتو .قلقلل اببس لكشت لاو ادج ةعئاش تاونق لخاد ومنت Papillomas ةيميلحلا مارولأا .ةملحلا نم تازارفإ ببست نأ نكميو ،بيلحلا تاونق لخاد ومنت ليلآثلا هبشت ةريغص ماروأ اهنإ يف ببست نأ نكميو ،ةملحلا نم برقلاب بيلحلا .ةملحلا نم ةيفاص وأ ةيومد تازارفإ نايحلأا ضعب ةينهدلا مارولأا هذه Lipomas ةيمحشلا مارولأا ةأرملا رعشت ؛ةيناطرس نوكت ام اردانو ةعئاش ريغ ةكرحتم نوكت انايحأو يدثلا يف ةنيلو ةمعان ةلتكب اردانو يدثلا دلج يف تاريغت ببست لا ،ةملؤم ريغ .ةملحلا نم تازارفإ ببست ام ؟ةيناطسر لىإ لوحتت له مارولأا لوحتت نأ نكمي ،ةردانلا تلااحلا ضعب يف نإف ،كلذ عمو .ةيناطرس ماروأ ىلإ ةديمحلا يدثلا يعدتست يتلا تاريغتلا نم .ادج ردان ثودحلا اذه مجح وأ ةعرسب يداع ريغ لكشب مرولا ومن قلقلا دقف مجحلا وأ لكشلا يف ريغت يأ ةظحلام وأ ،ريبك ناك اذإو .ةيناطرس تاريغت دوجو ىلإ كلذ ريشي دقف ،ارمتسم وأ اديدش املأ ببسي ديمحلا مرولا .ةروطخ رثكأ ةلكشم دوجو ىلع ارشؤم كلذ نوكي وا ةبلاص رثكأ حبصيف سململا ريغتي دق انايحأ دلجلا نول ريغتي دق لاثم وا ئجافم لكشب ةواسق لك .تاحرقت وا مروت دوجو عم نوللا رمحأ حبصيف بيبطلا ىلإ يروفلا هجوتلا يعدتست تاريغتلا هذه هيجوتلا ىلع لوصحلاو حيحص لكشب اهمييقتل كانه نأ ىلإ ةراشلإا بجي ،نكل .بسانملا يبطلا ةيلامتحا نم ديزت نأ نكمي يتلا لماوعلا ضعب .ناطرس ىلإ يدثلا يف ديمحلا مرولا لوحت ةحترقلما تاجلاعلا ارطخ ةديمحلا يدثلا ماروا لكشت لا ،ةداعلا يف يفتكي لب يروف جلاع ىلإ جاتحت لاو اريطخ ايحص دق ريغت يأ ةظحلامل بثك نع اهتبقارمب بيبطلا نكمي ،تلااحلا ضعب يف ،كلذ عمو .اهيلع أرطي ببست وأ ةجعزم اضارعأ مارولأا هذه ببست نأ ضعب ذاختا متي دق تلااحلا هذه يفو ،ةأرملل اقلق ةثيدحلا تاجلاعلا نيب نمو .ةيجلاعلا تاءارجلإا :ةديمحلا ةييدثلا مارولأل ةمدختسملا 3D( داعبلأا ةيثلاث يفارغوماملاب ريوصتلا دعاست ةثيدح ةينقت يهو )mammography ةييدثلا مارولأا نع فشكلا نيسحت يف .اهمييقتل احوضو رثكأ روص ريفوتو ةديمحلا Breast( ةيعطقملا ةعشلأاب يدثلا ريوصت ةييدثلا مارولأا لكيه ليلحتل )ultrasound ةربلإا هيجوتل اهمادختسا نكمي .اهتعيبط ديدحتو .ةجاحلا ةلاح يف ىرخلأا ةيحارجلا تاءارجلإا وأ ةلاح يف )Lumpectomy( ةيفيظولا ةحارجلا اضارعأ ببست يتلا ةديمحلا ةييدثلا مارولأا ،ةلازإ ىلإ جاتحتو ايليمجت اهوشت وأ ةجعزم ةلازلإ ةيفيظولا ةحارجلا ءارجإ متي نأ نكمي .هلمكأب يدثلا ةلازإ نود نم مرولا

؟ةيناطسر لىإ لوحتت له ...ةديمحلا يدثلا ماروأ ةزرلما ةحص

91 l 2024 )رايأ( ويام ةعومجم لبق نم ءاج يدثلا ليمجت لاجم يف ةثادح ةعيلطلا يف ربتعت يتلا )Medica Group( اكيديم ازجوم احرش انل تمدق ثيح ،ليمجتلا عاطق لخاد ىلع تلصح اهتيمهأ تسمل امدنعو ،ءارجلإا اذهل دنعو ؛ةكرشلا لبق نم اكيجلب يف صاخ بيردت ةكرشلا نم صصختم بيبط انراز ةيلمع لوأ ءارجإ .ةبرجت لوأ يف انتكراشمل Mia® ةينقت دئاوف انل تحشر لاه ثيح نم ةزيمم اهلعجي يذلا امو ؟ةينقتلاو ايجولونكتلا اهلعجت يتلا تازيمملا نم ديدعلا Mia® ىدل تايلمعل ةروطتم لاولح مدقت ثيح ،لثملأا رايخلا ةيعيبط جئاتن قيقحت ىلع زيكرتلا عم يدثلا قسانت امأ .ءافشلا ةعرس ةدايزو رطاخملا ليلقتو ةلاعفو :دئاوفلا زربأ نم ءارجلإا ماقي :يئرم ريغو ريغص حرجلا للقي ام ،طبلإا تحت يفخم ريغص حرج للاخ .ءافشلا ةيلمع عرسيو تابدنلا نم بلطتت لا :يديرو ريدخت عم يعضوم جنب .رطاخملا نم للقي ام ،اماع اريدخت ةيلمعلا ةيلمعلا يف مدختست :ةروطتم ةوشحلا اهلكش يف ةساملا هبشت ةروطتم ةوشح .رثكأ ةيعيبط جئاتن رفوتو فاوح اهل سيلو ةوشحلا عنصت :مسجلا عم ةوشحلا لعافت ام ،تقولا رورمب مسجلا عم لعافتت داوم نم بلصت وأ فيلت ثودح رطخ نم للقي .يدثلا يف تاينقت مدختست :يدثلا ةجسنأ ىلع ظافحلا ىلإ ةجاحلا نود نم ةوشحلا لاخدلإ ةصصختم .يدثلا ةجسنأ عطق ؟ةجيتنلا لىع رثؤت يتلا لماوعلا يه ام ؟Mia® ةينقتل تاحشرلما نه نم لا يتاوللا ءاسنلل ايلاثم ارايخ Mia® ةينقت دعت نبغريو هيف غلابم لكشب يدثلا ريبكت يف نبغري نم نيناعي لاو ،ةيعيبط جئاتن ىلع لوصحلا يف ةينهد ةفاثك نهيدل نوكي نأ بجي امك ،يدثلا لهرت نود نمو ةحيرم ةبرجت نع نثحبيو يدثلا يف ةيفاك نأ وه راطلإا اذه يف هيلع ديكأتلا دوأ ام .رطاخم رثؤي ةينقتلا هذه ءارجلإ ةبسانملا ةديسلا رايتخا تداز املك اقيقد رايخلا ناك املكو ،ةجيتنلا ىلع ةقدب مييقتلا ةيلمع ىرجت نأ بجي .اضرلا ةبسن ام ديدحتو اهفادهأو ةديسلا تاجايتحا مهفل ةيانعو .اهل ةبسانم ةينقتلا هذه تناك اذإ ةدشرمل ةلماك ةمدخ عم ةبرجتلا هذه يتأت هدعبو هللاخو ءارجلإا لبق ةديسلا قفارت ةصصختم .ةيضرمو ةسلس ةبرجت ىلع لوصحلا نامضل ةليدبلا تارايخلا نذإ يه ام ةركتبلما ةينقتلا هذه اهرفوت يتلا ؟ةيديلقتلا ةحارجلا نع ةصرفلا ةينقتلا هذه تحاتأ ،ظحلا نسحل نهرهظم نيسحتب نبغري يتاوللا تاديسلل هسفن تقولا يف نكلو قسانتمو يعيبط لكشب ةيديلقتلا تاحارجلا نم سجاوهو فواخم نهيدل ةرتف لوطو يمومعلا ريدختلل ضرعتلا لثم نيعسي تقو يف ،نهمزلات يتلا بودنلاو يفاعتلا يعدتسي لاو قسانتم نهرهظم نوكي نأ ىلإ هيف .رطاخملا هذه لكل ضرعتلا فادهلأا ينب نزاوتلا قيقحت نكيم فيك ؟ةيعيبطلا جئاتنلاو ةيلماجلا نزاوتلا قيقحت ةيمهأ كردأ ،ليمجت حارجك ظافحلاو ةيلامجلا ةضيرملا تابغر ةيبلت نيب قيقدلا جهن عابتا للاخ نم كلذو ،يعيبط رهظم ىلع تاعقوت مهف ىلولأا ةجردلاب يعاري لماش اهتاعقوت مهفل ةيليصفت ةشقانم للاخ نم ةديسلا لكشلل مييقتب موقأ مث ةيلمعلا نم اهفادهأو لضفأ ديدحتل ةرشبلاو مسجلا صئاصخو ماعلا .يحارج جهن ةيلمعلا للاخ ةقيقدلا ليصافتلاب متهأ ديكأتلابو ةمغانتم ودبت ةيعيبط جئاتن قيقحت نامضل ةيحارجلا ثدحأ مادختساب موقأ ثيح ،ةضيرملا مسج عم عم ةلاعفو ةقيقد جئاتن قيقحتل ةيحارجلا تاينقتلا .ءافشلا ةعرسو تابدنلا ليلقت رمأ ةيرودلا ةعباتملاو ةحارجلا دعب ام حئاصن ميدقت جئاتنلا ىلع ظافحلاو ماتلا ءافشلا نامضل يرورض .ليوطلا ىدملا ىلع جئاتن لىع لوصحلل سرلا وه ام ،كيأرب ؟دملأا ةليوطو ةيضرم ةلاح اهنأ ىلع ةديس لك عم لماعتلا يغبني اصصخم ايدرف اجهن قحتستو اهتاقباس نع ةفلتخم ءاطعإب موقأ ،كلذل .اهتاعقوتو اهتاجايتحا بسحب دعتو ،ةدح ىلع ةديس لك مهفل يفاكلا تقولا مييقتلا ةيلمعل ىلولأا ةوطخلا يه ةراشتسلإا سايقب موقأ مث .ليصافتلا قدأ ةشقانم للاخ نم ،بسانملا ةوشحلا مجح ديدحتو ةديسلا يدث مجح ةحاتملا تارايخلا درس يف نمكت مهلأا ةوطخلاو .اهتاعقوتلو اهتلاحل بسنلأا يه ةينقت يأو

2024 )رايأ( ويام l 90 ،ةحارج نود نم يدثلا رهظم ليمجت لاجم في اديدج اراكتبا Mia Femtech™ لكشت روعشلا ةديسلا حنمتف ،ةفاك مسجلا تانوكم ينب مغانتو قسانت قيقحت اهنم فدهلا ميهاربإ روتكدلا ةيليمجتلا ةحارجلا في ئياصخلأا .اهرهظم في سفنلاب ةقثلاو ةحارلاب برتعت يتلا Mia® ةينقت صئاصخ لوح ”بيرعلا ىفشتسلما“ ةلجم لىا ثدحت كيلم اتفلا ،هيف غلابم يرغ يعيبط لكش لىع لوصحلل يدثلا رهظم ليمجت لاجم في ثدحلأا في بنغري تياوللا تاديسلا نم ةديدج ةئفل ةصرفلا حاتأ ةينقتلا هذه لوخد نأ لىإ .ةيديلقتلا تاحارجلا يرياعلم عوضخلا نود نم قسانتم ماوق لىع لوصحلا ةلباقم كيلم ميهاربإ روتكدلا ةيليمجتلا ةحارجلا ئياصخأ لاجم في ةيروث ةديدج ةينقت - Mia Femtech™“ ”يدثلا قسانت ينسحت كتبرخو كصصخت نع ةيادب انثدح يه ام .ليمجتلا ةحارج لاجم في ؟لمعلا في كتفسلف لاجم يف اماع 22 نع ديزت ةعساو ةربخ يدل هجولل ةيليمجت تايلمعب موقأ ثيح ،ليمجتلا ةحارج .لكك يدثلاو مسجلاو زكرأ ام لج نإف ،لمعلا يف يتفسلفل ةبسنلاب مسج عم ةقسانتم ةيعيبط جئاتن قيقحت وه هيلع مويلا ديازتملا هجوتلاف ؛ةغلابملا نع اديعب ،ةضيرملا يعيبط رهظم ىلع لوصحلا وحن وه ءاسنلا ىدل ةيعيبطلا ةيليمجتلا تايلمعلا للاخ نم قسانتم نم اهسفنب اهتقث ززعتو ةديسلا لامج زربت يتلا .ةيلمعلل ةحضاو اراثآ رهظت نأ نود مسجلا ءازجأ عيمج نيب قسانت داجيإ ىلإ ىعسن نم لادب ،ةفاك مسجلا تانوكم نيب مغانتلا قيقحتل اذه يف لوقلا نكمي .طقف دحاو ءزج ىلع زيكرتلا اظوحلم اريغت تدهش ليمجتلا ةحارج ةفاقث نإ راطلإا ديازتم هاجتا ايلاح ظحلايو ةيضاملا دوقعلا رادم ىلع لاجم يف ةصاخ ةيعيبطلا ةيليمجتلا تايلمعلا وحن يف تاديسلا نم ريثكلا بغرت ثيح يدثلا ريبكت نم نهداسجأ عم قسانتم رهظم ىلع لوصحلا .هوشت وأ ةغلابم نود لاجم في تاروطتلا بكاوت فيك ىوتسم لىع مايسلا ةيليمجتلا ةحارجلا ؟ةئشانلا تاينقتلاو تاينقتلا American Board of ـلا يف اوضع ينوك نم اقلاطنا يف يتاراهم ريوطتب مازتلا يدل ،Plastic Surgery تارود يف ةكراشملا للاخ نم ،ليمجتلا ةحارج لاجم يرورض رمأ وهو رخلآاو نيحلا نيب ماقت ةيبيردت ةياعرلا نم ىوتسم ىلعأ ىلع ظافحلل ةياغلل تابيردت مدقت لمع شرو يف كراشأ .ىضرملل كلذكو ،ةديدجلا ليمجتلا ةحارج تاينقت ىلع ةيلمع ةشقانمل ليمجتلا ةحارجب قلعتت تارمتؤمو تاءاقل لدابتل ةيملع تاودنو ،ثاحبلأاو تاروطتلا رخآ .ءلامزلا نيب تاربخلا لقنو تامولعملا يتلا ةيجولونكتلا تاروطتلا يه ام ةحارجلا لاجم لىع يرثأت بركأ اهل ناك ؟ةيرخلأا تاونسلا في ةيليمجتلا ةيجولونكت تاروطت ةيليمجتلا ةحارجلا لاجم دهش تانيسحت ىلإ ىدأ ام ،ةريخلأا تاونسلا يف ةلئاه اذه حبصأف ،اهتملاسو تايلمعلا جئاتن يف ةريبك ثيحب ىضم تقو يأ نم ةيلاعفو انامأ رثكأ لاجملا فخأ ملأب لضفأ جئاتن عقوت نلآا ىضرملل نكمي .احوضو لقأ تابدنو ىلع ليمجتلا بطو رمتسم روطت يف بطلا هفراعم ةرئاد عيسوت بيبطلا ىلعو صوصخلا هجو باستكا نلأ هاضرمل ةثيدح ةيبط تامدخ ميدقتل نيسحت ةهجل ىضرملا ىلع سكعني ةديدج تاراهم ةملاسلا ثيح نم لضفأ جئاتن قيقحتو جئاتنلا .اضرلاو ةيلاعفلاو ةعيرس ةريتو دهشت ليمجتلا ةحارج تاينقت نأ امك هذه ةبكاوم دعيو ،روطتلا ةيرارمتسا ثيح نم ىوتسم ىلع روطت كانهف .ايرورض تاروطتلا تايلمعلا ةقد نيسحت ىلإ فدهي ةحارجلا تاينقت ،تافعاضملاو رطاخملا ليلقت عم اهتيلاعفو .ةديدج داومو تاينقت فاشتكا ىلإ ةفاضلإاب تاهاجتلاا ثدحأ ضعب يه ام بجي يتلا يدثلا ةحص في تاراكتبلااو ةءاضلإا دونو ؟ليمجتلا وحارج اهكردي نأ مايسلا يدثلا قسانت تايلمع لىع انه .Mia Femtech™ روهظ عم عونتتو ،ةلئاه تاروطت يدثلا ةحارج ملاع دهشي هدش وأ ردصلا ريبكتل ةحاتملا تاينقتلاو بيلاسلأا تاءارجلإا هذه رثكأو .تلااحلا ضعب يف هريغصت وأ نيب مات قسانت قيقحتل Mia Femtech™ اروطت صئاصخب زيمتت يتلاو مسجلا ءاضعأ ةفاكو يدثلا .ءاسنلا نم ديدعلل لثملأا رايخلا اهلعجت ةديرف دعت يتلا ،ةينقتلا هذه تمهسأ دقل ،عقاولا يف ةفسلف ءوشن ىلإ ،يدثلا ةحص لاجم يف ثدحلأا ،لكك مسجلا عم قسانتلا ةداعإ ىلع زكترت ةديدج قيقحت ىلإ يدؤي ام رصخلاو نيفتكلا كلذ يف امب .ةغلابم نود نم باذجو يعيبط رهظم يتلا ةيعيبطلا ماجحلأا ىلع Mia® ةينقت زكرتف لامجلا ريياعم نع اديعب ،ةأرملا مسج عم بسانتت مسجلل قسانتلا ةداعإ وه فدهلا نلأ ةيعقاولا ريغ هذه دعاست ثيح ،هيف غلابملا ريبكتلا ىلإ سيلو ةقثلاو ةحارلاب روعشلا ىلع ءاسنلا ةفسلفلا .نهرهظم يف سفنلاب رايخ ميدقت وه Mia Femtech™ نم فدهلا ىلع ظافحلا عم نييدثلا لكش قيسنتل بسانم ىلع ندمتعي يتاوللا ءاسنلل يعيبطلا رهظملا تاداسولاو ردصلا تلاامح لثم ةيضيوعتلا سبلاملا لكشب يدثلا ريبكت يف نبغري لا وأ )لجلا( ةيملاهلا رثكلأا ءارجلإا اذه يف روطتلا ،عقاولا يف .ريبك

PanoramicWEB

93 l 2024 )رايأ( ويام ةمدقتلما اتاتسوبرلا ةدايع لاجرلا ةحصل ثدحأ ةمدقتملا اتاتسوربلا ةدايع مدختست ،ةفلتخملا ةيلوبلا كلاسملا تلااجم يف تاينقتلا كلاسملا تلااح ىلع صاخ لكشب زيكرتلا عم نينرلاب ريوصتلا لثم تاينقت دعاست .ةيلوبلا ةعزخلاو تاسايقلاو ريياعملا ددعتم يسيطانغملا امم ،اتاتسوربلا لكاشم صيخشت يف ةيجامدنلاا .ةقدب لحارملا ديدحتل ةفدهتسم تاعزخ ءارجإ حيتي PSMA PET/CT مادختسا متي ،صيخشتلا دعب ،ةيتوبورلا ةحارجلا ىلإ ةفاضلإاب.لحارملا ديدحتل نيكس لثم ةيحارجلا ريغ بيلاسلأا مادختسا متي تاجوملا ةقاط ىلع لوصحلل HIFU ـلاو ،ونانلا ومن جلاع فانئتساو ددرتلا ةيلاع ةيتوصلا قوف ليلقتل ،ءاملا راخب للاخ نم ديمحلا اتاتسوربلا .عرسأ لكشب يفاعتلا امبرو مللأا طمنل ةيرغتلما ةيحصلا ايجولونكتلا عم ةيعذجلا ايلاخلا برتخم :ةايحلا ةديجلا عينصتلا تاسرمام يرياعم بطلل ةيعذجلا ايلاخلا قيبطتو جاتنإ زكرم دعي هؤاشنإ مت يذلا ،Liv ىفشتسم يف يديدجتلا ،ايكرت يف هعون نم لولأا ،GMP ريياعمل اقفو لوقي .ىفشتسملا طيحم لخاد عقي يذلاو مت هنإ ،Erdal Karaöz | زوراك لادرإ روسيفوربلا يوطنت يتلا تاءارجلإا يف ةحجان جئاتن قيقحت ةيسكنتلا ضارملأل ةيعذجلا ايلاخلا تاجلاع ىلع يبصعلا زاهجلا ىلع رثؤت يتلا لولأا ماقملا يف تابارطضلا كلذكو ،يلضعلا زاهجلاو يزكرملا ضارمأ جذامن ضعبو ةيومدلا ةيعولأاو بلقلا ماظن تلاجملا يف جئاتنلا ترشن دقو .ةيتاذلا ةعانملا ديق ىلع ءاقب لدعم قيقحت دعبو .ةيملع تلااقمك ىدل ةيعذجلا ايلاخلاب جلاعلا عم 37% ةبسنب ةايحلا ىرخلأا جلاعلا تارايخ عيمج اوبرج نيذلا ىضرملا ايلاخلاب جلاعلا جمدب ةرازولا تماق ،ءابولا ءانثأ عمو .Covid -19 جلاع ةيمزراوخ يف ةيعذجلا ايلاخلا ىلع ةمئاقلا ةيولخلا تاجلاعلا ةيمهأ ديازت لبقتسملا يف متي نأ لامتحا كانه ،ةيعذجلا بعلاتلا كلذ يف امب ةفلتخم بيلاسأ مادختسا .ينيتور لكشب ينيجلا ةحارجلا عم ىوتسلما ةيلاع ةمدخ ةنيجهلا تايلمعلا ةفرغو ةيتوبورلا يرجي ،ةيتوبورلا ةيحارجلا ةيتحتلا ةينبلا لضفب ةياغلل ةدقعم ةيحارج تايلمع Liv ىفشتسم ةيعانطصلاا فارطلأا تاءارجإ اضيأ نمضتيو يتلا ،ةنيجهلا تايلمعلا فرغ رفوت .كرولاو ةبكرلل ةيديلقتلا ةيحارجلا بيلاسلأا نيب عمجت اديدج ادعب ،ةروطتملا ايجولونكتلاو تاعومجم جلاعت ثيح ،ةيحصلا تامدخلل تامدصلا تاحارجو ةفلتخملا ضارملأا يكوشلا لبحلاو غامدلا لمشت يتلا .يرقفلا دومعلاو ءلامزلا بيردت LIV زكرم في ينيلودلا يحصلا Spine يرقفلا دومعلا ةدايع تحجن يهو ،Liv ىفشتسم يف The Spine Clinic يف ،يرقفلا دومعلل ةيبورولأا ةمظنملا يف وضع لثم ةدقعملا ةيحارجلا تايلمعلا نم ديدعلا ءارجإ .فنجلا نم نوناعي نيذلا ىضرملا دعاست يتلا كلت ،يرقفلا دومعلا ةحارجل زكرمك اضيأ ةدايعلا لمعت فلتخم نم يرقفلا دومعلا يحارج بذتجت ثيح .بيردتلل ملاعلا ءاحنأ ةزئاجب نوزئافلا :Liv ىفشتسم ةحصلا لاجم في راكتبا لضفأ 2024 ماعل ةيبورولأا ةيمقرلا تاوطخلا مهأ ىدحإ ،Liv ىفشتسم يف Health- يه ةيحصلا ةياعرلا ةنمقر يف ةدعاسملل ،ةينقتلا هذه مادختساب. verse PanoramicWEB ةضورعملا تائيبلا فاشكتسا ىضرملل نكمي مادختساب ةجرد 360 ةيوازب تاريماك للاخ نم ايناكم وأ ةلومحملا فتاوهلا وأ يضارتفلاا عقاولا تاراظن نكمي .هيف نوبغري ناكم يأ نمو ،رتويبمكلا ةزهجأ دقع ةيناكمإ نمضتي يذلا ،يضارتفلاا عقاولا ةبرجت لوؤسم ةقفارم للاخ نم امإ ،هجول اهجو تاعامتجا ةلئسلأا حرط دارفلأل نكمي امك .لقتسم لكشب وأ تامولعملا ىلإ لوصولاو يلعفلا تقولا يف Healthverse لخاد ةدوجوملا ويديفلا عطاقمو .لقتسملا مهفاشكتسا ءانثأ


2024 )رايأ( ويام l 92 تاصصختلا ددعتم جهن ،2013 ماع يف Liv ىفشتسم لوأ حاتتفا مت كلذ يف امب ،تايفشتسم ةينامث نلآا دجويو ىلع لاامجإ تايفشتسملا دتمتو .ناتيلود ناتأشنم يوتحتو ،اعبرم امدق 2,723,292 غلبت ةيلامجإ ةحاسم ،ةدايع 103و ،تايلمع ةفرغ 64و ،اريرس 1,316 ىلع نمضي .روطتم يرامعم ميمصتب اهعيمج زيمتتو هئادأب فورعملاو ،ةريبكلا ةربخلا وذ يبطلا انمقاط ىضرملا تامدخو ،ةبعصلا ةيحارجلا تايلمعلل عئارلا ايجولونكتلاو فايضملا جهنلاو ،ةيفارتحلاا ةيلاع .ىضرملل ازاتمم ارايخ Liv ىفشتسم لعج ةثيدحلا زكرم“ لثم تادامتعا ىلع ىفشتسملا لصح امك يتلا ”JCI“ ـلاو “Center of Excellence | زيمتلا .ةيلودلا هتناكم سكعت تافاقثلا تاجايتحا عم فيكتلا ةفلتخلما ،ةلود 182 نم ىضرم Liv ىفشتسم لبقتسا قيرف ثدحتي .ةلود 35 نم مهمظعم ناك ثيح نوكي ثيح ،مهنيب اميف ةغل 25 يلودلا قيوستلا اذهو .هلثمي يذلا دلبلا يف انطاوم وضع لك روعشلاب Liv ىفشتسم فويض رعشي نأ نمضي نيذلا دارفلأا نم معدلا مهيقلت دنع ناملأاو ةفللأاب ىلع كلذو – مهنطوو مهتغلو مهتفاقث نومهفي .مهنطو نع مهدعب نم مغرلا يثيدح نم ،بلقلا ةحصب ةيانعلا ينغلابلا لىإ ةدلاولا نيقومرم نييميداكأ نم بلقلا ةحص قيرف نوكتي نيذلاو بلقلا ةحارجو بلقلا ضارمأ يف نيصصختم بلقلا ضارمأ عم لمعلا يف ةربخ اعيمج مهيدل .ةيومدلا ةيعولأاو رثكلأا جلاعلا تارايخ ديدحت مهنكمي هنأ ينعي اذهو اءدب — ةيرمعلا تائفلا عيمج ىلع ةقبطملا ةقد .نيغلابلا ىتحو ةدلاولا يثيدح لافطلأا نم ةيبط تاسسؤم

هتقايل ضيرملا ديعتسي نأ نكمي كلذلو تاحارج ىدحإب نزولا ةراسخ دعب ةيندبلا هتايح ةدوج نيسحت نم نكمتيو ،ةنمسلا .هسفنب هتقثو ةيسفنلا هتحار زيزعتو تاميلعتب همازتلاو ضيرملا ةدارإ نأ ركذلاب ريدجلا ةنمسلا ةحارج ءارجإ دعب اهب يصوي يتلا بيبطلا قيقحت يف ريبك لكشب مهست لماوع اهلك حارجلل سوردملا رايتخلإا ىلإ ةفاضإ ،جئاتنلا لضفأ يف ةربخلا نإ ثيح ،نيبسانملا ىفشتسملاو ىفشتسملا يف رخفن .ةيرورض لاجملا اذه فرغلا لضفأ زيهجتو تادعملا ثدحأ ريفوت يلهلأا ةنمسلا جلاع تامدخ لضفأ ميدقتو ،تايلمعلل ءاربخلا نم قيرف فارشإب ،ةيحارجلا ريغو ةيحارجلا .ةيملاعلا ةربخلا يوذ نييراشتسلااو ةنمسلا تاحارج عاونأ ىرجتو ،ةنمسلا ةحارج تايلمع نم ةدع عاونأ كانه ءابطأ يديأ ىلع يلهلأا ىفشتسملا يف اهعيمج مادختساب ةيملاعلا ةربخلا باحصأ نم تابيبطو :ةنمسلا تاحارج عاونأ مهأ لمشت .تاينقتلا ثدحأ رثكأ دعت يتلا ةدعملا صق وأ ةدعلما ميمكت نم ءزج لاصئتسا اهيف متي ثيح ،اعويش تاحارجلا تايمكل لاإ عستت لاو امجح رغصأ حبصتف ،ةدعملا .ماعطلا نم ةطيسب ةدعملا مجح ليلقت نمضتت :ةدعلما راسم ليوحت تارعسلا صاصتما ليلقتل ماعطلا راسم ليدعتو ،ةدعملا ىلعأ ريغص بيج حتف للاخ نم ،ةيرارحلا بارشلاو ماعطلا بهذيل ،ةقيقدلا ءاعملأاب هطبرو نم هب لوصوملا ءزجلا ىلإ بيجلا نم ةرشابم .ةدعملا ءازجأ مظعم ازواجتم ،ءاعملأا قييضت متيل ةدعملا لوح طابر عضوي :ةدعلما طبر قيض راسم كرت عم نيمسق ىلإ اهلصفو ،اهتعس .طسولا يف ماعطلا رورمل امهنيب تاءارجلإا ضعب دجوت ،ةيحارجلا تاجلاعلا بناج ىلإ جلاعل اهدامتعا نكمي يتلا ةيحارجلا ريغ ةيبطلا ،ةروطتملا ةدعملا تانولاب لثم ،اضيأ ةنمسلا متي تاجلاعلا هذه عيمج .اهريغو ،ةدعملا سكوتوب يبط قيرف فارشإ تحتو هجو لمكأ ىلع اهؤارجإ يلهلأا ىفشتسملا يف ةيملاع ةربخبو صصختم ريغو ةيحارجلا ةنمسلا جلاع تاينقت ثدحأب زهجملا .لماكلاب ةزهجملا تايلمعلا فرغو ،ةيحارجلا تامدخلا لضفأ ميدقتل هدادعتسا بناج ىلإ ثيح ،ثانلإا وأ روكذلا نم ىضرملا ةعباتمو جلاعل ،اضيأ تايئاصخأ تابيبط نييراشتسلاا قيرف مضي نم ديزمب تاديسلا نم تاعجارملا رعشي امم .ةيصوصخلا ىفشتسملا ىدل رفوتي ،كلذ ىلا ةفاضإ ىضرملا ةعباتمل صصختم ةيذغت مسق يلهلاا ةيريظنتلاو ةيحارجلا تايلمعلا دعب ام ةلحرم يف نزولا لوزن نامضل كلذو ةنمسلا ةجلاعمل ةيئاذغلا تايمحلا جمارب عضوو سوردملاو يحصلا .ةدح ىلع ضيرم لكل ةبسانملا 95 l 2024 )رايأ( ويام

ةحصلا تايدحت ثركأ نم ةدحاوك ةنمسلا تزرب ،نيشرعلاو يداحلا نرقلا في اراشتنا ةماعلا هلكشو مسجلا نزو في يرغت درجم تسيل يهو ةيرثم ةيحص ةلكشم اهنإ لب ،نوهدلا مكارت ببسب ةنمزلما ضارملأا نم ديدعلاب اهطابترا ببسب قلقلل عافتراو يركسلاو بلقلا ضارمأ :كلذ في ابم .اهيرغو دبكلا ضارمأو مدلا طغض نإف ،ةطرفملا ةنمسلا نم صلختلا ليبس يفو ةسراممو يئاذغلا ماظنلا رييغت وه تارايخلا لوأ وأ كلذ قيقحت يف لشفي دق ضعبلا نكل ؛ةضايرلا اهنيح ،يفاكلا نزولا نادقف يف ةبوعص دجي امبر ةريثك عاونأ كانهو ،ةنمسلا تاحارج يف ركفي دق بسانملا عونلا ديدحت متي نكلو اهنم ةددعتمو .ةلاحلا بسحب ةنمسلا تاحارج دئاوف ةنمسلا نم صلختلا فدهب ةنمسلا ةحارج ىرجت ،هتحصو ضيرملا ةايح ىلع رثؤت يتلا ةطرفملا ةوجرم ةدئاف ىلع لوصحلا نم لملأا دافنتسا دعب دئاوف لثمتت .ةيديلقتلا نزولا نادقف لئاسو نم :يلاتلا وحنلا ىلع ةنمسلا تاحارج ةنمسلا تاحارج للقت :ماعطلا لوانت ليلقت ينعي اذهو ،اهلوانت نكمي يتلا ماعطلا ةيمك ةراسخ يلاتلابو ،لقأ ةيرارح تارعس كلاهتسا .تامارجوليكلا نم ديزملا باستكا عنمو نزولا :نزولاب ةطبترملا ةيحصلا لكاشملا رطخ ليلقت تلادعملا ةداعتسا ىلع ةنمسلا ةحارج دعاست دحي ام ،لورتسيلوكلاو مدلا طغضل ةيعيبطلا ىلع دعاست امك ؛بلقلا ضارمأب ةباصلإا نم ةباصلإا عنمتو ،يركسلا ىضرم ةلاح نيسحت ةيلاع ةيلامتحا نوهجاوي نمل ةبسنلاب يركسلاب .هب ةباصلإل ففخت نأ ةنمسلا ةحارجل نكمي :مونلا نيسحت ءانثأ سفنتلا فقوت ضارعأ نم لاعف لكشب لضفأ مون ىلع لوصحلا ينعي اذهو ،مونلا .رطاخم نود نمو ديزت :ةايحلا ةدوج نيسحتو ةقايللا ةداعتسا لصافم ىلع طغضلا ةمكارتملا نوهدلا ،ةيرحب ةكرحلا ىلع ةردقلا نم دحتو ،مسجلا يبط لاقم اهدئاوفو اهعاونأ مهأ :ةنمسلا ةحارج يبطلا مقاطلا سيئرو – لوأ ةحارج يراشتسا ،ينسح باهولادبع ميظعلادبع روتكدلا رطق - ليهلأا ىفشتسلما في ةماعلا ةحارجلا سيئرو 2024 )رايأ( ويام l 94
97 l 2024 )رايأ( ويام تارابتخلااو ،)ةحارجلا كلذ يف امب( نييلخادلا .يئاودلا جلاعلاو ،ةيعاعشلإاو ةيربخملا اهفيرعت مت يتلاو ،ةرشابملا ريغ فيلاكتلا ةلاحل ةجيتن ةدوقفملا دراوملا“ اهنأ ىلع لاثم ةفلتخم تائف يف عقت يهو ،”ةيحص لكل ةفلكت يه لمعلا نم ةعئاضلا مايلأا )ةدوقفملا روجلأا يف( نيفظوملا نم .)لمتكملا ريغ لمعلا يف( لمعلا باحصأو يتلا ةايحلا ىلع نيمأتلا طاسقأ كلذكو ءارج ةعفترم نوكتو لمعلا باحصأ اهعفدي بعصي هنأ تاساردلا ربتعتو اذه .ضرملا ةنراقم ةرشابملا ريغ فيلاكتلا سايقو ديدحت .ةرشابملا فيلاكتلاب يف ةذخآ ةنمسلا فيلاكت نأ ىلإ تاءاصحلإا ريشتو تلايلحتلا دحأ يفو .ايملاع تفلا لكشب عافترلاا تاذ اهنأ نيبتي ،ةنمسلاب ةطبترم ةعئاش تلااح 6ـل ،يناثلا عونلا نم يركسلا ضرمب ةيببس ةقلاع ةيعولأاو بلقلا ضارمأو ،مدلا طغض عافتراو ،نولوقلا ناطرسو ،ةرارملا ضارمأو ،ةيومدلا يف هنأ نيبتو .ثمطلا عاطقنا دعب يدثلا ناطرسو ةدحتملا تايلاولا يف ةنادبلا تناك ،1986 ماعلا كلتو ةرشابملا فيلاكتلا نم 5.5% نع ةلوؤسم ةيبطلا تلااحلا هذهب ةطبترملا ةرشابملا ريغ .رلاود رايلم 39 ىلاوح وأ ،ةعئاشلا يبطلا قافنلإا نع ةقحلالا ريراقتلا ترهظأو ادرطم اعافترا )ةرشابملا فيلاكتلا( ةنمسلاب طبترملا .ضرملا ومن عم ،نينسلا رم ىلع ةفلكتلا يف ام نع ةلوؤسم ةنمسلا تناك ،2006 ماعلا لولحبف برقي ام يأ ،ةيبطلا فيلاكتلا نم 10% نم برقي ىلع قافنلإا لثميو .ايونس رلاود رايلم 86 نم نم 8.5% وحنب ردقي ام ةنمسلاب ةطبترملا تلااحلا جمانرب قافنإ نم 11.8%و ،ةيبطلا ةياعرلا قافنإ .صاخلا عاطقلا قافنإ نم 12.9%و ،Medicaid تانايبل ”يبهذلا يرايعملا“ ردصملا ىلإ رظنلابو ةدحتملا تايلاولا يف ةيحصلا ةياعرلا ىلع قافنلإا ةحصلا ىلع قافنلإا تاباسح تانايب ةعومجم( ةلوؤسم تناك امبر ةنمسلا نأ نيبتي ،)ةينطولا ىلع قافنلإا نم رلاود رايلم 147 ىلإ لصي ام نع 2006 ماعلا يف دلابلا يف ةيحصلا ةياعرلا ةفلكتلاو ضرلما دايدزا ةدايزل يداصتقلإا رثلأل يلبقتسملا مييقتلا يف ةفلكتلا نأ ،ارخؤم ةارجملا تاساردلا رهظت ،نزولا 2035 ماعلا لولحب رلاود تانويليرت 4 زواجتتس ناكس فصن نم رثكأ نأ ةيملاع ةسارد عقوتتو 12 نوضغ يف نزولا ةدايز عم نوشيعيس ملاعلا ريشيو .معدلاو جلاعلاو ةياقولا نسحتت مل اذإ اماع داحتلاا هرشن يذلا ،2023 يملاعلا ةنمسلا سلطأ يملاعلا يداصتقلاا رثلأا نأ ىلإ ،ةنمسلل يملاعلا رلاود تانويليرت 4.32 ىلإ لصي امبر نزولا ةدايزل ريبادت نسحتت مل اذإ 2035 ماعلا لولحب ايونس جتانلا نم ابيرقت 3% ةبسنبو ،جلاعلاو ةياقولا ةنراقم نكمي هنأو .يملاعلا يلامجلإا يلحملا .2020 ماعلا يف 19 -ديفوك ريثأتب غلبملا لولحب هنأ نوثحابلا ردق ،لبقتسملا ىلإ رظنلابو ةعفترم ةنمسلا تاهاجتا ترمتسا اذإ ،2030 ماعلا ةنمسلاب ةطبترملا ةيبطلا فيلاكتلا نإف ،عدار نودب رايلم 66 ىلإ 48 رادقمب عفترت نأ نكمي اهدحو قفنتو .اهدحو ةدحتملا تايلاولا يف ايونس رلاود ةنراقم ،ةضفخنملا ةنمسلا تلادعم تاذ نادلبلا ةياعرلا لاومأ نم لقأ ةصح ،ةدحتملا تايلاولاب ىقبي ءبعلا نكل ،ةنمسلا ىلع اهب ةصاخلا ةيحصلا ،دحاولا صخشلل ةنادبلا فيلاكت باسح امأ .اريبك اودجوو ،همييقتب نيثحابلا نم ديدعلا ماق دقف قافنلإا نم درفلا بيصن غلب ،2006 ماعلا يف هنأ ةطرفملا ةنمسلا نم نوناعي نيذلا دارفلأل يبطلا ةنراقم )42% ةبسنب ىلعأ( ايفاضإ ارلاود 1429 .يعيبطلا نزولا يوذ دارفلأاب ناك يبطلا قافنلإا نم درفلا بيصن نأ نيبتو نوناعي نيذلا دارفلأل ارلاود 2741 رادقمب ىلعأ نوناعي لا نيذلا دارفلأاب ةنراقم ةطرفملا ةنادبلا نم ةنمسلا فيلاكت نأو .150% اهردق ةدايزبو ،اهنم فيلاكتل ةلثامم تناك ،هتايح رادم ىلع ،صخش لكل ةطبترم ةعئاش تلااح سمخ جلاع ىدأو .نيخدتلا ىلإ 9000 ىلاوحب فيلاكتلا عافترا ىلإ ،ةنمسلاب نزولا يوذ نم نيغلابلاب ةنراقم رلاود 17000 تارشؤملا هذه نأ ماقرلأا يف تفلالاو .يعيبطلا هيلع نوكيس امع ةحضاو تاعابطنا يطعتل ةيفاك فارتعلاا نكل .لبقتسملا يف ةيحصلا ةفلكتلا مجح نم لاح يأب سكعي لا ةنمسلل يداصتقلاا رثلأاب نوناعي نيذلا صاخشلأا ىلع موللا ءاقلإ لاوحلأا .عئاشو نمزم ضرم وهو ،اهنم جلاعلا نم ليدب لا ربكأ اهيدل نادلب 10 نيب نم نأ ثحبلا ةجيتنب ظحلاي ملاعلا ىوتسم ىلع ةنمسلا يف ةعقوتملا تادايزلا ىلإ يمتنت اهنم 9 ،)لافطلأاو نيغلابلا نم لكل( طسوتملا لخدلا تاذ وأ لخدلا ةضفخنملا نادلبلا نإف ،كلذل .ايقيرفأ وأ ايسآ نم اهعيمجو .ىندلأا عضو ىلإ رارمتساب وعدي ةنمسلل يملاعلا داحتلاا ىلع نادلبلا ةدعاسمل ةلماش ةينطو لمع ططخ ةحصلا ةمظنمل ةديدجلا تايصوتلا ىلع ءانب لمعلا .اهترادإو ةنمسلا نم ةياقولل ةيملاعلا يف رمتسملا لشفلا مهاسي نأ نكمملا نمو يداصتقا ريثأت ثادحإ يف جلاعلاو ةياقولا نيسحت يلامجلإا يلحملا جتانلا ىلع رارمتساب ديازتم نع ةريبك ةدايز ةديدجلا ماقرلأا لثمتو .يملاعلا تاوعد ىلع احاحلإ يفضتو ةيلاحلا تايوتسملا ةينطو لمع ططخ ريوطتل ةنمسلل يملاعلا داحتلاا .ملاعلا ءاحنأ عيمج يف نزولا ةدايز ةجلاعمل ،يداصتقلاا ريثأتلا يف ةدايز ةقطنم لك دهشتسو )ةيبونجلاو ةيلامشلا( ناتكريملأا لمحتت ثيح فيلاكتلا ىلعأ ،ئداهلا طيحملا برغ ةقطنمو .يلامجلإا يلحملا جتانلا نم ةبسنك ديدعلا حفاكي ،ةنمسلل ةديدج تاجلاع روهظ عمو اوناك اذإ ام ديدحتل ةيحصلا ةياعرلا يعفاد نم ةيودلأا هذهف .ةنمسلل ةداضملا ةيودلأا نوطغيس نزولا صاقنإ ىلع ىضرملا ةدعاسم يف حجنت ةطبترملا ةعئاشلا ةبحاصملا ضارملأا ريثأت ليلقتو .عفترم رعسب يتأت نأ نكمي نكلو .ةنمسلاب له :وه بئارضلا وعفاد هحرطي يذلا لاؤسلاو ىلع دئاعلا قحتست ةنمسلا جلاعل ةيلولأا فيلاكتلا نم ،لاؤسلا اذه فاشكتسلاو ،كلذل ؟رامثتسلاا .مويلا داصتقلاا ىلع ةنمسلا ريثأت مهفن نأ مهملا قافنلإا نإف ،ةنمسلا تلادعم عافترا رارمتسا عمو تلااحلا هذه جلاعو صيخشت ىلع رشابملا يبطلا اضيأ عفتري فوس رادقمب ىلعأ ةيبطلا فيلاكتلا نأ نوثحابلا دجوو ةنمسلا نم نوناعي نيذلا كئلولأ ارلاود 1861 هذه دادزتو .يعيبطلا نزولا يوذ ىضرملاب ةنراقم نمف ،كلذل .ةنمسلا ةدش تداز املك فيلاكتلا ريثأتلا مهفل ثاحبلأا نم ديزملا ءارجإ يرورضلا ةجاحب اننأ اميس لا .داصتقلاا ىلع ةنمسلل قيقدلا ةلماشلا ةياعرلا ىلإ لوصولا قاطن عيسوت ىلإ اضيأ بجيو دقعمو نمزم ضرم ةنمسلاف .ةنمسلل بجيف .جلاعلا تارايخ نم ةعساو ةعومجمب هتيطغت يف ركفت نأ يحصلا نيمأتلا تاكرش ىلع لاثم بجيو ،ةنمسلا جلاعل رامثتسلاا دئاع درجم نم رثكأ نم ةنمسلل يناسنلإا بناجلل ةيولولأا يطعت نأ ةيحصلا تانيسحتلاو ةايحلا ةيعون ىلع زيكرتلا للاخ .نيجلاعملا ىضرملل

لماعلا لوح ةنمسلا ضرم ةيربك ةيداصتقإ ةفلكتو يحص قلق نع مجانلا ةحصلا ءوس جلاع ةفلكت ءابرخ ردق 1.2ـب لماعلا ءاحنأ عيمج في ةنادبلا وأ ةنمسلا .2025 ماعلا نم ءادتبا ايونس رلاود نويلرت ةنمسلاب ةقلعتلما ضارملأا جلاع ةفلكت نأو ،ةلبقلما ماوعلأا للاخ ادج ةعفترم نوكتس نم دحلل دوهجلا نم ديزبم مايقلا متي لم ام جئاتنلا ردقتو .دارطاب ديازتلما ضرلما اذه عسوت عافترا نأ ةنمسلل يلماعلا داحتلاا ريرقت بسحب هل نوكيس لماعلا ءاحنأ عيمج في اهتلادعم 3 لداعي ابم ،يلماعلا داصتقلإا لىع يربك يرثأت .يلماعلا ليماجلإا ليحلما جتانلا نم ةئلماب يداصتقلاا يرثأتلاب هفاترعا نأ ريرقتلا دكؤيو موللا لاوحلأا نم لاح يأب سكعي لا“ ةنمسلل انمإ ،”ةنادبلا نم نوناعي نيذلا صاخشلأا لىع هيلع نوكتس امو يداصتقلإا عقاولل فيصوت وه .لابقتسم اهجلاع فيلاكت ،لاثملا ليبس ىلع ،ةدحتملا تايلاولا هجاوت ضارملأاو ةنمسلا ةجلاعمل ”ىلعلأا ةفلكتلا“ رايلم 325 نم عفترت نأ عقوتي ثيح ،اهب ةقلعتملا رلاود رايلم 555 ىلإ 2014 ماعلا يف ايونس رلاود يفو .ةلبقملا ينامثلا تاونسلا نوضغ يف ىلإ ةفلكتلا عفترت نأ رظتنملا نم ةدحتملا ةكلمملا لصتسو .2025 ماعلا لولحب ايونس رلاود رايلم 237 .رلاود رايلم 390 ىلإ ايناملأ يف ضرملا جلاع ةفلكت قرشلا يف امأ .ليزاربلا يف رلاود رايلم 251و .ةفلكت لقأو اجرح لقأ ةلأسملا ودبتف طسولأا ةقلقم ةيلماع ماقرأ يف ءاذغلا ةملاسو ةيذغتلا ةرادإ ريدم ظحلا وكسيشنارف روسيفوربلا ،ةيملاعلا ةحصلا ةمظنم ناك امم ربكأ ةعرسب رشتنت ةنمسلا“ نأ ،اكنارب ةبتع زواجت نأ ىلإ ريشت تاعقوتلا تناكو .”اعقوتم لصحيس ةنادبلا وأ ةنمسلا نوناعي صخش رايلم دجام روسيفوربلا بسحب ،ابيرقت 2030 ماعلا لولحب نيدعملا دحأ ،ندنل يف جديلوك لايربمإ نم يتزع اذهب ةمظنملا اهترشن يتلا ةساردلل نييسيئرلا تانايب ىلإ تدنتسا يتلا ةساردلا تنيبو .صوصخلا ،ادلب 190 نم رثكأ يف صخش نويلم 220 وحن نم عفترا ةنمسلا نوناعي يذلا صاخشلأا ددع نأ 880 وحن ىلإ 1990 ماعلا يف غلاب نويلم 195 نويلم 374و ةأرمإ نييلام 504 مهنيب نم ،انويلم تاونسلا يف لاجرلا نيب ةنادبلا لدعم دازو .لجر ةئاملا يف 4.8 نم عفترا ذإ ،ابيرقت تارم 3 ةريخلأا نم رثكأو ،2022 ماعلا يف 14% ىلإ 1990 ماع حبصأو ةئاملا يف 8.8 ناك ذإ ،ءاسنلا ىدل فعضلا ،تاريدقتلل اقفوو .نادلبلا نيب قراوف عم ،18.5% ةلئاهلا رئاسخلاو يداصتقلإا ءبعلا اذه ةماخض نإف تعفد ،ةيهافرلاو ةحصلاب دئازلا نزولا اهقحلي يتلا دارفلأا نأب يملاعلا يسايسلا يعولا عفر ىلإ نأ بجي ةيلودلا تامظنملاو لودلاو تاعمتجملاو دعاصتملا ديازتلا اذه فقول دهجلا نم ديزملا اولذبي .ملاعلا لوح ةنمسلل فيلاكت ينب تزيم تاساردلا نأ تفلالاو ذإ .ةنمسلل ةشرابم يرغ ىرخأو ةشرابم ةنمسلا جلاعب فيلاكتلا نم ناعون لصتي :اهنمو ،اهب ةطبترلما تلااحلاو نع جتنت يتلا كلت يهو ةرشابملا فيلاكتلا كئلوأو نييجراخلا ىضرملل ةيحصلا تامدخلا ةعئاش ضارمأ
99 l 2024 )رايأ( ويام ؟لبقتسلما نع اذماف ةيلماعلا ةحصلا ددهي رطخ ..ةنمسلا ةيلماعلا ةحصلا ةمظنلم ةثيدح ةسارد ترهظأ رايلم نم ثركأ نأ ينيلودلا ينثحابلا نم ةعومجمو نم ديزت ةلاح يهو ،ةنمسلا نم نوناعي صخش يرشتو ؛ةيرطخلا ضارملأا نم ديدعلاب ةباصلإا رطخ .عافترلاا في ذخآ مقرلا اذه نأ لىإ تاريدقتلا مام ،ينقهارمو لاافطأ ماقرلأا هذه لمشت نادلبلا في ةنمسلا ةلكشم مقافت لىإ يرشي هذه دعتو .لخدلا ةطسوتلماو ةضفخنلما راشتنا لىإ يرشت ثيح ،ةياغلل ةقلقم ماقرلأا .لماعلا ىوتسم لىع يربك لكشب ةنمسلا هجاوت يتلا ةيحصلا تايدحتلا ربكأ دحأ يه ةنمسلا ةددعتم ةيملاع ةيحص ةلكشم دعتو ،مويلا ملاعلا ىوتسم ىلع ةيئابو تايوتسم ىلإ تلصو هجولأا نم ةريبك ةيمك مكارتب زيمتت ةلاح يهو .ملاعلا ةباصلإا رطخ نم ديزي ام ،مسجلا يف نوهدلا ائبع لكشت يتلا ةنمزملا ضارملأا نم ديدعلاب بلقلا ضارمأ اهنم عمتجملاو درفلا ةحص ىلع اريبك طغض ،يناثلا عونلا نم يركسلا ،ةيومدلا ةيعولأاو .ناطرسلا عاونأ ضعبو عفترملا مدلا :اهنم ،لماوعلا نم ديدعلا ىلإ ةنمسلا ىزعت ةيثارولا لماوعلا ةدايزب طبترت يتلا تانيجلا نم ديدعلا فاشتكا مت ىلع تانيجلا هذه رثؤت .ةنمسلاب ةباصلإا رطخ ةيهشلا ميظنتو ،مضهلاو يئاذغلا ليثمتلا ةيلمع ةثارولا بعلت .مسجلا يف نوهدلا نيزختو ،عبشلاو امب ،دارفلأل ةيدرفلا ةعيبطلا ديدحت يف اماه ارود ،يندبلا طاشنلاو ةيذغتلل مهتباجتسا كلذ يف رثأتي .ضيلأا لدعمو ،مسجلا يف نوهدلا عيزوتو تلاعافتب ةنمسلاب ةطبترملا تانيجلا نم ديدعلا ىلع رثؤي ام ،ةيكولسلاو ةيئيبلا لماوعلا عم ةدقعم .ةنمسلاب ةباصلإل ةيصخشلا ةيلامتحلاا يف ةيئيبلا لماوعلا عم ةيثارولا لماوعلا لعافتت نأ نكمي ،لاثملا ليبس ىلعف .ةنمسلا ريوطت ةيرارحلا تارعسلا ةيلاع ةمعطلأا رفوت يدؤي رطخ ةدايز ىلإ ةيحصلا ريغ ةيئاذغلا ةبيكرتلاو نولمحي نيذلا صاخشلأا ىدل ةنمسلاب ةباصلإا .يئاذغلا ليثمتلاب ةقلعتملا ةينيجلا تارفطلا ضعب ةيئيبلا لماوعلا رثؤت نأ نكمي ،كلذ ىلإ ةفاضلإاب يف يندبلا طاشنلا ةلقو يبلسلا ةايحلا طمن لثم .ةنمسلاب ةطبترملا تانيجلا ريثأت زيزعت ةيئيبلا لماوعلا مهاست يتلا لماوعلا مهأ نم ةيئيبلا لماوعلا دعت ةلق لمشتو ،عمتجملا يف ةنمسلا راشتنا يف هكاوفلا كلاهتسا ةلقو ةيحصلا ةمعطلأا رفاوت ،ةيلاعلا فايللأا تاذ ةمعطلأاو تاوارضخلاو ةعنصملاو ةعيرسلا ةمعطلأا ىلإ لوصولا ةلوهسو ةعبشملا نوهدلاو ةيرارحلا تارعسلاب ةينغلا .ةليلق ةيئاذغ ميق ىلع يوتحت امنيب ،تايركسلاو ةكرحلا ةلق ىلإ يجولونكتلا روطتلا ىدأ امك ىلع نودمتعي سانلا حبصأ ثيح ،يندبلا طاشنلاو .ةيمويلا مهتطشنأ مظعم يف تلالآاو تارايسلا نكاملأاو ءارضخلا تاحاسملا لقت ،لباقملا يف دحلا يف مهسي ام ندملا يف يشملل ةصصخملا .ةيندبلا تاطاشنلاو ةضايرلا ةسرامم صرف نم ةيكولسلا تاداعلا نوهدلاب ةينغلا ةمعطلأاو ةعيرسلا تابجولا ربتعت تاببسملا نم ةفاضملا تايركسلاو ةيلاعلا نأ ىلإ ةمعطلأا هذه ليمت .ةنمسلل ةيسيئرلا رصانعلا ىلإ رقتفتو ةيرارحلا تارعسلاب ةينغ نوكت .نداعملاو تانيماتيفلاو فايللأا لثم ةماهلا ةيئاذغلا كلاهتسا نم ديزي ةمعطلاا هذه لوانت نم راثكلإا .نزولا ةدايز ىلإ يدؤيو ةيرارحلا تارعسلا امهاسم لاماع ربتعت يندبلا طاشنلا ةسرامم ةلق ةيضايرلا نيرامتلاب مايقلا مدع .ةنمسلا يف قرح نم للقت ةيمويلا ةكرحلا ةلق وأ ماظتناب .نزولا ةدايز يف مهاستو ةيرارحلا تارعسلا ىلع رثؤي نأ نكمي يحصلا ريغ مونلا طمن .يئاذغلا ليثمتلاو ةيهشلاب ةطبترملا تانومرهلا ةيهشلا ةدايز ىلإ يفاكلا ريغ مونلا يدؤي دق .ةيلاعلا تارعسلا تاذ ةمعطلأا لوانت يف ةبغرلاو ةيومدلا ةيعولأاو بلقلا ضارمأ ةباصلإل ةيسيئرلا رطخلا لماوع دحأ ةنمسلا ربتعت كلذ يف امب ،ةيومدلا ةيعولأاو بلقلا ضارمأب تلااحلاو يجاتلا نايرشلا ضارمأو بلقلا روصق يف ةدئازلا نوهدلا طبترت .ةلصلا تاذ ىرخلأا للاتعا ةدايزب ،ةيوشحلا نوهدلا ةصاخو ،مسجلا ترهظأ دقو .تايفولاو ةيومدلا ةيعولأاو بلقلا ةباصإ ىلإ يدؤت نأ نكمي ةنمسلا نأ تاساردلا ددعتم بلقلا ىلع ةنمسلا ريثأتف .بلقلا ةلضع ةيفيظولا تاريغتلا نم ديدعلا كلذ يف امب ،هجولأا يف مهاست يتلا ةيومدلا ةيكيمانيدلاو ةيهاكفلاو ةيومدلا ةيعولأاو بلقلا ضارمأو تاهوشت روطت لثم بلقلا ضارمأب ةباصلإا رطخ نم ةنمسلا ديزت ةافولا رطخ عافتراو يبلقلا روصقلاو ةيبلقلا تابونلا ةنمسلا ريثأت دوعي ثيح ،بلقلا ضارمأ نع ةمجانلا رطخلا لماوع ىلع يبلسلا ريثأتلا ىلإ بلقلا ىلع .لورتسيلوكلاو مدلا طغض عافترا لثم ىرخلأا عافتراب ةباصلإا ةيلامتحا ةدايز يف مهست ةنمسلا ةباصلإا رطخ يف مهسي هرودب يذلا مدلا طغض تابونلا لثم ةيومدلا ةيعولأاو بلقلا ضارمأب تايوتسم عافترا نأ امك .ةيغامدلا تاتكسلاو ةيبلقلا يف نوهدلا ةبسن ةدايزو )LDL(راضلا لورتسيلوكلا ةيلامتحا نم ديزي نييارشلا يف اهمكارتو مسجلا نم ديزي يلاتلابو ،نييارشلا بلصت ثودحو اهقيضت .ةيومدلا ةيعولأاو ةيبلقلا ضارملأا رطخ نياثلا عونلا نم يركسلا هسفن تقولا يف ةدقعمو ةقيثو ةقلاع كانه ربتعت .2 عونلا نم يركسلا ضرمو ةنمسلا نيب يركسلاب ةباصلإل رطخلا لماوع مهأ دحأ ةنمسلا ةباصلإا رطخ نم دئازلا نزولا ديزي .2 عونلا نم رملأا قلعتي امدنع ةصاخ ،2 عونلا نم يركسلاب ايسيئر لاماع ربتعت .ةطرفملا ةنمسلا وأ ةنمسلاب ،يناثلا عونلا نم يركسلاب ةباصلإا رطخ ةدايز يف نيلوسنلأا ةمواقم روطت ةيلامتحا نم ديزت ثيح مسجلا ةردق مدعب زيمتت ةلاح يهو مسجلا يف يف مكحتلل ةءافكب نيلوسنلأا مادختسا ىلع ةدئازلا نوهدلا ديزت .مدلا يف ركسلا تايوتسم جاتنإ ىلإ مسجلا جاتحيف ،نيلوسنلأا ةمواقم نم ايجيردتو ،مدلا يف ركسلا عم لماعتلل هنم ديزم نيلوسنلأا نم ةيفاك ريغ تايمك سايركنبلا جتني يف عافترا ثدحي يلاتلابو ،مسجلا تاجايتحا ةيبلتل نم يركسلا روطتو مدلا يف ركسلا تايوتسم .يناثلا عونلا ،مسجلا يف نوهدلا مكارتب ةنمسلا طبترت امك ريشت .رصخلا طيحمو نطبلا ةقطنم يف ةصاخو طبترت نطبلا ةقطنم يف نوهدلا نأ ىلإ تاساردلا .يناثلا عونلا نم يركسلاب ةباصلإل ىلعأ رطاخمب ىلع ةرطيسلا يف مهم لماع وه يندبلا طاشنلا .مسجلا يف نيلوسنلأا ةيساسح نيسحتو نزولا

ةعئاش ضارمأ









101 l 2024 )رايأ( ويام
2024 )رايأ( ويام l 100 نم ديزت ةيبلسلا ةايحلاو يندبلا طاشنلا ةسرامم ةلق يركسلاب ةباصلإا ةيلامتحا نم ديزتو ةنمسلا رطخ تايللآا نمضتت ،كلذ ىلإ ةفاضلإاب .يناثلا عونلا نم 2 عونلا نم يركسلا ضرمو ةنمسلا نيب طبرت يتلا ةيئيبلا تاريثأتلاو ينيجلا دادعتسلإا لثم ىرخأ لماوع نزولا ريثأتو اتيب ايلاخ للخو نيلوسنلأا ةمواقمو ،ماع لكشب .هزارفإو نيلوسنلأا ةيساسح ىلع دئازلا يركسلا ضرم روطت يف امساح ارود ةنمسلا بعلت ةرادإ ةيمهأ ىلع ءوضلا طلسي امم ،2 عونلا نم نم ةياقولا يف ةيحصلا ةايحلا طمن تارايخو نزولا .اهترادإو ةنمزملا ةلاحلا هذه ناطسرلا عاونأ ضعبب ةباصلإا تانومرهلا ضعب زارفإ ةدايز ىلإ ةنمسلا يدؤت مهست امك ،ةيناطرسلا ايلاخلا ومن زفحت يتلا ىلإ يدؤي ام ،مسجلا يف باهتللإا ةدايز يف ةباصلإا رطخ نم ديزيو يوونلا ضمحلا فلت فاعضإ ىلإ كلذك ةنمسلا يدؤت .ناطرسلاب ةباصلإل ةضرع رثكأ مسجلا حبصيف ةعانملا زاهج .ناطرسلاو ىودعلاب روطتت نأ نكيُم يتلا تاناطسرلا عاونأ نم :ةنمسلا ببسب يتاوللا ءاسنلا نأ نيبت ثيح :يدثلا ناطرس نهيدل ثمطلا عاطقنا دعب ةنمسلا نم نيناعي .يدثلا ناطرسب ةباصلإل ىلعأ رطخ نأ دقتعي :ميقتسملاو نولوقلا ناطرس امو مسجلا يف ةدئازلا نوهدلاو ةنمسلا ارود نابعلي نمزمو ضفخنم باهتلإ نم هببست .ناطرسلا نم عونلا اذه روطت يف ةيلامتحا نم ديزت ةنمسلا :ىلكلا ناطرس نيذلا صاخشلأا .ىلكلا ناطرسب ةباصلإا روطتل ربكأ رطخ مهيدل ةنمسلا نم نوناعي .ىلكلا ماروأ نأ ىلإ ثاحبلأا ريشت :سايركنبلا ناطرس مهيدل ةنمسلا نم نوناعي نيذلا صاخشلأا .سايركنبلا ناطرسب ةباصلإل ىلعأ رطخ رطخ ةدايزب طبترت ةنمسلا :محرلا ناطرس نم نيناعي يتاوللا ءاسنلا .محرلا ناطرس ناطرس روطتل ربكأ رطخ نهيدل ةنمسلا .محرلا طبترت دق ةنمسلا :تاتسوربلا ناطرس .لاجرلا ىدل تاتسوربلا ناطرس رطخ ةدايزب مهيدل ةنمسلا نم نوناعي نيذلا صاخشلأا .ناطرسلا نم عونلا اذهب ةباصلإل ىلعأ رطخ طغض عافتراب ةنمسلا طبترت :ءيرملا ناطرس نم ديزي اذهو ،ةدعملا ضمح عاجتراو ةدعملا .ءيرملا ناطرس روطت رطخ ةنمسلا جلاع ةنمسلا نم صلختلا تاجلاعو تايجيتارتسا عونتت اجهن لمشت امومع اهنكل ،رخلآ صخش نم فلتختو ؛يبطلا معدلاو ةايحلا طمن رييغت نيب عمجي لاماش نم صلختلل اهعابتا نكمي ةدع تاراسم كانهف يف تارييغتلاب اقلعتم اهضعب نوكي دق ،ةنمسلا ضعبلا بلطتي نيح يف ،ةيذغتلاو ةايحلا طمن ضعب كيلإ .ةيحارج تاءارجإ وأ ايبط امعد رخلآا :ةكرتشملا تاجلاعلاو تايجيتارتسلاا ةايحلا طنم ىلوأو تاوطخلا مهأ نم ربتعي ةايحلا طمن رييغت نإ نيسحتو ةنمسلا نم صلختلل ةيجلاعلا تارايخلا نزولا ىلع ظافحلل ايساسأ ربتعيو ،ةماعلا ةحصلا ةيادبلا يف يغبني .ليوطلا ىدملا ىلع يلاثملا نزولا نادقفل ةيعقاوو ةحضاو فادهأ عضو .اهقيقحتل ددحم تقو ديدحتو ةحصلا نيسحتو ةيحصلا ةيذغتلا وه هب مايقلا يغبني ام لوا نإ تاوارضخلاو هكاوفلا لمشت ةنزاوتم تابجو لوانتو بنجتو ،ةيحصلا تانيتوربلاو ةلماكلا بوبحلاو .ةدئازلا تايركسلاو ةينهدلاو ةجلاعملا ةمعطلأا صصحلا يف مكحتلا بجي ،كلذ ىلإ ةفاضلإاب صصحلا مجحو ةيرارحلا تارعسلا باستحاو ةيئاذغلا .ةدئازلا تابجولا لوانت ليلقتو ةيئاذغلا يشملا لثم ماظتناب يندبلا طاشنلا ةسرامم ةقيقد 150 نع لقي لا امب ،ةوقلا ةضايرو ضكرلاو يف اماه ارود يندبلا طاشنلا بعلي .عوبسلأا يف ةيرارحلا تارعسلا قرح ةدايز للاخ نم نزولا ةراسخ ةيساسح نيسحت ىلإ ةفاضإ ،تلاضعلا ةلتك ةدايزو رطخ نم كلذ للقي يلاتلابو نيلوسنلأل مسجلا .يناثلا عونلا نم يركسلاب ةباصلإا نزولا ةرادإ جمارب ىلإ فدهت ةلماش جمارب يه نزولا ةرادإ جمارب هيلع ظافحلاو نزولا نادقف يف صاخشلأا ةدعاسم ةيذغتلاو ةايحلا طمن رييغت ىلع زيكرتلا قيرط نع هذه نمضتت .يندبلا طاشنلا ةسراممو ةميلسلا طاشنلاو ،يئاذغلا ماظنلا نع تاهيجوت ةداع جماربلا ةطبترملا ةيسفنلا لماوعلا عم لماعتلاو ،يندبلا نيب يحصلا نزاوتلا قيقحت لوح تاميلعتو ،لكلأاب ةيرارحلا تارعسلاو ةلوانتملا ةيرارحلا تارعسلا نم ايساسأ اءزج يسفنلا معدلا دعي .ةكلهتسملا ةيفيقثت تاسلج نمضتي دقو ،نزولا ةرادإ جمارب ةطبترملا ةيسفنلا لماوعلا عم لماعتلا لوح نأ نكميو .بائتكلااو قلقلاو رتوتلا لثم ،لكلأاب وأ ةيدرف تاسلج اضيأ يسفنلا معدلا نمضتي قيقحت يف ةدعاسملل نيراشتسم عم ةيعامج جماربلا نمض نم .ةيباجيلإا ةيسفنلا تارييغتلا جلاعلل تاسلج عابتا مزلالا معدلا ميدقتل ةعبتملا تايكولسلا رييغت فدهب يفرعملا يكولسلا نزولاو ةيذغتلاب ةطبترملا ةيبلسلا راكفلأاو نمضتت امك .ةيسفن ةجلاعم تاسلج للاخ نم لماش مييقتو ةيرود ةعباتم نزولا ةرادإ جمارب ىوتسم ىلع ضيرملا هزرحأ يذلا مدقتلا ىدمل مسجلا تاسايقو نزولا مييقت متي .نزولا ةراسخ طاشنلا ىوتسمو يئاذغلا ماظنلا يف تاريغتلاو .يندبلا يحارجلا لخدتلا ةيانعب ةنمسلا جلاعل يحارجلا لخدتلا رايتخا متي خيراتلاو ةيحصلا ةلاحلل لماش مييقت ىلع ءانبو يف رايخلا اذه ىلإ ءوجللا متي ثيح ،درفلل يبطلا ةايحلا طمن يف تارييغتلل ةباجتسلإا مدع ةلاح لكاشم دوجو ةلاح يف وأ ،ىرخلأا تاجلاعلاو لخدتلا ذيفنت متي .ةنمسلا نع ةجتان ةريطخ ةيحص مجح نم للقت تاءارجإ للاخ نم ةنمسلل يحارجلا ىلإ يدؤي ام ،مضهلا ةيلمع لدعت وأ ةدعملا .ةماعلا ةحصلا نيسحتو نزولا نادقف ةنمسلا نم نوناعي نيذلا ىضرملا ضعبل ةبسنلاب نإف ،ىرخلأا ضارملاا ضعب روطت رطخل نوضرعمو مكحتلا نيسحت يف دعاسي دق يحارجلا لخدتلا تايوتسمو مدلا طغض عافتراو يركسلا ضرمب نم للقي نأ نكمي امك .مدلا يف لورتسيلوكلا ةيغامدلا ةتكسلاو بلقلا ضارمأب ةباصلإا رطاخم ريضحت يغبني نكل .يسفنتلا زاهجلا ضارمأو ام لك ىلع هعلاطاو ةحارجلا لبق اديج ضيرملا تادادعتسلاا ضعب ءارجإ رملأا بلطتي امك ،هرظتني مدلا تاصوحف كلذ يف امب ةيبطلا تامييقتلاو نوكي دق .يسفنلا مييقتلاو بلقلا تاصوحفو ةيمح عابتاو ةايحلا طمن رييغت ىلإ ةجاح اضيأ كانه لخدتلا نأ كردي نأ ضيرملا ىلع .ةحارجلا لبق ةصاخ ،هيلع ظافحلاو نزولا نادقف ةلحرل ةيادب وه يحارجلا يف امب ،ةيلمعلا دعب ةايحلا طمن رييغت يغبني ثيح طاشنلا ةسراممو يحص يئاذغ ماظن عابتا كلذ ىلإ ةجاح اضيأ كانه نوكي دق .ماظتناب يندبلا .يبطلا قيرفلا عم ةيرود ةعباتم ةيوق ةادأ دعي ةنمسلا جلاعل يحارجلا لخدتلا ةنمسلا نم نوناعي نيذلا صاخشلأا ةدعاسمل نيسحتو نزولا نادقف قيقحت ىلع ةطرفملا لخدتلا ءارجإب رارقلا ذاختا نإف ،كلذ عمو .مهتحص مييقت ىلإ دنتسيو ةيانعب متي نأ بجي يحارجلا .رطاخملاو دئاوفلل لماش ةعئاش ضارمأ

103 l 2024 )رايأ( ويام ةطساوب ةدعملا ىلإ هلاخدإ دعب همجح ليدعت 400-800 ـب بيبطلا هلأمي نأ نكمي ثيح ،راظنملا كلذو ،مقعملا يحلملا لئاسلا نم بعكم مس رهشأ 4 دعب لاثمف ،هتباجتساو ضيرملا ةبغر بسح يف هتيلاعف ديزيل همجح نم بيبطلا ديزي نأ نكمي مل اذإ همجح ليلقتب موقي امنيب ،نزولا ةراسخ ةلماك ةنس ةدم Spatz نولاب ىقبي .ضيرملا هلمحتي .اضيأ راظنملا مادختساب هتلازإ لبق ةدعملا يف ىرخأ عاونأ دجوت ،ةروكذملا عاونلأا بناج ىلإ تاءارجلإا نم دعي يذلاو ،ةدعملا تانولاب نم يف ىوتسم ىلعأب اهذيفنت متي يتلا ةروطتملا نم قيرفب زيمتي يذلا ،يلهلأا ىفشتسملا رفوت بناج ىلإ ،ةيملاعلا ةربخلا يوذ نييراشتسلاا ،ةنمسلا جلاعل تامدخلا لضفأو تاينقتلا ثدحأ تاجلاعلا نم اهريغ وأ سكوتوبلا وأ نولابلاب ءاوس راسم ليوحتو ميمكتلا تايلمع لثم ةيحارجلا .لماكلاب ةزهجم تايلمع فرغ يف اهريغو ةدعملا ةدعلما تانولاب دئاوف نزولا نم صلختلا ىلع ةدعملا تانولاب دعاست هتلاحو ضيرملا ةايح ةدوج نسحي يذلا رملأا ،دئازلا بناج ىلإ ،هسفنب هتقث نم ديزيو ،ةيسفنلا امك .ةيندبلا ةطشنلأاب مايقلا ىلع هتردق ةدايز ةطبترملا ضارملأاب ةباصلإا رطخ نم ءارجلأا للقي :لثم ،ةنمسلاب .ةيومدلا ةيعولأاو بلقلا ضارمأ .ةيغامدلا تاتكسلاو تاطلجلا .مدلا طغض عافترا .مدلا يف لورتسيلوكلا تايوتسم عافترا .يناثلا عونلا نم يركسلا ضرم .مونلا ءانثأ يدادسنلاا سفنلا عاطقنا دبكلا ضرم :لثم دبكلا لكاشمو تاباهتلا .يلوحكلا ريغ ينهدلا ةنمسلا ةحارج ماسقأ زييم يذلا ام ؟ليهلأا ىفشتسلماب نم صلختلاب نيبغارلا ىفشتسملا لبقتسي نأ ةصاخ ،تامدخلا لضفأ مهل مدقيل ،ةنمسلا رطق يف لاجرلا نم 35.9%و ،ءاسنلا نم 46.1% ةجاحلا ديزي امم ،ةطرفملا ةنمسلا نم نوناعي لماعتلل ةيفاكلا ةربخلا كلتميو روطتم ىفشتسمل ةجلاعم مسق زيمتي .اهجلاعو تلااحلا هذه عم :يلي امب يلهلأا ىفشتسمب ةنمسلا 1 .لماكلاب ةزهجمو ةثيدح تايلمع فرغ 2 جلاعل ةيبطلا تادعملاو ةزهجلأا ثدحأ رفوت .ةيحارجلا ريغو ةيحارجلا قرطلاب ةنمسلا .3 تاءافك ووذ ءابطأ مضي صصختم يبط رداك .ةيملاعلا ةربخلا باحصأ نم ةيلاع 4 تلااح ةعباتمل تايئاصخأ تابيبط دوجو نم ديزملا نع نثحبي يتلالا تاديسلا .ةيصوصخلا 5 ميمكتلا تايلمع لمشتل تامدخلا عونت ،ةنمسلا تاحارج نم اهريغو راسملا ليوحتو سكوتوب ةينقتو ،ةدعملا تانولاب بناج ىلإ ةعباتملاو جلاعلا تاينقت ىلإ ةفاضلإاب ،ةدعملا .ةفلتخملا راظنملا ةزهجأب 6 صصختم ةيذغت مسق رفوت ىلا ةفاضلااب ةيحارجلا تايلمعلا دعب ىضرملا ةعباتمل لوزن نامضل كلذو ةنمسلا ةجلاعمل ةيرظنتلاو تايمحلا جمارب عضوو سوردملاو يحصلا نزولا .ةدح ىلع ضيرم لكل ةبسانملا ةيئاذغلا

2024 )رايأ( ويام l 102 نزولا ةراسخل بسنلأا قرطلا نع ثحبلا ةلحر للاخ تاينقت نع عمسن ،ةطرفلما ةنمسلا جلاعو دئازلا هذه ىدحإ ةدعلما نولابو ،ةروطتمو ةيرثك نم دب لا كلذلو ،اهنع ثيدحلا ثرَك يتلا تاينقتلا .اهنع تامولعلما نم ديزلما لىع فرعتلا ؟ةدعلما نولاب وه ام ،ةيحارج ةيلمع بلطتي لاو تقؤم يبط ءارجإ وه مسجلا ةلتك رشؤم ناك لاح يف هيلإ ءوجللا نكمي تايمحلا دعاست ملو ،40 ـلا ىتحو 25 نم ىلعأ ءارجلإا نمضتي .دئازلا نزولا ةراسخ يف نيرامتلاو يحلم لولحمب ءولمم نوكيليسلا نم نولاب لاخدإ يتلا ةحاسملا صلقيو اهنم ازيح لأميل ،ةدعملا ىلإ ةلوانتملا ةمعطلأا ةيمك للقي ام ،ماعطلل عستت .عبشلاب روعشلا ديزيو تارييغتب ضيرملا مايق ةدعملا نولاب ءارجإ بلطتي يئاذغ ماظنب مازتللااو ةايحلا طمن يف ةيرذج ،ماظتناب ةضايرلا ةسرامم عم ،دعب اميف نزاوتم ،جلاعملا بيبطلا عم ةعباتملاب مازتللاا ىلإ ةفاضإ .جئاتنلا لضفأ ىلع لوصحلا نامضل ةدعلما تانولاب عاونأ مهأ ديدحت متي ،ةدعملا تانولاب نم ةدع عاونأ كانه زربأ نمو ،ضيرملا ةلاح ىلع ءانب بسانملا عونلا :يلي ام هعاونأ لاخدإب متي ،اعويش رثكلأا وهو :)Orbera( نولاب مادختساب ةدعملا ىلإ مفلا ربع غرفم نولاب نم بعكم مس 500 ىلاوحب هئلم مث ،راظنملا هناكم يف نولابلا ىقبي .مقعملا يحلملا لولحملا لوانت ىلع ضيرملا اهللاخ داتعيف رهشأ 6 ةدم ىلع دعاسي يذلا رملأا ،ماعطلا نم ةليلق تايمك مادختساب نولابلا ةلازإ متي اهدعبو ،نزولا ةراسخ اضيأ راظنملا وهف ،ةيكذلا ةلوسبكلاب فورعملا :)Elipse( نولاب ،راظنملا مادختسا بلطتي لا يذلا ديحولا عونلا علب قيرط نع ةدعملل نولابلا لاخدإ متي ثيح لئاسلاب ئلتمتو ةدعملا يف حتفت ةيكذ ةلوسبك هناكم يف نولابلا زكرمت نم دكأتلا متي .يحلملا هعضو نم رهشأ 4 دعبو ،ةينيسلا ةعشلأاب حيحصلا تايوتحم غرفي طشن مامص طيشنتب نولابلا أدبي .يمضهلا زاهجلا ربع نولابلا ةيناكمإ وه عونلا اذه زيمي ام :)Spatz( نولاب يبط لاقم اهعاونأ رهشأو اهدئاوف :ةدعلما تانولاب لىع فرعت رطق - ليهلأا ىفشتسلما في ةماعلا ةحارجلا يراشتسإ دعاسم ،دادحلا سوخاب روتكدلا
105 l 2024 )رايأ( ويام اقحلا ضارملأاب مهددهي ءابو ...لافطلأا ىدل ةنمسلا في رمتسم دايدزا في لافطلأا ىدل ةنمسلا تايرغت وه كلذ في ببسلاو لماعلا لود ىتش اهل امو اهيف نوشيعي يتلا ةئيبلاو ةايحلا طنم لىع ةردقلاو ةيئاذغلا تارايخلا لىع يرثأت نم ةيثارولا بابسلأا بناج لىا ،يحصلا رايخلا ذاختا .نزولا لىع يرثأتلا في اهرودو اهنوك نم دعبأ يه ةلوفطلا ةلحرم يف ةنمسلا لوزت لفطلا ةايح يف ةرباع ةلحرم وأ ،ةيلامج ةلكشم لافطلأا نأ يف نمكت ةلكشملا ؛هجضنو هومن عم رملأا ،نينيدب نيغلاب اوحبصيل نوليمي نونيدبلا ةرئاد نمضو رطخ يحص عقاو ماما مهعضي يذلا ةطبترملا ةيبطلا لكاشملاو ضارملأاب ةباصلإا رطخ ةيبلسلا راثلآا نم مويلا يملاع قلق كانه .ةنمسلاب ،جضنلا دعبو غولبلا ةلحرم نم لافطلأا ىدل ةنمسلل يدؤيس ،عافترلاا يف تلادعملا ترمتسا اذإف ةلصلا تاذ ضارملاا نم ريثكلا راشتنا ىلإ كلذ لثم ةداع نيغلابلا بيصت يتلا ضارملاا اهتاذ يهو لورتسيلوكلا عافتراو مدلا طغض عافتراو يركسلا ةنمسلا ببست دق امك ،نييارشلاو بلقلا ضارمأو ىدل سفنلاب ةقثلا فعض ةلوفطلا ةلحرم يف .بائتكلااو لفطلا ةنمسلا باستحا ةيفيك لافطلأا ىدل مسجلا ةلتك رشؤم وه هيلع فراعتملا سايقلا يملاع سايقم وهو )Body Mass Index – BMI( ىلع )مارغوليكلاب( صخشلا نزو ميسقت هللاخ متي للاخ نم رابكلا ةلاح ميقتو .)رتملاب( لوطلا عبرم لا كلذ نكل .مسجلا ةلتك باسح نع جتانلا مقرلا ةيعيبطلا مسجلا ةلتك نإ ذإ ،لافطلأا دنع يفكي اهتورذ غلبت يهف ،رمعلا بسحب ريغتت لفطلا دنع عجارت عم عجارتت مث فصنلاو ةنسلا ىلإ ةنسلا رمعب .كلذ دعب عيضرلا دنع ينهدلا جيسنلا ةبسن مسجلا ةلتكل لافطلأل ةصاخ تاططخم كانه كلذل مقر عضو متيف ،ثانلإلو روكذلل رمعلا عم اهتقلاعو يفكي لاو ،ططخملا اذه ىلع ءانب مسجلا ةلتك لب ،لفطلا ةلاح مييقتل ةداع ةدحاو ةرم باسحلا لكشتيل ةينمز ةرتف للاخ لفطلا ةبقارم نم دب لا موقي نمو ،ةلاحلا مييقتل فاك ططخم انيدل فرشملا لافطلأا بيبط وه مييقتلاو ةبقارملاب .عبطلاب لهلأا سيلو ةيحصلا لفطلا ةلاح ىلع موسرلا نم ةلسلس نم ومنلا ططخم فلأتي مسجلل ةراتخم تاسايق عزوت حضوت يتلا ةينايبلا نم ومنلا تاططخم مادختسا متيو ،لافطلأا دنع ىدل ومنلا ةلاح مييقتل ةيبطلا رداوكلاو ءابطلأا لبق يفكت لا اعبط نكل .اهعبتتو نيقهارملاو لافطلأا امنإ ةنمسلا صيخشت يف اهدحو ومنلا تاططخم بنج ىلإ ابنج اهمادختسا بجي ةدعاسم ةادأ يه لوط باسح دعب بيبطلا موقي .ىرخأ ةليسو عم ومنلا ططخم ىلع هعقوم ديدحتب هنزوو لفطلا نزولا يعيبط مأ ةنمسلاب باصم وه له ةفرعمل .نزولا يف ةلوبقم ةدايز هيدل مأ ىلع ءانب يسايقلا مسجلا ةلتك رشؤم باستحإ رشؤملا سيقي لا نكلو ،هنزوو لفطلا لوط يف امب ةجسنلأا مجح سيقي لب مسجلا نوهد مث ،لفطلا ىدل ماظعلاو نوهدلاو تلاضعلا كلذ لفطلا طوقس ناكم ديدحتل ةميقلا مادختسا متي سنجلا نم لافطلأا نيب ةيوئملا ةبسنلا ثيح نم مادختسا متي ةقيرطلا هذهب .اهسفن ةيرمعلا ةئفلاو ناكأ ءاوس لفطلا نزو ةئف ديدحتل ةيوئملا ةميقلا .نزولا صقن امبر وا نزولا ةدايز نم يناعي وا انيدب ببسلا ديدحت يدؤت يتلا لماوعلاو بابسلأا نم ديدعلا كانه ثيح ةيثارولا لماوعلا اهنم ةنمسلا ثودح ىلا يذلا لفطلا ىدل ةنمسلاب ةباصلإا لامتحا دادزي نكمي امك ؛ةنمسلا نم نايناعي هيدلاو نوكي ةيرسلأا لكاشملا وأ رتوتلا لثم ةيسفنلا لماوعلل لكاشمو ةنمسلل لفطلا ضرعت لامتحا نم ديزت نأ ماعطلا لوانتب لافطلأا ضعب موقي ثيح نزولا ماظنلا.ةيسفنلا لكاشملا ريثأت ةجيتن طرفم لكشب وا ةضايرلا ةسرامم مدعو نزاوتملا ريغ يئاذغلا اهلك ةيودلاا ضعب لوانت انايحأو ،يندب طاشن يأ ةنمسلل ضرعتلاو نزولا ةدايز ىلا يدؤت لماوع :يلاتلا وحنلا ىلع بابسلأا لثمتت .لافطلأا ىدل تارايخلاو يحصلا ريغ ماعطلا لوانت طرف نم ريثكلا لفطلا لوانتي ثيح ةئطاخلا ةيئاذغلا تارعسلاب ةينغلا ةمعطلأاو ةزهاجلا تابجولا تابورشملاو ةيركسلا رئاصعلا لثم ةيرارحلا نم لادب ،اطاطبلا قئاقرو تايولحلاو ةلاحملا .هكاوفلاو راضخلاك يحصلا ماعطلا طاشنلا عاونأ نم عون يأ ةسرامم مدع عم اميسلا ةيضايرلا نيرامتلا ةلقو يندبلا لافطلأا نامدإو ةينورتكللاا باعللأا راشتنا اهيف سيل يتلا باعللأاو ايجولونكتلا ىلع .يكرح طاشن لكاشم دوجو لاح يف رتوتلاو يسفنلا طغضلا ام ،مامتهلاا مدعب لفطلا روعش وأ ةيلئاع .يسكع لعف در ثودح ىلا يدؤي ضعب ببستت ثيح يثارولا لماعلا يف ةنادبلا يف ةردانلا ةينيجلا تابارطضلاا لكلأا ىلع اهريثأت قيرط نع ةلوفطلا ةلحرم لعجت تانيج كانه نأ امك ،بلاقتسلااو .ةنادبلل ةيلباق رثكأ لفطلا ةيوناثلا ةنمسلاب فرعي ام كانهو ضيرلما ببسلا لاوز عم لوزت يتلا :اهبابسأ مهأو ،اهثودحل لثم ءامصلا ددغلا تابارطضا وا لكاشم للخ ،غنيشوك ةمزلاتم ،ةيقردلا ةدغلا روصق نيلوسنلاا طرف ،ءاطولا يف عبشلا زكرم يف .تاسيكتلا ددعتم ضيبملا ةمزلاتم ،مدلا يف ،رنروت ةمزلاتم لثم ةيغبصلا تامزلاتملا ضعب .لديب نوم سنارول ةمزلاتمو .ةليوط ةرتفل نوزيتروكلا ةيودأب جلاعلا ليلاحتو تاصوحف ءارجإ ىلإ بيبطلا جاتحي ركس ،لورتسيلوكلا تايوتسم سايقل ةيربخم تارابتخا ىلا ةفاضلإاب ،ةيثلاثلا موحشلاو ،مدلا يف للاتخا دوجو مدع نم ققحتلل تانومرهلا دق اهنلأ ءامصلا ددغلا ضارمأ وأ ينومرهلا نزاوتلا .ةنمسلاب لفطلا ةباصإ ءارو ببسلا يه نوكت تافعاضم ىدل ةنمسلل ةيدسجلا تافعاضملا نمضتت :يلي ام لافطلأا ةنمسلاف ،يناثلا عونلا نم يركسلا ءاد عفرت ةكرحلا ةلقب مستت يتلا ةايحلا طامنأو يناثلا عونلا نم يركسلا ءادب ةباصلإا رطخ نم اهب ديفتسي يتلا ةقيرطلا ىلع رثؤي يذلا .زوكولغلا نم لفطلا مسج يهو مدلا طغض عافتراو لورتسيلوكلا عافترا اهتايط يف لمحتو نزولا ةدايزب طبترت ضارما هذه مهست نأ نكمي ثيح ةميخو بقاوع ،نييارشلا لخاد تاحيوللا مكارت يف لماوعلا ،اهبلصتو نييارشلا قيض يف ببستي ام وهو تابونلل ضرعتلا ىلإ لمتحم لكشب يدؤتو ةلحرم للاخ اقحلا ةيغامدلا تاتكسلا وأ ةيبلقلا .ةايحلا يف ام

ةعئاش ضارمأ


2024 )رايأ( ويام l 106 ثيح لصافملا ملاآو ماظعلا يف لكاشم نيكرولا ىلع ايفاضإ اطغض دئازلا نزولا ببسي لافطلأا ىدل ةنمسلا ببستت دقو ،نيتبكرلاو .ملأ ثودح يف بارطضا وهو مونلا ءانثأ سفنتلا عاطقنا لفطلا سفن فقوت هيف رركتي لمتحم ريطخ .مونلا ءانثأ ىرخأ ةرم هعوجر مث ءلاؤه حبصي ثيح سفنتلا يف لكاشم يفو سفنتلا لكاشمل ةضرع رثكأ لافطلأا هتلاح دادزت فوسف وبرلا نم يناعي ناك لاح .ةبونلا ثودح ءانثأ اءوس ببسب ةيعامتجلااو ةيسفنلا تافعاضملا كلذكو تاذلا ريدقتو سفنلاب ةقثلا يندت طاشنلا ةلقو لفطلا ىدل بائتكلاا ببست .ةلزعلاو يعامتجلاا جلاعلا قرط لاوأ يعدتسي لفطلل بسانملا جلاعلا ديدحت ديدحتل هلاعأ ةروكذملا ةيبطلا تاصوحفلل هعاضخا نم ددغلا لمع يف للاتخاو ةيضرم ةلاح دوجو ببست يتلا ضارملأا ةجلاعم بجي ثيح همدع يتلاو ةيقردلا ةدغلا طاشن صقن لثم ةنمسلا نومره نمضتت ةيودأ ءاطعإب اهتجلاعم نكمي موحشلا بلاقتسا ززعي يذلا نيسكوريتلا .مسجلا يف تلاضعلا ءانبو تايركسلاو اهدامعو ةبسانملا ةيجلاعلا ةطخلا بيبطلا عضي تلايدعت لاخدإب موقيف ،يحصلا ءاذغلاو طاشنلا ائيش كلذ متي نا ىلع ةايحلا طمن ىلع ةيرذج ةيئاذغلا هتاجاحو لفطلا رمع ةاعارم عم ائيشف .ميلسلا ومنلل ىلع يساسأ لكشب دمتعي يحصلا ءاذغلا طمن تابجولاو نوهدلاو تايولحلاو تايركسلا ليلقت هلوانت نم دحلاو ةيئاذغلا لفطلا تاداع نم ةعيرسلا نداعملاو فايللأاو تانيتوربلاب اهلادبتسا متيو ،اهل يحص لكشب لفطلا ومنل ةمهمو ةيساسأ يهف .نزولا ةدايزو موحشلا مكارت ببست لاو ةدايزو هتكرح ةدايز ىلع لفطلا عيجشت بجي دمتعت يتلا باعللأا للاخ نم ةيكرحلا ةطشنلأا ةيحوللا ةزهجلأل همادختسا ليلقتو ةكرحلا ىلع ،ةليوط تاعاسل سولجلا ىلع لفطلا عجشت يتلا نوكم يضاير جمانربب لفطلا مزتلي نأ لضفي لاو ،لافطلأا ىدل لوطلا ةدايز نم للقت ذإ نيرامتلا نم موقي ثيحب ةكرحلا ىلع لفطلا عيجشت بجي امنإ اهلوانتي يتلا ةدئازلا ةيرارحلا تارعسلا كلاهتساب .نزولا ةدايزو اهمكارت عنمي امب ماعطلا يف ثيح ادج يرورض جلاعلا ةرتف للاخ يسفنلا معدلا صاقنإ ىلع عيجشتلاو معدلا ىلا لفطلا جاتحي ةطشنلأا يف لفطلا كرتشي نأ بجي امك ،هنزو نع هعنمتل هتقو لغشت يتلا ةيلسملاو ةيهيفرتلا .للملا ببسب لكلأا ةعئاش ضارمأ

109 l 2024 )رايأ( ويام ىلع رداق ريغ كمسج لازي لاف ،ةبلصلا ةمعطلأا .اهعم لماعتلا ةسورهلما ةمعطلأا :4–3 عوبسلأا لوانتب ءدبلا كنكمي ،لئاوسلا كمسج لبقت دعب نم ةيلاخلاو ،مسدلا ةليلق ،ةسورهملا ةمعطلأا تابجو 4-6 نمض ،يدابزلل هباشم ماوقبو ،ركسلا قعلام 2-3 ىلع اهنم لك يوتحي ،موي لك ةريغص .ايجيردت كلذ ةدايز نكميو ،ماعط ،اديج هغضمو ،ءطبب ماعطلا لوانت نم دكأت نوكي نأ بجي لاف ،رغصأ تائيزج ىلإ هميسقتو برش يف رمتساو ،روشق وأ ةبلص عطق يأ كانه نأ ىلع ،لئاوسلا نم ايموي رتل 2 ىلإ لصي ام تارايخ نم .اهعم سيلو تابجولا نيب كلذ نوكي :ةحاتملا ةمعطلأا .سورهملاو خوبطملا كمسلا .قولسملا وأ قوفخملا ضيبلا .ءاسحلا .نبجلا .ةسورهم عطق عم هكاوفلا رئاصع وأ وجناملا وأ زوملا لثم ةسورهملا هكاوفلا .وداكوفلأا .يدابزلا .يلجلاو ،درتساكلاو ،ةيبلهملا بنجت يف رمتساو ،زبخلاو ،جاجدلاو ،محللا لوانتت لا .نييفاكلاو ةيزاغلا تابورشملا ةنيللا ةمعطلأا :5-8 عوبسلأا راضخلا لثم ،ايجيردت ةنيللا ةمعطلأا لاخدإ كنكمي جاجدلاو ،نبجلاو ،ةيرطلا هكاوفلاو ،ةخوبطملا ةمعطلأا ىلإ ةفاضلإاب ،نوهدلا نم ةيلاخلا موحللاو نود نكل ،ةقباسلا ةرتفلا للاخ اهلوانتت تنك يتلا ةيفاك ةجردب ةيرط نوكت نأ ىلع ،اهسره ىلإ ةجاحلا .ةقعلملا وأ ةكوشلاب اهيلع طغضلا دنع ككفتتل لدعمب ،مويلا رادم ىلع ةريغص تابجو 3-4 لوانت ،ةريغص تامقل لكش ىلع ،ةبجو لكل بوك فصن رتل 2 ىلإ لصي ام برشاو ،علبلا لبق اديج اهغضماو .تابجولا نيب لئاوسلا نم ايموي يعيبطلا لكلأا :8 عوبسلأا دعب :هدعب امو نماثلا عوبسلأا يف حئاصنلا ضعب كيلإ ةيحص اهنأ املاط ،ةيداعلا ةمعطلأا لوانت تانيتوربلاب ةينغلا ةمعطلأاب ىصويو ،ةيذغمو ةضفخنمو ،فايللأاو نوهدلا نم ةيلاخلا .تارديهوبركلا ةلدتعمو ،ركسلا يف كتقو ذخو ،ءطببو اديج ماعطلا غضمإ ببسب قارغلإا ةمزلاتم بنجتل ،ةبجولا لوانت ىلإ ةعرسب ماعطلا نم ةريبك تايمك لوخد .ءاعملأا لئاوسلا برش نوكي نأ ىلع ،ءاملا برشا ةمعطلأا رتخاو ،اهبناج ىلإ سيلو تابجولا نيب .تاورضخلاو هكاوفلا لثم ،هايملاب ةينغلا ،ايموي نيتوربلا نم امارج 60-80 ىلع لصحإ ،ةيعيبطلا تابورشملا وأ ةمعطلأا نمض نم ىلإ نيتوربلا تلامكم قوحسم ةفاضإب وأ .بيلحلا وأ ءاسحلا وأ رئاصعلا لمحت يف ةبوعص هجاوت كنأ تدجو اذإ ،ماع لكشب ةلحرملا ىلإ عجراف ،ةلحرم يأ يف ةمعطلأا ماوق ،ىرخأ ةرم لواح مث ،نييفاضإ نيموي ةدمل ةقباسلا ةيئاذغلا رصانعلاو تانيماتيفلا تايوتسم بقارو ضعب مادختسا ىلإ ةجاحب نوكت دقو ،اهصقن بنجتل نيماتيفو ،مويسلاكلاو ،ديدحلا لثم تلامكملا ووذ ةيذغتلا ويئاصخأ ممصي .د نيماتيفو ،12 ب ىفشتسملا يف ةيمح زكرم يف انيدل ةربخلا كتاجايتحا بسانت اططخ ةيذغتلا يف يلهلأا .ةدعملا ميمكت ةيلمع دعب ةديرفلا ةعونملما ةمعطلأاو تابوشرلما ةدعلما ميمكت دعب ةيلاتلا تابورشملاو ةمعطلأا بنجتب ىصوي ىدملا ىلع ىتح امبرو ،ةيحارجلا ةيلمعلا دعب :ليوطلا ةمزلاتم بنجتل :ةيركسلا تابورشملا ،بعتلاو ،ديدشلا نايثغلاب روعشلاو ،قارغلإا تارعسلا بنجت كلذكو ،ءيقلاو ،لاهسلإاو .ةديفملا ريغ ةيرارحلا ضمحلا عاجترا يف مهاسي دق :نييفاكلا .فافجلاو ببست دق :ادوصلاو ةيزاغلا تابورشملا .خافتنلااو تازاغلا .ةدعملا ةقرح ببست دق :لباوتلا دق :ةينهدلا وأ ةراحلا وأ ةيلقملا ةمعطلأا .ةدعملل لكاشم ببست ةبعص وأ ةجلاعملا وأ ةعيرسلا ةمعطلأا .ةدعملل لكاشم ببست دق :مضهلا 109 2024

2024 )رايأ( ويام l 108 ةيلمع ماتمإ دعب يروضر ئياذغلا ماظنلا برتعي لىع ةدعاسلما فدهب كلذو ةدعلما ميمكت زيزعت بناج لىإ ،ةحارجلا عم فيكتلاو فياعتلا .تافعاضلما عنمو نزولا نادقف دامتعلااب ةدعملا ميمكت دعب يئاذغلا ماظنلا أدبي ايجيردت لاقتنلاا مث طقف ةيفاصلا لئاوسلا ىلع ،ةسورهملا ةمعطلأا مث ،ةفيثكلا لئاوسلا ىلإ دجت دق ،ةيادبلا يف .ةبلصلا ةمعطلأا ىلإ لاوصو رعشت لا دقو ،ةريبك ةعرسب عبشلاب رعشت كنأ نسحتتس ثيح ،امامت يعيبط رمأ اذهو ،عوجلاب .ةلبقملا ةليلقلا عيباسلأا للاخ ايجيردت كتيهش كبيبط لأست نأ بجي نكلو ،ةماع تاداشرلإا هذه بسح ىرخأ حئاصنب كيصوي دقف ،كبساني امع أطخلاو ةبرجتلا جهن عابتا نكمي ،ماع لكشبو .كتلاح .كبساني ام ىلإ لصتل ةيفاصلا لئاوسلا :1 عوبسلأا ،امامت ةيفاصلا لئاوسلا نم ةريغص تافشرب أدبا نودب ياشلاو باشعلأاو ،قرملاو ،ءاملا :لثم ةيعانص تناك نإو ،ةيعيبطلا رئاصعلاو ،نييفاك نم رتل 2 ىلإ لوصولا لواحت ىتح ،ركس نودبف .ةعاس لك ريغص بوك 1-2 لدعمبو ،ايموي لئاوسلا نم رثكأ برشت لاو ،عبشلاب رعشت امدنع فقوت وأ مللأا نم يناعت تنك اذإو ،كرضي اذهف كتجاح اتقو كرتاو ،لقأ تافشر لوانتف ،ؤيقتلا وأ جاعزنلاا .اهنيب لوطأ ،ةيزاغلاو ،ةيضمحلاو ،ةيركسلا تابورشملا بنجت .نييفاكلا ىلع ةيوتحملاو ةفيثكلا لئاوسلا :2 عوبسلأا لئاوسلا نم لماك يئاذغ ماظن ىلإ لقتنتس بيلحلاو ،ةنينشلا( نابللأا تاجتنم لثم ،ةفيثكلا ةبروش( ةكيمسلا تابروشلاو ،)مسدلا نم يلاخلا .)نافوشلا ،رطفلا ،سدعلا ،كتيهش ةدايزب رعشت دق ،ةرتفلا هذه للاخ لوانتل اببس سيل هنكلو ،امامت يعيبط رمأ اذهو يبط لاقم تمايلعتلا مهأو ئياذغلا ماظنلا :ميمكتلا دعب ام رطق - ليهلأا ىفشتسلما في ةيمح زكرم ةريدم ةيذغتلا ييئاصخأ ةيربك ،يصرلما ءايفأ

111 l 2024 )رايأ( ويام ينلوسنلأا نقح روطت لىعأ ةيلاعفو بركأ ةنوربم يركسلا ضرم ةرادإ في ةيربك تاوطخ ينلوسنلأا نقح مدقت دهش ةرمتسم ةبقارم روهظ عم ةيرخلأا تاونسلا يتلا ةيللآا ينلوسنلأا ليصوت ةمظنأو زوكولجلل ةبسنلاب مايسلا يركسلا ضرم ةرادإ دهشم تيرغ تاروطتلا هذه تدأ دقل .لولأا عونلا ضىرلم يركسلا ينبولغوميهلا تايوتسم ينسحت لىإ لىع لهسف مدلا في ركسلا صقن ليلقتو .مهتلاح ةرادإ ضىرلما ىضرمل نيلوسنلأا نقح يف تاروطتلا مدقت هجو ىلع لولأا عونلا ىضرمو ماع لكشب يركسلا يف ركسلا تايوتسم ىلع ربكأ ةرطيس صوصخلا ةليوط تافعاضم ثودح رطخ نم للقي ام ،مدلا ضرم ةرادإ دمتعت .يركسلا ضرمب ةطبترم دملأا نقح ىلع ريبك لكشب لولأا عونلا نم يركسلا قرط يف تاروطتلا نأ وه راسلا ربخلاو .نيلوسنلأا رثكأ امبرو لهسأ ةايحلا تلعج نيلوسنلأا ليصوت .ةلاحلا هذه نم نوناعي نيذلا صاخشلأل ةحص لوعفلما عيسر ينلوسنلأا ءدبل ةقيقد 30-60 ىلإ يديلقتلا نيلوسنلأا جاتحي ديدجلا لوعفملا عيرس نيلوسنلأا نكل ،هلوعفم للاخ هلوعفم أدبي يرشبلا نيلوسنلأل هباشملاو ةيعيبطلا مسجلا ةباجتسا يكاحيو ،ةدودعم قئاقد ربكأ ةنورم رفوي ام ماعطلا لوانت دعب نيلوسنلأل ركس طوبه رطخ نم للقيو تابجولا طيطخت يف أدبي هنأب لوعفملا عيرس نيلوسنلأا زيمتي .مدلا نيلوسنلأل لثامم وهو قئاقد للاخ هلوعفم ةباجتسا ةاكاحم ىلع ةردقلا هيدل ثيحب يعيبطلا ؛ماعطلا لوانت دعب نيلوسنلأل ةيعيبطلا مسجلا حنميف تابجولا طيطخت يف ربكأ ةنورمب زيمتي امك نم ةيرح رثكأ لكشب ماعطلا لوانت ةصرف ضيرملا تقوب ةبجولا لبق نيلوسنلأا نقح ىلإ ةجاحلا نود داح طوبه ثودح ةيلامتحا نم كلذك للقيو .ليوط .هلوعفم ةعرس ببسب مدلا ركس يف لوعفلما ليوط ينلوسنلأا اتباث ىوتسم لوعفملا ليوط نيلوسنلأا رفوي .مويلا رادم ىلع مسجلا يف نيلوسنلأا نم ليوط نيلوسنلأا نم ةديدجلا لاكشلأا زيمتت رثكأ ريثأتب يرشبلا نيلوسنلأل ةهباشملاو لوعفملا اذهو .ةيديلقتلا عاونلأاب ةنراقم اتابثو ةيرارمتسا ةددعتملا نيلوسنلأا نقح ىلإ ةجاحلا نم للقي ركس نم ةتباث تايوتسم ىلع ظافحلا ىلع دعاسيو :لوعفملا ليوط نيلوسنلأا تازيمم .مدلا نم اتباث ىوتسم رفوي :لوعفملا رارمتسا .مويلا رادم ىلع نيلوسنلأا اتابثو ةيرارمتسا رثكأ ريثأتب زاتمي :ربكأ تابث .يديلقتلا لوعفملا ليوط نيلوسنلأاب ةنراقم نقح ىلإ ةجاحلا نم للقي :نقحلا ددع ليلقت .مويلا للاخ ةددعتملا نيلوسنلأا ىلع دعاسي :مدلا ركس يف لضفأ مكحت مدلا ركس نم ةتباث تايوتسم ىلع ظافحلا .مويلا رادم ىلع ينلوسنلأا تاخضم ةبسوحم ةريغص ةزهجأ يه نيلوسنلأا تاخضم نم ةرمتسم تاعرجب مسجلا ديوزتب موقت .مويلا رادم ىلع لوعفملا عيرس نيلوسنلأا تاعرج ةجمربب نيمدختسملل تاخضملا هذه حمست اهنم لماوع ةدعل اقفو اهليدعتو نيلوسنلأا لبق نيلوسنلأا ةعرج ةدايز نكمي ثيح تابجولا ءانب تاعرجلا ليدعت نكمي .هللاخو وأ ماعطلا لوانت لكشب اهسايق متي يتلا مدلا ركس تاءارق ىلع ءانثأ نيلوسنلأا ةعرج ليلقت ةيناكمإ عم ،مظتنم تاخضم رفوت .يندبلا طاشنلا وأ ةضايرلا ةسرامم ةرادإ يف ربكأ ةنورمو لضفأ امكحت نيلوسنلأا .ةيديلقتلا نقحلاب ةنراقم يركسلا ضرم مكحتلا ىلع اهتردقب نيلوسنلأا تاخضم زيمتت ليدعتب حمستو يركسلا تايوتسمب قيقدلا ىلع ءانب ةقد رثكأ لكشب نيلوسنلأا تاعرج ليدعت نم ضيرملا نكمتيف .مسجلا تاجايتحا .طاشنلا تايوتسمو تابجولل اقفو تاعرجلا ظافحلاو مدلا ركس يف مكحتلا نيسحت ،ةجيتنلاو نقحلا ددع ليلقت عم اتابث رثكأ تايوتسم ىلع .مويلا للاخ ةددعتملا ةيكذلا ينلوسنلأا ملاقأ ةممصملا ةيجولونكتلا تاراكتبلإا ثدحأ يه ملاقلأا هذه .يركسلا ضرم يف مكحتلا نيسحتل يكذلا فتاهلاب لصتت Bluetooth ةدحوب ةدوزم عبتتب لاصتلاا اذه حمسي .ىرخأ ةلومحم ةزهجأب وأ يف ركسلا تايوتسم ةرادإو نيلوسنلأا تاعرج ةلهس نوكتل اهميمصت مت ؛تقولا لاوط مدلا يلعفلا تقولا يف تانايبلا لاسرإو مادختسلإا .ثوتولبلا لاصتا ربع قيبطتلا ىلإ ىلع ءانب ةعرج لك باسح ةزهجلأا هذهل نكمي تايمكو ،يلاحلا مدلا يف زوكولجلا ىوتسم ،طشنلا نيلوسنلأاو ،ةبجولا مجحو ،تارديهوبركلا ملاقأ زيمتت .بيبطلا اهفصي يتلا تادادعلإاو لضفأ ليلحت ىلع اهتردقب ةيكذلا نيلوسنلاا تاعرج تانايب ليلحت ىلع دعاست ثيح تانايبلل ام ،مدلا يف زوكولجلا تايوتسمو نيلوسنلأا .نيلوسنلأل مسجلا ةباجتسا نع حضوأ ةروص رفوي ءانب ةيصخش تلايدعت لاخدإب ضيرملل كلذ حمسي تاجايتحا عم بسانتي لكشب تانايبلا ليلحت ىلع ضرم ةرادإ نيسحتب حمسي ام ،ةيدرفلا مسجلا .ليوطلا ىدملا ىلع يركسلا

ةيبط تاروطت




/https://www.uclahealth.org/international-services
113 l 2024 )رايأ( ويام ةياهن يف يدؤي امم ،اضيأ ةفدهتسملا تاجلاعلاو ىضرملا جئاتنو تاصيخشتلا نيسحت ىلإ فاطملا ةراشتسلاا تامدخ نأ امك .ليوطلا ىدملا ىلع سول يف اينروفيلاك ةعماج يف ةمدقملا ةيثارولا ىلع لوصحلا نم مهرسأو ىضرملا نكمت سولجنأ دراومو ةيثارولا رطاخملاو مهتلاح لوح ةميق ىؤر .ةحاتملا معدلا ةيعذجلا ايلاخلا ةوق نع فشكلا جلاع في يعيبطلا ددجتلا ةوق :ةيوعلما لافطلأا ىدل يمضهلا زاهجلا ضارمأ ةديدج اقفأ ةيوعملا ةيعذجلا ايلاخلا ثاحبأ لثمت يف لافطلأا ىدل يمضهلا زاهجلا بط يف مدقت ثيح ،سولجنأ سول يف اينروفيلاك ةعماج يمضهلا زاهجلل ةيددجتلا ةردقلا لوح ةديدج ىؤر حيضوت للاخ نم .ضارملأا جلاع ىلع اهراثآو ايلاخلا كولس يف مكحتت يتلا ةيئيزجلا تايللآا ريوطت ىلإ نوثحابلا فدهي ،ةيوعملا ةيعذجلا ءاعملأا ءاد لثم تلااحل ةركتبم ةيديدجت تاجلاع رخانلا ينولوقلا يوعملا باهتللااو يباهتللاا .ةيقلخلا يمضهلا زاهجلا تاهوشتو سول يف اينروفيلاك ةعماج ءاملع فشكي ةيعذجلا ايلاخلا ايجولويب تاديقعت سولجنأ عبتت لثم تاينقتلا ثدحأ قيرط نع ةيوعملا كلذ يف امب ،ةدحاولا ةيلخلا لسلستو بسنلا ةباجتسلااو اهديدجتو ةجسنلأا حلاصإ يف اهرود يقلي لا قمعلأا مهفلا اذه .ةيئيبلا تاراشلإل تابارطضلا ةيضرملا ايجولويزيفلا ىلع ءوضلا ةلمتحم افادهأ مدقي لب ،بسحف يمضهلا زاهجلا ةيويحلا ةيسدنهلا تلااقسلا نم .يجلاعلا لخدتلل يعسلا نإف ،ايلاخلا ىلع ةمئاقلا تاجلاعلا ىلإ ريخلاب رشبي يديدجتلا بطلا يف مئاقلا مدقتلاو ءاعملأا ةفيظو ةداعتساو جلاع ىلإ يدؤي دقو .ىضرملا لافطلأل ةايحلا ةيعون نيسحتو ةيعيبطلا ةيحصلا ةياعرلا تاينقت :يمضهلا زاهجلا لشفل ةركتبلما زاهجلا ةحص في ديدج قفأ لافطلأا ىدل يمضهلا ةدئار سولجنأ سول يف اينروفيلاك ةعماج دعت دنع يمضهلا زاهجلا لشف تاجلاع راكتبا يف ةينيجلا ثاحبلأا ىلإ ةفاضلإاب ،لافطلأاو عضرلا نترام يج نترام روتكدلا عم ،ةيعذجلا ايلاخلا ثاحبأو ةعماج مدقت .صصختملا لاجملا اذه ةعيلط يف ةيجلاع بيلاسأ سولجنأ سول يف اينروفيلاك ةلماشلا ةياعرلا ىلع زيكرتلا للاخ نم ةركتبم كلذ يف امب ،تاصصختلا فتلخم نيب نواعتلاو ليهأتلا ةداعإو ةيوعملاو ةيديرولا ةيذغتلا معد ضيرم لكل ةبسانملا ةيحارجلا تلاخدتلاو يوعملا .ةديرفلا هتاجايتحا بسح ةعئارلا ةديدجلا تاودلأا ةبرجتل سمحتم نترام روتكدلا نيذلا لافطلأا صيخشت ىلع انتردق تززع يتلا ةعرسب ةيثارولا يمضهلا زاهجلا تابارطضا نم نوناعي تايوضع ديلوت ىلع انتردق انل تحاتأ دقو ،ةقدو ايجولويبل انمهف ريخست ضيرم لكب ةصاخ ةيوعم .لافطلأل ةديدج ةيجلاع تارايخ حنمل ةيعذجلا ايلاخلا سول يف اينروفيلاك ةعماج دعت ،ماتخلا يف ةيثحبلاو ةيبطلا تاسسؤملا ةعيلط يف سولجنأ زاهجلا ضارمأ تاجلاع ريوطت ىلع لمعت يتلا ةدئارلا ثاحبلأا للاخ نم لافطلأا ىدل يمضهلا ةثارولا ملع تلااجم يف ةيريرسلا تاسرامملاو جلاع لاجم ءابطلأا ريغي امك .ةيوعملا ةيعذجلا ايلاخلاو ريخست للاخ نم لافطلأل يمضهلا زاهجلا ضارمأ يطعيل ،يديدجتلا بطلاو تايمونيجلا ملع ةوق ةيمضه تابارطضا نم نوناعي نيذلا لافطلأا .ةنسحم جئاتنو لمأ عاعش مهرسأو ةدقعم سولجنأ سول يف اينروفيلاك ةعماج رارمتسا عم ،نواعتلاو راكتبلاا لاجم يف قيرطلا ةدايق يف يمضهلا زاهجلا ضارمأ تاجلاع لبقتسم نإف صيخشتلا تايناكمإ لضفب قرشم لافطلأا ىدل .ةيديدجتلا تاجلاعلاو ةيصخشلا تاجلاعلاو ةنسحملا ةرايز ىجري ،تامولعلما نم ديزلم
:مقرلا لىع لاصتلاا وأ

2024 )رايأ( ويام l 112 لافطلأا ىدل يمضهلا زاهجلا ضارمأ تاسارد في رهاب يبط مدقت سولجنأ سول في اينروفيلاك ةعماج في ةيحصلا ةياعرلا لبقتسم فشتكا في لافطلأا ىدل يمضهلا زاهجلا بط فقي ةعماج في مايس لا ،ةيبطلا تاراكتبلاا ةعيلط ثاحبلأا تثدحأ ثيح ،سولجنأ سول في اينروفيلاك مهف في ةروث ةيريسرلا تاسرمالماو ةدئارلا ىدل يمضهلا زاهجلا تابارطضا جلاعو ةساردو لكشب ماهيلع زيكترلا متي نلااجم كانه .لافطلأا ةيعذجلا ايلاخلا ثاحبأو ةثارولا ملع ماهو لاأ صاخ جئاتن ينسحتل لائاه ادعو لمحي ماهلاكو ،ةيوعلما .مهتايح ةيعونو ضىرلما ةلاحو :ةثارولا ملعل نانعلا قلاطإ جلاعل ةيلولأا تاططخلما ديدحت لافطلأا ىدل يمضهلا زاهجلا زاهجلا ضارمأ ةسارد يف ةثارولا ملع جمد لثمي يف اينروفيلاك ةعماج يف لافطلأا ىدل يمضهلا تابارطضا جلاعو مهفل ايليوحت اجهن سولجنأ سول تاينقت للاخ نم .لافطلأا ىدل يمضهلا زاهجلا فلتخم نيب نواعتلاو ةروطتملا ينيجلا لسلستلا سسلأا نع ءابطلأاو نوثحابلا فشك ،تاصصختلا ءاعملأا باهتلا ضرم لثم تلااحل ةدقعملا ةيثارولا تابارطضلااو ةيمضهلا تابارطضلاا ضرمو )IBD( .يمضهلا زاهجلا ىلع رثؤت يتلا ةردانلا ةيثارولا ءابطلأل نكمي ،يثارولا دادعتسلاا ديدحت للاخ نمو ةصصخم ةيجلاعو ةيصيخشت تايجيتارتسا ميدقت .ضيرم لكل ديرفلا ينيجلا فلملا عم بسانتت زيزعت ىلإ قيقدلا بطلا يف جهنلا اذه يدؤي لا ركبملا لخدتلا لهسي لب ،بسحف صيخشتلا ةقد ةيبط تاسسؤم

2024 )رايأ( ويام l 114 نم ةعومجم ةيبطلا دمح ةسسؤم ترجأ ةعجارم دعب ديعاولما زجح ماظن في تايريغتلا قفارلما في ديعاولما زجحو تلااحلإا ةرادإ ماظن تايريغتلا هذه ترفسأو ،ةسسؤملل ةعباتلا ضىرلما اهدهشي ةسوملم تانيسحت نع .لياحلا تقولا في نوعجارلماو نم 2022 ماع يف ةيبطلا دمح ةسسؤم تماق نيفظوملاو ىضرملا تاكراشمو تاربخ زكرم للاخ ماظن زيزعت ىلع لمعت ةردابم ذيفنتب ةسسؤملاب بناوجلا عيمج يطغي ثيحب ،هلمكأب ديعاوملا زجح ،ديعاوملا ةلودج ىتحو تلااحلإا نم اءدب ةمزلالا تايلمعو اينورتكلإ تلااحلا زرف كلذ يف امب ةسسؤملا مازتلا ىدم دهجلا اذه سكعي .لاصتلاا ةياعرلا تامدخ ىلإ ىضرملا لوصو نيسحتب ةبرجت قيقحت نمضي ام ،ةرمتسم ةروصب ةيحصلا .عيمجلل ةيلاعفو ةلوهس رثكأ يذيفنتلا سيئرلا ،يميعنلا رصان ديسلا حضوأ ريدمو ةيبطلا دمح ةسسؤمب ىضرملا تاربخل ىلع“ :لائاق ،ةيحصلا ةياعرلا ةدوجل دمح دهعم زجحو تلااحلإا ماظن ةرادإ تايلمع نأ نم مغرلا بولسأب قبطت تناك اهنأ لاإ ةيزكرم ربتعت ديعاوملا ،ةفلتخملا ةيحصلا ةياعرلا قفارم ربع ةيزكرم لالا ىلع ربكأ مكحت اهيدل تايفشتسملا نأ ينعي امم بنجت ىلع دعاسي ىضرملل ديعاوملا زجح ماظن ةردق ةيبلت جهنلا اذه نمضيو ،يرورضلا ريغ ريخأتلا لكشب دحلا يلاتلابو ىضرملا تاجايتحلا تادايعلا نم كلذ دعيو ،ديعاوملا راظتنا تاقوأ نم لاعف يف ةسسؤملا حاجنل ةيساسلأا زئاكرلا نمض .”ةيجراخلا تادايعلا ىضرم ةياعر نيسحت تلااحلإا ةرادإ ماظن زيزعتو نيسحت مت دقل ةيسيئرلا ةيحصلا قفارملا يف ديعاوملا زجحو زكرم اهنمض نمو ،ةيبطلا دمح ةسسؤمل ةعباتلا ،ماعلا دمح ىفشتسمو ،ةيمويلا ةيبطلا ةياعرلا زكرمو ،روخلا ىفشتسمو ،ةركولا ىفشتسمو تنب ةشئاع ىفشتسمو ،ليهأتلا ةداعلإ رطق زكرمو ،ثاحبلأاو ةأرملا ةحص زكرمو ،ةيطعلا دمح .نانسلأل دمح زكرمو ،لصافملاو ماظعلا عيسوت ىلع يلاحلا تقولا يف عورشملا زكري ةياعر يدعاسم جمد للاخ نم ماظنلا تامدخ ىلإ ةردابملا هذه فدهت ثيح ،ىضرملا ةيلمع طيسبتو تادايعلا نم ةدافتسلاا زيزعت ةفرغ نم ةرشابم ةعباتملا ديعاوم ىلع لوصحلا ةءافكلاو ىضرملا ةياعر زيزعت يلاتلابو ،بيبطلا .ةماع ةروصب ةبقارمل ةيذيفنت تامولعم ةحول ميدقت مت قيقحت نامضل كلذو ديعاوملاب ةقلعتملا تايلمعلا ةحوللا هذه رفوت ،نيسحتلا دوهجل رمتسملا حاجنلا ىلإ ىضرملا لوصول يلعفلا تقولا يف تانايب ،بسانملا تقولا يف رارقلا ذاختا حيتي امم ،ةياعرلا ادج ةمهم تانايبلا ىلع ةينبملا ىؤرلا هذه ربتعت نم اهقيقحت مت يتلا بساكملا ىلع ظافحلا يف .نيسحتلا جمارب للاخ تارييغتلا تدأ”:لائاق ،يميعنلا رصان ديسلا فاضأو ديعاوملا زجحو تلااحلإا ةرادإ ماظن ىلع ةديدجلا ىلع ىضرملا لصحي ثيح ،ةريبك تانيسحت ىلإ دعب قباس تقو يأ نم عرسأ ةروصب مهديعاوم تدأ دقف .ةيبطلا دمح ةسسؤم ىلإ مهتلاحإ امب يباجيإ ريثأت ثودح ىلإ ماظنلا يف تارييغتلا ظوحلم لكشب عفترا ثيح ،ىضرملا ةياعر صخي نوضغ يف مهدعوم ديكأت مت نيذلا ىضرملا ددع ددع ريبك لكشب ضفخناو ،ةلاحلإا نم مايأ ةعبس ”.ةقلعملا ىضرملا تلااحإ نع تايريغتلا كلت ترفسأو :ةيلاتلا جئاتنلا ىضرملا ددع يف 224% اهردقو ةريبك ةدايز للاخ لولأا مهدعوم ىلع نولصحي نيذلا ةيبطلا دمح ةسسؤبم ديعاولما زجحو تلااحلإا ةرادإ ماظن في تايريغت عسرأ ةروصب ديعاولما لىع لوصحلا نم ضىرلما ينكمتل يميعنلا صران ديسلا ةيبط تاسسؤم

115 l 2024 )رايأ( ويام نم ماقرلأا عافتراو .ةلاحلإا نم مايأ ةعبس يف 10,723 ىلإ 2022 رياربف يف 3,315 2024 رياني تلااحإ ددع يف 70% ةبسنب ريبك ضافخنا نم مقرلا ضفخنا ثيح ةقلعملا ىضرملا يف 27,754 ىلإ 2022 ربوتكأ يف 93,109 .2024 رياني ىضرملا ددع يف 91% ةبسنب ظوحلم عافترا نم نيعوبسأ نوضغ يف مهصحف مت نيذلا يف 6,815 نم دادعلأا عافترا عم ،ةلاحلإا 2024 رياني يف 13,005 ىلإ 2022 رياربف راظتنا تاقوأ يف 25% ةبسنب ضافخنا 2022 رياني رهش نيب ددجلا ىضرملل ةلاحلإا 2024 سرامو ،يليكشلا ةجيدخ ةديسلا تلاق اهبناج نم دمح ىفشتسمب ضيرمتلل يذيفنتلا ريدملا تلااحلإا ةرادإ ماظن يف لوحتلا نمضتي“ :ماعلا انتادايع ليغشتو لاماش احلاصإ ديعاوملا زجحو ةرشابملا ةكراشملا للاخ نم ةءافكب ةصصختملا .تامدخلا هذه يمدقمل نم ةدافتسلاا زيزعت ىلإ ةردابملا هذه فدهت اناضرم تاجايتحلا ةيولولأا ءاطعإو ةيلاحلا انتاردق ىضرملا تابلط ميظنت يف انحجن دقل .مهتياعرو تايفشتسملا ىلع ريبكلا طغضلا فيفختو ىفشتسم ةصاخو ةحودلا ةقطنم يف ةيسيئرلا تلااحلإا هيجوت ةداعإ للاخ نم كلذو ماعلا دمح ةينعملا فارطلأا عم ةكارشلاب ةيجيتارتسا ةروصب ةياعرلا ةسسؤمو ةيبطلا دمح ةسسؤم يف تاردابملا هذه تنمض دقو .ةيلولأا ةيحصلا ةياعرلا ىلع ىضرملا لوصح ةددعتملا تاكارشلاو يلاتلابو ،بسانملا قفرملاو ةمدخلا يف ةبسانملا .”دعوملا راظتنا تقو ليلقت ىضرملل نكمي ،ديعاوملاب ةقلعتم تاراسفتسا يلأ ”كعمسن“ ءلامعلا ةمدخل ةدعاسملا طخب لاصتلاا حاتملاو ،16060 مقرلا ىلع ةيبطلا دمح ةسسؤمب .عوبسلأا مايأ لاوط ةعاس 24 رادم ىلع



117 l 2024 )رايأ( ويام يعافرلا للاه روتكدلا هدبع ناسغ روتكدلا صحف ةيلاعف زيزعتل ريخلأا دهجلا اذه نع ،ةساردلا جمد دعاسي نأ عقوتملا نم“ :لائاق ةدلاولا يثيدح يثيدح صحف جمانرب يف يمونيجلا لسلستلا عيسوت يف ريبك لكشب ناكسلا قاطن ىلع ةدلاولا ةيضيلأا ةيثارولا ضارملأا نع ركبملا فشكلا قاطن ابلاغ هذه نلأ ارظنو .اهجلاع نكمي يتلا ةردانلاو ةقاعلإاو عضرلا تايفول يسيئرلا ببسلا نوكت ام رشبت ةيبيرجتلا ةساردلا هذه نإف ،ةايحلا ىدم ةدعاسمل اهمادختسا نكمي ةميق تانايب ريفوتب .”مهتلائاعو ىضرملا ،عمسلل يلماعلا مويلاب لافتحلاا راطإ في ةسسؤم في نزاوتلاو عمسلا ةدحو تمظن يريغت “ راعش تحت ةيوعوت تايلاعف ةيبطلا دمح ةحاتم عمسلاو نذلأاب ةيانعلا لعجنل :ميهافلما فيرعتلا لوح تايلاعفلا هذه تروحتمو .”عيمجلل ةياقولا لبسو هنادقف وأ عمسلا فعض تاببسبم فعض فاشتكلا ةيصيخشتلا تاصوحفلاو ،اهنم .هتجلاعمو عمسلا 300 ىلع ديزي ام ةكراشم تايلاعفلا تدهش دقو لوح ةيميلعتلاو ةيفيقثتلا ةلمحلا يف كراشم امك ،هنم ةياقولا لبسو عمسلا نادقف تاببسم قفارملا نم ددع يف تايلاعفلا نم ددع ةماقا تمت .ةلودلاب ةيبطلا بط يراشتسا ،يداهلا دبع دلاخ روتكدلا دافأ يف نزاوتلاو عمسلا ةدحو سيئرو نزاوتلاو عمسلا نادقفو فعض بابسأ نأ ،ةيبطلا دمح ةسسؤم ابلاغو ةفلتخملا ةيرمعلا لحارملا لمشت عمسلا تارتفلا للاخ اهراثلآ اضرعت رثكأ دارفلأا نوكي ام .مهتايح نم ةجرحلا لمشت ،ةدلاولا لبق ام ةلحرم يف هنأ حضوأو ضرعتت دق امو ةيثارولا لماوعلا بابسلأا هذه ةبصحلا كلذ ىلع لاثم ،لمحلا ةرتف للاخ ملأا هل يف امأ .ايلاخلل مخضملا سوريفلا ىودعو ةينامللأا :ةيتلآا بابسلأا لمشتف ،اهدعب امو ةدلاولا ةرتف ضافخناو ،مدلا نيبوريليب طرفو ،يدلاولا قانتخلاا .بابسلاا نم اهريغو ةدلاولا دنع نزولا ثيح ،ةقهارملاو ةلوفطلا ةلحرم اهدعب يتأت لئاوسلا عمجتو ةنمزملا نذلأا تاباهتلا لمشت ىودع يأو اياحسلا باهتلاو ىطسولا نذلأا يف دقف ،ةخوخيشلاو غولبلا ةلحرم يف امنيب .ىرخأ ةباصلاا يه هنادقفو عمسلا فعض بابسأ نوكت يسحلا عمسلا روهدتو ةنمزملا ضارملأا دحأب يتلا لماوعلا نمو .رمعلا ربكل ةجيتن يبصعلا وأ فعض ىلا يدؤت دق يتلاو ايموي اهل ضرعتن عمش( خلامصلا عمجت لمشت ،عمسلا نادقف ىودعلاو ،ةيذغتلا صقن ،ةبخاصلا ءاضوضلا ،)نذلأا !اهريغو ةيسوريفلا فشكلا ءارجإ متي“ :لائاق يداهلا دبع دلاخ .د عباتو رطق ةلود يف عمسلا نادقفو فعض لكاشم نع ىضرملا ددع غلب امنيب ،ايونس صخش فلأ 28 وحنل 384 ةيعمسلا ةعقوقلا ةعارز ةيلمعل اوعضخ نيذلا وحنل ةيعمسلا تانيعملا ريفوت مت امك ،ضيرم .”ضيرم 10000 ارخؤم ةرداصلا ريراقتلا تركذ لصتم قايس يفو نم 5% نم رثكأ نأ ةيملاعلا ةحصلا ةمظنم نع ىلإ نوجاتحي ،صخش نويلم 430 يأ ،ملاعلا ناكس ةقاعلإل ببسملا عمسلا نادقف ةجلاعمل ليهأتلا .لفط نويلم 34 مهنمو ةيعمسلا ،2050 ماع لولحب هنأ ىلإ تاريدقتلا ريشتو - ملاعلا لوح صخش نويلم 700 نم رثكأ يناعيس عمسلا نادقف نم - صاخشأ ةرشع لك نم دحاو وأ .هتاذ ردصملا بسحب تايلاعف مظنت ةيبطلا دمح ةسسؤم عمسلل يلماعلا مويلا ةبسانبم عمسلا لىع ةظفاحلماو نذلأاب ةيانعلا ةيفيك لوح ةيوعوت يداهلادبع دلاخ.د


2024 )رايأ( ويام l 116 جمابرلا ثركأ دحأ ةدلاولا يثيدح صحف جمانرب دعي ايلماع هقلاطإ ذنم احاجنو ةيلاعف ةماعلا ةيحصلا تنواعت دقو ،ةيضالما ينسمخلا تاونسلا في غيربلدياه ىفشتسم عم ةيبطلا دمح ةسسؤم حجانو لماش جمانرب ذيفنتل اينالمأ في يعماجلا فرعتلل ؛رطق ةلود في ةدلاولا يثيدح صحفل ضارعلأا ثودح لبق جلاعلل ةلباقلا ضارملأا لىع ةيئايميكلا تابلقتسلما ضعب سايق قيرط نع في دجوت يتلا ةيرغصلا تائيزجلا( ةيويحلا .)ئياذغلا ليثمتلا ةيلمع في ةمهلماو مسجلا نم حبصأ ،مونيجلا بط لاجم في مدقتلا عمو ةيمونيجلا تاصوحفلا مادختسا نلآا نكملما فشكلل ةدلاولا يثيدح صحف زيزعتل ةروطتلما اهلمشت لا يتلا ةيفخلا ةيثارولا ضارملأا نع .ةيلاحلا ةدلاولا يثيدح تاصوحف ضارملاا ةنجل سيئر ،يبعكلا دعس روتكدلا لوقي ةيلودلا ةيبطلا نوؤشلا بتكم سيئرو ةردانلا ذنم مئاقلا نواعتلا نإ“ :ةيبطلا دمح ةسسؤمب ىفشتسمو ةيبطلا دمح ةسسؤم نيب ةليوط ةدم ةدلاولا يثيدح صحف لاجم يف يعماجلا غريبلدياه عورشم ءانبل لثمأ لمع راطإ ريفوت يف مهاس رطق في ددجلا ديلاوملل لضفأ ةحص لجأ نم ةيبيرجت ةسارد لوأ قلطي ةيبطلا دمح ةسسؤبم ةردانلا ضارملأا زكرم Q-Chip ةينقت لىع دمتعت ةدلاولا يثيدحل يمونيجلا صحفلل ةعسوم يبعكلا دعس روتكدلا نمايلسلا مير ةروتكدلا يثيدحل مونيجلا صحف“ مسا تحت ديدج ثحب ةثيدح صحف ةادأ ريوطت وه انفده .”ةدلاولا ثودح لبق ةينيجلا ضارملاا ىلع فرعتلل ةركتبمو نكمي لا يتلا ةينيجلا تابارطضلاا ةصاخو ضارعلأا يثيدح صحفلا تاودأ مادختساب اهيلع فرعتلا .”ايلاح ةرفوتملا ةيسايقلا ةدلاولا ةنجل سيئر دعاسم ،ناميلسلا مير ةروتكدلا تلاقو ةساردلا يف يساسلأا ثحابلاو ةردانلا ضارملأا صحفل ةديدجلا ةينقتلا هذه قلاطإ نإ“ :ةيثحبلا ةياقو نامض ىلع لمعت ةدلاولا يثيدحل مونيجلا جلاعلاو صيخشتلا للاخ نم ضارملأل لضفأ نإ .اينيج ةردانلاو ةدقعملا ضارملأا رثكلأ ركبملا صحفلا ليوحت ىلع لمعيس ديدجلا جمانربلا اذه لماشو مدقتم جمانربل ةدلاولا يثيدحل يديلقتلا ثيح نم بسانمو ةعرسو ةقد رثكأ صحفلا حبصيل ةباصإ نم دحلاو ضارملأا ىلع فرعتلل ةفلكتلا .”ةافولاو ضارملأاب عضرلا ،يناث لآ ءامسأ ةروتكدلا تحضوأ اهتهج نمو هذه يف“ :قيقدلا بطلا دهعمل يذيفنتلا ريدملا ةحيرش مادختسا متيس ،ةدئارلاو ةديرفلا ةساردلا ىلع ،Q-Chip مساب ةفورعملاو ،يرأوركيم رطق ةحيرشلا هذه يوتحت .ةدلاولا دعب يرسلا لبحلا مد ةببسملا ةينيجلا تاريغتملا نم فلالآا ىلع انمق ،كلذك .رطق ناكس نيب ةعئاشلا ضارملأل ددع صحفل Q-Chip ميمصتب ةساردلا هذه يف ضرغل جلاعلل ةلباقلا ةينيجلا ضارملأا نم ددحم لك معدي ذإ ،ةدلاولا يثيدحل يمونيجلا صحفلا مسقو مونيجلل رطق جمانربو كنبويب رطق نم ةيبطلا دمح ةسسؤم يف يصيخشتلا مونيجلا .“Q-Chip ةرادإ مسق سيئر ،نارمع نب قيفوت روتكدلا فاضأ هرودب يف كراشملا ثحابلاو يثارولا بطلاو مونيجلا ةصاخ ةينيج تارابتخا اضيأ يرجن فوس“ :ةساردلا يثارولا بارطضلااو يكوشلا تلاضعلا رومضل ةافولل يسيئر ببس ربتعي يذلا يلضعلا يبصعلا صيخشت لجأ نمو ،ةيناثلا نس نود لافطلأا ىدل تلاضعلا رومضب نيباصملا ةدلاولا يثيدح لافطلأا يلاتلابو ،ضرملا ضارعأ ثودح لبق يكوشلا لفطلا ةايح ذاقنلإ يروفلا لخدتلاو جلاعلا ءاطعإ رابتخا ءارجإ متيس .ةايحلا ةيعون نيسحتو باصملا Q-Chip ىلإ ةفاضلإاب يكوشلا تلاضعلا رومض ةدلاولا يثيدحل يسايقلا يضيلأا صحفلاو ضارملأا نم ديدعلا نع لضفأ لكشب فشكلل .“جلاعلل ةلباقلاو ةيضيلأا ةيثارولا سيئرلا ،يعافرلا للاه روتكدلا لاق كلذ ىلإ ةأرملا ةحص زكرمل يبطلا ريدملاو يذيفنتلا رطق جمانرب ريدمو ةيبطلا دمح ةسسؤمب ثاحبلأاو ينطولا جمانربلا حجن“ :ةدلاولا يثيدح صحفل جلاعو صيخشت يف ةدلاولا يثيدح صحفل يلاحلا لافطلأا تائم ىدل ةريطخلا ةيضيلأا ضارملأا ةينب ءاشنإ ىلإ ىدأ امم ،رطق يف ةدلاولا يثيدح يثيدحل مونيجلا صحفل حجانلا ذيفنتلا نامضل ةيتحت يف ةدئار ةيبطلا دمح ةسسؤم لعجي امم ةدلاولا .”طسولأا قرشلا يف لاجملا اذه صحف ةدحو سيئر ،هدبع ناسغ روتكدلا ثدحت امك يف كراشملا يسيئرلا ثحابلاو ةدلاولا يثيدح ةيبط تاسسؤم



119 l 2024 )رايأ( ويام لافطلاا نم ةئفلا هذه جاردإ متيف .ةيعمسلا ملاكلاو ةغللا اوبستكي ىتح ةيجلاع ةطخ نمض ثدحتلا يف ةيوغللا مهتاراهم ريوطت لجأ نم بناوجلا نم ديدعلاب مهتاردق ةيمنتل عامتسلااو ،كاردلااو ةغللاو ثدحتلاو عامتسلااو عامسلا لثم ةرسلاا ةدعاسمب ةيجلاعلا ةطخلا فادها لمتكت ذإ ،ةموظنملا ةذه حاجنل دعاسملا لماعلا مهف تاشاشب دوزم صاخ ناكم زيهجت مت دقف كلذلو عم تاسلجلا روضح نم لهلأا نكمت ةعباتم مسق تامدخ نمضت .بيردتلا قرط ملعتو مهئانبا يظفللا يعمسلا ليهأتلاو ةيعمسلا تانيعملا ةجمرب ،بلاوق عينصت ،عمس تارابتخا( :يهو يعمسلا جلاعلا تاسلجو ةيعمسلا تانيعملا ةمدخلا ىلع ضيرملا لوصح ةيناكما )يظفللا تقو ليلقتل انتعارم عم ةسلسو ةطسبم ةقيرطب .اناضرمل ةحارلا ريفوت لجا نم راظتنلاا ةيؤر نأ يداهلا دبع دلاخ .د دكأ رخآ بناج نم ةيبطلا دمح ةسسؤم يف نزاوتلاو عمسلا ةدحو لاجم يف ةيبطلا ةياعرلا ةدوج ريوطت يف لثمتت ميلعتلاو بيردتلا للاخ نم نزاوتلاو عمسلا جمارب نزاوتلاو عمسلا ةدحو مدقت ذإ ،ثوحبلاو تاعماجلا بلاطل ةدوجلا ةيلاع ةبيردتو ةيميلعت عمسلا ينفو نييئاصخلااو نييلودلاو نييلحملا تاعاطقلا يبستنم عيمجلو ةيحصلا زكارملاب يميلعت جمانرب كلذ لمشيو ،ةلودلاب ةيحصلا قرطو عمسلا تاصوحف لاجم يف يناديم بيردتو ةيبط رداوك ريفوت لجأ نم جلاعلاو صيخشتلا ةيحصلا ةياعرلا تاجايتحا ةيبلتل ةربخلاو ةءافكلا ةيلاع .يرطقلا عمتجملل ةيلبقتسملا فشكلا ءارجإ متي :يداهلا دبع دلاخ .د“ في عمسلا نادقفو فعض لكاشم نع متو ،ايونس صخش فلأ 28 وحنل رطق ةلود ةيعمسلا ةعقوقلا ةعارز ةيلمع ءارجإ تانيعلمايرفوت مت ماك ،ضيرم 384 ـل ”.ضيرم 10000 وحنل ةيعمسلا

ةيبط تاسسؤم نكمي فيك يداهلا دبع دلاخ روتكدلا حضوأ هتهج نم نادقف ىلإ يدؤت يتلا بابسلأا نم ديدعلا بنجت ،ةماعلا ةحصلا تايجيتارتسا عابتا للاخ نم عمسلا دبع روتكدلا دكأ ،عمسلا ىلع ظافحلا نامضلو اهنمو تاداشرلاا هذه عابتا ةرورض ىلع يداهلا ،ةديجلا ةلوفطلاو ةموملأا ةياعر تاسرامم عابتا فشكلاو ةثارولاب ةقلعتملا ةروشملا ميدقتو ريفوتو نذلأا يف ةعئاشلا ضارملأا نع ركبملا ةينهملا جماربلا قيبطت ،اهل بسانملا جلاعلا رركتملا ضرعتلا تلااح يف عمسلا ظفحل ةصصخملا تايجيتارتسا عابتا ،ةيئايميكلا داوملاو ءاضوضلل ةيلاعلا تاوصلأل ضرعتلا نم دحلل ةنملآا عامتسلاا ةيودلأا مادختسا ،اريخأو ةيهيفرتلا تائيبلا يف نادقف نم ةياقولل يبط فارشا تحتو رذحب .نذلأل ةماسلا ةيودلأا نع جتانلا عمسلا يف عمسلل يملاعلا مويلاب لفتحي ملاعلا نأ ركذي يعولا ةدايز فدهب ،ماع لك نم سرام نم ثلاثلا زيزعتو ،عمسلا نادقفو ممصلا نم ةياقولا لوح .ملاعلا ىوتسم ىلع عمسلاو نذلأل ةيحصلا ةياعرلا يف نزاوتلاو عمسلا ةدحو نأ ركذلاب ريدجلاو نادقف ىضرمل مدقت ةيبطلا دمح ةسسؤم اهل ليثم لا تامدخ ،مهنم لافطلأا ةصاخ ،عمسلا ةمدقملا تامدخلا يهاضتو ةقطنملا ديعص ىلع مت دقف ،ةصصختملا ةيملاعلا زكارملا ىقرأ يف رداوكلا فيظوتو ةزهجلأا ثدحأب ةدحولا زيهجت ميدقت نمضي امب ةيلاعلا ةءافكلا تاذ ةبردملا ،ىضرملل ةيحصلا ةياعرلا نم نكمم ىوتسم لضفأ ليهأتلاو ةيعمسلا تانيعملا مسق حاتتفا مت ثيح ميدقتو لماشلا ميقتلا ريفوتل يظفللا يعمسلا لكاشم نم نوناعي نيذلا ىضرملا عيمجل جلاعلا نيب عمجي لماكتم جهن عابتا مت ثيح ،ةيعمس يظفللا ليهأتلا تايجيتارتساو ةثيدحلا ايجولونكتلا .ضيرملا ىلع زكرت يتلا مييقتل ةصتخم تادايع ثلاث مسقلا مضي صاخ ربتخمو ةيعمسلا تانيعملا ةجمربو بيكرتو زهجم نذلأا تادادسو بلاوق عينصتو ميمصتل موقي ثيح ،داعبلأا ةيثلاث ايجولونكتلا ثدحأب ضيرملاب ةصاخلا نذلأا ةمصب ذخأب صصختم قيرف لضفأ نيمدختسم داعبلأا يثلاث ماظنب اهميمصتو ةيعمس تانيعم ةدوج ميدقت لجا نم ماخلا داوملا يعمسلا ليهأتلل تادايع تس دجوت امك ،ةزيمتم عمسلا فاعض لافطلاا ليهأت متي ثيح يظفللا تانيعملا يمدختسمو ةعقوقلا يعراز نم



121 l 2024 )رايأ( ويام ،ةيبطلا دمح ةسسؤمب ةزغ ىضرمل يعمتجملا ىضرمل يعمتجملا معدلا قيرف نم فدهلا نأ ةزغ نم نيمداقلا ىضرملا لوصح نامض وه ةزغ ىلع اضيأ نكلو ةيبط ةياعر لضفأ ىلع طقف سيل .مهجلاع ءانثأ يعمتجملا معدلل ىلثملا دئاوفلا ةيعامتجلاا ةمدخلا ةرادإ ربتعت“ :دشارلا تلاقو ةيناسنلإا ةمهملا هذه ةيبطلا دمح ةسسؤم يف تايقلاخلأا قيبطت نم اننكمت ذإ ،انل زايتما ةباثمب للاخ نم يعامتجلاا لمعلل ةيساسلأا ئدابملاو نمو .ةلماشلا مهتاجايتحا قيقحتو ىضرملا نيكمت ءبعلا فيفختل ىعسن ،ةينافتملا اندوهج للاخ نم ةعومجم ميدقت ربع مهرسأو ىضرملا نع .ةيدرفلا مهفورظل اصيصخ ةممصملا تامدخلا تامدخلا ىلإ لوصولا ليهست كلذ لمشيو يمدقم ريفوتل قيسنتلاو ،ةيساسلأا ةيحصلا ،نوقفارملا اهيف رفوتي لا يتلا تلااحلا يف ةياعرلا يعامتجلاا يسفنلا معدلا تاكبش ءاشنإو قيرفلا ءاضعأ عم نواعتلا للاخ نم ىضرملل زيزعتل ةيبطلا دمح ةسسؤمب تاصصختلا ددعتم ةيحصلا ةياعرلا ةلحر لاوط ةيهافرلاو ةنورملا ةمدخلا قيرف نأ دشارلا تفاضأو .”مهب ةصاخلا نيكمتلاو ةيلومشلا ةفاقث زيزعتب مزتلي ةيعامتجلاا نم هنأ نمؤن نحن“ :ةلئاق ،ةزغ ىضرم عمتجم لخاد نيعوطتملاو ةيلحملا تامظنملا عم نواعتلا للاخ لولح ءاشنإ اننكمي ،ةلودلا يف ةينعملا تاهجلاو يبلت لا ةمادتسم ززعت لب ،بسحف ةلجاعلا ةيحصلا ةياعرلا تاجايتحا .ليوطلا ىدملا ىلع يتاذلا ءافتكلااو ةنورملا اضيأ لمعلاو عمتجملا ةكراشم ةيمهأ ىلع انجهن دكؤيو ةحصلا قيقحتل ىضرملا معد يف يعامجلا ةياعر ةئيب داجيإ ىلإ ةفاضلإاب .عيمجلل ةيهافرلاو .”عيمجلل ةحاتم ةيحص ،يلامشلا ةحيلم ةديسلا تحضوأ ،هتاذ قايسلا يف ةيعامتجلاا ةمدخلا ةرادلإ يذيفنتلا ريدملا دعاسم ةزغ ىضرمل يعمتجملا معدلا قيرف يف وضعو ءاوجأ ءافضإ وه ةيلاعفلا هذه نم فدهلا“ :ةلئاق ىضرم نم انفويض ىلع ةعتملاو ةجهبلا نم باعلأو ةطشنأ ةماقإ للاخ نم ،مهيقفارمو ةزغ ةلاحلا نيسحت ىلإ فدهتو مهتاجايتحا عم قفاوتت ةيعامتجلاا ةمدخلا ةرادإ نمؤت .مهيدل ةيجازملا يف ايعامتجا مهجمدو ىضرملا ةكراشم ةيمهأب فيفخت يف مهست يتلا ةفلتخملا ةطشنلأا دقو .ليهأتلا وأ جلاعلا ةرتف لوط نع جتانلا رتوتلا يف نيميقملا ىضرملا نم ددع ةيلاعفلا رضح نم جمانربل ايلاح نوعضخي نيذلاو ىفشتسملا يف ةكراشملل مهل ةصرف تناكو ،ليهأتلاو جلاعلا زيزعت يف مهاسي امم هيفرتلاو ةعتملا نم ءاوجأ .”ةيسفنلا مهتحص يئاصخأ ،يدمحأ ءامسأ ةديسلا تدافأ اهبناج نم يف وضعو ليهأتلا ةداعلإ رطق زكرمب يعامتجا فدهلا نأ ،ةزغ ىضرمل يعمتجملا معدلا قيرف ىضرملل ةيهيفرت تايلاعف ميظنت نم يساسلأا ،يسفنلا هافرلا زيزعت يف لثمتي مهيقفارمو قلقلاو داهجلإا تايوتسم ليلقت ىلع لمعلاو لعافتلا عيجشت ىلع لاضف ،طرفملا ريكفتلاو .مهل ةمعادلا ةيعامتجلاا تاقلاعلا ءانبو يعامتجلاا



2024 )رايأ( ويام l 120 ةيبط تاسسؤم ةعباتلا ةيعماتجلاا ةمدخلا ةرادإ تمظن نيشرعلاو يداحلا في ةيبطلا دمح ةسسؤلم نم ينمداقلا ضىرملل ةيهيفرت ةيلاعف ليربأ نم تايفشتسبم مهجلاع نوقلتي نيذلا ةزغ عاطق ةطشنأ ةيلاعفلا هذه تنمضت ثيح ،ةسسؤلما اضرعو ،ةيهيفترلا تاقباسلما اهنيب نم ةيلعافت تابجو ميدقتو لافطلأل نيولت ةطشنأو ،ايورك .ةيحصو ةفيفخ نع هيفرتلا يف ةردابملا هذه نم فدهلا لثمت نع لاضف ،ةيسفنلا مهتحص زيزعتل ىضرملا جلاعلا نوقلتي ثيح رطق ةلود يف مهب بيحرتلا لوصحلا بناج ىلإ ،ةدوجلا تايوتسم ىلعأ قفو يسفنلا معدلا اصوصخو مزلالا معدلا ىلع نوقفارملاو ىضرملا ههجاوي امل كلذو ،يعامتجلاا يف ةرئادلا ثادحلأا ءارج ةبعص تايعادت نم مهل ةقيدح يف تميقأ يتلا ،ةيلاعفلا رضح .ةزغ عاطق يبستنم نم ددع ،ةيبطلا ةفيلخ نب دمح ةنيدم معدلا قيرف ءاضعأو ةيعامتجلاا ةمدخلا ةرادإ ،ةيبطلا دمح ةسسؤم يف ةزغ ىضرمل يعمتجملا ةصاخلا تايفشتسملا ضعب يلثمم ىلإ ةفاضلإاب .ةلودلا يف يذيفنتلا ريدملا ،دشارلا رياشب ةديسلا تدافأ دقو معدلا قيرف سيئرو ةيعامتجلاا ةمدخلا ةرادلإ ةيبطلا دمح ةسسؤبم ةيعماتجلاا ةمدخلا ةرادإ ةزغ عاطق نم ينمداقلا ضىرملل ةيهيفرت ةيلاعف مظنت


123 l 2024 )رايأ( ويام ريزو ،يراوكلا دمحم نانح ةروتكدلا ةداعس تدكأو اهب ىظحي يتلا ةريبكلا ةيمهلأا ىلع ةماعلا ةحصلا ”ةيحصلا ةياعرلا لبقتسم ليكشت“ ىدتنملا عوضوم ةعيفر ةكراشمب اهشقاني يتلا ةماهلا اياضقلاو نم نيصتخملاو ءاربخلاو رارقلا عانص نم ىوتسملا .ملاعلاو يبرعلا نطولاو رطق اهل يفحص حيرصت يف اهتداعس تفاضأو تادجتسملا لظ يف“ :ىدتنملا داقعنا ةبسانمب يحصلا ماظنلا اههجاوي يتلا ةيحصلا تايدحتلاو رمتسملا لمعلل ةريبكلا ةيمهلأا زربت يملاعلا ةنورمو ةوق رثكأ نوكتل ةيحصلا ةمظنلأا ريوطتل ةماه ةبسانم ىدتنملا اذه لكشيو ،ةمادتساو ىلع ةحجانلا تاسرامملاو تاربخلا لضفأ لدابتل دوشنملا مدقتلا قيقحتل ملاعلاو ةقطنملا ىوتسم ”.ةيحصلا ةياعرلا عاطق يف ىلع صرحت رطق ةلود نإ“ :اهتداعس تفاضأو ميظعتو ةزيمملا جذامنلاو ةحجانلا براجتلا لدابت مهاسي امبو ،ايملاعو ايبرعو ايلحم اهنم ةدافتسلاا انتايجيتارتساو ةينطولا رطق ةيؤر قيقحت يف نواعتلا زيزعتو ،يرطقلا عمتجملا ةمدخل ،ةيحصلا .”يحصلا لاجملا يف يلودلاو يبرعلا ةيذيفنتلا ةريدملا ،زيوب نيمي سيلأ ةديسلا تلاقو يمسرلا ثدحتملاو ةيبرعلا تايفشتسملا داحتلا هدوهج ةيبرعلا تايفشتسملا داحتا لصاوي“ :همساب ةزيمتملا ةيحصلا تاعاطقلا ىلع ةءاضلإاب ةخسارلا دعي يذلاو رطق يف ةيحصلا ةياعرلا عاطقو ايبرع ىذتحي لااثم امود انتطعأ يتلا تاعاطقلا نم ادحاو دمتعملا يحصلا ماظنلا للاخ نم ءاوس زيمتلاب هب مدقتو زيمتو اهتدوجو ةيحصلا تامدخلا ةيعونو ريياعم ىلعلأ ةقباطملا ةديرفلا ةيحصلا تاسسؤملا ةيحصلا ةياعرلا عاطق نأ امك ،ايملاع ةدوجوملا ةدوجلا ايملاعو ايميلقإو ،ايبرع ةدئار ةناكمب ىظحي رطق يف نم ،امدقت اهرثكأو ةيحصلا تاعاطقلا لضفأ دحأك يذلا ماهلا ثدحلا اذه ةماقلإ رطقل انرايتخا ناك انه ةيجيتارتسا ةكارش ءانب ىلع داحتلاا صرح سكعي للاخ تدسجت ةيبطلا دمح ةسسؤم عم ةزيمم ةيقار ةروص ءاطعإ اهللاخ انعطتسا ماع رشع سمخلا .”ءانبلا يحصلا يبرعلا نواعتلاو لماكتلا نع لبقتسم ليكشت“ ناونع ماعلا اذه ىدتنملا لمح نم اددع هتايلاعف تطغ ثيح “ ةيحصلا ةياعرلا ةياعرلا لبقتسم اهزربأ نمو ةماهلا تاعوضوملا ءاكذلا لثم ةئشانلا تاينقتلا جمدو ةيبرعلا ةيحصلا ميدقت نيسحتو ىضرملا ةياعر زيزعتو ،يعانطصلاا ةياعرلا ىلع زيكرتلا ىلإ ةفاضلإاب ةيحصلا ةياعرلا ةياعرلا لوحتو ،ةمادتسلااو ،ميقلا ىلع ةمئاقلا .ةيمقرلا ةيحصلا رارقلا باحصلأ ىوتسملا عيفر روضحب ىدتنملا زيمت ءاسؤرو ،ءارزو نم يبرعلا يحصلا عاطقلا يف نم نيلثممو ،نييموكح نيلوؤسمو ،ةيحص تائيه عانصو ،ةلصلا تاذ ةيلودلاو ةيميلقلإا تامظنملا نم ةيحصلا ةياعرلا عاطق يف نييسيئرلا رارقلا .ةيملاع تاكرشو ىربك تاسسؤم يريدم نم ددع ىدتنملا يف كراش امك نييرادإو ءابطأو ةصاخلاو ةيموكحلا تايفشتسملا نم لودلا نم ددع نم ةحصلا عاطق يف نيلماعو ،ةيدوعسلا ةيبرعلا ةكلمملاو ،رطق ةلود اهزربأ ،تيوكلا ةلودو ،ةدحتملا ةيبرعلا تاراملإا ةلودو رصم ةيروهمجو ،نامع ةنطلسو ،نيرحبلا ةكلممو ةيندرلأا ةكلمملاو ،ةينانبللا ةيروهمجلاو ،ةيبرعلا لثم ىرخلأا لودلا نم ددع ىلإ ةفاضإ ،ةيمشاهلا ،ةدحتملا ةكلمملاو ،ةيكريملأا ةدحتملا تايلاولا ةيداحتلاا ايناملأ ةيروهمجو ،ةيسنرفلا ةيروهمجلاو .دنهلا ةيروهمجو ،اكيجلب ةكلممو


2024 )رايأ( ويام l 122 ةماعلا ةحصلا ةرازو ةياعرب ةيبرعلا تايفشتسلما داحتا همظن رطق فادهأ – ةيحصلا ةياعرلا ريوطتل بيرعلا ىدتنلما تايلاعف داقعنا ةعساو ةيلماعو ةيبرع ةكراشبم ىدتنلما تايلاعف ارخؤم ةحودلا تفاضتسا ،رطق فادهأ – ةيحصلا ةياعرلا ريوطتل بيرعلا ،يراوكلا دمحم نانح ةروتكدلا ةداعس روضحب دبع دلاخ روتكدلا ةداعسو ،ةماعلا ةحصلا ريزو صرم ةيروهمج في ناكسلاو ةحصلا ريزو – رافغلا في ينلوؤسلما رابك نم ددع لىإ ةفاضإ ،ةيبرعلا ثركأ نم ءابرخو ينصتخمو ،بيرعلا يحصلا عاطقلا .ةلود 15 نم داحتا ،نيموي ىدم ىلع دقع يذلا ،ىدتنملا مظن ةماعلا ةحصلا ةرازو ةياعرب ةيبرعلا تايفشتسملا يجيتارتسلإا كيرشلا ةيبطلا دمح ةسسؤم معدو ،ةيبرعلا لودلاب ةحصلا تارازو عم نواعتلابو ،داحتلال قرشل ةيملاعلا ةحصلا ةمظنمل يميلقلإا بتكملاو .ىرخلأا ةيسيئرلا تاهجلا نم ديدعلاو ،طسوتملا دمحم نانح ةروتكدلا ةداعس تملست ىدتنملا للاخ يويؤرلا دئاقلا ةزئاج“ ،ةماعلا ةحصلا ريزو ،يراوكلا تايفشتسملا داحتا نم ”يحصلا ماظنلا زيمت يف عاطقلا مدقتو روطت يف ةريبكلا اهدوهجل ةيبرعلا دبع دلاخ روتكدلا ةداعس ملست امك .يبرعلا يحصلا رصم ةيروهمج يف ناكسلاو ةحصلا ريزو – رافغلا .”ةماعلا ةحصلا زيزعت يف زيمتلا“ ةزئاج ةيبرعلا ةيبط تاسسؤم


125 l 2024 )رايأ( ويام جماربلا مسقب ،زوكايروك يونيب روتكدلا اهنع ةباين حاجنب ءاهتنلاا لثمي“ :ةرازولاب طيطختلاو ةينطولا انتلحر يف ةقراف ةملاع ةيبيردتلا ةشرولا هذه نم .رطق يف ةيحصلا ةياعرلا ماظن ءادأ زيزعت وحن اهبستكا يتلا تاراهملاو ةفرعملا بعلتسو نيسحتلا ةلجع عفد يف امساح ارود نوكراشملا عيمجل ةدوجلا ةيلاع ةياعر ميدقت نامضو رمتسملا .”رطق يف نيميقملا ءانبل انيتم اساسأ ةيبيردتلا لمعلا ةشرو تسرأ ميدقت يف زيمتلا قيقحتو راكتبلاا زيزعتو تاردقلا .ةيحصلا ةياعرلا للاخ ةيوعوت ةلمح نوقلطي اهؤاكشرو ةماعلا ةحصلا ةرازو :ينصحتلاب حاورلأا ذاقنإ( راعش تحت يلماعلا ينصحتلا عوبسأ )اهقيقحت نكيم ةيناسنإ ةيلوؤسم عم نواعتلاب ةماعلا ةحصلا ةرازو تقلطأ ةيلولأا ةيحصلا ةياعرلاو ةيبطلا دمح يتسسؤم ةلمح صاخلا يحصلا عاطقلاو بطلل ةردسو يلماعلا ينصحتلا عوبسأب لافتحلاا للاخ ةيوعوت راعش تحت 2024 ليربأ 30 لىإ 24 نم ةترفلا في نكيم ةيناسنإ ةيلوؤسم :ينصحتلاب حاورلأا ذاقنإ( .)اهقيقحت ةيمهأ ىلع ءوضلا طيلست ىلإ ةلمحلا تفده نيصحتلا ةمهاسم ةيفيكو تاحاقللا ىلع لوصحلا ةباصلإا مدعب عمتجملا دارفأ ةايح ذاقنا يف ىلإ اهتافعاضم يدؤت نأ نكمي يتلا ضارملأاب لوصحلل عمتجملا دارفأ معد ىلإ ةفاضلإاب ،ةافولا نكمي يتلا ضارملأا دض ةمزلالا تاحاقللا ىلع مهسفنلأ نيصحتلا قيرط نع اهنم ةياقولا .مهلافطأو تاميعطتلا نع ةيوعوت لئاسر رشن ةلمحلا للاخ مت زيزعت مت امك ،يعامتجلاا لصاوتلا لئاسو ربع ةيحصلا ةياعرلا زكارم نم ددع يعجارم ىدل ةيعوتلا يف رفوتي .ةصاخلا تادايعلاو زكارملاو ،ةيلولأا ىوتسم ىلع ميعطتلا جمارب لضفأ دحأ رطق ةلود عم نواعتلاب ةماعلا ةحصلا ةرازو رفوت ثيح ملاعلا ةدوجلا ةيلاعو ةيناجملا ميعطتلا تامدخ اهئاكرش لودج رفويو ،رطق ةلود قطانم فلتخم يف ةيامحلا رطق يف دمتعملا ةينيتورلا تاميعطتلا تدمتعا امك ،اضرم 16 نم رثكأ نم لافطلأل ددع ليلقتل ةبكرملا تاحاقللا ماظن ةرازولا ىلع ةظفاحملا عم لفطلا اهاقلتي يتلا تاعرجلا .اهسفن ةيلاعفلاو ةيامحلا

2024 )رايأ( ويام l 124 ئراوطلا نم ةياقولاب ةينعلما ةئمادلا ةنجللا عماتجا في كراشت رطق ةيلماعلا ةحصلا ةمظنبم اهل ةباجتسلااو بهأتلاو ةيحصلا ءادأ مييقتل ةيبيردت لمع ةشرو مظنت ةماعلا ةحصلا ةرازو لماشلا يحصلا ماظنلا عبارلا عماتجلاا في ارخؤم رطق ةلود تكراش ئراوطلا نم ةياقولاب ةينعلما ةئمادلا ةنجلل ةحصلا ةمظنبم اهل ةباجتسلااو بهأتلاو ةيحصلا ةقيرطب عماتجلاا دقع ثيح ،فينج في ةيلماعلا ةكراشلماو صيخشلا روضحلا ينب عمجت ةطلتخم .تنترنلإا برع ةروتكدلا ةداعس عامتجلاا يف ةلودلا دفو سأرت سيئرو ةماعلا ةحصلا ريزو يراوكلا دمحم نانح كلذو ،ةيملاعلا ةحصلا ةمظنمل يذيفنتلا سلجملا .دعب نع لاصتلاا تاينقت للاخ نم نم ،ةماهلا تاعوضوملا نم اددع عامتجلاا شقان ةيحصلا ئراوطلا نأشب ةثدحم تامولعم اهزربأ شقان امك .ايلود اقلق ريثت يتلا ةرمتسملا ةماعلا ةيملاعلا ةحصلا ةمظنم جمانرب زيزعت عامتجلاا اذه يف مت ثيح ،هيلع فارشلإاو ةيحصلا ئراوطلل نم ةياقولا نأشب ةثدحم تامولعم ضارعتسا ددصلا ةردقلاو اهل ةباجتسلااو بهأتلاو ةيحصلا ئراوطلا ةيحصلا تاديدهتلا كلذ يف امب ،دومصلا ىلع تامولعم ىلإ ةفاضإ ،ايفاضإ ابهأت بلطتت يتلا ةيسيئرلا ةيحصلا ئراوطلل ةباجتسلاا نأشب ةثدحم ةنجل نع ةرداصلا تايصوتلا ذيفنت ةلاحو ،ةيراجلا ةيبيردت لمع ةشرو ةماعلا ةحصلا ةرازو تمظن لماشلا يحصلا ماظنلا ءادأ مييقتل ارخؤم ،”رطق في ةيحصلا ةياعرلا في زيمتلا ةدايق“ تاراهلما ريوطتل ”ناقتإ“ زكرم في كلذو ،ةيبطلا دمح ةسسؤبم ،عادبلإاو ةيكينيلكلإا قفارم نم 209 ليثمم نم 600 وحن ةكراشبمو ةيموكحلا تايفشتسلما نم ةيحصلا ةياعرلا زكارمو ةيلولأا ةيحصلا ةياعرلا زكارمو ةصاخلاو ءابطلأا كلذ في ابم تادايعلاو جلاعلاو صيخشتلا نيريدلماو تايفشتسلما يريدمو ينضرملماو ينسحت يقسنمو ةدوجلا يريدمو ينيريسرلا .ةئبولأا ءمالعو ينيويحلا ينيئاصحلإاو ءادلأا ةيبط تاسسؤم مييقتل يمسرلا قلاطلإل اديهمت ةشرولا دعت هقلاطإ ررقملاو ،لماشلا يحصلا ماظنلا ءادأ ديوزت ىلإ ةشرولا تفدهو ،يراجلا ماعلا فصتنم مييقتل ةمزلالا ةفرعملاو تاراهملاب نيكراشملا هزيزعتو رطق ةلود يف ةيحصلا ةياعرلا ماظن ءادأ ةيلعافت تاسلج دقع للاخ نم كلذو ،لاعف لكشب ةعومجم فاشكتسا اهللاخ مت ،مايأ ةعبرأ رادم ىلع بناوجلا ىلع زيكرتلا عم ،تاعوضوملا نم ةعساو ديدحتو ةيساسلأا ميهافملا مهف لثم ةيسيئرلا ،ةقدب تانايبلا عمج ةيمهأو ،مييقتلا تارشؤم ةممصملا تانايبلا عمجل ةفلتخملا بيلاسلأاو ،يحصلا ماظنلا مييقتل ةفلتخم داعبلأ اصيصخ مييقتل لاعف لكشب اهعمج مت يتلا تانايبلا ليلحتو نوكراشملا بستكا .ةيحصلا ةياعرلا ةمظنأ ءادأ ةملاسلاو ةءافكلاو ةيلاعفلا مييقت ىلع ةردقلا .ةمظنلأا هذه لخاد ةلماكتملا ةياعرلا ىوتسمو طاقن ديدحت ىلع نيكراشملا لمعلا ةشرو تعجشو تايصوت دادعإ يلاتلابو ،نيسحتلا تلااجمو ةوقلا ماظنلا ءادأ زيزعت ىلإ فدهت ةلدلأا ىلع ةمئاق .فاطملا ةياهن يف ىضرملا جئاتن نيسحتو يحصلا طيطختلا ةرادإ ريدم ،يريثكلا ىده ةديسلا تلاق ةحصلا ةرازو يف راكتبلااو ءادلأاو يجيتارتسلاا اهاقلأ يتلا ةشرولا للاخ اهتملك يف ةماعلا ةمظنم جمانربل ةلقتسملا ةيراشتسلاا ةباقرلا ةثدحم تامولعمو ،ةيحصلا ئراوطلل ةيملاعلا ةحصلا ،بهأتلا دصرل يملاعلا سلجملا ةنامأ ريرقت نع ةيئانثتسلاا تاعامتجلال ةدحوملا ليغشتلا تاءارجإو ةياقولاب ةينعملا ةمئادلا ةنجللا نأ ركذي .ةمئادلا ةنجلل ىلوتت اهل ةباجتسلااو بهأتلاو ةيحصلا ئراوطلا نم ضارعتسا اهزربأ نم ،ةيسيئرلا ماهملا نم اددع ةيحصلا ئراوطلل ةيملاعلا ةحصلا ةمظنم جمانرب بسح تايصوتلا ميدقتو ،اهل تاداشرلإا ريفوتو .ةمظنملل يذيفنتلا سلجملا ىلإ ءاضتقلاا


2024 )رايأ( ويام l 126 لافتحلاا في كراشت رطق يلماعلا ةحصلا مويب ةحصلا مويب لافتحلاا في رطق ةلود تكراش لك نم ليربأ نم عباسلا قفاوي يذلا يلماعلا برتعت .)يقح ،يتحص( ماعلا اذه هعوضومو ،ماع دقو ،ةحصلا في قحلا نماض في ةدئار رطق ةلود ىنعت ةلودلا نأ لىع ةلودلل مئادلا روتسدلا دكأ جلاعلاو ةياقولا لئاسو رفوتو ،ةماعلا ةحصلاب نم اقلاطناو .نوناقلل اقفو ةئبولأاو ضارملأا نم لىعو ايوق ايحص اماظن رطق ةلود تسسأ ،كلذ ةيطغتلا ةيمهأ لوح روحمتي يلماع ىوتسم .عمتجلما دارفأ عيمجل ةلماشلا ةيحصلا ةحصلا ريزو ،يراوكلا دمحم نانح ةروتكدلا ةداعس ىلع رطق ةلود صرح نم اقلاطنا هنأ تدكأ ةماعلا تلمع دقف ،ناكسلا عيمجل ةحصلا يف قحلا نامض ةدوجلا تاذ ةيحصلا ةياعرلا تامدخ ريفوت ىلع ةلودلا يتلا ةياعرلا ىلع عمتجملا دارفأ لوصح نامضل ةيلاعلا ام وهو ،نيبسانملا نامزلاو ناكملا يفو اهنوجاتحي ،ةيحصلا انتايجيتارتساو ةينطولا رطق ةيؤر هيلع دكؤت تفاضأو .ةمادتسملا ةيمنتلا فادهأ قيقحت ززعيو ةرضح لبق نم ةميكحلا تاهيجوتلا لضفب“ :اهتداعس ريمأ يناث لآ دمح نب ميمت خيشلا ومسلا بحاص اريبك اروطت يحصلا ماظنلا دهش ىدفملا دلابلا يف اصوصخ ،ناكسلل ةيحصلا تاجايتحلاا ةيبلتل اماهو مازتللاا عم ،يناكسلا ومنلل ةعفترملا تلادعملا لظ لمشو ،ةيحصلا ةياعرلا يف ةدوجلا ريياعم لضفأب ،ةيحصلا قفارملاو تآشنملا يف ريبكلا عسوتلا كلذ ريوطتب مامتهلاا فيثكت عم ،ةؤفكلا ةلماعلا ىوقلاو .”ةيحصلا تاينقتلاو تامدخلا يف ريبكلا مدقتلا مهاس امك“ :اهتداعس تلاقو يف ةفاك ةلودلا تاعاطق عم نواعتلاو يحصلا ماظنلا وهو ايملاع زربلأا يحصلا يدحتلل ةؤوفكلا ةباجتسلاا ىندأ دحأ رطق ةلود تلجس ثيح ،-19ديفوك ةحئاج .ملاعلا يف ةحئاجلا نع ةمجانلا تايفولا تلادعم هتامدخو يحصلا ماظنلا روطت كلذك مهاس امك ثادحلأا نم ديدعلا حاجنإ يف ةمدقتملا ةيحصلا ةلوطب اهزربأ نمو ،ىربكلا ةيضايرلا تلاوطبلاو ايسآ سأك ةلوطبو 2022 رطق افيف ملاعلا سأك ةيضايرلا تلاوطبلا رثكأ نم اتناك ثيح ،2023 رطق ءاكرشلاو ةماعلا ةحصلا ةرازو نيب نواعتلابو ،ةيحصلا قلخ يف ناتلوطبلا تمهاس نييلودلاو نييلحملا ةداعس تفاضأو .”ةضايرلاو ةحصلل مادتسم ثرإ يف ةحصلا جهن نم اقلاطناو“ :ةماعلا ةحصلا ريزو ةيبط تاسسؤم ةماعلا ةحصلا ةرازو هتدمتعا يذلاو تاسايسلا عيمج مت دقف ،ةحصلل ةيناثلا ةينطولا ةيجيتارتسلاا نمض عمتجملاو ةلودلا تاعاطق لك نيب كرتشملا لمعلا تازجنم نمو ،ناكسلا عيمجل فاصنلإاو ةحصلا زيزعتل يف ىلولأا تحبصأ رطق ةلود نأ جهنلا اذه دامتعا ةنيدملا بقل ىلع اهتايدلب عيمج لصحت يتلا ملاعلا جمانرب معديو ،ةيملاعلا ةحصلا ةمظنم نم ةيحصلا ةداعس تلاقو .”ناكسلا هافرو ةحص ةيحصلا ةنيدملا زيزعت ىلع رطق ةلود صرحت امك“ :ةماعلا ةحصلا ريزو نادلبلل يحصلا معدلا ميدقتو ،يلودلا نواعتلا يف ةماهلا تاردابملا نمو ،لخدلا ةليلقو ةطسوتملا خيشلا ومسلا بحاص ةرضح تاهيجوت ددصلا اذه لفكتب ىدفملا دلابلا ريمأ ،يناث لآ دمح نب ميمت ةزغ عاطق نم ينيطسلف 1500 جلاع رطق ةلود دوهج نمض ،ةددحملا تايفشتسملا نم ددع يف لظ يف نيينيطسلفلا ءاقشلأا نع فيفختلل ةلودلا .”هل نوضرعتي يذلا يليئارسلاا ناودعلا تاردابملا نم ديدعلا ةماعلا ةحصلا ةرازو تقلطأ نمو ،ةحصلا يف قحلا معد ىلإ ةفداهلا ةماهلا هرشنو ،ىضرملا تابجاوو قوقح قاثيم رادصإ اهزربأ ،ناكسلا عيمج نم همهف ةلوهسل تاغل نامثب لكشب ضيرملا تابجاوو قوقح قاثيملا نمضتيو ةيحصلا تآشنملا نأ ىلإ ةراشلإا عم ،طسبمو حضاو ززعيو .هقيبطتو روهمجلل هضرعب ةمزلم ةلودلا يف 2022 ةنسل )9( مقر ةماعلا ةحصلا ريزو رارق كلذ اهتاعارم بجاولا ىضرملا تابجاوو قوقح ديدحتب كلذل فاضي ،ةيحصلا ةياعرلا تامدخ يقلت ىدل ةبسانمبو .ىضرملا كارشإ تاردابم نم ديدعلا ةيملاعلا ةحصلا ةمظنم حضوت يملاعلا ةحصلا موي نكت مل ام ةحصلا يف قحلا لامعإ نكمي لا هنأ ،ةديجو ،ةلوبقمو ،ةحاتمو ،ةرفاوتم ةيحصلا تامدخلا .ةفلكتلا ةروسيمو ملاعلا ناكس فصن نم رثكأ نأ ةمظنملا دكؤتو ةياعرلا تامدخ ىلع لوصحلا ةيناكمإ ىلإ نورقتفي رثكأ هجاوي امك .ةلماك ةروصب ةيساسلأا ةيحصلا ىلع لوصحلا يف ةيلام ةقشم صخش يرايلم نم ةحصلا ةمظنم دكؤت .ةيساسلأا ةيحصلا ةياعرلا ةيملاعلا ةحصلا موي عوضوم رايتخا“ نأ ةيملاعلا لك قح نع عافدلل يتأي )يقح ،يتحص( ماعلا اذهل تامدخلا ىلع لوصحلا يف ناكم يأ يف صخش هايم نع لاضف ،تامولعملاو ميلعتلاو ةيحصلا ةديجلا ةيذغتلاو يقنلا ءاوهلاو ةنومأملا برشلا ةيئيبلا فورظلاو قئلالا لمعلاو ديجلا نكسلاو .”زييمتلا نم ررحتلاو ،ةمئلاملا

129 l 2024 )رايأ( ويام دعب نع بطلا نيديفتسلما ثركأ ضيرلماو ...اهل صرح لا تاناكمإ ةقيرط لىع اقيمع ايرثأت دعب نع بطلا ثدحأ دقل ايازلما نم ديدعلا حاتأو ،ةيبطلا تامدخلا ميدقت ءاوس دح لىع ةيبطلا تاسسؤلماو ضىرملل تلكش يتلا تلااصتلاا تاينقت مادختسا لضفب نع بطلا .ةيحصلا ةياعرلا لاجم في ةيعون ةلقن نع لاصتلاا تاينقت مادختساب فرعي يذلا ،دعب عساو حبصأ ةيحصلا ةياعرلا تامدخ ميدقتل دعب .ةيرخلأا تاونسلا في قاطنلا ةياعرلا ميدقت ىلع ريبك ريثأت هل دعب نع بطلا لوصولا ةلوهس هدئاوف ضعب نمو ،ةيحصلا ىلع لوصحلا ىضرملل حيتي ثيح ةيبطلا تامدخلل مهعقوم نع رظنلا ضغب ةيبطلا تاراشتسلإا .دهجلاو تقولا رفويف يفارغجلا جئاتن زيزعت ىلع ةردقلا هيدل دعب نع بيبطتلا ىلإ ةمءلام رثكأ لوصو ريفوت للاخ نم ىضرملا ،راظتنلإاو رفسلا تاقوأ ليلقتو ،ةيبطلا ةربخلا ،ةيئاقولا ةياعرلا زيزعتو ،دراوملا صيصخت نيسحتو .ةيلامجلإا ةيحصلا ةياعرلا فيلاكت ليلقت يلاتلابو ةنمزملا ضارملأا ةرادإ نيسحت ىلع دعاسي امك ةيحصلا مهتلاح ةعباتم ىلع ىضرملا ثح للاخ نم ةيبطلا تاهيجوتلا ىلع لوصحلاو لضفأ لكشب بطلا تاينقت نم ةدافتسلإا كلذك نكمي .ةمزلالا ،ةيحصلا ةيوعوتلا جماربلا ميدقت يف دعب نع ةباصلإا نم دحلل ةيئاقولا تاراشتسلإا ميدقتو .ضارملأاب هيدل دعب نع بيبطتلا نأ نيح يفو ،لباقملا يف ،ةيحصلا ةياعرلا ةرادإ يف ةروث ثادحإ ىلع ةردقلا ةسارد بلطتي حجان لكشب ةيللآا هذه قيبطت نإف ةلاعفلا ةدافتسلإل يجيتارتسا جهنو تايدحتلل ةينأتم لكشب تايدحتلا هذه ةجلاعم للاخ نم .اهصرف نم نع بيبطتلل نكمي ،صرفلا نم ةدافتسلااو لاعف ةيحصلا ةياعرلا ىلإ لوصولا ةيناكمإ نيسحت دعب ةماعلا ةءافكلاو ،ىضرملا جئاتنو ،ريبك لكشب نع بطلا لمحي ،عقاولا يف .ةيحصلا ةياعرلا ةمظنلأ :ةيحصلا ةياعرلا ميدقت ىلع ةريبك راثآ هتايط يف دعب لىإ لوصولا ينسحت ةيحصلا ةياعرلا نلآا نكمي ثيح ةيفارغجلا زجاوحلا ىلع بلغتلا ةكرحلا يوذ وأ ةيئانلا عقاوملا يف ىضرملل نيصصختملاو ةينيتورلا ةياعرلا يقلت ةدودحملا دويقلا ليزي امم ،دعب نع بيبطتلا لضفب ةياعرلا يمدقم نيب دعب نع تاراشتسلإا .ةيفارغجلا تاملاكم للاخ نم اهؤارجإ نكمي ىضرملاو ةيحصلا ةيفتاهلا تاثداحملا وأ يلعفلا تقولا يف ويديفلا تافصولا ىضرملا ىقلتيف ةنملآا لئاسرلا وأ تقولا نم للقي ام ،مهلزانم نم حئاصنلاو ةيبطلا ةدايزو رفسلا ىلع اهقافنإ متي يتلا ةفلكتلاو .ةيفيرلا وأ ةيئانلا قطانملا ىلإ لوصولا ةيناكمإ ناكمإب تاب دعب نع بطلا تاينقت لضفب ،نذإ مهئابطأ عم ةيبطلا تاراشتسلإا ءارجإ ىضرملا تاقوأ ليلقت يف مهاسي ام ،يضارتفا لكشب تارايز راركت نأ ثيح ،ظوحلم لكشب راظتنلاا دعوملا ىلإ لوصولل اركبم لزنملا ةرداغمو بيبطلا تادايعلا يف راظتنلإا مث ،ددحملا تقولا يف كلهتست ةقهرم رومأ اهلك ،تاعاسل ةمحدزملا .دهجلاو تقولا نم ريثكلا ضيرلما ةحار ينسحت ةيحصلا ةياعرلا يقلت ىضرملل دعب نع بطلا حيتي فيراصمو لقنتلا ءانع مهيلع رفوي ام ،مهلزانم نم وأ لافطلأا باحطصا ةقشم بنجتو تلاصاوملا لكشب ةديفم ةزيملا هذه .ىرخأ ةصاخ تابيترت ،ةنمزملا ضارملأل ةيرودلا ةعباتملا تلااح يف صاخ .ةيسفنلا ةحصلاب ةقلعتملا تاراشتسلإاو تامدخو ةينورتكللإا ديعاوملا زجح تاباوب للاخ نمو نيسحت يف دعب نع بطلا مهاسي ،ةنملآا لئاسرلا .ءابطلأاو ىضرملا نيب لاعفلا لصاوتلا ةلصاوتم ةيحص ةياعر تازيمملا نم ةدحاو ةلصاوتملا ةيحصلا ةياعرلا ربتعت ىلع رصتقي دعي مل يذلا دعب نع بطلل ةيفاضلإا اضيأ دعي لب ،بسحف لاملاو دهجلاو تقولا ريفوت ،ةيحصلا ةياعرلا ةيرارمتسا نيسحتل ةلاعف ةليسو ضارمأ نم نوناعي نيذلا ىضرملل ةبسنلاب ةصاخ .ةيرود ةعباتم بلطتت ةنمزم تاراشتسا ءارجإ دعب نع بطلا تاينقت حيتت مل نإو ىتح ،مظتنم لكشب بيبطلا عم تاعباتمو ةدايعلا ىلإ ايصخش روضحلا ىلع ارداق ضيرملا نكي ةبقارم ةصاخ تاينقت للاخ نم بيبطلل نكمي ثيح طغض لثم دعب نع ضيرملل ةيويح ةيحص تارشؤم يف مهاسي امم ،مدلا يف ركسلا ةبسن وأ مدلا ةلمتحم تافعاضم وأ تاريغت يأ نع ركبملا فشكلا عم مءلاتي امب جلاعلا ططخ ليدعت ىلإ ةفاضلإاب .ضيرملا ىلع أرطت يتلا ةيحصلا تاريغتلا

ةيبط تاروطت



2024 )رايأ( ويام l 130 دعب نع نواعتلا زيزعت ةياعرلا ريفوت ىلع دعب نع بطلا رود رصتقي لا اضيأ دعي لب ،بسحف ىضرملل دعب نع ةيحصلا ةياعرلا يمدقم نيب نواعتلا زيزعتل ةلاعف ةليسو ةيصصختلا ةيبطلا تاربخلا نم ةدافتسلااو ةيحصلا ءارجإ دعب نع بطلا تاينقت حيتت .رسيأ لكشب ةيلولأا ةياعرلا ءابطأ نيب ةكرتشم تاراشتسا رظنلا ضغب ،تلااجملا فلتخم يف نييئاصخلأاو ءاربخلا ءارآ نم ةدافتسلإاو يفارغجلا مهعقوم نع تلااحلا يف ءاربخلاو نييئاصخلأا رابك ءارآ بلطو ةيصيخشت تاهيجوت ىلع لوصحلاو ،ةدقعملا .ةقيقد ةيجلاعو ةيلزنلما ةياعرلا ريفوت ىلع دعب نع بطلا رود رصتقي لا كلذ ىدعتي لب ،دعب نع ةيبطلا تاراشتسلإا ىضرملا ةلاحل دعب نع ةبقارملا اضيأ لمشيل ةبقارملا ةزهجأ رفاوت كلذ ىلع ةلثملأا نم .ةيحصلا تاقيبطتو ءادترلإل ةلباقلا ةزهجلأا لثم ةيويحلا لاسرلإ تاينقتلا نم اهريغو لومحملا فتاهلا بلقلا تابرض لدعمو مدلا طغض لثم ةيويح تانايب ةياعرلا يمدقم ىلإ مدلا يف ركسلا ىوتسمو ،دعب نع بطلا تاينقت مادختساب .دعب نع ةيحصلا يتلا ةيحصلا ضارعلأا نع غلابلإا ىضرملل نكمي بيبطلا دعاسي امم ،مظتنم لكشب اهنم نوناعي ومدقم ميقي امك ،ةيحصلا ةلاحلا روطت عبتت ىلع ضيرملا نم اهنوقلتي يتلا تانايبلا ةيحصلا ةياعرلا لماش لكشب ةيحصلا هتلاح مييقتل اهنومدختسيو .ةبسانملا ةيجلاعلا تارارقلا ذاختاو ئراط يبط معد تلااح يف امساح ارود دعب نع بطلا بعلي يتلا وأ ةيئانلا قطانملا يف ةصاخ ،ةيبطلا ئراوطلا .ةصصختملا ةيبطلا تامدخلا يف صقن نم يناعت يف ةيبطلا قرفلل نكمي ،ئراوطلا تلااح يفف نع نيصصختم ءابطأ ةراشتسا ةديعبلا عقاوملا ةيبط تاهيجوتو تاداشرإ ىلع لوصحلاو ،دعب ةكراشم ىلإ ةفاضإ ،ضيرملا ةايح ذاقنلإ ةيروف ام ،يظحل لكشبو يلعفلا تقولا يف تامولعملا .ةبسانمو ةعيرس ةيجلاع تارارق ذاختاب حمسي نييئاصخلأا تاهيجوتل نكمي ،تلااحلا ضعب يفو ،هعقوم يف ضيرملل مزلالا جلاعلا ميدقت دعب نع ،ةديعب ةيبط زكارم ىلإ هلقن ىلإ ةجاحلا نم للقي ام ذاقنلإ امساح نوكي دق يذلا تقولا رفوي يلاتلابو ىضرملا جلاع جئاتن نسحت تاءارجلإا هذه .هتايح .ةاجنلا صرف نم ديزتو ،ئراوطلا تلااح يف ةيبط تاروطت